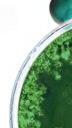

LEERWERKBOEK



Lies Alen
Patrick Arnou
Alexander Colin
Frederik De Ridder
Marie Diels
Nikolai Dobbelaere
Hanne Goossens
Zoë Meerkens
Lore Praet
Elke Stasseyns
Stef Van Aken
Annelies Van Laere
Saskia Yperzeele
Via www.ididdit.be heb je toegang tot het onlineleerplatform bij Traject Nederlands 5. Activeer je account aan de hand van de onderstaande code en accepteer de gebruiksvoorwaarden. Kies je ervoor om je aan te melden met je Smartschool-account, zorg er dan zeker voor dat je e-mailadres aan dat account gekoppeld is. Zo kunnen we je optimaal ondersteunen.


LET OP: DEZE LICENTIE IS UNIEK, EENMALIG TE ACTIVEREN EN GELDIG VOOR EEN PERIODE VAN 1 SCHOOLJAAR. INDIEN JE DE LICENTIE NIET KUNT ACTIVEREN, NEEM DAN CONTACT OP MET ONZE KLANTENDIENST.
Fotokopieerapparaten zijn algemeen verspreid en vele mensen maken er haast onnadenkend gebruik van voor allerlei doeleinden. Jammer genoeg ontstaan boeken niet met hetzelfde gemak als kopieën. Boeken samenstellen kost veel inzet, tijd en geld. De vergoeding van de auteurs en van iedereen die bij het maken en verhandelen van boeken betrokken is, komt voort uit de verkoop van die boeken.
In België beschermt de auteurswet de rechten van deze mensen. Wanneer u van boeken of van gedeelten eruit zonder toestemming kopieën maakt, buiten de uitdrukkelijk bij wet bepaalde uitzonderingen, ontneemt u hen dus een stuk van die vergoeding. Daarom vragen auteurs en uitgevers u beschermde teksten niet zonder schriftelijke toestemming te kopiëren buiten de uitdrukkelijk bij wet bepaalde uitzonderingen. Verdere informatie over kopieerrechten en de wetgeving met betrekking tot reproductie vindt u op www.reprobel.be.
Ook voor het digitale lesmateriaal gelden deze voorwaarden. De licentie die toegang verleent tot dat materiaal is persoonlijk. Bij vermoeden van misbruik kan die gedeactiveerd worden. Meer informatie over de gebruiksvoorwaarden leest u op www.ididdit.be.
© Uitgeverij VAN IN, Wommelgem, 2023
De uitgever heeft ernaar gestreefd de relevante auteursrechten te regelen volgens de wettelijke bepalingen. Wie desondanks meent zekere rechten te kunnen doen gelden, wordt verzocht zich tot de uitgever te wenden.
Foto’s p. 77:
Crewdson, Gregory (b.1962). Untitled (beer dream). 1998. laser direct colour coupler print mounted on Cintra, 127x152.4cm; Untitled (Ophelia). 2000-2001. Digital chromogenic print, edition number six of ten, 127 x 152.4 cm (50 x 60 in.). Claire and Gordon Prussian Fund for Contemporary Art (2001.486); Crewdson, Gregory (b.1962). Untitled, Winter (bed of roses). 2005. chromogenic print, 144. 7x223.5cm; Crewdson, Gregory (b.1962). Untitled (Boy with Hand in Drain). 2001-2002. colour coupler print, 121.9x152.4cm; Untitled. 2001-02. Chromogenic print. A.P. 2/3, edition of 10. 48 x 60 inches (121.9 x 152.4 cm). Purchased with funds contributed by the Photography Committee, 2002; Untitled. 1999. Chromogenic print. edition 4/10. 50 x 60 inches (127.0 x 152.4 cm). Purchased with funds contributed by the Photography Committee, 2000; Untitled, 1998.
Photograph, Silver dye-bleach (Cibachrome) print, with laminate, Image: 50 x 60 in. (127 x 152.4 cm), Framed: 55 x 65 in. (139.7 x 165.1 cm). Ralph M. Parsons Fund (AC1999.71.1)
p. 125, 126 - Reproductie van de artikels met toestemming van de uitgever, alle rechten voorbehouden. Elk hergebruik dient het voorwerp uit te maken van een specifieke toestemming van de beheersvennootschap License2Publish: info@license2publish.be
Eerste druk 2023
ISBN 978-94-647-0101-2
D/2023/0078/124
Art. 603780/01
NUR 110
Ontwerp: Effenaf
Opmaak: Zyncke Vanderplancke
Tekeningen: Veerle Hildebrandt



Hoe ga je met dit boek aan de slag? We leiden je door enkele belangrijke aspecten.
Je kunt je volledig verliezen in een boek en het slechte of goede bij jezelf ontdekken. Dankzij een boek krijg je een onbelemmerde inkijk in iemands hoofd en leven. 1 Je ziet het nut van verhalen in 1 Je denkt na over je eigen leesgedrag en erkent daarbij de voordelen van boeken lezen
In boeken kan eender wat gebeuren. Jouw grootste angsten, dromen, fantasieën … worden werkelijkheid. 2 Je maakt kennis met verschillende verhalen
1 les
10 Formuleren Je kunt een duidelijk en goed geformuleerd antwoord geven op een vraag 1 Je maakt correct gebruik van signaal- en verwijswoorden
Waarom lezen wij? Over het nut van verhalen les A Stel je voor dat jij de leerkracht bent. Tijdens de les hebben drie leerlingen onderstaande antwoorden ingediend. Geef ze telkens een score en beargumenteer waarom je die score geeft.
3 9
Vooraan elke les zie je de lesdoelen Die verduidelijken wat je met die les zult bereiken.
1
2 Waarvoor staat de afkorting PIE? Leg het begrip kort uit in je eigen woorden. Leerling 1 Taal. PIE = Proto-IndoEuropees hypothetische voorouder Europese talen 3
3 Je kunt een goed opgebouwde alinea schrijven
les 2 Taal voor een leerkracht –taal voor leerlingen H ? Hoe leert een mens een taal? Veel wetenschappers hebben zich al over die vraag gebogen. Keer even terug naar je eigen jeugdherinneringen. Hoe heb jij je moedertaal geleerd? Wat is jouw moedertaal? b Hoe heb je je moedertaal geleerd? Wie
4




Leerling 2 De afkorting PIE staat voor Proto-Indo-Europees. Dit is een hypothetische taal die de Europese taalfamilie.
impliciete en expliciete taalregels
1 onDERWEG
wees je voor het eerst op taalfouten die je maakte? Je leest een fragment uit Taal Fragment 1 Kinderen leren hun moedertaal grotendeels vanzelf, zonder uitleg. Grotendeels maar niet helemaal. Om goed te leren lezen en schrijven, bijvoorbeeld, hebben mensen een leraar nodig. Ook wanneer je als volwassene een vreemde taal wilt leren is goed onderwijs van grote waarde. Maar wat houdt goed taalonderwijs eigenlijk in? Welke regels moet een lerares haar klas bijbrengen als ze wil dat de leerlingen goed Nederlands leren? Wat zijn taal- en spelfouten en hoe voorkom je ze? Sterre Leufkens is taalkundige en auteur van boeken, artikelen en blogs over taal en taalwetenschap. Ze heeft taalwetenschap gestudeerd en is gepromoveerd aan de Universiteit van Amsterdam. Op dit moment werkt ze als universitair docente Nederlandse Taalkunde aan de afdeling Nederlands van de Universiteit van Utrecht. Leufkens doet onderzoek naar de leerbaarheid van talen en naar het onderwijs Nederlands als tweede taal. Naast haar academische activiteiten Je kunt op basis van woordleerstrategieën de betekenis van onbekende woorden achterhalen
is ze ook actief als populair-wetenschappelijk auteur. Onder het pseudoniem Milfje Meulskens is ze coauteur van het taalblog De Taalpassie Milfje ze kennis over en enthousiasme voor taal en taalkunde probeert over te brengen.
Leerling 3 De hypothetische voorouder van de Indo-Europese talen is het Proto-Indo-Europees. Deze gereconstrueerde taal wordt afgekort als PIE. De Indo-Europese talen zijn een taalfamilie. De talen die tot die familie behoren, worden gesproken over hypothetische taal omdat er geen bronnen in deze taal zijn overgeleverd, ze werd dus gereconstrueerd. 3 118 21

Je kunt spelfouten, taalfouten en typfouten van elkaar onderscheiden Je kent prescriptieve en descriptieve naslagwerken die je kunt inzetten bij schrijftaken 3 literatuur informatie & communicatie taalinzicht

Waarom lezen wij?
Je ziet het nut van verhalen in 1
Je denkt na over je eigen leesgedrag en erkent daarbij de voordelen van boeken lezen

LEZEN. WAAROM? WIE?
1 Bekijk onderstaande uitspraken. a Zet een kruisje bij de uitspraak die het beste bij jou past.
b Welke uitspraak kun je nog toevoegen?
Nadat je een goed boek gelezen hebt, blijf je verweesd en gedesoriënteerd achter.
Je kunt niet zeggen ‘ik lees niet graag’, je bent gewoonweg het juiste boek nog niet tegengekomen.
Er is zoveel leukers te doen dan lezen.
Dankzij een boek krijg je een onbelemmerde inkijk in iemands hoofd en leven.
Lezen is de geschiedenis herbeleven.
Boeken tonen je de stommiteiten van anderen en zorgen ervoor dat je niet dezelfde begaat.
Over het nut van verhalen 128 Tussenstop 2 TAAL EN WOORDENSCHAT Taal: tekstverbanden en signaalwoorden In het Kennisoverzicht op p. XXX vind je een overzicht van de soorten tekstverbanden en signaalwoorden. Verbind de zinnen met een signaalwoord. Breng genoeg variatie in de tekstverbanden die je uitdrukt en de signaalwoorden die je gebruikt. Vandaag zijn we niet op school. De leerkracht en bijna de helft van de klas is ziek. b De professor zet alle materialen en stoffen klaar. Hij doet zijn labojas aan. Hij overloopt de werkwijze van het proefje. De meeste Belgen eten om zes uur. Belgische vrijgezellen eten meestal om half acht. d Tsjechië is een mooi land. Ik wil er niet wonen. Voor roeien heb je sterke arm- en beenspieren nodig. Ik doe veel aan krachttraining. Ik wil niet mee op vakantie. Ik heb er geen zin in. Ik heb er geen geld voor. Het mag niet van mijn ouders. 1 ©VANIN
In boeken kan eender wat gebeuren. Jouw grootste angsten, dromen, fantasieën … worden werkelijkheid.
Lezen? Saai!
Na enkele lessen is er een tussenstop. Die herken je aan de oranje achtergrondkleur. In de tussenstops ga je verder aan de slag met de leerstof die je tijdens de voorgaande lessenreeks behandelde. Het gaat hier om oefeningen op taal en woordenschat, receptieve vaardigheden en een uitdaging.
Je kunt je volledig verliezen in een boek en het slechte of goede bij jezelf ontdekken.
Wie zich laat afschrikken door het aantal pagina’s mist soms de mooiste ontmoetingen.

1 woord verweesd: eenzaam, verlaten, verloren 1
2 Je maakt kennis met verschillende verhalen LES 1 WAAROM LEZEN WIJ? OVER HET NUT VAN VERHALEN 9
In enkele lessen geven we je eerst het bronmateriaal (bijvoorbeeld een artikel) en de bijhorende instructies, gevolgd door ruimte om te noteren. Zo moedigen we je aan om je antwoorden op een geordende manier neer te schrijven. Dat is een mooie voorbereiding op het hoger onderwijs, waar je ook zelfstandig zult moeten noteren.
ons het mooiste is wat ik in mijn leven heb en soms ben ik zelfs zo vreselijk opgelucht, dat ik tegen haar zeg dat ik niks aan het leven zou vinden als ik haar niet had. Ik weet niet eens zeker of dat wel zo overdreven is, maar dat je, als je je zo gelukkig voelt, alles een beetje aandikt, dat is ook wel waar.
Ara is een stuk rustiger dan ik. Die zegt zonder een spier te vertrekken dat wij voor elkaar bestemd zijn en dat niemand daar ooit verandering in kan brengen. Dat ze dat weet.
‘Wij zijn elkaars lot’, zegt Ara.
In de lessen ondersteunen we je met enkele kaders en iconen.
dat je een vlinder ter dood veroordeelt als je zijn vleugels ontmoeting. Ik voelde me net zoals toen ik voor het eerst de archipel dook helder op boven de zeespiegel, die dagenlang me op de brug. Hij trappelde van ongeduld en sprak land, ook al bezocht hij het voor het eerst. u, luitenant Pinkerton, neemt u als echtgenote een van ogen van een kat?’ instemde.
Onthouden-kaders bevatten belangrijke kennis, vaardigheden en strategieën
Een taalregister is een stilistische taalvariant waarbij de taalgebruiker zijn taalgebruik aanpast aan een sociale situatie. Taalregisters vormen een continuüm met aan het ene uiteinde zeer informeel taalgebruik en aan het andere uiteinde zeer formeel taalgebruik auto – vehikel
buitenlanders een huis en een echtgenote kozen voor de duur van gewoonte in dit land van tradities, zo leerde ik later tot
2 Welk taalregister gebruik je in de volgende situaties? Plaats de verschillende voorbeelden op het onderstaande continuüm.
de tekst? dat? verslag krantenartikel gebruiksaanwijzing keuze.
Onderaan sommige pagina’s tref je de verklaring aan van een woord of uitdrukking op die pagina. Online bij het lesmateriaal vind je bij elke tussenstop een overzicht van de woorden die aan bod kwamen.
geheid: gegarandeerd de archipel: eilandengroep
zeer formeel suggestie: e | b | c | h | j | i | g | f | a | d
evaluatiestructuur handelingsstructuur structuur




Je telefoneert naar een mogelijke stageplaats.
b Je legt je oma uit hoe ze een smartphone moet gebruiken.
c Je vraagt je leerkracht om een toets uit te stellen.
d Je opent een nieuwe rekening bij de bank.
Bij sommige opdrachten staat een tip om je op weg te helpen.
e Je spreekt af met enkele vrienden om iets te gaan drinken.
Je maakt een afspraak om een studentenkamer te bezoeken.
Je vraagt naar een bepaald product in de winkel.
Je gaat in gesprek met je leerkracht tijdens je mondelinge examen.
Je knoopt een gesprek aan met je leerkracht wanneer je hem/haar tegen het lijf loopt in de winkel.
Bekijk de vaste tekststructuren in het Kennisoverzicht op p. .
Vergelijk jouw bevindingen met die van een medeleerling en bespreek eventuele verschillen. Welke factoren hebben in deze situaties een invloed gehad op jouw keuze? Leg uit waarom.
uitdrukkingen) die de samenhang van de tekst kernwoorden over de inhoud van die alinea.
Onderweg-kaders bevatten leuke weetjes
In voorgaande voorbeelden wordt de keuze voor het register bepaald door het doelpubliek, de ontvanger van de boodschap, maar ook door de context. Zo communiceer je formeler met je leerkracht tijdens een mondeling examen dan wanneer je hem/haar tegen het lijf
onderweg
Interne Keuken is een Vlaams programma op Radio gepresenteerd door Koen Fillet en Sven Speybrouck. Zij interviewen wekelijks vier gasten tijdens een tafelgesprek over de actualiteit.

2 Vul het schema in over je gekozen onderwerp. persoonlijk antwoord
Welk thema koos je? A B C D
Waarom koos je dat thema?

Voorkennis activeren
Als je dit icoon ziet, ga je voorkennis activeren. Dat kan gaan om leerstof die je in een voorgaand schooljaar of in een eerdere les al gezien hebt of onderwerpen die je kent uit je dagelijks leven.
Di erentiatie
Het di erentiatie-icoon geeft aan dat je met een remediërings- of een verdiepingsopdracht te maken hebt. Je oefent verder op leerstof die je nog niet helemaal onder de knie hebt (remediëring) of je gaat een extra uitdaging aan (verdieping of uitbreiding).
Woordenschat
Dit icoon geeft aan dat je je woordenschat zult verrijken of strategieën leert om met nieuwe en moeilijke woorden om te gaan.
Actief verwerken
Eenmaal je kennis of vaardigheden verworven hebt, kun je actief verwerken Je past wat je leerde zelfstandig toe in een nieuwe situatie.
Play
Dit icoon geeft aan dat je een audio- of videofragment zult beluisteren of bekijken.
Gami cation
Doorheen het boek vind je verschillende games om met je medeleerlingen te spelen.
iDiddit
Dit icoon geeft aan dat er aanvullend lesmateriaal of een extra opdracht op iDiddit staat.
VAN IN Plus
Soms is het handig dat je extra lesinformatie of een videoof audiofragment zelf kunt bekijken of beluisteren op je smartphone. Als je dit icoon ziet, open dan de VAN IN Plus-app en scan de pagina.
Mijn lesmateriaal
Hier vind je alle inhouden uit het boek, maar ook meer, zoals filmpjes, audiofragmenten, extra oefeningen ...
Extra materiaal
Bij bepaalde stukken theorie of oefeningen kun je extra materiaal openen. Dat kan een bijkomend audio- of videofragment zijn, een woorden- of begrippenlijst, een extra bron of een leestekst. Kortom, dit is materiaal dat je helpt om de leerstof onder de knie te krijgen.
Adaptieve oefeningen
In dit gedeelte kun je de leerstof inoefenen op jouw niveau. Hier kun je vrij oefenen of de oefeningen maken die de leerkracht voor je heeft klaargezet.
Opdrachten
Hier vind je de opdrachten die de leerkracht voor jou heeft klaargezet.
Evalueren
Hier kan de leerkracht toetsen voor jou klaarzetten.
Resultaten
Wil je weten hoever je al staat met oefenen, opdrachten en toetsen? Hier vind je een helder overzicht van al je resultaten.
Notities





Heb je aantekeningen gemaakt bij een bepaalde inhoud? Via je notities kun je ze makkelijk terug oproepen.
Meer weten?
Ga naar www.ididdit.be

Je ziet het nut van verhalen in 1
Je denkt na over je eigen leesgedrag en erkent daarbij de voordelen van boeken lezen
1 Bekijk onderstaande uitspraken.
a Zet een kruisje bij de uitspraak die het beste bij jou past.
b Welke uitspraak kun je nog toevoegen?
Boeken laten je de wereld ontdekken vanuit je luie zetel.
Nadat je een goed boek gelezen hebt, blijf je verweesd en gedesoriënteerd achter.
Je kunt niet zeggen ‘ik lees niet graag’, je bent gewoonweg het juiste boek nog niet tegengekomen.
Er is zoveel leukers te doen dan lezen.
Dankzij een boek krijg je een onbelemmerde inkijk in iemands hoofd en leven.
Lezen is de geschiedenis herbeleven.
Boeken tonen je de stommiteiten van anderen en zorgen ervoor dat je niet dezelfde begaat.
In boeken kan eender wat gebeuren. Jouw grootste angsten, dromen, fantasieën … worden werkelijkheid.
Je maakt kennis met verschillende verhalen
Lezen? Saai!
Je kunt je volledig verliezen in een boek en het slechte of goede bij jezelf ontdekken.
Wie zich laat afschrikken door het aantal pagina’s mist soms de mooiste ontmoetingen.
verweesd: eenzaam, verlaten, verloren
WAAROM LEZEN JONGEREN NIET GRAAG?

Jongeren lezen niet graag. Waar zij in de lagere school nog graag met hun hoofd tussen de boeken zaten, neemt dat leesplezier nadien zienderogen af. Enkele VRT-journalisten hebben vijf jongeren ondervraagd over hun houding tegenover lezen.
1 Voor deze opdracht werk je in groepen. Elk groepslid bekijkt minstens één getuigenis en beantwoordt de volgende vragen.
a Waarom vindt de leerling in het filmpje lezen niet leuk?
zienderogen: duidelijk zichtbaar, goed waarneembaar
b Ervaart de leerling negatieve gevolgen van weinig lezen? Zo ja, welke?
Nele Savannah Louise Jan Feryal
c Geeft de leerling ook (een) mogelijke oplossing(en) om leerlingen te motiveren om toch te lezen? Zo ja, welke?
Nele Savannah Louise Jan Feryal
Na het bekijken van de filmpjes bespreken jullie in groepjes de antwoorden. Vervolgens bespreek je of je akkoord gaat met de oorzaken en oplossingen die de vijf jongeren aanreiken. Kunnen jullie nog andere oplossingen bedenken voor literatuuronderwijs om literatuur en het lezen ervan weer aantrekkelijk te maken voor jongeren?
Je vindt hieronder en op de volgende pagina’s een reeks tekstfragmenten. Daarna vind je een overzicht van de bijhorende uitgaven met telkens de auteur, de cover en een korte beschrijving.





Precies op het moment dat ik van de onderzoekstafel af kwam en mijn wijde groene trui weer over mijn dijen zakte, zei de gynaecoloog dat ik met zekerheid zwanger was. Wat ik voor een maagkwaal had gehouden, was zwangerschapsmisselijkheid. Niettemin schrijft hij mij injecties voor om de menstruatie weer op te wekken, maar hij zag er niet uit of hij dacht dat ze veel effect zouden hebben. Op de drempel glimlachte hij joviaal, ‘Liefdesbaby’s zijn altijd de mooiste.’ Dat was een vreselijke zin. Ik keerde te voet terug naar het studentencomplex. In de agenda staat: ‘Ik ben zwanger. Wat verschrikkelijk.’
Iemand moest Josef K. belasterd hebben, want zonder dat hij iets kwaads had gedaan, werd hij op een morgen gearresteerd. De keukenmeid van mevrouw Grubach, zijn kamerverhuurster, die hem elke ochtend tegen achten het ontbijt bracht, kwam deze keer niet. Dat was nog nooit gebeurd. K. wachtte nog een poosje, zag van zijn kussen uit de oude vrouw die tegenover hem woonde en die hem met een voor haar heel ongewone nieuwsgierigheid gadesloeg, maar dan, met een gevoel van bevreemding en honger tegelijk, belde hij. Onmiddellijk werd er geklopt en een man, die hij hier in huis nog nooit had gezien, kwam binnen. Hij was slank en toch stevig gebouwd, hij droeg een nauw aansluitend zwart pak, dat als een reiskostuum voorzien was van verscheidene plooien, zakken, gespen, knopen en een ceintuur en dientengevolge, zonder dat het je duidelijk werd waartoe het dienen moest, bijzonder praktisch leek. ‘Wie bent u?’ vroeg K. en zat meteen half rechtop in bed. Maar de man negeerde zijn vraag alsof je zijn verschijning moest accepteren, en zei op zijn beurt slechts: ‘U hebt gebeld?’ ‘Anna moet me het ontbijt brengen’, zei K. en probeerde, eerst in stilte, door oplettendheid en nadenken uit te maken wie de man eigenlijk was. Die echter stelde zich niet al te lang bloot aan zijn blikken, maar keerde zich naar de deur, die hij een eindje opendeed om tegen iemand, die kennelijk vlak achter de deur stond, te zeggen: ‘Hij wil dat Anna hem zijn ontbijt brengt.’ Er volgde een kort gelach in de aangrenzende kamer, uit de klank viel niet op te maken of er meer dan één persoon aan meedeed.
Je truitjes en je witte en rode sjaals en je kousen en je slipjes (met liefde gemaakt, zei de reclame) en je brassières (er steekt poëzie in die dingen, vooral als jij ze draagt) –ze slingeren rond in dit gedicht als op je kamer.
Kom er maar in, lezer, maak het je gemakkelijk, struikel niet over de zinsbouw en over de uitgeschopte schoenen, gaat u zitten.
(Intussen zoenen wij even in deze zin tussen haakjes, zo ziet de lezer ons niet.) Hoe vindt u het, dit is een raam om naar de werkelijkheid te kijken, alles wat u daar ziet bestaat. Is het niet helemaal als in een gedicht?
Ara en ik denken meestal dat we alles van elkaar weten, ook zonder dat we daarover praten. Zodra ze het wel doet en mij over iets ondervraagt, weet ik van verlegenheid niet waar ik het moet zoeken en dan kost het me heel veel moeite om een eerlijk antwoord te geven. Het is hartstikke stom, want achteraf ben ik er altijd heel gelukkig mee dat zij de moed heeft gevat om iets dat tussen ons in hangt, te bespreken en dat de lucht dan opgeklaard is. Het is ook nog eens zo dat moeilijke gesprekken geheid eindigen met dat je weer eens tegen elkaar zegt hoeveel je toch van elkaar houdt en dan kan ik haar ook gewoon zeggen dat die vriendschap tussen ons het mooiste is wat ik in mijn leven heb en soms ben ik zelfs zo vreselijk opgelucht, dat ik tegen haar zeg dat ik niks aan het leven zou vinden als ik haar niet had. Ik weet niet eens zeker of dat wel zo overdreven is, maar dat je, als je je zo gelukkig voelt, alles een beetje aandikt, dat is ook wel waar.
Ara is een stuk rustiger dan ik. Die zegt zonder een spier te vertrekken dat wij voor elkaar bestemd zijn en dat niemand daar ooit verandering in kan brengen. Dat ze dat weet.
‘Wij zijn elkaars lot’, zegt Ara.
O, Butterfly! Wordt er niet gezegd dat je een vlinder ter dood veroordeelt als je zijn vleugels aanraakt?
Ik herinner me onze eerste ontmoeting. Ik voelde me net zoals toen ik voor het eerst de Japanse kust had gezien. De archipel dook helder op boven de zeespiegel, die dagenlang leeg en triest was gebleven.
Yves, mijn rechterhand, stond naast me op de brug. Hij trappelde van ongeduld en sprak luid. Hij leek alles te weten van dit land, ook al bezocht hij het voor het eerst.
‘Zodra ik aankom, ga ik trouwen! En u, luitenant Pinkerton, neemt u als echtgenote een van die popjes met een gele huid en de ogen van een kat?’
Ik glimlachte, alsof ik ermee instemde.
Het was gebruikelijk dat buitenlanders een huis en een echtgenote kozen voor de duur van hun verblijf. Een vreemde koloniale gewoonte in dit land van tradities, zo leerde ik later tot mijn schande.
woord


geheid: gegarandeerd de archipel: eilandengroep



Ik wil nu weten of zij haar al lang kennen. Neen, pas sedert vandaag. Zij was aan boord gekomen om zakken te verstellen en zij hadden haar een sjaaltje gegeven, een pot gember en zes doosjes sigaretten. Nadat zij dit alles aanvaard had, werd een afspraak gemaakt voor vanavond en toen het eerste doosje ledig was, had zij naam en adres op de bodem geschreven. Dus niet langs de weg gevonden. Daar zit wel enige waarborg in.
En wie van hen nu eigenlijk op haar verliefd was. Hijzelf of welke van zijn twee volgelingen?
‘Alle drie’, verzekert Ali.








En als ik hem even beloer, want het kon wel een geestigheid zijn, spreekt uit zijn aangezicht al de oprechtheid van een paard.

Ik kan mijn westerse onbescheidenheid niet langer in toom houden.

‘En of Maria hen werkelijk alle drie ontboden had?’






Want dat zou getuigen van een zeldzame ondernemingsgeest voor een meisje van twintig. woord
ontbieden: laten komen



NU autorennen – vliedende – vlucht
groeiend door de priemen pijlen gloeiend
wrakken auto’s rijten donkere lappen van de nacht wrakke wriemelen
onregelmatige SAKKADEN vertrapte mensen verdrekte soldaten verrekte beesten
Yes, ‘n’ how many years can a mountain exist Before it is washed to the sea?
Yes, ‘n’ how many years can some people exist Before they’re allowed to be free?
Yes, ‘n’ how many times can a man turn his head And pretend that he just doesn’t see?
The answer, my friend, is blowin’ in the wind
The answer is blowin’ in the wind
Yes, ‘n’ how many times must a man look up Before he can see the sky?
Yes, ‘n’ how many ears must one man have Before he can hear people cry?
Yes, ‘n’ how many deaths will it take ‘til he knows That too many people have died?




The answer, my friend, is blowin’ in the wind
The answer is blowin’ in the wind
Origineel
Hoeveel jaar kan een berg bestaan Alvorens hij wegspoelt in de zee?
En hoeveel jaar kunnen sommige mensen bestaan Alvorens zij vrij mogen zijn?
En hoe vaak kan een man zijn hoofd wegdraaien
En doen alsof hij net niet ziet?
Het antwoord, mijn vriend, verwaait in de wind
Het antwoord verwaait in de wind
En hoe vaak moet een mens opkijken Alvorens hij de lucht ziet?
En hoeveel oren moet iemand hebben
Alvorens hij de mensen kan horen huilen?
En hoeveel doden moeten er vallen vooraleer hij weet Dat er te veel mensen zijn gestorven?
Het antwoord, mijn vriend, verwaait in de wind
Het antwoord verwaait in de wind










Toen meneer Bilbo Balings van Balingshoek bekendmaakte dat hij binnenkort met een bijzonder luisterrijk feest zijn elftigeneerste verjaardag zou vieren, werd dit in Hobbitstee het gesprek van de dag. Bilbo was heel rijk en een hoogst eigenaardig iemand, en was zestig jaar lang het wonder van de Gouw geweest, vanaf het moment van zijn merkwaardige verdwijning en onverwachte terugkeer. De schatten die hij van zijn reis had teruggebracht waren nu een plaatselijke legende geworden, en men geloofde algemeen, wat de oude lieden ook mochten beweren, dat de Heuvel van Balinshoek vol gangen zat die waren volgepropt met schatten. En alsof dat hem al niet beroemd genoeg maakte, gaf ook zijn onverminderde vitaliteit aanleiding tot verbazing. De tijd schreed voort, maar scheen weinig invloed op meneer Balings te hebben. Toen hij negentig jaar was, zag hij er bijna net zo uit als toen hij vijftig was. Toen hij negenennegentig was, begon men hem ‘goed geconserveerd’ te noemen, maar ‘onveranderd’ zou juister zijn geweest. Er waren lieden die het hoofd schudden en vonden dat dit een beetje te veel van het goede was: het scheen niet eerlijk dat iemand (blijkbaar) niet alleen de eeuwige jeugd bezat, maar ook (naar verluidde) een onuitputtelijke rijkdom. ‘Dat zal zich wreken’, zei men. ‘Het is onnatuurlijk en daar komen moeilijkheden van.’

Frans Kafka, Het proces, 1914

Het proces is Kafka’s onvoltooide roman over een bankbediende die door twee heren wordt opgepakt en in staat van beschuldiging wordt gesteld, zonder echter ooit te weten waarom.
Paul van Ostaijen, Bezette stad, 1922

Paul van Ostaijen maakt in een vernieuwende bundel de gruwel van de Eerste Wereldoorlog zichtbaar via typografische gedichten en taal.
Het woord ‘kafkaiaans’ is afgeleid van de schrijver. Wie ooit uren heeft moeten doorbrengen in de wachtkamers van de rechtbank of het stadhuis, van het ene loket naar het andere is gestuurd, aan de telefoon een heel menu voorgeschoteld kreeg zonder vooruitgang te boeken, die kan zich een personage uit een roman van Kafka voelen.
In Het dwaallicht laat Willem Elsschot drie Afghaanse matrozen op zoek gaan naar Maria Van Dam in de Antwerpse binnenstad. Het is een druilerige novemberavond als Frans Laarmans hen helpt in hun zoektocht naar dit mysterieuze meisje. Vinden zij uiteindelijk dit meisje of heeft zij hen bewust op een dwaalspoor gezet? Deze korte novelle is opgenomen in de canon van de Nederlandstalige literatuur.
J.R.R. Tolkien, In de ban van de ring, 1954 Dit boek is een van de populairste boeken uit de twintigste eeuw; het gaat over een zoektocht die zich afspeelt in een door Tolkien gecreëerde wereld. De trilogie vormt de grondslag voor de moderne fantastische literatuur en is verkozen tot het beste boek van de twintigste eeuw. Peter Jacksons verfilmingen van het boek wonnen samen zeventien Oscars.

André Franquin, Guust
Flater – Flaters schade, 1968














Guust Flater is een stripreeks die zich afspeelt op de redactie van het stripblad
Robbedoes. Guust is de held zonder werk, hij is lui, onhandig, gulzig en eigenwijs. De tekenstijl van Franquin heeft vele tekenaars beïnvloed.

In 1963 bracht Bob Dylan het protestlied Blowin’ in the wind uit. In dit lied plaatste de Amerikaanse folk- en protestzanger grote vraagtekens bij vrede, oorlog en vrijheid. In 2016 ontving de zanger de Nobelprijs voor literatuur. Woordvoerster Sara Danius prees Dylans werk ‘omdat hij nieuwe poëtische uitdrukkingsvormen in de grote Amerikaanse songtraditie heeft gecreëerd. Hij maakt poëzie voor het oor.’ Bob Dylan blijft voor velen een bron van inspiratie.


de typogra e: alle aspecten die horen bij de opmaak van een tekst (bv. lettertype, regelafstand en witruimte) de trilogie: drie romans die een geheel vormen

Herman de Coninck, De lenige liefde, 1969

De lenige liefde is de eerste dichtbundel van Herman de Coninck. In zijn gedichten speelt hij graag met de spanning tussen woorden en voorwerpen.
Annie Ernaux, Het voorval, 2004


De Franse auteur Annie Ernaux won in 2022 op 82-jarige leeftijd de Nobelprijs voor literatuur. Annie Ernaux schrijft autobiografisch, maar plaatst haar persoonlijke verhaal altijd in een bredere context. Ze publiceerde al meer dan twintig romans.
Connie Palmen, De vriendschap, 1995


In het midden van het schooljaar merkt Kit een iet wat rare, nieuwe leerling op aan het verlaten muurtje op de speelplaats. Ze besluit dat deze nieuwe leerling, Ara, haar beste vriendin zal worden. Meer nog, ze adoreert Ara, die haar volledige tegenpool blijkt te zijn. Via allerlei filosofische en psychologische beschouwingen neemt Connie Palmen de lezer mee in de verschillende levensfases van de vriendinnen. Is dit ‘bloedzusterschap’ een verbintenis voor het leven?
Het voorval speelt zich af in de jaren zestig. Annie, de hoofdfiguur, is zwanger geraakt en ze besluit clandestien abortus te laten plegen. Zonder te oordelen, zonder valse emoties, vertelt ze over die gebeurtenis. Het boek is ook verfilmd en won in 2021 de Gouden Leeuw op het filmfestival van Venetië.
Shaun Tan, De aankomst, 2008


Een vader verlaat zijn gezin en emigreert naar een vreemd land. Hij gaat op zoek naar het nieuwe geluk voor hemzelf en zijn gezin. Onderweg ontmoet hij tal van lotgenoten, ze wisselen hun levensverhalen uit, helpen elkaar en zo ontstaan er nieuwe vriendschappen. Zal hij zijn gezin terugzien? In deze graphic novel maken sterke afbeeldingen woorden overbodig.
Benjamin Lacombe, Madame Butterfly, 2014

Benjamin Lacombe maakte een vrije bewerking van Puccini’s opera










Madama Butterfly. Hij beschrijft het welbekende verhaal vanuit het oogpunt van de Amerikaanse luitenant Benjamin Franklin Pinkerton. De marinier huwt een jonge geisha, Cio-Cio-San, bijgenaamd Butterfly. Wanneer Pinkerton teruggeroepen wordt naar Amerika, belooft hij Butterfly dat hij zal terugkeren als het roodborstje zijn nest maakt. Jarenlang blijft ze op haar grote liefde wachten, maar hij blijft de grote afwezige. Op een zeker moment meert zijn boot aan. Butterfly ziet daarin de bevestiging van zijn liefde aan haar, maar … was zijn liefde oprecht? Een dramatisch verhaal met respect voor tal van Japanse tradities en voorzien van prachtige tekeningen in een boek van … 6 meter lang.
clandestien: in het geheim en bij wet verboden de beschouwing: bespreking, analyse
Ronan Le Breton, Sagen van de tafelronde – Deel 1 Eerste heldendaden, 2007 In deze trilogie komen de oude verhalen van de ridders van de Ronde Tafel opnieuw tot leven. Minder bekende ridders worden voorgesteld, waarbij de onderliggende queestestructuur met heldendaden en wonderen erg herkenbaar is. Aan dit boek hebben verschillende illustrators meegewerkt. Iedere ridder krijgt zo een eigen vormgeving en kleurgebruik. In dit deel vertelt Viviane, de vrouwe van het meer, over de lotgevallen van Lancelot, Percival en Gawein.
1 Verbind de verschillende tekstfragmenten op p. 12-17 met de uitgaven op p. 18-20.


uitgave


2 Bekijk de uitgaven bij de vorige opdracht.
a Van welke werken heb je al gehoord? Omcirkel de letter naast de titel(s).
b Welke werken heb je al gelezen? Markeer de titel(s).
c Welke werken spreken je aan? Plaats een ‘+’ voor de titel(s).
3 Vergelijk jouw antwoorden uit de vorige opdracht met enkele medeleerlingen. Wat stel je vast?
4 Welke auteur of welk boek ontbreekt volgens jou in deze lijst? Kun je ook zeggen waarom?
a Ga op zoek naar een leuk fragment uit dit boek of van deze auteur. Kies je fragment zo dat de lezer zin krijgt om het hele boek te lezen.
b Geef een samenvatting van het werk of info over de auteur.

Je kunt spelfouten, taalfouten en typfouten van elkaar onderscheiden
Je kent prescriptieve en descriptieve naslagwerken die je kunt inzetten bij schrijftaken

Je kent het verschil tussen impliciete en expliciete taalregels
Je kunt op basis van woordleerstrategieën de betekenis van onbekende woorden achterhalen
1 Hoe leert een mens een taal? Veel wetenschappers hebben zich al over die vraag gebogen. Keer even terug naar je eigen jeugdherinneringen. Hoe heb jij je moedertaal geleerd?
a Wat is jouw moedertaal?
b Hoe heb je je moedertaal geleerd?
c Wie wees je voor het eerst op taalfouten die je maakte?
Je leest een fragment uit Taal van Sterre Leufkens.


Kinderen leren hun moedertaal grotendeels vanzelf, zonder uitleg. Grotendeels maar niet helemaal. Om goed te leren lezen en schrijven, bijvoorbeeld, hebben mensen een leraar nodig. Ook wanneer je als volwassene een vreemde taal wilt leren is goed onderwijs van grote waarde. Maar wat houdt goed taalonderwijs eigenlijk in? Welke regels moet een lerares haar klas bijbrengen als ze wil dat de leerlingen goed Nederlands leren? Wat zijn taal- en spelfouten en hoe voorkom je ze?
Sterre Leufkens is taalkundige en auteur van boeken, artikelen en blogs over taal en taalwetenschap. Ze heeft taalwetenschap gestudeerd en is gepromoveerd aan de Universiteit van Amsterdam. Op dit moment werkt ze als universitair docente Nederlandse Taalkunde aan de afdeling Nederlands van de Universiteit van Utrecht. Leufkens doet onderzoek naar de leerbaarheid van talen en naar het onderwijs Nederlands als tweede taal.

Naast haar academische activiteiten is ze ook actief als populair-wetenschappelijk auteur. Onder het pseudoniem Milfje Meulskens is ze coauteur van het taalblog De Taalpassie van Milfje, waar ze kennis over en enthousiasme voor taal en taalkunde probeert over te brengen.
Bron: www.sterreleufkens.nl
2 Welke waarde heeft een leerkracht – volgens dat fragment – bij het leren van een taal?
3 Onderstaande zinnen bevatten fouten. Kun jij ze allemaal vinden?
a Duid de fouten aan.
b Verbeter de fouten.
A De vergrootte foto hing prominent in de huiskamer.
B Het werd me gisteren even teveel.
C Het wedr me gistren even te veel.
D De zonnenstraal verblindde hem tijdens de auto rit.
E Hij werkte avn vroeg in de morgen tot erg laat aan zijn scriptie.
F Het meisje waarop ik verliefd ben, ziet me niet eens staan.
G Ik ben men huiswerk thuis vergeten.
H Kun je me nu onmidellijk die schaar eens aanrijken!
I De werkgever had hun nog zo gewaarschuwd.
4 Bovenstaande opdracht bevat drie soorten fouten: taalfouten, spelfouten en typfouten.
a Probeer nu de drie soorten fouten te onderscheiden: markeer de spelfouten in het blauw, de taalfouten in het groen en de typfouten in het rood.
b Plaats bij elke soort fout de passende definitie.
taalfout •
spelfout•
typfout•
• Een fout die per ongeluk ontstaat tijdens het typen van een tekst. De spellingcontrole van de computer duidt deze (meestal) aan.
• Een overtreding van de spellingregels. Vaak kent de taalgebruiker de juiste spelregel niet, waardoor de fout ontstaat.
•een grammaticale fout of een verkeerd gebruikt woord

Dat je niet alle taalregels moet kennen om een nooit eerder gehoorde taaluiting te kunnen beoordelen op correctheid, bewijzen volgende zinnen:
‘het duidelijk niet politicus belooft is wat de!’
‘Het is niet duidelijk wat de politicus belooft!’
1 Ook al heb je bovenstaande zinnen misschien nog nooit eerder gelezen, toch voel je meteen aan dat de eerste taaluiting geen correcte zin is in het Nederlands. Hoe komt dat?



Taalregels zijn te verdelen in twee soorten. Ten eerste zijn er de impliciete regels, die iedere taalgebruiker kent, zonder ze te kunnen opnoemen. Elke moedertaalspreker van het Nederlands kan je vertellen dat de zin ‘het duidelijk niet politicus belooft is wat de!’ geen correcte zin is. Maar als je vraagt ‘Is er in deze samengestelde zin sprake van nevenschikking of onderschikking?’ dan staat diezelfde moedertaalspreker vaak met zijn mond vol tanden. Dit soort regels beheers je onbewust, zonder ze onder woorden te kunnen brengen – vandaar de term ‘impliciet’. Je leert ze als kind vanzelf, zonder leraar of andere instructie. Als je op school iets leert over impliciete regels dan gaat het eerder om het inzichtelijk maken ervan, bijvoorbeeld door zinnen te ontleden.
De tegenhanger van de impliciete regel is de expliciete regel, die je juist wél op school leert. Denk hierbij bijvoorbeeld aan de spellingregels: die leer je niet automatisch, maar van een leraar of uit een boek. Als je veel leest, dan zul je er een zeker gevoel voor ontwikkelen, maar zelfs dan moet je af en toe een woord opzoeken. Tenslotte voelt niemand van nature aan hoe je ‘pousse-café’, ‘cheerleader’ en ‘naïef’ moet schrijven. Maar ook makkelijkere expliciete regels, zoals de dt-regels, moet je bewust aanleren om ze goed te hanteren. In tegenstelling tot woordvolgorderegels vormen ze dan ook bewuste kennis: mensen die hebben opgelet op school, kunnen uitleggen wanneer je een d of juist een t moet schrijven.
2 Wat wordt er verstaan onder deze termen?
a impliciete taalregels
b expliciete taalregels
1 Bekijk even onderstaande dialoog.
a Welke twee personen zijn er aan het woord?
b Waarin verschillen beide taaluitingen wezenlijk van elkaar?
‘Goh, die plek ziet rood en jeukt. Er staan ook blaasjes op.’ ‘Ik zal je een anti-allergiepilletje en een zalf voorschrijven.’
2 Bekijk de woorden ‘prescriptief’ en ‘descriptief’ van naderbij.
a Welk (Latijns) woord vind je in beide woorden terug?
b Ken je nog woorden die datzelfde (Latijnse) woord bevatten? En kun je daar de betekenis van geven?
c Welk Nederlands werkwoord ontdek je hier?
3 Bekijk nu het woord ‘prescriptief’.
a Geef enkele woorden die met het voorvoegsel ‘pre-’ beginnen.
b Kun je op basis van die woorden achterhalen wat het voorvoegsel ‘pre-’ betekent?
4 Als je leerkracht Frans of Engels je een ‘description’ vraagt, wat bedoelt hij dan?
5 Met de juiste woordbetekenis in je achterhoofd, orden je nu de afbeeldingen op p. 25-26 in twee groepen. Leg uit waarom je ze in een bepaalde kolom plaatst. prescriptief
Naam en voornaam van de voorschrijver: DEMIR ELIF
DOOR DE VOORSCHRIJVER IN TE VULLEN: Naam en voornaam van de rechthebbende: BASIL CARDOEN
Voorbehouden aan het verpakkingsvignet R/ Dafalgan forte 1g Bij pijn innemen, max. 3x/dag



■ ANTWERPEN Ingerichte studentenkamer te huur in de Antwerpse binnenstad. De kamer is 25m² groot en heeft eigen douche en toilet. De gemeenschappelijke keuken en leefruimte deel je met 5 andere studenten.
Huurprijs: €350 + €40 maandelijkse kosten (water + gas + elektriciteit).
Te bezichtigen na afspraak: 03 123 45 67.
INGREDIËNTEN VOOR 1 PERSOON



• 1 ei

• peper en zout
• boter
GENEESMIDDELENVOORSCHRIFT


INGREDIËNTEN: aardappelen, zonnebloemolie (26%), koolzaadolie (6%), paprikasmaak, paneermeel (van tarwe), paprikapoeder, suiker, fructose, karnemelkpoeder, uipoeder, aroma’s (bevat melk, cafeïne, vanille, knoflookpoeder, champignonpoeder), kaliumchloride, rookaroma’s, rijstmeel, kleurstof (paprika-extract), zuurteregelaars (citroenzuur en appelzuur)], zout. Verpakt onder beschermende atmosfeer.

















6 Lees nu het fragment hieronder en keer daarna nog eens terug naar de indeling die je maakte bij opdracht 5. Blijf je bij die indeling of moet je nog iets veranderen?

Taal evolueert non-stop en zo is er wel degelijk een argument om af en toe een spellingwijziging door te voeren. Ons schrift is een afspiegeling van de gesproken taal, althans, een formele versie daarvan. Als de gesproken taal verandert, dan moet de spelling mee veranderen om te voorkomen dat het schrift te ver van de taal verwijderd raakt.
De impliciete en expliciete regels van de taal kun je vaak in boeken vinden: in Het Groene Boekje, lesboeken, schrijfwijzers … Zulke boeken kunnen prescriptief zijn: ze schrijven voor wat goed en fout is op het gebied van spelling, grammatica of stijl. Prescriptieve grammatica’s verschenen veel in de zeventiende eeuw, toen schrijvers vonden dat het Nederlands op het Latijn moest lijken. Ze hoopten de taal te verbeteren door nieuwe grammatica’s in te voeren. Ook nu nog verschijnen prescriptieve grammatica’s van het Nederlands, naast allerlei (online) adviesdiensten. Zij proberen geen regels toe te voegen, maar willen de bestaande regels uitleggen, zodat gebruikers fouten kunnen voorkomen.
Daarnaast bestaan er ook descriptieve boeken, die de impliciete regels beschrijven zonder er een oordeel over te vellen. In de bekendste descriptieve grammatica van het Nederlands, de Algemene Nederlandse Spraakkunst (ANS), staan de grammaticaregels van het Nederlands beschreven. Je kunt erin vinden welke regels Nederlandstaligen (onbewust) gebruiken, maar niet of die regels goed of fout zijn. Ook woordenboeken zijn descriptief: de makers ervan willen vooral weergeven welke woorden de taalgemeenschap daadwerkelijk gebruikt. Van die woorden moet een taalgebruiker tenslotte de betekenis kunnen opzoeken. Als een woord in de Dikke Van Dale staat, wil dat dus niet zeggen dat je dat woord móét gebruiken, of dat de redacteurs het een mooi woord vinden. Het is slechts de beschrijving van een bestaand Nederlands woord.
7 Geef op basis van de tekst een verklaring voor volgende termen.
• een prescriptief werk =
• een descriptief werk =






Lees fragment 4 uit Taal

Fragment 4
De beste spellers maken wel eens een dt-fout. Taalkundigen van de Universiteit Leuven hebben onderzoek gedaan naar de oorzaken daarvan. De meeste spellingfouten blijken niet het gevolg van domheid of onkunde, maar van slordigheid. Mensen weten de regels vaak wel, maar denken er even niet aan. Op die momenten gaan hun hersenen op automatische piloot. Die zijn niet stuurloos: onze hersenen hebben een ingebouwde voorkeur voor woordvormen die ze relatief veel zien. Het voltooid deelwoord ‘gebeurd’ komt vaker voor dan de persoonsvorm ‘gebeurt’. Als een speller haast heeft, zullen zijn hersenen op basis van die statistische informatie automatisch voor ‘gebeurd’ kiezen, ook als hij met even nadenken wel weet dat het fout is op die plek. Intelligentie en opleiding kunnen dit niet helemaal verhinderen, omdat het een automatisch en onbewust proces is. Wat wél helpt, is de tekst goed (laten) nalezen en corrigeren.
1 Kan iedere dt-fout afgedaan worden als een vorm van onoplettendheid? Leg je antwoord uit.
2 Waarom is het soms beter om een tekst door anderen te laten nakijken op taal- en spelfouten?
3 Hieronder staan enkele werkwoordsvormen die een gelijkaardige ‘gebeurd/gebeurt’-verwarring oproepen. Onderstreep de juiste vorm.
a Het is me weer een dag: eerst verlies ik mijn sleutels, nadien berooft/beroofd midden in de winkelstraat een gauwdief me van mijn portefeuille.
b Tomorrowland spreekt tot ieders verbeelding. Het decor is fantastisch, evenals de sfeer. De mensen zijn uitgelaten en gelukkig. Ik heb nog nooit zo’n magische sfeer beleeft/beleefd.
c Toen de notaris het testament voorlas, voelde je de spanning tussen de familieleden stijgen. De rijkdom van de grootvader werd jaren geleden al stiekem onder heel wat familieleden verdeelt/verdeeld.
d Als er nu niet snel iets aan deze penibele situatie verandert/veranderd, dan zal het nooit in orde komen.
e Hoe kan het dat een kind zich tijdens de zomervakantie zo verveelt/verveeld?
1
Je test hoe goed je leesvaardigheid is
Je haalt het onderwerp, de hoofdgedachte en de kernzinnen uit een tekst 3 4
Je herkent tekstdoel, tekstsoort en teksttype
1 Hieronder vind je vijf stellingen. Wat vind jij hiervan?
Je gebruikt woordleerstrategieën om de betekenis van onbekende woorden te achterhalen
Ik ben geïnteresseerd in muziek. ja nee Ik luister naar muziek tijdens het studeren. ja nee Ik kan veel liedjes meezingen. ja nee Ik heb een goede muziekkennis. ja nee Muziek heeft een invloed op mijn humeur. ja nee
2 Lees de tekst op p. 31-32 een eerste keer globaal en beantwoord volgende vragen.
a Wat is volgens jou het onderwerp van de tekst?
b Duid in de inleiding de hoofdgedachte aan van de tekst.
c Met welk tekstdoel schreef de auteur de tekst, denk je?
informeren
ontspannen
ontroeren
overtuigen
d Om welke tekstsoort gaat het hier?
een informatieve tekst
een persuasieve tekst
een narratieve tekst
een opiniërende tekst
e Welk teksttype is dit?
een reclametekst
een wetenschappelijke studie
een nieuwsartikel
een opiniestuk
3 Lees de tekst nu een tweede keer. Je leest het geheel en dringt door tot de volledige boodschap van de tekst. Beantwoord daarna volgende vragen.
a Welke alternatieve titel past het beste bij dit artikel?
Mensen kunnen maximaal 20 000 liedjes onthouden
Muziek blijkt belangrijk om hersenen te trainen
Brein kan oneindig aantal liedjes onthouden
Woorden onthouden moeilijker dan liedjes onthouden
b Duid in elke alinea de kernzin aan.
c Welke vraag over het onderwerp wordt in de alinea’s van deze tekst beantwoord? Verbind.
alinea 1 a Welke studie bewijst dat een mens gemiddeld 20 000 liedjes kent?
alinea 2 b Hoe goed onthouden we woorden en namen?
alinea 3 c Welke soort liedjes worden er gespeeld rond de eindejaarsperiode?
alinea 4 d Waarom onthouden we slechter woorden en namen?
alinea 5 e Hoeveel melodieën kunnen je hersenen tegelijkertijd aan?
alinea 6 f Hoeveel liedjes kunnen onze hersenen opslaan?
alinea 7 g Hoe belangrijk is het om vertrouwd te zijn met de muziek om liedjes te onthouden?
alinea 8 h Waarom voeren we onderzoek naar het onthouden van liedjes?
alinea 9 i Hoe ging het onderzoek naar geheugencapaciteit in zijn werk?
alinea 10 j Hoe verwerken we liedjes in ons hoofd?
k Waarom zijn liedjes zo gemakkelijk te onthouden?
l Hoeveel liedjes kent een mens gemiddeld?
d Wat is de juiste conclusie van het artikel?
De belangrijkste reden dat liedjes gemakkelijk te onthouden zijn, is omdat we meerdere melodieën tegelijkertijd kunnen onthouden.
In westerse culturen is het gemakkelijker om liedjes te onthouden.
Onze hersenen zijn in staat om duizenden liedjes te onthouden.
Je episodische geheugen is het belangrijkste om liedjes te kunnen onthouden.
e Welke stelling is fout?
Hoe je je voelt bij een bepaald nummer, is belangrijk om het te kunnen onthouden.
We onthouden heel veel liedjes passief, ze blijven ergens achteraan in ons hoofd zitten.
We kunnen precies 20 000 liedjes onthouden.
De herkenbaarheid van de muziek is belangrijk om liedjes te kunnen onthouden.
f In alinea 2 staat er: ‘Het is speculeren en het aantal zal natuurlijk per persoon sterk verschillen, maar qua ordegrootte denk ik ook aan zoiets.’ Wat betekent ‘speculeren’? Leid af uit de context.
g Geef drie redenen waarom we muziek zo goed kunnen onthouden.
4 Je hebt zonet een informatieve tekst besproken. Slaag je erin om zelfstandig zo’n tekst te verwerken? Je leerkracht zet op iDiddit een zelftest voor je klaar.




WETENSCHAPSWINKEL LIESELOT DELMAIRE, BRUGGE
Een gouwe ouwe in vele eindejaarslijstjes: Fleetwood Mac.


 © Richard McCaffrey / Contributor
© Richard McCaffrey / Contributor
Je hebt het ongetwijfeld al meegemaakt: je staat op een feestje, de dj draait een nummer dat je al jaren niet gehoord hebt, en toch blijk je nog grote delen te herkennen. ‘ Onze hersenen zijn in staat haast een oneindig aantal nummers te onthouden’, zegt geheugenonderzoeker Boris Konrad van het Donders Instituut in Nijmegen. Maar is dat ook zo, en vooral: hoe komt dat?
Herkennen boven meezingen
Met hun Top 1000 en 2000 aller tijden bespeelden radio-dj’s vlak voor de jaarwisseling als vanouds ons jeugdsentiment. ‘Ze draaien nummers die in ons collectieve geheugen gegrift staan’, mailt Lieselot Delmaire. ‘Al na de eerste paar tonen herken je ze. We kunnen ze niet allemaal van begin tot einde meezingen, maar ze geven op z’n minst het gevoel van “hé, dit nummer ken ik”.’
het collectieve geheugen: verzameling herinneringen die een groep van mensen gemeenschappelijk hebben
Onbewuste kennis
Hoeveel nummers kent een mens gemiddeld, vraagt Delmaire zich af. Ze gokt twintigduizend. ‘Dat lijkt me geen gekke schatting’, zegt geheugenonderzoeker Boris Konrad. ‘Het is speculeren en het aantal zal natuurlijk per persoon sterk verschillen, maar qua ordegrootte denk ik ook aan zoiets. De liedjes zitten in je episodische geheugen. Je bent je er niet altijd van bewust dat je ze kent, maar als je de eerste riedel hoort, blijk je de rest te kunnen meeneuriën.’
20 000 liedjes






Op welk onderzoek baseert Konrad het aantal van twintigduizend? ‘Het vraagstuk is nooit echt onderzocht’, zegt hij. ‘Maar er is wel een studie geweest naar ons visuele geheugen, een experiment met afbeeldingen.’
Begin jaren 70 wilde de Canadese psycholoog Lionel Standing uitzoeken hoeveel plaatjes mensen kunnen onthouden in korte tijd. Hij liet proefpersonen tienduizend afbeeldingen zien, vrij basale plaatjes van bijvoorbeeld een hond, een vliegtuig, een huis. Deelnemers mochten telkens maar enkele seconden kijken. Een week later schotelde hij ze een deel van diezelfde afbeeldingen voor, samen met plaatjes die ze nog niet eerder gezien hadden. Ze moesten aangeven welke ze al kenden en welke nieuw waren. De proefpersonen hadden meer dan 80 procent goed.
Liedjes verdringen elkaar niet
Onze hersenen kunnen veel informatie opslaan, wil Konrad daarmee zeggen. En als het op muziek aankomt, zijn ze nog performanter De hoeveelheid muziek die in ons brein past, lijkt hier oneindig.
‘Het gekke is: hoe meer liedjes we kennen, hoe makkelijker het wordt om nieuwe te onthouden.’
Dat zegt ook neurowetenschapper Steffen Herff van de Technische Universiteit van Lausanne, die onderzoekt hoe onze hersenen muziek verwerken. Er is iets opmerkelijks aan de manier waarop we dat doen, vertelt hij. Liedjes lijken elkaar niet te verdringen in je hoofd.
Met een experiment toonde Herff een paar jaar geleden aan dat mensen tot wel 200 nieuwe melodieën achter elkaar kunnen beluisteren zonder dat er ‘interferentie’ optreedt. Je hersenen kunnen die stortvloed aan informatie aan.
Niet hetzelfde voor woorden, namen en afbeeldingen
Met woorden, namen en afbeeldingen kunnen we minder goed uit de voeten. ‘Probeer maar eens op een feestje dertig namen te onthouden van mensen die je net hebt ontmoet. Dat is knap lastig. Na verloop van tijd vergeet je de namen die je als eerste hebt gehoord.’ Bij muziek gebeurt dat niet, of veel minder.
‘Dat we muziek zo goed onthouden, komt doordat die sterke associaties en emoties bij ons oproept’, vervolgt Herff. ‘We linken muziek vaak aan gebeurtenissen in ons leven.’
Belang van herkenning
‘Maar we hebben ook ontdekt dat je vertrouwd moet zijn met de muziekstijl. Zet als westerling eens Balinese Gamelanmuziek op: dat is een pak lastiger voor je geheugen.’
Naar: De Standaard
speculeren: zie opdracht 3f het episodische geheugen: geheugen voor persoonlijke gebeurtenissen de riedel: melodie, deuntje performant: goed presterend de interferentie: storing, samen- of tegenwerking van twee zaken op dezelfde tijd en plaats de associatie: gedachten met elkaar in verband brengen
Je kunt het verschil tussen informeel en formeel taalgebruik herkennen
2
Je kunt een correct taalregister kiezen voor een bepaalde situatie
Je kunt een zakelijke e-mail schrijven
Je bekijkt een fragment uit Zonde van de zendtijd
1 Bepaalde politici antwoorden niet op bepaalde vragen. Waarom?
2 Is dat terecht volgens jou? Waarom wel/niet?
3 Wat maakt dit fragment humoristisch?
Zonde van de zendtijd was een humorprogramma met Bert Gabriëls en Henk Rijckaert dat wekelijks werd uitgezonden op Canvas.
In een interview met hoogleraar An De Moor over de achteruitgang van de taalkennis van hogeschoolstudenten sprak ze over thema’s als begrijpend lezen en woordenschat, maar ze zei ook het volgende:
Bovendien hebben meer en meer studenten ook een probleem met taalregisters, ze kunnen het onderscheid niet maken tussen een formeel academisch register en een informele taal zoals die gebruikt wordt om te chatten.
Bron: www.radio1.be
1 Wat wordt er volgens jou bedoeld met ‘taalregister’? Leg die term in je eigen woorden uit.

Een taalregister is een stilistische taalvariant waarbij de taalgebruiker zijn taalgebruik aanpast aan een sociale situatie. Taalregisters vormen een continuüm met aan het ene uiteinde zeer informeel taalgebruik en aan het andere uiteinde zeer formeel taalgebruik
auto – vehikel
2 Welk taalregister gebruik je in de volgende situaties? Plaats de verschillende voorbeelden op het onderstaande continuüm.
a Je telefoneert naar een mogelijke stageplaats.
b Je legt je oma uit hoe ze een smartphone moet gebruiken.
c Je vraagt je leerkracht om een toets uit te stellen.
d Je opent een nieuwe rekening bij de bank.
e Je spreekt af met enkele vrienden om iets te gaan drinken.
f Je solliciteert voor een vakantiejob.
g Je maakt een afspraak om een studentenkamer te bezoeken.
h Je vraagt naar een bepaald product in de winkel.
i Je gaat in gesprek met je leerkracht tijdens je mondelinge examen.
j Je knoopt een gesprek aan met je leerkracht wanneer je hem/haar tegen het lijf loopt in de winkel.
3 Vergelijk jouw bevindingen met die van een medeleerling en bespreek eventuele verschillen.
4 Welke factoren hebben in deze situaties een invloed gehad op jouw keuze? Leg uit waarom.






Wie wil de laatste zaterdag van juni het schooljaar samen afsluiten met een teambuilding en pizza? :) We vertrekken om 8.30u aan het station. Ieder betaalt zelf zijn eigen activiteit en pizza.

Geef een seintje voor 30 mei of je aanwezig zult zijn of niet.
Met vriendelijke groeten
De klastitularis
Om formeel (zakelijk) te communiceren, moet je niet alleen je taalgebruik, maar ook het medium aanpassen aan de context. Een bepaald medium zorgt ervoor dat je communicatie als (in)formeler wordt beschouwd.

Zo worden een e-mail, een brief of een contactformulier vaak bij formele communicatie gebruikt. Een medium zoals een sms, een Snap of een wenskaart is vaak geschikt voor een informele situatie.



2 Welk medium (kanaal) zou jij gebruiken in onderstaande situaties? Bespreek klassikaal.
a Je wilt een afspraak maken met de leerkracht voor een extra bijles.
b Je wilt je relatie na vijf jaar beëindigen.
c Je wilt contact opnemen met een mogelijke stageplaats.
d Je wilt graag een afspraak maken om een studentenkamer te bezichtigen.
e Je wilt extra informatie over een rondreis die via een reisbureau georganiseerd wordt.
f Je wilt een jongen/meisje laten weten dat je hem/haar leuk vindt.
g Je wilt klagen over de dienstverlening van de trein.
h Je wilt samen met enkele vrienden naar Rock Werchter.
i Je wilt solliciteren voor een openstaande vacature.
j Je wilt je oma een gelukkige verjaardag wensen.
In een communicatiesituatie kun je deze delen onderscheiden:
• de zender wie de boodschap zendt: de spreker, de schrijver, de tekenaar …
• de boodschap wat: de informatie die wordt gestuurd (wat je letterlijk zegt)
waarover: de boodschap achter de boodschap (wat je bedoelt)
• de ontvanger wie de boodschap ontvangt: de luisteraar, de lezer, de kijker …
• het doel wat de zender bij de ontvanger wil bereiken (informeren, ontroeren …)
• de context de omstandigheden waarin de boodschap wordt doorgegeven
• het kanaal hoe/waarmee de boodschap wordt doorgegeven (het medium)
• het effect de uitwerking die de boodschap heeft op de ontvanger
Soms zijn er elementen die ervoor zorgen dat een boodschap niet helemaal tot bij de ontvanger komt. Die elementen noemen we ruis.
een slechte verbinding, veel achtergrondlawaai, een computer die niet werkt …
1 Je luistert straks naar een fragment uit Hautekiet, een programma op Radio 1. Zoek op welk soort programma dat was. Wat voor een fragment verwacht je?
2 Geef de, volgens jou, drie belangrijkste ‘do’s-and-don’ts’ bij het opstellen van een zakelijke e-mail.
Beluister nu het fragment.
3 Welke verschillen tussen een zakelijke brief en een zakelijke e-mail worden er in het fragment aangehaald?
4 Welke drie factoren bepalen hoe formeel je je communicatie opstelt?
5 Vul op p. 38 het schrijfkader voor een zakelijke e-mail verder aan.
6 Vergelijk jouw schrijfkader met dat van een medeleerling en vul aan indien nodig.
onderwerpregel
kenmerken van een goede onderwerpregel:
aanhef/aanspreking
mogelijke aansprekingen:
Zeer geachte
Leestekens
inleidende alinea
In deze alinea geef je kort de aanleiding van de e-mail en formuleer je een kernmededeling. midden
Werk in de overige alinea’s de inhoud verder uit. Elke alinea is een thematisch geheel, bestaande uit een kernzin en de uitwerking van die kernzin.
§1 context van het probleem
§2 mogelijke oplossingen
§3 voorstel of persoonlijke voorkeur oplossing
afsluitende alinea
Sluit je zakelijke e-mail af met een duidelijke vraag of wens. slot
mogelijke slotformules:
tip
Met de meeste hoogachting
©VANIN
Leestekens
7 Geef opnieuw de, volgens jou, drie belangrijkste ‘do’s-and-don’ts’ bij het opstellen van een zakelijke e-mail.
Hoe schrijf je een zakelijke e-mail?
Met vrienden en familie communiceer je vaak online. De stijl daarbij is informeel: je gebruikt afkortingen, afbeeldingen en memes, je laat hoofdletters en leestekens weg en je tekst is meestal niet opgebouwd uit alinea’s.
Voor school en later voor je stage of werk moet je soms communiceren met mensen die je niet kent of mensen die een hogere positie hebben. In dat geval maak je gebruik van een zakelijk bericht
De onderwerpregel in zakelijke mails is kort en duidelijk. Je gebruikt een groep woorden die de inhoud van je bericht samenvat. Leestekens, woordgrappen of dubbele bodems zijn hier niet gepast.
Gebruik als aanspreking Geachte heer of Geachte mevrouw voor mensen die je niet kent. Je kunt de familienaam toevoegen (Geachte heer Demunyck of Geachte mevrouw Franck) of mensen met hun functie aanspreken: Geachte commissaris, Geachte mevrouw de directeur
Gebruik neutrale woorden, blijf altijd beleefd en schrijf positief. Vermijd geklaag, ook als je over een probleem mailt. Stel zelf (haalbare) oplossingen voor en geef aan dat je steeds wilt bellen of afspreken om dingen verder te bespreken.
Bij een mail is het belangrijk dat de tekst kort blijft. Bouw je bericht op uit alinea’s en voeg geen emoticons of memes toe.
Rond je mail op een vriendelijke manier af zodat je op het einde een positieve indruk achterlaat.
Lees voor het versturen je bericht zeker na, zodat je geen storende spellingfouten laat staan.
Hoofdlettergebruik bij het persoonlijk voornaamwoord ‘u’
Het persoonlijk voornaamwoord ‘u’ wordt enkel met een hoofdletter geschreven wanneer er verwezen wordt naar een godheid of een heilig persoon
Vroeger werd ‘u’ ook met een hoofdletter geschreven wanneer het als aanspreekvorm gebruikt werd, dat is nu niet meer het geval.
Zeer geachte, geachte, beste of dag?
‘Zeer geachte’ wordt ervaren als een zeer formele aanhef, die kan gebruikt worden bij het aanschrijven van een notaris.
Zowel ‘geachte’ als ‘beste’ kan gebruikt worden voor een standaard zakelijke brief, al wordt ‘beste’ doorgaans als minder formeel beschouwd. ‘Geachte’ heeft de voorkeur in een professionele context wanneer een bericht gericht is aan cliënten of derden.
‘Dag’ wordt beschouwd als een informelere aanhef. Die kan gebruikt worden wanneer de ontvanger een bekende is, zoals bijvoorbeeld een naaste collega.
De aanhef wordt telkens gevolgd door mevrouw/heer en de naam van de ontvanger (indien die gekend is).
Hoogachtend of met vriendelijke groeten?
‘Hoogachtend’ of ‘met de meeste hoogachting’ kan gebruikt worden bij ‘zeer geachte’ en ‘geachte’ in zeer formele e-mails.
Wanneer ‘beste’ als aanhef gebruikt wordt, gaat de voorkeur uit naar ‘met vriendelijke groet(en)’.
Vermijd archaïsmen
Archaïsmen zijn verouderde woorden of taalvormen. Men kan archaïsmen gebruiken om een bepaald stilistisch effect te bekomen, maar doorgaans maakt het gebruik van archaïsmen een tekst onnodig zwaar.
gemaal, gaarne, de mening toegedaan zijn, dientengevolge …
Bijlage
Soms wil je een bestand als bijlage toevoegen aan je e-mail. Verwijs dan telkens in je e-mail naar de bijlage die je meestuurt. Om daarnaar te verwijzen, kun je gebruikmaken van ‘als bijlage’ (standaardtaal in het hele taalgebied) of ‘in bijlage’ (standaardtaal in België).
In een zakelijke brief verwijs je naar een bijlage met ‘Bijlage: …’
Een goede zakelijke e-mail of brief:

is kort en gericht op oplossingen;
is beleefd, zeker in de aanspreking en afsluiter;
bevat geen spellingfouten, memes of emoticons;
heeft een duidelijke onderwerpregel.
ouders
Kaas- en wijnavond 23/05 om 18u schoolteam
Beste heer/mevrouw
Met dit bericht nodig ik u graag uit voor onze kaas- en wijnavond op 23 mei.
Naar jaarlijkse gewoonte organiseert onze school een kaas- en wijnavond om de ouders van onze leerlingen beter te leren kennen. Deze activiteit zal plaatsvinden op 23 mei. Ons schoolteam ontvangt jullie graag om 18u met een drankje om vervolgens rond 18.30u aan tafel te gaan.
Graag uw aanwezigheid bevestigen voor 1 mei door te reageren op dit bericht.
Met vriendelijke groeten
Het schoolteam
Bij de start van een nieuw schooljaar komt heel wat kijken.
8 Schrijf een e-mail naar je leerkracht Nederlands waarin je je verwachtingen van dit schooljaar voor het vak Nederlands neerschrijft.
Volgende richtvragen kunnen je helpen bij de uitwerking van je tekst.
• Zijn er bepaalde onderwerpen waarrond je dit jaar graag wilt werken?
• Welke lessen vond je interessant in het verleden?
• Wat verwacht je van je leerkracht (bv. op vlak van feedback)?
Voorbereiding
• Wie is de ontvanger van je tekst?
• Wat is het doel van je e-mail?

• Welk taalregister gebruik je? formeel informeel
Checklist
Mijn tekst sluit aan bij de opdracht: ik bespreek mijn verwachtingen voor het vak Nederlands dit schooljaar.
Mijn alinea’s zijn thematisch afgebakend en bestaan uit een kernzin en de uitwerking daarvan.
Mijn taalregister is afgestemd op de opdracht.
Ik blijf steeds beleefd en respectvol in mijn e-mail.
Mijn opmaak komt overeen met de opmaak van een zakelijke e-mail.
Mijn e-mail is bondig.
Ik heb mijn tekst nagelezen op taal- en typfouten.
Het gebruikte taalregister sluit aan bij de opdracht.
Het gebruikte taalregister sluit gedeeltelijk aan bij de opdracht, maar:
- je gebruikt archaïsmen.
- je taal is soms informeel of te formeel.
- je aanspreking en slotformule zijn niet op elkaar afgestemd.
correctheid en aantrekkelijkheid
De spelling van het eindresultaat is (nagenoeg) foutloos.
De tekst bevat enkele spellingfouten die
- de communicatie niet hinderen;
- de boodschap niet in de weg staan.
Je taalregister is niet afgestemd op de opdracht:
- Je bent te informeel en gebruikt vulgaire taal en/of chattaal.
- Je gebruikt archaïsmen.
- Je gebruikt te formele constructies.
- Je gebruikt een foute aanspreking en/of slotformule.
De tekst bevat te veel en/of te opvallende spellingfouten.
Je gebruikt duidelijke en goed afgebakende alinea’s in je e-mail. Die alinea’s worden correct opgebouwd (kernzin + uitwerking).
- De tekst is onderverdeeld in alinea’s, maar die worden niet altijd correct opgebouwd.
- De tekst is onderverdeeld in alinea’s, maar die worden niet altijd duidelijk afgebakend.
- De tekst werd niet opgedeeld in alinea’s.
- De alinea’s zijn niet correct opgebouwd.
- De alinea’s vormen geen thematisch afgebakend geheel.
De opmaak van je e-mail komt overeen met de opmaak van een zakelijke e-mail.
volledigheid en duidelijkheid
- De inhoud van je e-mail wordt op een korte en bondige manier neergeschreven.
- Ook je onderwerpregel is kort en duidelijk.
- De inhoud van je e-mail is op een kernachtige manier neergeschreven, maar je onderwerpregel is te vaag en/of te lang.
- De kern van de inhoud wordt te laat duidelijk.
De opmaak van je e-mail komt niet overeen met de opmaak van een zakelijke e-mail.
- De e-mail is te uitgebreid. De kern van de e-mail is niet duidelijk en wordt te omslachtig verwoord. OF De inhoud van je e-mail is te kort, de ontvanger krijgt niet de nodige informatie.
- Het onderwerp geeft niet weer waarover de e-mail gaat.
- De inhoud van je e-mail sluit onvoldoende aan bij de opdracht.
Aanvullende commentaar:
Je staat stil bij hoe je een kortverhaal ervaart 1 Je kent de kenmerken van crime fiction 2

3



Je weet hoe de spanning in een kortverhaal wordt opgebouwd
Je analyseert de verhaalaspecten personage, spanningsopbouw, tijd en vertelperspectief
1 Het verhaal dat je gaat lezen behoort tot het genre crime ction. Wat zijn volgens jou de kenmerken van dat genre?
2 Bekijk onderstaande posters van tv-series.






a Welke van die series behoren ook tot het genre crime fiction?
b Wat hebben al die series gemeen?
3 De titel van het verhaal is Vrienden. Vind je dat een logische titel voor een crime ction verhaal? Waarom (niet)?
Pieter Aspe, die eigenlijk Pierre Aspeslag heet, was een Vlaamse schrijver. In 1995 schreef hij zijn eerste boek, Het Vierkant van de wraak, en al snel werd hij een erg succesvol misdaadauteur. Zijn bekendste personage is commissaris Van In, rond wie naast meer dan veertig misdaadboeken ook tv-reeksen en theatertours bestaan. Aspe woonde en werkte in de buurt van Brugge en liet ook zijn misdaadverhalen altijd afspelen in en rond die WestVlaamse stad. Hij stierf in 2021.

4 Hierboven kreeg je achtergrondinformatie over Pieter Aspe, de auteur van het verhaal.
a Wat verwacht je over de schrijfstijl, het thema en de moeilijkheidsgraad van het verhaal?
b Welke van zijn boeken heb je al gelezen?
Vrienden
Deel 1
Het kortverhaal wordt in drie delen verteld. Na elk deel beantwoord je een aantal vragen. 1
‘Het leven kan soms wreed zijn’, zei ik met een lijkbiddergezicht.
Patrick stak hoofdschuddend een sigaret op en blies de rook voor zich uit. Aan de andere tafels in de kroeg werd gelachen, geleuterd en gezopen. Zo hoorde het op vrijdagavond, na het werk. Dit was de plek noch het moment om een ernstig gesprek te voeren. Geld, wijven of sport. Het onderwerp maakte niet uit, als het maar gezellig bleef.
‘Heb je weer problemen met Rita?’ vroeg hij niet erg enthousiast toen ik mijn handen voor mijn gezicht sloeg en een diepe zucht slaakte.
‘Nee’, zei ik gelaten. ‘Dit keer is het veel erger.’ Patrick haalde zijn schouders op en probeerde me met een kwinkslag duidelijk te maken dat een paar pilsjes me wel in de juiste stemming zouden brengen, want ik had koffie besteld en dat beviel hem niet.
‘Hoe lang zijn we al vrienden?’ vroeg ik.
‘Waarom vraag je dat?’
‘Vierentwintig jaar’, zei ik. ‘Vierentwintig jaar en zeven maanden … om precies te zijn.’


‘Dat jij dat nog weet.’
de kwinkslag: grappige opmerking, humoristische uitspraak
Ik had Patrick op mijn elfde leren kennen bij de jeugdbeweging en sindsdien waren we onafscheidelijk. We hadden samen de dolste avonturen beleefd, stiekem sigaretten gerookt in de bosjes achter het parochiaal centrum en later op dezelfde plek de meiden proberen te versieren. Op school waren we haantjes-devoorste, de nachtmerrie van menige leraar. Hoewel ik de middelbare school niet afmaakte, bleef onze vriendschap intact. Dat Patrick later carrière maakte bij Financiën en ik waarschijnlijk tot aan mijn pensioen postbode zou blijven, veranderde daar niets aan. Integendeel. We bleven onafscheidelijk.
‘Ik denk dat ik toch maar iets sterkers neem’, zei ik.
Patrick dronk zijn glas in een teug leeg. Ik schoof mijn kop koffie terzijde.
‘Ken je het mopje van de Romeinse kapitein die zijn roeiers voor de middag meedeelt dat hij goed en slecht nieuws voor ze heeft?’
‘Nee’, loog Patrick.
Hij kende het mopje natuurlijk wel. Hij wilde alleen maar vermijden dat ik weer begon te zeuren. Iedereen wist toch dat de kapitein de roeiers eerst een dubbel rantsoen beloofde en daarna doodgemoedereerd verklaarde dat hij na de middag zin had om te waterskiën.
‘Er is mij iets gelijkaardigs overkomen’, fluisterde ik.
‘Laat me raden’, zei Patrick. ‘De Post is failliet en jij hebt een betere baan gevonden bij Belgacom.’
‘Nee, Patrick. Ik heb de lotto gewonnen. Achtenvijftig miljoen.’
‘Onnozelaar.’


‘Achtenvijftig miljoen vierhonderd vijfenzeventigduizend driehonderd zesentwintig frank om precies te zijn.’
Ik haalde het winnende formulier uit mijn binnenzak en liet het hem zien.
‘12, 15, 21, 22, 25, 39. Geloof je me nu?’



Ik liet hem ook een krantenknipsel zien met de winnende nummers. Patrick leek door een bliksemschicht getroffen. Zijn gezicht trok wit weg. Ik stopte het kostbare formulier weer in mijn binnenzak en bestelde voor ons beiden: geen pils maar trappist.
‘Waarom heb je me dat niet eerder verteld?’ vroeg Patrick ongelovig.
Hij had vorig jaar al zijn spaarcenten in aandelen van een Vlaams bedrijf gestopt. Het avontuur was hem zuur opgebroken. Hij was alles kwijtgeraakt.
‘Omdat mijn dokter me verteld heeft dat ik kanker heb. Aan de pancreas. De tumor is uitgezaaid, een behandeling nutteloos.’
‘Achtenvijftig miljoen’, herhaalde Patrick wezenloos. Dat ik hoogstens nog zes maanden te leven had, leek hem niet te interesseren. Het eerste wat hij vroeg was: wat zegt Rita daarvan?
‘Rita weet van niets’, zei ik. ‘Jij bent de enige die het weet, en ik ben niet van plan om het haar te vertellen.’ Mijn relatie met Rita stelde niet veel voor. Volgende maand waren we tien jaar getrouwd. Veel meer viel er over ons huwelijk niet te melden, behalve dat het kinderloos was.
‘De reden waarom ik Rita niets heb verteld, is dat ik niet wil dat ze mijn fortuin erft. Dat verdient ze niet.’ Het was al misgelopen tijdens onze huwelijksnacht toen ze misselijkheid veinsde en ik daarna van pure ellende naar de kroeg was getrokken. Ik was er nooit achter gekomen waarom ze die avond en bijna alle andere die daarop volgden een excuus had verzonnen om niet met mij naar bed te hoeven. In het begin had ik haar met rust gelaten in de overtuiging dat ze zou bijdraaien als ik lief voor haar was. Het had niet mogen baten, hoezeer ik me ook voor haar uitsloofde. Na verloop van tijd legde ik me daarbij neer, maar ook dat beviel haar niet. Ze begon over alles en nog wat te zeuren: over mijn povere salaris, mijn eetgewoonten die ze plotseling walgelijk vond en mijn wekelijkse bridgeavondjes natuurlijk, waaraan ze een grondige hekel had. In haar ogen kon ik niets goeds doen.
Ik reikte naar het glas trappist, zette het voorzichtig aan mijn lippen en nam een slokje. Het bier smaakte voortreffelijk. Patrick keek me doordringend aan.
intact: zonder scheuren, helemaal in orde doodgemoedereerd: heel rustig, ijzig kalm baten: helpen, winst opleveren pover: arm, mager, triestig
60


‘Wat ben je in vredesnaam van plan?’ vroeg hij achterdochtig.
Patrick luisterde met wijd opengesperde ogen toen ik hem vertelde dat ik hem mijn fortuin wilde nalaten, maar hij bleef realistisch.
‘Je vergeet de fiscus’, zei hij een beetje gepikeerd. ‘Over zo’n bedrag moet ik minstens tachtig procent successierechten betalen.’
Ik glimlachte.
‘Je houdt er hoe dan ook tien miljoen aan over.’
‘Toch niet. Rita heeft recht op de helft. Je kunt haar niet zomaar onterven.’
‘Is dat zo?’
‘Natuurlijk is dat zo.’
Patrick pakte zijn glas en dronk met gulzige teugen van het donkere bier. Slechts vijf van de achtenvijftig miljoen beuren. Het was je reinste waanzin.
‘Vijf miljoen is vijf miljoen’, zei ik rustig. ‘Tenzij …’
‘Tenzij wat?’
Patrick verslikte zich bijna. Hij keek me aan met de blik van een roofdier dat net een prooi heeft gemist en nu een tweede kans krijgt om toe te slaan.
‘Ik heb het formulier nog niet ingewisseld’, zei ik.
‘Wat bedoel je daarmee?’


‘Dat ik je het onderhands kan geven.’ ‘Dat meen je niet.’
‘Toch wel’, zei ik. ‘Maar in ruil daarvoor moet jij Rita van kant maken.’
de scus: de belastingambtenaar, (bij uitbreiding:) het hele belastingsysteem de successierechten: belasting die je moet betalen op een erfenis
1 Vat de gebeurtenissen in het fragment in één zin samen.
2 In het fragment maak je kennis met twee belangrijke personages.
a Wie zijn ze?
b Hoe is de verhouding tussen hen?
3 Focus op de ruimte waar het verhaal zich afspeelt.
a Welke afbeelding geeft het best de sfeer op café weer?


b Is dat een sfeer die je normaal gezien met een café associeert? Wat wil de schrijver daarmee bereiken?

4 Wie is in het verhaal de verteller?
5 Dit deel van het verhaal eindigt met een cli hanger.
a Wat is een cliffhanger?
een open einde dat de lezer zelf kan invullen
een gesloten einde waarin de auteur een verklaring geeft voor de gebeurtenissen
een onderbreking op een spannend moment
een verwijzing naar een andere tijd of andere plaats
b Waarom gebruikt de auteur een cliffhanger?
c* Hoe denk je dat het verhaal verdergaat?
* Het antwoord op deze vraag hoef je niet te noteren.
De slaapkamer, waar Patrick de voorbije drie jaar iedere dinsdagavond uitgebreid aan zijn trekken was gekomen, leek vanavond een beetje op een graftombe, ondanks de warmte die van Rita’s naakte lichaam afstraalde. ‘Scheelt je wat?’
‘Ik ben een beetje moe’, zei Patrick. ‘Jij moe. Laat me niet lachen.’
Ze schurkte zich tegen hem aan en liet haar hand onder de lakens naar beneden glijden. De dinsdagavonden waren haar dierbaar omdat het ‘facteurtje’ dan steevast ging bridgen en hij nooit voor middernacht thuiskwam. In den beginne had ze hem voorgesteld om met hem mee te gaan naar het clubhuis, maar dat vond hij dan weer niet leuk. Je zou je er alleen maar vervelen, luidde het commentaar. De onderliggende boodschap was duidelijk: bridgen was een denksport, dus ongeschikt voor vrouwen die een beroepsopleiding hadden gevolgd zoals zij. Alsof hij het er beter vanaf had gebracht. Miskende genieën die geen diploma hadden behaald, ze zou ze niet te eten willen geven.
‘Ik heb trek in een pilsje.’
Patrick pakte haar grijpgrage hand beet en haalde ze onder de lakens vandaan. Rita liet haar ontgoocheling niet merken. Ze wierp een blik op de klok. Het was vijf voor acht. Tijd zat dus.
‘Zal ik er eentje voor je halen?’
Ze sloeg de dekens terug en liep heupwiegend naar de slaapkamerdeur. Op haar figuur viel niets aan te merken. Hetzelfde gold voor haar borsten. Dat had ze aan haar ‘facteur’ te danken, en aan het zaad dat hij bijwijlen produceerde. Het was onvruchtbaar. Die informatie had ze van haar huisarts bij wie ze destijds stiekem een staal sperma had ingeleverd. Uw man is niet in staat om kinderen te verwekken, had hij gezegd. Ik vrees dat u zich daarbij zult moeten neerleggen. Rita had met plezier haar figuur opgeofferd in ruil voor een blozende baby, maar toen dat na het verdict van de huisarts onmogelijk bleek en ook het alternatief, adoptie, bij de ‘facteur’ niet in goede aarde viel, had ze Patrick gebeld, met wie ze vroeger in de bosjes achter het parochiaal centrum ettelijke keren heerlijke momenten had beleefd. Na drie jaar werd het stilaan tijd dat hij haar droom waarmaakte. Straks werd ze tweeëndertig, en de klok tikte.
Patrick staarde naar het plafond. Een duiveltje schreef er met een zwarte viltstift een getal van acht cijfers op. Achtenvijftig miljoen. Eigenlijk had Rita haar beste tijd gehad. De wekelijkse vrijpartijen waren routine geworden. Met achtenvijftig miljoen kon hij zich de duurste callgirls permitteren. Iedere week, zijn hele leven lang. De vraag was: hoe vermoord je iemand van wie je houdt?
‘Sorry, schat. Ik ben vergeten de pilsjes in de koelkast te zetten.’
Rita reikte hem een glas aan dat lauw aanvoelde. ‘Je vindt het toch niet erg?’
Patrick schudde zijn hoofd en nam een slok. Het goedje smaakte afschuwelijk. Met iemand samenleven is iets anders dan om de week binnenwippen en …
‘Weet je wat ik echt zou willen?’
Rita gleed onder de lakens en drukte zich stevig tegen hem aan. Op de kalender in de keuken had ze met rood haar vruchtbare periode aangekruist. Ze draaide zich op haar zij en gaf hem een zoen.
‘Een kind.’



‘We hadden toch afgesproken dat …’ Rita ging schrijlings op hem zitten. ‘Eentje maar’, smeekte ze.
‘Het bier is lauw’, zei Patrick.
‘Zal ik iets anders voor je halen?’
‘Nee, schat. Dit keer zorg ik wel voor de drankjes.’
Patrick sprong uit het bed en liep naar beneden. De voorraad slaappillen die Rita in het medicijnkastje in de keuken bewaarde, was voldoende om een heel bataljon soldaten naar dromenland te sturen. Drie of vier tabletten zouden volstaan. Als ze eenmaal in een diepe slaap was gevallen, zou hij het bad laten vollopen, haar erin leggen en haar hoofd gedurende een paar minuten onder water houden. Iedereen zou denken dat het om een ongeluk ging. Het was een mooi plan.
het verdict: (juridisch) eindoordeel het bataljon: groep militairen; (zelfstandige) legereenheid



Lees deel 2 van het verhaal.
6 Wat gebeurt er in dit fragment?

a Vat de gebeurtenissen opnieuw in één zin samen.
b* Had je dit vervolg verwacht?
7 Ook dit fragment focust op twee personages.

a Wie zijn ze?
b Hoe is de verhouding tussen de twee personages?
8 In het vorige fragment maakten we kennis met een naamloze ik-verteller.
a Welk vertelperspectief vind je in dit fragment terug?
b Waarom is hier de ik-figuur uit het vorige deel niet meer aan het woord?
c Waarom is hier voor een andere verteller gekozen, denk je?
9* Hoe verwacht je dat het verhaal zal a open?
1
In het clubhuis heerste een doodse stilte. Aan de tafels werd druk geboden. Het spel was volop aan de gang. ‘Jouw beurt.’
Ik legde mijn kaarten op tafel. De overwinning was in zicht.
Jean-Luc, barman en manusje-van-alles, tikte mij discreet op de linkerschouder. Er is telefoon voor u, zei hij.
Ik gaf mijn medespelers met een knikje te kennen dat ik het spel even wilde onderbreken en volgde JeanLuc naar de bar, waar het telefoontoestel stond.
‘Hallo.’
‘Ben jij het?’
‘Ja. Het is afgelopen.’
‘Fijn.’
Ik verbrak de verbinding en liep terug naar de speeltafel. In mijn hoofd zette een filharmonisch orkest de vijfde van Beethoven in.
Om kwart over twaalf parkeerde ik mijn wagen voor de deur van ons huis, correctie: mijn huis. Ik stapte uit, sloot de portieren af en liep naar de voordeur. Mijn hand trilde toen ik de sleutel in het slot stak. Eindelijk vrij. Het was een heerlijk gevoel. Ik liep door de gang. Vreemd dat er in de woonkamer nog licht brandde.
‘Wat doe jij hier nog?’
Patrick zat op de bank. Naast hem stonden een fles whisky en twee glazen. Zo te zien had hij al flink gedronken want de fles was half leeg. Op het vloerkleed zat een donkerrode vlek. Ernaast lag een koperen kandelaber
‘Er is een en ander misgelopen toen ik haar wilde verdoven. Ze werd argwanend en toen heb ik haar …’
Patrick wees naar de met bloed besmeurde kandelaber.
‘Waar is ze nu?’
‘Ik heb het lijk in het kanaal gedumpt.’
‘Ben je helemaal gek geworden?’
‘Maak je niet ongerust. Niemand heeft me gezien.’
Patrick nam de fles whisky en schonk de glazen half vol.
‘Niet doen’, schreeuwde ik gesmoord. ‘Als ik de politie nu niet bel, is mijn alibi waardeloos. Je moet hier stante pede weg.’
‘Dat zou pas onverstandig zijn’, zei Patrick doodkalm.
‘Wat bedoel je daarmee?’





Hij reikte mij een glas aan. Ik nam het aan, zette het aan mijn lippen en dronk het in een teug leeg. De drank deed me goed.
‘Ik denk dat de politie zich zal afvragen waarom je hen meteen hebt gebeld. Het lijk is weg. Een ongeruste echtgenoot zou eerst contact opnemen met familie en vrienden als hij bij zijn thuiskomst merkt dat zijn vrouw er niet is. Veronderstellen dat haar iets ergs is overkomen, zou je alleen maar verdacht maken. Zeker als later blijkt dat ze vermoord is.’
‘En de kandelaber dan … de bloedvlek op het kleed?’
‘Die kunnen we dumpen.’

Ik liet me op de bank neerzijgen, pakte de fles en schonk nog een borrel in.
‘Je kunt je verhaal zelfs nog geloofwaardiger maken’, ging Patrick onverstoorbaar verder.
‘Hoe dan?’
‘Weet iemand wie je vanavond gebeld heeft in de club?’
‘Natuurlijk niet.’
‘Dan zeg je de politie toch dat het Rita was.’
‘Waarom zou zij mij bellen?’
‘Om te zeggen dat ze zin had in een uitje en je haar niet al te vroeg thuis moest verwachten. Hebben wij rustig de tijd om alle sporen uit te wissen en de rest van de zaak af te handelen’, zei Patrick.
‘Welke zaak?’
‘Het lottoformulier.’
Ik glimlachte. Wat er ook was gebeurd, ik beschikte nog steeds over de sterkste hand.
‘Ik vrees dat ik je zal moeten teleurstellen, Patrick.’
Ik haalde het lottoformulier en het krantenknipsel uit mijn binnenzak. Het knipsel was veertien dagen oud, het lottoformulier dateerde van vorige week. Ik reikte hem beide papiertjes aan. ‘Ik wist dat jij en Rita al drie jaar een verhouding hadden’, zei ik op een triomfantelijke toon. ‘Ik heb geen wroeging dat ik je in de maling heb genomen. Ze is dood en ik ben vrij. Ik zou je eigenlijk moeten bedanken.’
woord
het lharmonisch orkest: groot orkest de kandelaber: grote kandelaar argwanend: wantrouwig stante pede: onmiddellijk, direct triomfantelijk: trots, zoals na een overwinning
Patrick klemde zijn kaken opeen, verfrommelde de papiertjes en gooide ze op de grond.
‘Dan heb je waarschijnlijk ook geen kanker’, zei hij toonloos.
‘Nee’, zei ik. ‘Ik voel me zo gezond als een vis.’
‘Smeerlap.’

‘Ik stel voor dat we de rotzooi eerst opruimen’, stelde ik monter voor.
Als het lijk gevonden werd, kon ik de politie nog altijd zeggen dat ik Patrick van de moord verdacht. Niemand zou zijn verhaal geloven.
‘Ik denk dat hij slaapt’, zei Rita.
Ze boog zich voorover en begon me te ontkleden. Het laatste wat ik hoorde, was een klokkend geluid van een fles die werd leeggegoten. Daarna sleepten ze me naar de badkamer. ‘Iedereen zal denken dat hij zelfmoord heeft gepleegd’, gniffelde Rita.
Ze zette haar hand op mijn hoofd en duwde het onder water.
10 Wie is de verteller?
11 Hoe is de relatie tussen Patrick en de ik- guur nu, in vergelijking met het begin van het verhaal?
12* Had je dit einde verwacht? Waarom (niet)?
13* Werden er in dit kortverhaal te veel gedachten en gevoelens beschreven of net te weinig?
14 Misschien deden meerdere elementen uit Vrienden jou denken aan andere verhalen of lms.
a Noteer ze kort.
b Zet een plus of een min wanneer je vindt dat dat element in Vrienden beter of net minder goed gebruikt wordt.
c Bespreek de lijst die je opstelde met je medeleerlingen.

1 Som alle personages uit het verhaal op.
a Vergelijk de personages met iemand uit de werkelijkheid.
b Welke personages uit het verhaal kun je weglaten?
c Verbind de namen van de personages met de begrippen protagonist, antagonist en nevenpersonage
2 Focus op de ruimte in het verhaal.
a Welke drie verschillende ruimtes worden gebruikt in dit kortverhaal?
b Waarom is er voor die ruimtes gekozen, denk je?
c Waarom denk je dat de auteur ervoor koos om Patrick en Rita in de slaapkamer te laten praten en niet in bijvoorbeeld de woonkamer?
3 In dit verhaal vinden we voor het grootste deel een ik-verteller terug.
a Waarom is de wissel in vertelperspectief belangrijk voor de spanning in het verhaal?
b Wat zou er anders zijn als het hele verhaal vanuit hetzelfde standpunt was geschreven?
Vertelperspectief
De verteller is diegene die het verhaal vertelt. Dat is niet de auteur, maar een onzichtbare stem die het verhaal naar ons brengt. In films of tv-reeksen is die soms letterlijk aanwezig: daar vertelt een stem terwijl we bepaalde beelden zien (voice-over).
De meest gebruikte vertelperspectieven zijn de ik-verteller en de hij/zij-verteller. Er zijn vier grote categorieën.
Belevende ik
Bij de belevende ik is er een ik-verteller die als personage meespeelt in het verhaal. Als lezer zie je alles wat er gebeurt door zijn of haar ogen en weet je wat het personage denkt en voelt. Hierdoor kun je je goed inleven en weet je waarom het personage bepaalde keuzes maakt. Als lezer ken je de afloop van het verhaal niet.
Vertellende ik
De vertellende ik heeft een ik-figuur die de gebeurtenissen rapporteert maar er geen echte rol in speelt. Die verteller vertelt de gebeurtenissen achteraf: hij weet hoe alles afloopt. Om de spanning hoog te houden, zal de verteller echter niet van bij het begin alles prijsgeven.
Alwetende hij/zij
De alwetende hij/zij of auctoriële hij/zij heeft een hij/zij-figuur die boven het verhaal staat en over de personages praat. Die verteller weet alles over iedereen, weet wat er eerder gebeurd is, weet wat er op andere plaatsen gebeurt en kent de afloop van het verhaal.
Bij dat vertelperspectief ligt de nadruk op het weergeven van handelingen; emotie en denken komen minder aan bod. De alwetende verteller kan soms op de voorgrond komen, letterlijk commentaar geven en de lezer aanspreken.
Personele hij/zij
Bij de personele hij/zij vertelt een hij/zij-figuur het verhaal door de ogen van één personage, maar staat het verhaal in de hij/zij-vorm. Net als bij de belevende ik-verteller krijg je subjectieve informatie over de andere personages. Je hebt een heel duidelijk beeld van het denken en voelen van dat ene personage, maar die weet niet hoe het verhaal afloopt.
5 In opdracht 3 bij ‘Situeren’ besprak je je mening over Vrienden als titel voor deze crime ction.
a Vind je dat na het lezen een gepaste titel voor het verhaal? Waarom (niet)?
b Welk ander woord kun je als titel nemen?
6 Bij crime ction is spanningsopbouw heel belangrijk. Voeg de elementen uit de vorige vragen samen om de spanningsopbouw in het verhaal te beschrijven.
Spanningsopbouw
Veel lezers vinden dat een goed verhaal spannend moet zijn. In sommige verhalen zullen dat de gebeurtenissen zelf zijn: bij een thriller wil je weten of de held overleeft, bij een detectiveverhaal wil je te weten komen wie de dader is.
Een stuk van de spanning in een verhaal zit in de inleving met de personages (emotionele spanning). De lezer bouwt een band op met personages en leeft met hen mee. Hij kent ze en wil weten hoe het met hen afloopt. Dat is duidelijk het geval bij soaps en langlopende tv-reeksen.
Er zijn ook allerlei technieken die een auteur bewust kan inzetten om ervoor te zorgen dat de lezer blijft lezen. Een typisch voorbeeld van spanningsopbouw is informatie achterhouden voor de lezer of er net voor zorgen dat de lezer meer weet dan het personage. Een auteur kan de verhaallijn ook onderbreken door een flashback of hij kan kiezen voor locaties om een bepaalde sfeer op te roepen.
Wanneer een verhaal plots stopt op een spannend moment en je als kijker/lezer absoluut een antwoord wilt op vragen die je je nog stelt, heb je te maken met een cliffhanger. Meestal kom je het verdere verloop van het verhaal pas te weten in een volgende aflevering. Cliffhangers komen we heel vaak tegen in soaps en series. Vaak vallen de onderbrekingen samen met de start van een reclameblok.
7 Jullie maakten kennis met verschillende aspecten van crime ction. Je speelt nu ter afsluiting dit interactieve moordverhaal waarin jullie in groep een moordmysterie onderzoeken.

SPELREGELS
Heb jij ondertussen inspiratie gekregen om een spannend verhaal te vertellen? Tijd om je eigen crime fiction te schrijven! Ontdek snel je opdracht in Tussenstop 2 op p. 143.












Het kortverhaal van Pieter Aspe is een voorbeeld van crime fiction. Je hebt ongetwijfeld al enkele films of tv-reeksen binnen dit genre gezien. Hieronder vind je een crime scene terug waar inspecteur Daggermans een moord onderzoekt. Via verschillende voorwerpen op deze afbeelding maak je kennis met acht spannende boeken.




Charles den Tex

thriller, mysterie (2005)
Michael Bellicher werkt voor een van de grootste adviesbureaus ter wereld. Alles waar hij van droomt, lijkt binnen handbereik. Tot hij na jaren zijn broer terugziet. De ontmoeting schokt hem en hij gaat onderuit. Op zijn werk dreigt ontslag. Om te voorkomen dat hij de volgende dag zijn kantoor niet meer in kan, sluit hij zich op in de kantine. Die nacht is hij getuige van iets wat hij nooit had mogen zien. Vanaf dat moment wordt Michael steeds verder in het nauw gedreven. Tijdens zijn vlucht stuit hij voortdurend op ‘mijnheer Miller’, een ongrijpbare man die alles over hem lijkt te weten.


Helen Vreeswijk
thriller (2009)
Anouk is een gewone tiener. Ze heeft leuke vriendinnen bij wie ze altijd terechtkan, doet het goed op school en komt niets te kort. Maar ze heeft een geheim dat ze met niemand durft te delen. Als ze uiteindelijk de moed heeft om het haar ouders te vertellen, stuit ze op een muur van onbegrip. Haar wereld stort in en ze wenst haar ouders het ergste toe. Maar daar krijgt ze snel spijt van, als blijkt dat een onbekende het gezin binnendringt en geld eist voor een leven.












Jan Simoen
psychologische roman (2007)








Op het politiebureau zit Nathan, een jongen van zestien. Hij bijt op zijn nagels en wacht totdat de inspecteur hem komt ondervragen. Hij heeft niets gedaan. Niets ergs in elk geval. Dat voorval met zijn ex Elke? Daar heeft ze zelf om gevraagd. Toch? Oké, misschien is Nathan wel een etter. Af en toe. Maar slecht? Nee, echt slecht is hij niet.

Paul Kustermans
thriller, detective (2016)


In het Valeriusinstituut slaat een seriemoordenaar ongenadig toe. De laatstejaarsleerlingen van deze elitaire middelbare kostschool vormen een bijzondere groep. Als een van hen vermoord wordt, besluit de groep te proberen samen de dader te ontmaskeren.
In hun gesloten wereldje zijn de leerkrachten de eerste verdachten. Het motief van de seriemoordenaar is origineel: het ligt in de toekomst verborgen, zodat de speurders van de politie volkomen in het duister tasten.

Belinda Bauer
thriller, mysterie (2009)



Elke dag na school en in de weekends, wanneer zijn vriendjes voetbalplaatjes ruilen, gaat de twaalfjarige Steven graven. Hij heeft een doel, een belangrijk doel. Als hij de botten van zijn oom Billy vindt, die op elfjarige leeftijd is verdwenen, zal zijn familie eindelijk rust hebben. Waarschijnlijk is Billy om het leven gebracht door een moordenaar die nog vastzit. Steven schrijft hem een brief, zonder zijn identiteit kenbaar te maken. Dan begint een kat-en-muisspel tussen een wanhopige jongen en een verveelde kindermoordenaar. Een heel gevaarlijk spel met grotere consequenties dan Steven ooit had kunnen voorzien …
Jonas Boets

thriller (2012)

Yago De Moor is twaalf wanneer zijn vader vermoord wordt door inbrekers. Hij wordt bij een pleeggezin geplaatst, waar hij doodongelukkig is. Jaren later ontdekt hij dat zijn vader een boodschap voor hem heeft achtergelaten in een oud stuk speelgoed. Yago gaat op zoek en doet een gruwelijke ontdekking: zijn vader was een huurmoordenaar. Werd hij daarom vermoord? En door wie dan? Langzaam maar zeker ontdekt Yago de waarheid. En zint hij alleen nog op wraak.



Allan Stratton




thriller (2015)




Al vijf jaar is Cameron met zijn moeder op de vlucht. Telkens moeten ze weer verhuizen omdat zijn gewelddadige vader hen op het spoor is. Wanneer Cameron op hun nieuwe adres een map met kindertekeningen vindt, raakt hij gefascineerd door het lot van de vorige bewoners. Al snel geeft het huis geheimen prijs die alleen Cameron lijkt te zien en horen.

Isabelle Quinn
mysterie, griezelverhaal (2015)

Als de vijftienjarige Sam op een koude winteravond een pizza gaat halen, wordt hij ineens verrast door een mysterieuze en dichte mist. Als de mist zich eindelijk terugtrekt, is Sams leven voorgoed veranderd. Op een handvol overlevenden na is de stad helemaal verlaten. Wat is er gebeurd? Zijn zij de laatsten op aarde? En waarom lijken bijna alle overlevenden te lijden aan een rare vorm van krankzinnigheid? Sam gaat wanhopig op zoek naar antwoorden door de besneeuwde stad. Maar dat is niet zonder gevaar …



1 Vul de correcte vorm van het werkwoord in.
a Nu (vinden) ik het genoeg geweest!
b De leerkracht (beoordelen) de leerlingen meestal positief, maar vandaag (betreuren) hij de zwakke resultaten.
c Het (worden) gelukkig beter weer.
d Dat (beloven) spannend te worden.
e Het (gebeuren) te vaak dat automobilisten fietsers niet goed zien.
f (antwoorden) jij altijd zo onbeleefd als jou iets gevraagd (worden)?
g (benijden) de buurman jou om je nieuwe auto?
h Het is nog niet duidelijk wie de misdaad gepleegd heeft, maar blijkbaar (vermoeden) de politie dat er een bende aan het werk is.
i Gisteren (landen) een vliegtuig met succes op het water.
j Gelukkig (posten) ik dat kaartje nog net op tijd. Anders had ze geen enkel kaartje ontvangen voor haar verjaardag.
k De goochelshow was een succes. De kinderen (lachen) de hele tijd.
l De krant (berichten) vorig jaar al over de toegenomen armoede.
m Hij heeft altijd (beweren) dat hij onschuldig was.
n Je hoeft niet boos te zijn, ze heeft het zo niet (bedoelen).
o Er is deze week weer veel (gebeuren) dat ik je nog niet (vertellen) heb.
p Heb jij je huiswerk al (maken)?
q Hij heeft alle vragen goed (beantwoorden).
r (worden) nu toch eens volwassen!
s (staren) niet zo naar die mensen.
t (zijn) voorzichtig op de weg!
u (opwinden) je niet zo
v Die trainer (coachen) die turners al jaren.
w Mijn broer (skateboarden) vroeger heel graag, maar nu (volleyballen) hij een keer per week.
x Wanneer heb jij voor het laatst (scoren)?
y (deleten) dat filmpje onmiddellijk!
Je leerkracht deelt nu de oplossingen van opdracht 1. Kijk je antwoorden na en verbeter waar nodig. In de volgende opdrachten oefen je verder naargelang je score bij deze opdracht. Een overzicht van de theorie van de werkwoordspelling vind je in het Kennisoverzicht op p. 408.
2 Maakte je in opdracht 1 fouten in zinnen a tot e?
a Bekijk in het Kennisoverzicht op p. 408-409 nog eens goed de theorie over de persoonsvorm in de tegenwoordige tijd.
b Zet de volgende werkwoorden op de juiste plaats in de zin. Let op: je kunt niet alle vormen invullen!
Kies uit: vind – vindt – gebeurd – gebeurt – vertelt – verteld – schud – schudt – vermoed –vermoedt
c In de zinnen hieronder vulde je voornamelijk persoonsvormen in. Toch zat er ook een voltooid deelwoord in. Markeer dat werkwoord.
1 Wat jij ervan dat ze dat nu pas ?
2 Jij maar iets uit je mouw.
3 Dat is niet waar! Ik heb je altijd de waarheid
4 Als ik eens goed aan die boom , zal er wel een kokosnoot uitvallen.
5 jij hier kwaad opzet?
6 Het wel vaker dat hij zijn sleutels nergens
3 Maakte je in opdracht 1 fouten in zinnen f tot h?
a Bekijk in het Kennisoverzicht op p. 410 nog eens goed de theorie over inversie.
b Herschrijf de volgende zinnen tot een ja-neevraag, waardoor je inversie krijgt.
1 Jij benijdt jouw broer om zijn toffe kamer.
2 Jouw moeder kleedt je ’s morgens nog altijd aan.
3 Je besteedt te weinig tijd aan je huiswerk.
4 Jij wordt morgen al 18 jaar.
5 De brandweer redt dat katje uit die hoge boom.
In een gewone, enkelvoudige zin staat eerst het onderwerp en dan het werkwoord Amal kocht een appel voor Thomas.
Ik zing een lied.
Wanneer in een zin de persoonsvorm vóór het onderwerp staat, dan spreek je van inversie. Dat is bijvoorbeeld het geval bij ja-neevragen of wanneer een ander zinsdeel dan het onderwerp vooraan in de zin staat.
Kocht Amal een appel voor Thomas?
Gisteren zong ik een lied.
4 Maakte je in opdracht 1 fouten in zinnen i tot l?
a Bekijk in het Kennisoverzicht op p. 408-409 nog eens goed de theorie over de persoonsvorm in de verleden tijd.
b Vul de correcte vorm van het werkwoord in.
1 Toen ze haar hoofd zo hard (stoten), (belanden) ze in het ziekenhuis.
2 In haar ziekteverlof (volleyballen) ze niet, maar ze (missen) het wel.
3 (bereiden) je die presentatie goed voor?
4 De acteur werd zenuwachtig toen hij hoorde dat een vrouw in het publiek voortdurend (hoesten).
5 Maakte je in opdracht 1 fouten in zinnen m tot q?
a Bekijk in het Kennisoverzicht op p. 408-409 nog eens goed de theorie over het voltooid deelwoord.
b Vul het juiste voltooid deelwoord in.
1 Je ziet eruit alsof je (huilen) hebt.
2 Mijn tante heeft al zeker drie katten uit het asiel (redden).
3 Voor het feestje hadden we de zaal (versieren) met slingers en ballonnen.
4 Ik heb al veel berichten (sturen), maar ze heeft nog geen enkel bericht (beantwoorden).
5 Heb je zo hard (koersen)?
c Markeer de correcte vorm.
1 Het is al eens gebeurt / gebeurd dat hij veel te laat kwam omdat hij een lekke band had.
2 Wie heeft die band dan herstelt / hersteld?
3 Zijn buurvrouw herstelt / hersteld zijn band altijd.
4 Antwoord / Antwoordt nu toch op mijn vraag.
5 Ik antwoord / antwoordt zo meteen, maar ik wil eerst dat jij antwoord / antwoordt op mijn vraag!
6 Wie heeft nu als eerste jouw vraag beantwoord / beantwoordt?
6 Maakte je in opdracht 1 fouten in zinnen r tot u?
a Bekijk in het Kennisoverzicht op p. 410 nog eens goed de theorie over de imperatief.
b Vul de correcte imperatief in.
• (verwachten) er maar niet te veel van.
• (worden) wakker en kom kijken! Het heeft gesneeuwd.
• (beantwoorden) maar eerst dat berichtje.
• (worden) vandaag nog lid en ontvang vijf euro korting!
• (leiden) de mensen maar naar buiten.
7 Maakte je in opdracht 1 fouten in zinnen v tot y?

a Bekijk in het Kennisoverzicht op p. 411 nog eens goed de theorie over de Engelse werkwoorden.

b Markeer de correcte spelling.
1 Luncht / Lunchet hij wekelijks met zijn klanten?
2 Het is interessanter als je die auto least / leaset.
3 Heb je dat bestand al gedownload / gedownloaded?





4 Dat heb je perfect getimet / getimed!
5 Gisteren delete / deletete ik dat bestand per ongeluk!
8 Schrijf een verhaaltje van ongeveer tien zinnen.
a Gebruik daarin minstens vier van de onderstaande werkwoorden (in die vorm).
gebeurd – vertelt – antwoordt – red – houd – wordt
b Kruis nadien voor elk werkwoord aan in welke vorm je het gebruikt hebt.
• gebeurd
persoonsvorm tegenwoordige tijd voltooid deelwoord
persoonsvorm verleden tijd imperatief
• vertelt

persoonsvorm tegenwoordige tijd voltooid deelwoord
persoonsvorm verleden tijd imperatief
• antwoordt
persoonsvorm tegenwoordige tijd voltooid deelwoord
persoonsvorm verleden tijd imperatief
• red
persoonsvorm tegenwoordige tijd voltooid deelwoord
persoonsvorm verleden tijd imperatief
• houd
persoonsvorm tegenwoordige tijd voltooid deelwoord
persoonsvorm verleden tijd imperatief
• wordt

persoonsvorm tegenwoordige tijd voltooid deelwoord
persoonsvorm verleden tijd imperatief
9 Heb je de spellingregels onder de knie? Speel de escapegame en kraak de code van de computer van Mevrouw Ana R. Chie!


1 Zoek in de woordzoeker tien woorden in verband met misdaad en rechtspraak. Schrijf alle woorden die je gevonden hebt op.
NJBHUSHHHEFORENSISCH
CWDTGMEQPKTVOBTNLTBI
LEFPROCEDUREFOUTYRVU
EJCNDFHIOLJPASSBTAEW
DCASSATIECOWLHUUWFRI
RASSISENPROCESPRDBSL
SINETHNPLEIDOOIVILTD
MEDEPLICHTIGBAKWYAEQ
EDZNLJSSGFLZKYOATDKE
TGPROCESVERBAALRSEKW
2 Vul de krantenkoppen en fragmenten aan met woorden uit opdracht 1. Bespreek mondeling de betekenis van de ingevulde woorden.
a Al een van 8 pagina’s, maar man moet nog een keer voor de rechter verschijnen (Het Nieuwsblad )
b Beschuldigde ‘tiramisumoord’ zelfverzekerd op inleidingszitting van
: ‘Ik heb niets te verbergen’ (HLN )
c Man die vrouw op metrosporen duwde, blijft in voorlopige (Het Nieuwsblad )
d Koppel start detectivebureau in Oostrozebeke [..] ‘Mijn man doet al een tijdje digitaal onderzoek’ (VRT NWS )
e Agente die gefilmd werd terwijl ze burgers uitscheldt, gaat vrijuit door (De Standaard )
f Hof van verbreekt gedeeltelijke beslissing om rapper Valtònyc niet over te leveren aan Spanje (HLN )
g De verdenkingen tegen Willem B. […] zijn ‘verzinsels en speculaties’. Dat zei de advocaat van het 34-jarige lid van de inmiddels verboden motorclub Caloh Wagoh vrijdag in zijn (nieuws.nl )
h Nederlander die broek laat zakken voor ogen van vrouw bij veroordeeld (Gazet van Antwerpen)
i Opinie: Nederland is aan dood van duizenden vluchtelingen op zee (De Volkskrant)
j voor 16 fietsers zonder correcte verlichting (PZC )
3 Wie is wie? Omschrijf volgende guren in de rechtspraak in een volledige zin.


de wetsdokter

de jury

de pro-Deoadvocaat
de burgerlijke partij
1 in beroep gaan
2 borgtocht
3 verzwarende omstandigheden
4 minnelijke schikking
5 seponeren
6 voorwaardelijke straf
7 aanhoudingsbevel
8 verzachtende omstandigheden

9 delict
10 verhoor
a strafbaar feit
belementen in een rechtszaak waardoor een beklaagde een lichtere straf kan krijgen
cbetoog van een advocaat in een proces
deen verdachte wordt vrijgelaten uit voorarrest bij betaling van een geldbedrag

e overeenkomst waarbij een verdachte niet verder vervolgd zal worden in ruil voor een geldbedrag
fbeslissing om een strafbaar feit niet te vervolgen
gherbekijken van de zaak na betwisting van de beslissing hperiode waarin een verdachte in de cel wordt gehouden, in afwachting van het proces
ielementen in een rechtszaak waardoor een beklaagde een zwaardere straf kan krijgen
jstraf die uitgevoerd zal worden als de beklaagde zich niet aan bepaalde voorwaarden houdt
kondervraging van een verdachte of getuige lofficiële beslissing om een verdachte te arresteren
123456789 10
1 Bekijk onderstaande krantenkoppen. Welke passen bij jouw gevoel of ideeën over e-sigaretten? Markeer ze en bespreek met een medeleerling.
E-sigaret in het Engelse basispakket om roken tegen te gaan
E-sigaret moet beter gereguleerd worden, volgens WHO
Vapen heeft in België onterecht slechte reputatie
Onderzoekers slaan alarm: ‘De e-sigaret is zeker niet ongevaarlijk’
Belg van 18 mogelijk gestorven na roken e-sigaret
E-sigaret toch minder schadelijk dan tabak
2 Bekijk het fragment van het programma Volt over e-sigaretten. Maak op de volgende pagina notities bij dit fragment. Neem de tips voor leren noteren nog eens door voordat je de video bekijkt.
Leren noteren
• Kort af. Schrijf geen volledige zinnen, maar gebruik afkortingen en symbolen. Woorden zoals ‘het’ en ‘een’ zijn overbodig.
• Structureer. Maak opsommingen, gebruik tegenstellingen en geef verbanden weer tussen verschillende delen in je notities.
• Herformuleer. Geef de informatie weer in je eigen woorden en neem geen zinnen volledig over.
• Prioriteer. Spelling is minder belangrijk in je notities. Zorg vooral dat je de juiste informatie hebt overgenomen.
• Anticipeer. Laat voldoende witregels open om nieuwe informatie toe te voegen aan bepaalde delen in je notities.
• Herhaal. Bekijk het fragment nogmaals en vul aan met informatie die je eerst over het hoofd zag.
3 Vergelijk jouw notities met die van een medeleerling. Zoek naar een duidelijk verschil tussen jullie notities. Vul je eigen voorbereiding aan waar nodig.

Volt: e-sigaretten – mijn notities
4 Test de volledigheid van je notities. Beantwoord onderstaande vragen over het fragment.
a Wat maakt de e-sigaret over het algemeen gezonder?
b Welke persoonlijke voordelen van de e-sigaret haalt Serge aan in het fragment?
c Hoe test Tatjana de theorie dat een e-sigaret gezonder is?
5 Bekijk onderstaande soorten schema’s. Welk schema heeft jouw voorkeur om de informatie van het fragment te structureren? Leg uit met twee goede argumenten.



A mindmap B tijdlijn
C Cornell-methode D boomschema
titel
kernwoorden informatie
samenvatting
Volt:
7 Is alle informatie die de sprekers toevoegen betrouwbaar?
a Geef de sprekers een aantal sterren op basis van hun betrouwbaarheid.
b Motiveer je keuze met een duidelijk argument per spreker.
bron beoordeling
Luisteren: dictee voor BV’s
Je bekijkt een fragment uit het programma Terzake waarin drie bekende Vlamingen aan een dictee onderworpen worden. Deze BV’s zijn radiopresentator Tom De Cock, tv-presentatrice Ihsane Chioua Lekhli en en Ben Weyts die ten tijde van het dictee Vlaams minister van Onderwijs was.
1 Hoe staan de deelnemers tegenover taal?
• Tom De Cock:
• Ihsane Chioua Lekhli:
• Ben Weyts:

2 Welke drie principes volgt de Nederlandse spelling?

3 In hoeverre speelt ons geheugen een cruciale rol bij het spellen van woorden?
4 Geef een voorbeeld van een onlogische spelling in de Nederlandse taal.
5 Kunnen we dan beter alle uitzonderingen op de spelregels afscha en?
6 Wanneer moeten we ons zorgen maken bij spelfouten?

1 Bekijk de foto’s van deze vier performers.



a Ken je een of meerdere van deze mensen? Wie?
b Welk taalgebruik verwacht je bij elke persoon?

c Hoe staan deze performers op het podium? Wat verwacht je van hun gebaren, bewegingen, gelaatsuitdrukkingen en stemgebruik?


Je leerkracht toont je nu een beeldfragment. Je bekijkt het een eerste keer en let bij het kijken op de boodschap.
2 Waarover gaat het fragment? Beschrijf de inhoud in één zin.
3 Wat is het doel van de voorstelling? Wat wil de performer bij het publiek bereiken?
4 Beschrijf het taalgebruik van deze persoon.
a Is dit standaardtaal, dialect of tussentaal? Welk register (formeel, neutraal, elitair, vulgair, vriendschappelijk) wordt er gebruikt?
b Kwam de performance overeen met de voorspellingen die je deed? Ga in op twee concrete voorbeelden.
Een register is een bepaalde manier van spreken of schrijven, die verschilt per context (de relatie tussen de gesprekspartners, de ernst van de aangelegenheid, de sociale afstand, de status van de spreker …)
• Elitair taalgebruik is taalgebruik dat vaak academisch van aard is; een rijke, gevarieerde taal met moeilijke woorden die vaak ook archaïsch zijn of ontleend worden aan andere talen (Grieks, Latijn, Frans). De spreker wil met zijn/haar taalgebruik aantonen dat hij/zij hoogopgeleid is.
urineren
• Formeel taalgebruik is taalgebruik bij officiële situaties of wanneer er een (grote) hiërarchische of sociale afstand tussen de gesprekspartners is (bv. directeur-werknemer). wateren
• Neutraal taalgebruik is taalgebruik in de dagelijkse omgang tussen gelijken die elkaar niet of niet goed kennen.
naar het toilet gaan
• Vriendschappelijk/informeel taalgebruik is taalgebruik in de dagelijkse omgang tussen kennissen en vrienden, spreektaal.
plassen
• Vulgair taalgebruik is grof, plat, ordinair taalgebruik. pissen/zeiken
5 Bij een monoloog staat één acteur op het podium. Hij spreekt zijn publiek rechtstreeks aan.
a Hoe kun je van dit voorbeeld een dialoog maken?
b Blijft de tekst daardoor even krachtig, wordt hij sterker of zou de tekst aan kracht verliezen?
c Welke onderwerpen lenen zich het meest tot een monoloog? Wat past er eerder bij een dialoog?
6 Een geslaagde monoloog begint met een sterke tekst. Bedenk samen met een medeleerling minstens drie elementen die belangrijk zijn voor de tekst.
7 Vergelijk je antwoord bij opdracht 6 met het volgende fragment. Geeft de auteur nog extra kenmerken die niet in je eigen suggesties staan? Markeer ze in de tekst.





Het geheim van de monoloog
Voor ze aan een monoloog beginnen, moeten schrijvers heel duidelijk weten wie hun personage is. Het karakter moet tot de verbeelding spreken en de aandacht trekken. Vervolgens moet duidelijk zijn wat de persoon wil vertellen, wat de waarde is voor het stuk. Er moet een spanning ontstaan in wat het personage uitlegt. Blijf voor deze spanning in het hier en nu: iets wat op dit moment met een personage gebeurt, is veel spannender dan een verhaal dat achteraf verteld wordt. Probeer in een monoloog zo helder en beeldend mogelijk te zijn. Ook is het heel belangrijk te bepalen hoe het personage spreekt, wat haar of zijn stem en taal zijn. Een geschreven monoloog verandert namelijk onmiddellijk op het moment van uitspreken. Beginnende schrijvers vertrekken vaak vanuit hun eigen persoon, maar dit levert meestal geen overtuigende resultaten op.
Monologen komen in toneelstukken voor op het moment dat een personage zijn standpunt moet verduidelijken of een actie moet uitleggen. Daarom moeten schrijvers hun personage verschillende gevoelens of gedachten meegeven. Elk gevoel en elke gedachte brengt het verhaal een stap verder. Er ontstaat dan een ritme dat de monoloog naar een climax toebrengt. Het einde van een monoloog is van groot belang en geeft een antwoord op de vraag waar het personage mee worstelt.

Als een acteur op het podium een monoloog opvoert, dan kan hij gebruikmaken van de volgende technieken:
8 Verbind die termen met de juiste synoniemen.
mimiek
gestiek


















Gregory Crewdson is een fotograaf uit New York. De kunstfoto’s die hij neemt, lijken eigenlijk meer op schilderijen. Crewdson werkt met een team van veertig mensen en doet er weken over om locaties te kiezen, sets op te bouwen en de uiteindelijke foto te nemen. Dat komt omdat hij in elk resultaat onnoemelijk veel details stopt die je kunt lezen als aanwijzingen en hints. Ze doen je allerlei zaken vermoeden en laten je toe om een verhaal te bouwen, zonder volledig te zeggen wat er nu precies gebeurd is of wie de mensen op de foto zijn. Dat is het sterke, maar ook het moeilijke aan zijn foto’s.







Voor deze creatieve spreekopdracht vertrek je van één van Crewdsons kunstwerken. Aan de hand van het stappenplan schrijf je een monoloog bij één van de personages uit de afbeeldingen.
1 Bekijk de foto’s op p. aandachtig en kies er één uit.
2 Schrijf heel kort voor jezelf op waarom je die foto kiest.
• Is er een detail dat je aanspreekt?
• Zit er een bepaalde sfeer in?
• Herken je elementen in de foto?
• Kun je je inleven in een van de personages (of net niet)?
3 Maak een lijst van allerlei details die je ziet. Probeer de foto te lezen als een tekst: begin linksboven en ga met je ogen zo over het beeld alsof je tekst van een beeldscherm leest. Bekijk de foto een aantal keren en som de voorwerpen op die je ziet.
4 Focus nu op de personages in de foto en stel jezelf de volgende vragen:
• Hoe oud zijn ze?
• Zijn ze arm of rijk?
• Hebben ze een bepaald beroep?
• Zijn ze onderweg? Vluchten ze van iets weg of lopen ze net naar iets toe?
• Hoe voelen ze zich op dit moment?
• Zeggen ze iets of staan ze bij zichzelf te denken?
• Hebben ze net iets meegemaakt of staat hen iets te wachten?
5 Onderstreep in je lijst bij stap alle elementen die te maken hebben met het decor van de foto. Beantwoord daarna de volgende vragen.
• Speelt de scène zich af in een stad, in een dorp of op het platteland?
• Vinden de gebeurtenissen plaats in België, Europa, Amerika, Azië of elders in de wereld?
• Komt de plaats over als chic of net niet?
• Past het decor bij de personages die je ziet?
• Zie je elementen die niet op hun plaats zijn in deze context?
6 Kruip nu in het hoofd van één van de personages uit de foto’s van Gregory Crewdson. Gebruik de antwoorden die je bij stappen en gaf om een verhaal rond de foto te bouwen. Je mag vertellen wat er voor de scène gebeurd is of net uitwerken hoe de scène zal aflopen. De foto kan met andere woorden helemaal vooraan in je verhaal zitten, maar evengoed in het midden of aan het einde.
7 Je monoloog duurt minimaal twee minuten en sluit duidelijk aan bij de foto. Overloop de evaluatiematrix op p. , daarin vind je alle evaluatiecriteria voor deze opdracht.
8 Eerder in deze les analyseerde je een monoloog. Je ging in op de kenmerken en paste ze toe op een beeldfragment.
a Bekijk de elementen nog een keer. Je vindt ze terug bij opdrachten en op p. -.
b Ga na welke kenmerken je kunt gebruiken om jouw personage vorm te geven.
9 Oefen je monoloog hardop.
10 Overloop de monologen die je medeleerlingen en jij naar voren brachten.
a Welk verhaal is je het meest bijgebleven? Beschrijf concreet waarom dit verhaal je aandacht trok.
b Welke opvoering vond je sterk? Geef twee concrete elementen uit het taalgebruik, de mimiek, de gestiek of het ruimtegebruik van deze medeleerling.
Je monoloog duurt minimaal twee minuten en het verhaal eindigt in een climax: het eindpunt geeft duidelijk weer waar je personage mee worstelt.
Je kiest voor een register dat aansluit bij het personage dat je naar voren brengt. Je taalgebruik is consequent en geeft het personage vorm.
gepastheid
Het tempo van je monoloog past bij de boodschap van het personage. Je lichaamstaal en gelaatsuitdrukkingen ondersteunen de tekst.
Je vertelt de monoloog met intonatie. Bovendien bevat je verhaal geen storende overgangen of te lange pauzes.
De monoloog sluit duidelijk aan bij één van de foto’s. De gedachten in het eindresultaat vertellen een samenhangend verhaal.
De spanning speelt zich af op het vertelmoment: je personage heeft net iets gedaan, staat op het punt om een actie te ondernemen of beschrijft zijn gedachten en gevoelens van het moment zelf.
Aanvullende commentaar:
Je monoloog duurt twee minuten en heeft een duidelijk eindpunt. Je schetst echter niet helemaal duidelijk welk probleem, welke vraag of welk dilemma het personage heeft.
Je kiest de hele monoloog voor hetzelfde register, maar dit kan eigenlijk bij heel wat personages horen. Het taalgebruik dat je kiest, kleurt je personage niet.
Je boodschap is verstaanbaar. Je gebruikt je lichaamstaal en gelaatsuitdrukkingen om je tekst te ondersteunen. Die elementen drukken de boodschap uit, maar bouwen het personage niet uit.
Je verhaal bevat geen te lange pauzes of storende overgangen. Je probeert ook variatie in je stemgebruik te brengen.
De monoloog sluit duidelijk aan bij één van de foto’s. De kern van je boodschap is duidelijk, maar het verhaal is moeilijk te volgen.
Het verhaal is spannend, maar focust niet op de gedachten en gevoelens op één bepaald moment. Je schetst de gebeurtenissen chronologisch door de ogen van het personage.
Je monoloog is te kort.
Je wisselt van register in de loop van je monoloog. Het taalgebruik past niet bij je personage.
Je praat te snel of te traag. Je lichaamstaal en gelaatsuitdrukkingen leiden de kijker af van de boodschap.
Je gebruikt geen intonatie om je boodschap aantrekkelijk naar je publiek te brengen. EN/OF Je verhaal bevat te lange pauzes of storende overgangen.
Het is niet duidelijk bij welke foto je verhaal hoort.
Je verhaal geeft een situatieschets van het personage zonder in te gaan op gedachten, gevoelens en keuzes. Het verhaal is niet spannend.
3

Er staan drie witte koelkasten. Wat is de kleur van de eerste koelkast?
En de tweede?
En de derde?
En wat drinkt een koe?
Het is een bekend mopje. De meeste mensen antwoorden op de laatste vraag dat een koe melk drinkt, wat natuurlijk niet klopt. Maar als je net drie keer ‘wit’ gezegd hebt, zullen onze hersenen bij ‘koe’ sneller ‘melk’ zeggen dan ‘water’.
Elke mens heeft een mentaal lexicon. Alle woorden die we ons vanaf onze babytijd eigen maken, worden erin opgeslagen. Binnen het mentaal lexicon hangen woorden en hun eigenschappen onderling samen. Zo ontstaat er een soort netwerkje waarbij woorden (door hun betekenis, klank of een andere relatie) aan elkaar vasthangen.
In zo’n netwerkje zal ‘wit’ sterk verbonden zijn met ‘melk’, vandaar dat veel mensen zo snel ‘melk’ antwoorden als ze eerst aan een witte koelkast dachten.
koe wit zomer diepvriezer
hagel herfst lente
sneeuw winter
regen melk ijskast ijsjes
2 Teken nu op een apart blad een netwerk met woorden die je met ‘rood’ associeert.
3 Vergelijk jouw netwerk met dat van een medeleerling. Wat stellen jullie vast?
4 Op basis waarvan zouden de volgende woorden met elkaar geassocieerd kunnen worden? Kun je het rijtje aanvullen?
a korrelhagel – nevel – tornado – warmtefront –
b spel – wedstrijd – game – potje –
c aquaduct – aquarium – aquarel – aquagym –
5 Breng orde aan in deze woordenvloed: markeer de woorden die iets met elkaar te maken hebben in dezelfde kleur.
6 Vergelijk jouw ordening met die van je medeleerlingen. Maakten jullie dezelfde indeling? Waarom (niet)?
7 Van welke woorden ken je de betekenis (nog) niet? Gebruik de woordleerstrategieën om de betekenis te achterhalen.
Om de betekenis van woorden te achterhalen kun je een aantal woordleerstrategieën gebruiken. Zo kun je de betekenis van het woord vanuit de context verklaren. Je bekijkt afbeeldingen, je zoekt synoniemen, tegenstellingen of voorbeelden in de zinnen voor of na het onbekende woord. Soms wordt het woord ook in de tekst verklaard.
Omdat de drie gevangenen in detentie werden geplaatst, mochten ze niet deelnemen aan de dagactiviteiten en moesten ze hun maaltijd in afzondering opeten.
Door de context van de gevangenis en de extra uitleg na de komma begrijp je waarschijnlijk wat detentie betekent.
Je kunt nagaan of het woord lijkt op een woord dat je kent uit een anderetaal. Als je het woord in de vreemde taal begrijpt, zul je ook gemakkelijker de betekenis ervan kennen in het Nederlands.
Bij het horen van educatief verlof, kun je denken aan het Franse éducation of het Engelse to educate

Hoewel je het woord detentie niet dagelijks zult gebruiken, ken je uit een film of songtekst zeker détention of detention

Woorddelen kunnen je ook helpen. Denk na wat de afzonderlijke delen van een woord betekenen. Misschien ken je er een van.
soepgroente: groente die in de soep verwerkt wordt groentesoep: soep gemaakt met verschillende groenten
Begrijp je een woord niet, vind je de betekenis niet in de tekst en lukt het ook niet om de betekenis te achterhalen door het woord te ontleden? Gebruik dan een (online) woordenboek
Als je de betekenis zelf niet kunt vinden, dan vraag je de betekenis aan iemand die het woord wel begrijpt.
1 In welke situatie ben jij onlangs nog nieuwe woorden tegengekomen?
2 Sla een boek of cursus open en bekijk een willekeurig hoofdstuk dat je nog niet gezien hebt. Of ga naar een nieuwswebsite en lees daar om het even welk artikel. a Je krijgt drie minuten om zo veel mogelijk woorden op te schrijven die je nog niet kent.


b Wie verzamelde de meeste woorden?
c Waren de woorden voor iedereen even onbekend?
d Wat doe je om de betekenis van moeilijke woorden te achterhalen?
e Welke woorden die jullie in de opdracht tegenkwamen, vinden jullie belangrijk om te onthouden? Waarom?
Als we een nieuw woord aanleren, verbinden we dat nieuwe woord aan een woord dat we al kennen: ‘klimaatspijbelaar’ hangen we in onze hersenen als een kapstokje vast aan ‘klimaat’ en ‘spijbelen’.
3 Als je een nieuwe taal leert, kom je voortdurend met nieuwe woorden in aanraking. Bekijk het lmpje van Hasan. Wat vind je van zijn manier om nieuwe woorden te leren? Zou het voor jou ook werken? Waarom (niet)?
Reclamemakers kennen het mentale lexicon maar al te goed.
1 Met welke woorden is ‘groen’ verbonden in jouw mentale lexicon?


2 McDonald’s veranderde jaren geleden haar logo van rood-geel naar groen-geel. Kun jij uitleggen waarom?


3 Ook Coca-Cola wil graag dat je haar producten associeert met bepaalde waarden. Welke?

4 Ken je zelf nog reclames waarbij men jou het merk wil laten associëren met bepaalde waarden? ONTHOUDEN
Als je een consument wilt overtuigen om een product te kopen, moet je vooraf nadenken over de woorden, gevoelens, kleuren waarmee de consument dat product zal associëren. We spreken van priming als iemand onbewust beïnvloed wordt door woorden, beelden of kleuren die gebruikt worden.


5 Maak nu zelf een minicampagne waarbij je uitgaat van priming.
STAP 1


Kies een product dat je aan de man wilt brengen.
STAP 2
Maak rond het product een netwerk van woorden en beelden die je met dat product associeert.
STAP 3
Zoek een origineel beeld en/ of schrijf een creatieve slogan/ tekst waarbij je (een van) de woorden uit stap 2 gebruikt.
Het is duidelijk met welke waarden je je product wilt verbinden, zonder dat je het er te dik oplegt.
Het is duidelijk met welke waarden je je product wilt verbinden.
Het is niet erg duidelijk met welke waarden je je product wilt verbinden.
De waarde die je aan je product wilt koppelen, is logisch en origineel.
De waarde die je aan je product wilt koppelen, is logisch.
Het beeld / de slogan is goed gekozen en ondersteunt de boodschap die je wilt geven.
Aanvullende commentaar:
De link tussen het beeld / de slogan en de waarde die je aan je product wilt verbinden, is niet logisch of niet duidelijk.
De waarde die je aan je product wilt koppelen, is niet logisch of te vanzelfsprekend. Je zorgt voor een origineel beeld / originele slogan. Het sluit perfect aan bij de waarden die je aan je product wilt verbinden.
1

Je leest en bespreekt twee Middelnederlandse ridderromans: Karel ende Elegast en Walewein

Je analyseert het verschil tussen Karelromans en Arthurromans










Je kent de kenmerken van de Karelroman, de Arthurroman en de queeste
In de middeleeuwen lazen mensen geen verhalen; ze luisterden ernaar. Verhalen werden van generatie op generatie doorverteld in familieverband of gezongen door beroepsvertellers, de zogenaamde troubadours. Pas vanaf de e eeuw werden verhalen ook opgeschreven in de volkstaal. Vooral de ridderromans waren bijzonder populair.

Misschien zijn bepaalde elementen uit die ridderverhalen je niet vreemd. Veel films, stripverhalen en animatieseries verwijzen naar verhalen en personages uit die verteltraditie.

1 Test jezelf en ontdek of jij de slimste ridder of jonkvrouw van de klas bent.


De meeste middeleeuwse ridderverhalen spelen zich af aan het hof van koning Karel de Grote of aan dat van koning Arthur. Verdiep je in beide entourages en kies vervolgens de koning die jij wilt dienen.
Eerst verken je de Middelnederlandse klassieker Karel ende Elegast. Je bekijkt en bespreekt een moderne bewerking van het verhaal en ontdekt zo de belangrijkste elementen uit een Karelroman.



Je bekijkt het verhaal Karel ende Elegast van Helden in harnas
1 Wat vind je van dit verhaal/ lmpje?








2 Heb je aandachtig geluisterd? Lees de korte samenvatting van het verhaal nog eens en ontdek de vijf fouten.
Op de avond voor de hofdag krijgt keizer Karel in zijn kasteel te Ingelheim bezoek van een tovenaar, die hem niet één, maar drie keer beveelt om te gaan stelen. Eerst is hij op zijn hoede, maar de drievoudige herhaling van de boodschap overtuigt hem dat de boodschap van God komt. Hij gehoorzaamt en gaat op dievenpad. Waarom hij deze opdracht krijgt van God? Daarover tast hij (en met hem de lezer) in het duister. Het enige wat hij weet, is dat het een zaak van leven of dood is.
In het woud ontmoet hij een groene ridder. Die ridder blijkt Elegast te zijn, een vazal die hij ooit te zwaar gestraft heeft voor een klein vergrijp. Toch lijkt Elegast nog steeds trouw aan zijn vroegere leenheer, de koning. Karel stelt zich voor als Albert, dief van beroep. Elegast herkent hem niet. Wanneer Karel vervolgens voorstelt om gezamenlijk bij de koning in te breken – bij zichzelf dus –weigert Elegast verontwaardigd.
Ze besluiten dan maar naar Eggermonde te gaan, de burcht van Karels schoonbroer Eggeric. Met een ploegijzer maakt Elegast een gat in de muur. Hij wil de burcht binnendringen, maar wordt door een haan gewaarschuwd dat de koning buiten de slotpoort staat. Albert (Karel) verplicht hem echter om hun plan te voltooien en Elegast gehoorzaamt. In Eggerics slaapkamer wil hij een schaakbord stelen en hoort hij een ruzie tussen Eggeric en zijn echtgenote, Karels zus. Wanneer Eggeric vertelt dat hij Karel wil doden, protesteert zijn vrouw. Eggeric wordt kwaad en snijdt haar tong af. Elegast is getuige van dit alles en brengt Albert (Karel) op de hoogte van het moordcomplot.
Eens terug aan het hof, treft Karel maatregelen. Bij hun aankomst op de hofdag worden Eggeric en zijn trawanten aangehouden. Eggeric daagt Elegast uit om in een toernooi uit te maken wie de waarheid spreekt – God zal oordelen wie wint. Elegast wint dit gevecht en – jawel – ook de hand van de zuster van de koning, Eggerics weduwe.
Naar: literairecanon.be (De literaire canon is een initiatief van de Koninklijke Academie voor Nederlandse Taal en Letteren (KANTL), met de steun van Literatuur Vlaanderen.)





Het verhaal beleven
3 Welke rol speelt de vrouw in dit verhaal?
4 Klopt dat met het beeld dat je hebt van ridders en vrouwen?
5 Wat leert Elegast ons over het gedrag van een goede ridder?
6 In de middeleeuwen speelde het geloof een grote rol in het dagelijkse leven. God had een grote impact op het leven van alle dag (= theocentrisme). Hoe zie je dat in dit verhaal?
7 De middeleeuwse, feodale maatschappij was gebouwd op de trouw tussen een leenheer en zijn vazal (= feodaliteit). Hoe zie je dat in dit verhaal bij Elegast en bij Eggeric?
Beluister het begin van de moderne bewerking nog even en leg er de oorspronkelijke verzen van Karel ende
Elegast eens naast.
1 Vraye historie ende al waer
Machic u tellen hoert naer
Het was op enen auontstonde
Dat karel slapen begonde
5 Tengelem op den rijn
Dlant was alle gader sijn.
Hi was keyser ende coninc mede.
Hoort hier wonder ende waerhede
Wat den coninc daer gheuel
10 Dat weten noch die menige wel
Tenghelem al daer hi lach
Ende waende op den anderen dach
* Wil ik
* te Ingelheim: Karels kasteel
* gebeurde
* De volgende dag zou Karel hofdag
Crone draghen ende houden hof houden in zijn functie als koning.
Om te meerderen sinen lof
15 Daer die coninc lach ende sliep
Een heilich engel aen hem riep
So dat die coninc ontbrac
Biden woerden die dengel sprac
Doet haestelike u cleder an,
20 Wapent u ende vaert stelen
– God die hiet mi u bevelen, Die in hemelrike es Here –

Of ghi verliest lijf ende ere.
En steeldi in deser nacht niet,
25 So is u evel gheschiet
Ghi sulter omme sterven

Ende uwes levens derven
Eer emmer scheit dit hof.
* wakker worden
* zal het u slecht vergaan
* verliezen
* nog vóór
9 Wat valt er jou op aan de taal van het origineel?
Karel ende Elegast is een typisch voorbeeld van een Karelroman. Karelromans gaan over historische feiten of personen. Ze spelen zich af rond de figuur van Karel de Grote, koning der Franken. Hij leefde van tot en werd in tot keizer van het Westen gekroond. Deze vorst stond bekend als het toonbeeld van rechtvaardigheid en wordt beschouwd als de vader van Europa omdat hij een immens rijk wist uit te bouwen.

De ridderverhalen gaan over helden die ten strijde trekken. Daarbij zijn de thema’s dapperheid, strijdlust, wraak, eer en trouw aan de vorst duidelijk herkenbaar. Ook christelijke motieven (bidden, de aanwezigheid van engelen, de inmenging van God op aarde) zijn duidelijk herkenbaar.

Vrouwen en liefde spelen in dit soort verhalen een totaal ondergeschikte rol, als ze al voorkomen. De aandacht gaat in de eerste plaats naar het vechtlustige, het heldhaftige.

Heel wat andere ridderverhalen spelen zich af aan het hof van koning Arthur, zoals Walewein en het vliegende schaakbord
1 Beluister de korte inhoud van het verhaal. Noteer tijdens het luisteren onder elke afbeelding een korte samenvatting.






2 In Karel ende Elegast was Elegast een toonbeeld van trouw. Is Walewein dat ook?




3 Merk je gelijkenissen en/of verschillen in de structuur of de opbouw van dit verhaal en Karel ende Elegast?
4 Welke plaats krijgen God en bijgeloof of magie in dit verhaal?

Tijdens zijn zoektocht valt Walewein van het ene avontuur in het andere. In India neemt koning Assentijn Walewein gevangen. Al blijkt dat niet zo erg te zijn … In de kerkers van het kasteel beleeft hij ‘een avontuurtje’ met de beeldschone dochter van de koning, prinses Ysabele.


Ysabele zei: ‘Heren, ik zou mij graag willen wreken op deze ridder, die van plan was mijn vader leed te berokkenen. Of het me daarbij goed of slecht vergaat, ik moet mijn woede op hem koelen; maar ik zou het vervelend vinden, als openlijk bekend zou worden dat ik, een jonkvrouw, een ridder zo zwaar zou pijnigen. Ga daarom terug, heren, want het betaamt niet dat u toekijkt, want ik zal hem heel zwaar pijnigen – dat zeg ik jullie maar meteen.’
Zo keerden de ridders snel langs dezelfde weg uit de kerker terug, en toen ze buiten waren liet jonkvrouw Ysabele de kamer snel en stevig afsluiten.
Twee trouwe en goede kameniers had Ysabele toen bij zich, die haar altijd in alle omstandigheden in uiterste discretie dienden.
Ze had geen zin in muizenissen en wanneer het haar toescheen dat ze wisten wat er aan de hand was, liet ze alle kommer achter zich, nu ze haar lieve vriend bij zich heeft, in haar macht. Er was op de hele wereld geen jonkvrouw die zo hartstochtelijk en zo vurig van een ridder hield als zij van heer Walewein.
Wees er maar zeker van dat de mooie jonkvrouw op niets anders uit was dan zich met heer Walewein te vermaken.
Ze wist dat ze daar veilig was en dat ze geen angst hoefde te hebben.
Zonder aarzelen liep ze naar heer Walewein toe, die daar op de grond lag. Als haar schroom haar toen niet had afgeremd, dan had ze de beroemde ridder onmiddellijk omhelsd en met kussen overdekt. Met moeite heeft ze zich toen ingehouden en de edele man onmiddellijk losgemaakt.
Heer Walewein, die zich hoofs weet te gedragen, zei meteen: Ach mooie jonkvrouw, wat wordt het?
Zal ik sterven of leven?


Als ik sterf, dan zal ik u mijn ziel geven, schone jonkvrouw. Neemt u mijn leven, dan wil ik in zoete pijn sterven in uw schoot.’
De jonkvrouw sprak: ‘Heer, ik zal u de dood niet brengen.
Integendeel, als ik kon, dan zou ik u onmiddellijk helemaal bevrijden uit de gevangenis van mijn vader. Zoals het er nu voorstaat, weet ik ook wel hoe ik u binnenkort uit dit alles kan bevrijden.’
De jonkvrouw nam hem bij de hand, deed hem onmiddellijk overeind komen en leidde hem toen meteen naar een belendende kamer. Nooit was er op aarde zo’n mooie kamer of een die met evenveel meesterschap was gemaakt: ze blonk van het goud en schitterde oogverblindend.
Vertaling: Frank Willaert







5 Wat is Ysabele van plan? Hoe slaagt ze daarin?
6 Vergelijk de rol van Ysabele met die van de zus van Karel in Karel ende Elegast

Ysabele zus Karel
7 Walewein wordt hier omschreven als ‘hoofs’. Wat wil dat zeggen, denk je?
8 Koning Arthur krijgt een boodschap van God: hij moet de Heilige Graal halen uit het kasteel van koning Wonder. Maar hij is nog verzwakt van zijn laatste zwaardgevecht, dus draagt hij jullie, ridders van de Ronde Tafel, op om samen op queeste te gaan. Kunnen jullie de Heilige Graal naar kasteel Camelot brengen?

Walewein is een typisch voorbeeld van een Arthurroman. Arthurromans spelen zich af rond de legendarische koning Arthur en de ridders van de Ronde Tafel. Of die vorst echt heeft bestaan, is twijfelachtig. Hij zou een Keltische legeraanvoerder uit de e eeuw zijn geweest.

In vergelijking met de Karelromans is de sfeer in deze verhalen anders. Eer, trouw en moed in het gevecht blijven nog altijd belangrijke ridderlijke deugden, maar daarnaast hoort een echte ridder zich te beheersen, zich verfijnd te kleden en te dansen. Hij moet tafelmanieren hebben en een beleefde conversatie kunnen voeren.
Ook de positie van de vrouw is sterker in deze romans en een ridder doet er alles aan om haar te beschermen én haar liefde te winnen. Om die sfeer te beschrijven, wordt vaak het woord ‘hoofs’ gebruikt. ‘Hoofs’ heeft een dubbele betekenis: ‘zoals aan het hof’ en ‘hoffelijk’.
In heel wat ridderverhalen gaat een ridder op queeste.
1 Wat zou dat woord kunnen betekenen?
Een zoektocht of een queeste was een populair thema in de middeleeuwse Arthurverhalen. De meeste ridders gingen op zoek naar een voorwerp (bv. de Heilige Graal of een magisch voorwerp) of naar een persoon of dier. Tegelijkertijd kun je die queeste ook lezen als een zoektocht naar volwassenheid. De verhalen geven immers telkens het verslag van een leerproces: een jongeman legt een hele weg af om een volwassen en hoofse ridder te worden.
Een queeste verliep altijd volgens een vaste structuur.
• Orde: er heerst rust en vrede aan het hof.
• Oproep: de rust wordt verstoord.
• Queeste: er zijn tal van beproevingen en avonturen
- met helpers;

- en een beloning.
• Terugkeer: de orde is hersteld.
2 Pas de queestestructuur toe op deze tocht van Walewein.
Walewein en het vliegende schaakbord orde oproep queeste
• helpers
• beloning
terugkeer
3 In de volgende opdracht ga je op zoek naar een recente lm of serie met een queestestructuur. Vind je niet onmiddellijk een goede titel, bekijk dan zeker eens de suggesties van Knight ix op de pagina hiernaast.
In heel wat hedendaagse (avonturen)films en series vind je de queestestructuur terug. Denk bijvoorbeeld aan het verhaalverloop in Game of Thrones, Star Wars, Mandalorian, Shrek, The Lord of the Rings
1 Kies een lm of serie waarin je de queestestructuur herkent.
2 Maak een kort lmpje (maximaal vijf minuten) waarin je de onderdelen van de queeste in jouw lm/serie bespreekt en ze vergelijkt met de typische elementen van een Arthurroman.
3 Bedenk een originele intro en een passend slot voor je presentatie.







4 Vul als voorbereiding het schema hieronder in.
Film nu jouw analyse en mail het filmpje naar je leerkracht voor





















- Je vat in een paar zinnen samen waarover jouw film/ serie gaat.
- Je bespreekt bondig de verschillende onderdelen van de queeste.
- Je verwijst in je bespreking naar de typische elementen van een Arthurverhaal en/ of vergelijkt met andere verhalen.
- Je tekst start met een leuke intro en eindigt met een passend slot.
- Je presentatie is goed gestructureerd. Je gebruikt onder andere signaalwoorden.
Niet alle onderdelen worden even sterk uitgewerkt. Je besteedt te weinig aandacht aan:
- de korte inhoud;
- de onderdelen van de queeste;
- vergelijkbare elementen uit andere Arthurverhalen.
- Je presentatie mist een sterk begin of slot.
- Je presentatie kan meer gestructureerd worden.
- Je spreekt vlot, verstaanbaar en met intonatie.
- Je taal is verzorgd en bevat geen taalfouten.
- Je non-verbale communicatie (houding, gebaren …) versterkt de presentatie.
- Je filmpje is visueel aantrekkelijk.
Aanvullende commentaar:
De volgende aspecten van je spreken kunnen beter:
- Je praat te snel / te traag.
- Je gebruikt te weinig intonatie.
- Je taal klinkt niet zo verzorgd.
- Je maakt taalfouten.
- Je houding / het visuele kan beter.
De analyse/inhoud van jouw presentatie is onvoldoende.
- Je presentatie is weinig creatief.
- Je presentatie heeft weinig structuur.
- Je presentatie is niet aangenaam om te volgen.
- Je taal en houding liggen ver onder de verwachtingen.
In 2021 verscheen The Green Knight in de filmzalen, een bewerking van de middeleeuwse ridderroman Heer Gawein en de Groene Ridder. Die Gawein is gewoon een andere, vertaalde naam voor Walewein. (In het Engels werd Walewein ‘Gawain’.)

1 Bekijk eerst de trailer van de lm en lees de korte inhoud van het verhaal. Beantwoord daarna de onderstaande vragen.
Op nieuwjaarsdag arriveert in Camelot een reusachtige, groene ridder: volledig in het groen gekleed, maar ook met groen haar en een groene huid. Ook zijn paard is groen. Hij daagt de aanwezigen uit hem met zijn bijl een slag toe te brengen. In ruil daarvoor vraagt hij het recht om over een jaar en een dag terug te slaan. Gawein/Walewein, de jonge neef van de koning, accepteert de uitdaging en hakt de Groene Ridder het hoofd af. Deze pakt zijn hoofd op en beveelt Gawein/Walewein om hem over een jaar en een dag bij de Groene Kapel te ontmoeten, waar hij hem zal onthoofden. Hierop rijdt de Groene Ridder het kasteel uit. De dag na Allerheiligen gaat Gawein op weg, op zoek naar de Groene Kapel …
2 In dit verhaal legt Walewein als jongeman een hele weg af om een volwassen en hoofse ridder te worden. Wat zoekt hij – volgens de trailer – vooral op deze tocht?
3 Naast heel wat christelijke elementen bevatten ridderverhalen vaak ook heidense elementen (magie, bijgeloof). Welke voorbeelden zie je in de trailer?
4 Hoe denk je dat het verhaal a oopt voor Walewein?


Je leest zo dadelijk het artikel Dit is het vuilste plekje in een vliegtuig op de volgende pagina.
1 Wat is volgens jou het vuilste plekje in een vliegtuig?
2 Lees nu de inleiding van het artikel en vul het juiste woord in.
3 Lees de rest van het artikel en beantwoord onderstaande vragen mondeling met een medeleerling.
a Wat is vreemd genoeg niet het vuilste plekje in een vliegtuig?
b Hoe komt het dat er op een klaptafel veel bacteriën te vinden zijn?
c Wat hopen de onderzoekers met dit resultaat te bereiken?
4 Een alinea bevat steeds een kernzin. Vul onderstaande tekst over kernzinnen aan met de juiste woorden. Om je op weg te helpen, is de eerste letter van de woorden al gegeven.
Een kernzin geeft steeds de h van een
a weer. Die zin bevat dus de b i , de kern van wat je in die a wilt zeggen. Om die kernzin te vinden, zijn er een paar richtlijnen die je in acht kunt nemen.
• Ten eerste is het meestal de e of de l zin van de alinea.
• Verder bevat de kernzin veel k die je kunt linken aan de titel of tussentitels. De kernzin zou zelfs de effectieve titel van de alinea kunnen zijn.
• De kernzin bevat tot slot eerder a informatie en minder d . Meer concrete informatie wordt in de rest van de alinea gegeven.
Een studie van de online reistool Travelmath wilde nagaan welk plekje in een vliegtuig de meeste bacteriën bevat. Microbiologen namen daarom staaltjes bij vliegtuigen van vijf verschillende maatschappijen en ontdekten vervolgens dat niet de doorspoelknop van het toilet of de veiligheidsgordel de minst hygiënische plaats is, maar ...

Je hebt er vast al van gegeten, gedronken of zelfs op geslapen. De uitklaptafel die voor je vliegtuigzitje hangt, gebruik je tijdens de vlucht meermaals. Het mag dan ook niet echt verbazen dat het plekje heel wat bacteriën bevat. Maar volgens onderzoek van reiswebsite Travelmath bevat het, in vergelijking met de doorspoelknop van het toilet, zelfs acht keer meer micro-organismen. Bijgevolg krijgt het klaptafeltje de weinig eervolle titel van vuilste plekje in het vliegtuig.
Voor het onderzoek werden eerst staaltjes verzameld van bacteriën op verschillende plaatsen in een vliegtuig. Daarna werd in een laboratorium de concentratie aan organismen gemeten door onderzoekers. Die drukten ten slotte het aantal bacteriën uit in ‘kolonievormende eenheden’ of colony-forming units (CFU).
Op het toilet vonden ze gemiddeld 265 CFU per vierkante inch (dat is zo’n 2,54 centimeter). De veiligheidsriemen bleken iets meer hygiënisch met 230 CFU per vierkante inch, op de knopjes voor ventilatie werd dan weer een concentratie van 285 CFU vastgesteld. Dat alles is daarentegen niets vergeleken met de bacteriehoeveelheid op klaptafeltjes: de onderzoekers vonden daar 2155 CFU per vierkante inch. Kortom, deze tafeltjes blijken meer dan andere plekken een ware broeihaard voor bacteriën te zijn.
De studie toont aan dat klaptafels onvoldoende worden gereinigd tussen twee vluchten in. De reiswebsite hoopt om die reden met het onderzoek het vliegpersoneel te sensibiliseren om de hygiëne in het vliegtuig te verbeteren. Voedselspecialisten wijzen er bovendien op dat passagiers hun eten beter niet in onmiddellijk contact brengen met de tafeltjes.
Voor het onderzoek werden ook de luchthavens zelf geïnspecteerd. Daaruit bleek dat de meeste microben op de knoppen van de drinkfonteinen zitten (1240 CFU). De biologen meenden echter nergens de E.coli-bacterie, die een voedselinfectie kan veroorzaken, te hebben aangetroffen.
Bron: www.demorgen.be
5 Onderstreep de kernzin in alle alinea’s van het artikel. Welke kernzin vind jij de beste? Motiveer je antwoord aan de hand van de criteria uit het Onthouden-kader.
6 Herlees het artikel. Welke topische vragen (wie, wat, waar, wanneer, waarom en hoe) worden beantwoord in de verschillende alinea’s? Schrijf deze per alinea in de marge van het artikel.
7 Vul de marges van het artikel aan met maximaal vier kernwoorden per alinea.
EEN SCHEMA VAN EEN TEKST MAKEN
1 Maak op basis van de kernwoorden uit opdracht 7 een schema van het artikel. Werk niet in volledige zinnen, maar gebruik afkortingen, opsommingen …
1 Het artikel bevat heel wat signaalwoorden. Herhaal wat die signaalwoorden precies kunnen doen voor een tekst door de de nitie hieronder te lezen.
Verbindingswoorden of signaalwoorden verbinden zinnen of tekstdelen en geven aan wat voor verband er tussen die zinnen of tekstdelen bestaat. Ze ‘signaleren’ bijvoorbeeld een volgorde in de tijd, een opsomming, een tegenstelling, een voorwaarde of een oorzaak-gevolgrelatie. Als verbindingswoorden treden voegwoorden op (zoals maar, als, omdat) en bijwoorden (zoals toch, namelijk , daarna), maar ook bepaalde vaste combinaties en formuleringen (zoals in elk geval, dat wil zeggen) kunnen als verbindingswoorden worden beschouwd.
De laatste decennia is het aantal paarden in Vlaanderen sterk toegenomen. Land- en tuinbouwgronden worden bijvoorbeeld vaker gebruikt voor recreatieve en professionele paardenhouderij. Planologen spreken daarom van de verpaarding van het platteland. Verpaarding kan positieve economische gevolgen hebben, maar leidt er dikwijls toe dat het landschap een rommelige aanblik krijgt. Bovendien kan het fenomeen een bedreiging vormen voor de professionele land- en tuinbouw.
Bron: www.vlaanderen.be/taaladvies
2 Bestudeer nu onderstaande zinnen uit het krantenartikel. Markeer het signaalwoord en duid aan welk verband het uitdrukt.
a Kortom, deze tafeltjes blijken meer dan andere plekken een ware broeihaard voor bacteriën te zijn.
opsomming tegenstelling voorwaarde conclusie
b Voor het onderzoek werden eerst staaltjes verzameld van bacteriën op verschillende plaatsen in een vliegtuig.
chronologie voorwaarde reden of oorzaak vergelijking
c Dat alles is daarentegen niets vergeleken met de bacteriehoeveelheid op klaptafeltjes.
voorwaarde chronologie tegenstelling opsomming
d Voedselspecialisten wijzen er bovendien op dat passagiers hun eten beter niet in onmiddellijk contact brengen met de tafeltjes.
opsomming reden of oorzaak tegenstelling voorwaarde
e Microbiologen namen daarom staaltjes bij vliegtuigen van vijf verschillende maatschappijen.
voorwaarde chronologie reden of oorzaak opsomming
3 Vul onderstaande tekst aan met gepaste signaalwoorden. Kies uit onderstaande opties.



bovendien – zo – zoals – dus – aangezien – bijvoorbeeld – nadat – met andere woorden – desondanks – want

En nee, dit had je niet zien aankomen
Dat vliegen niet per se een activiteit is waar hygiëne op de voorgrond staat, is bij de meeste jetsetters nu wel bekend. werden passagiers van een vliegtuig in New York gisteren in quarantaine gezet meerdere mensen aan boord akelig begonnen te hoesten, of zelfs aan het overgeven waren. Smerig? Ja. BMC infectious diseases deed onderzoek naar hygiëne op alledaagse plekken. En je al kunt vermoeden, scoorde het vliegveld niet al te best.
Vies




De toiletten op een luchthaven zijn niet al te fris. blijkt uit onderzoek dat het nóg viezer kan. En dan heb ik het niet over de wc’s, maar over een voorwerp waar jij nog helemaal niet aan hebt gedacht. Het bakje waar jij altijd netjes je sieraden, elektronica en jas in deponeert , bevat voor 50% aan bacteriën waar je luchtweginfecties van kunt krijgen. Erg vrolijk word je daar niet van.
De onderzoekers waren gefocust op luchthavens, een virus zich in een vliegtuig enorm snel kan verspreiden. En je zit na een vakantie natuurlijk niet te wachten op een griepje. Advies van de onderzoekers? Sla als een malle die handsanitizer in! vinden ze dat vliegtuigmaatschappijen deze handige gel moeten aanbieden aan haar passagiers.

vanaf nu vergeet je nooit meer je handen te wassen. , je weet wat ze zeggen: een gewaarschuwd mens ...

Bron: www.elle.com

4 Ga in alle oefeningen en teksten van deze les op zoek naar signaalwoorden. Zet ze in het schema bij de juiste categorie. Vul aan met eigen voorbeelden. signaalwoorden
opsomming tegenstelling
oorzaak, reden, gevolg
vergelijking
conclusie chronologie

voorwaarde voorbeeld


Je maakt kennis met het genre kortfilm
Je gaat in gesprek met je medeleerlingen over het thema van de kortfilm
Je kunt jouw gedachten en gevoelens formuleren bij het bekijken van een kortfilm
1 Beantwoord onderstaande vragen zonder lang na te denken.

a Welke job heeft deze persoon, denk je? Kies uit: zangeres – tattoo-artist – advocate– illustratrice –leerkracht – tandarts – verkoopster.

Een vader en een zoon krijgen een ernstig auto-ongeluk. De vader overlijdt ter plekke, de zoon wordt overgebracht naar het ziekenhuis. De chirurg komt aangesneld, maar zegt vervolgens met tranen in de ogen: ‘Sorry, maar ik kan deze jongen niet opereren. Dit is mijn zoon.’
c De batterij van je smartphone is leeg en je moet snel de weg naar het station vinden, er naderen heel wat mensen. Aan wie vraag je de weg?
b Hoe kan dit?
d Is dit een jongen of meisje?
e Plaats deze twee namen bij de foto’s.
Kies uit: Thomas Gruyters –Manuel Sanchez

Zonder dat we er ons bewust van zijn, kampen we allemaal met vooroordelen: chirurgen zijn mannen, mensen met een andere huidskleur spreken geen / niet zo goed Nederlands, jongens dragen geen roze kleren, dikkere mensen sporten niet …
2 Hoe komt dat volgens jou? Ben jij je bewust van bepaalde vooroordelen die je hebt?
3 Jullie krijgen in drie delen een kort lm te zien met de titel Two strangers who meet ve times. Welk verhaal verwacht je bij zo’n titel?


4 Je kunt het woord ‘stranger’ op twee manieren vertalen, welke?
5 Welke betekenis is op de kort lm van toepassing, denk je?
6 Bekijk de a che: verwacht je een kwalitatieve kort lm? Waarom wel/niet?
Bekijk het eerste deel van de film.
1 Hoe voel je je na het bekijken van dit eerste fragment? Kies een of meerdere toepasselijke bijvoeglijke naamwoorden en vertel waarom je die emotie hebt.
woedend – machteloos –verrast –
verontwaardigd – opgewekt – teleurgesteld – woedend – onverschillig – machteloos – slechtgezind –geamuseerd – gegeneerd – verrast – gedemotiveerd – verward – nieuwsgierig – ongemakkelijk
2 In dit verhaal hebben we te maken met twee protagonisten. Wie? Omschrijf ze.
3 In het fragment zien we twee ontmoetingen. Bespreek elke ontmoeting aan de hand van volgende vragen.
a De hoeveelste ontmoeting is dit?
b Wat gebeurt er?
c Beschrijf het uiterlijk van de twee protagonisten.
d Wie heeft een sterke machtspositie? Wordt die macht positief ingezet of misbruikt?
ontmoeting #
ontmoeting #
Korte inhoud: wat gebeurt er?
uiterlijk personages Alistair:
Samir:
machtspositie Samir
Alistair
ander:
De macht wordt …
misbruikt.
positief ingezet.
Alistair:
Samir:
Samir
Alistair
ander:
De macht wordt …
misbruikt.
positief ingezet.
4 Welke drie vooroordelen worden Samir bij de tweede ontmoeting naar het hoofd geslingerd?
5 Hoe reageert Samir op die vooroordelen?
6 Ken je nog van die typische vooroordelen? Welke?
7 Ben je zelf al eens getuige of slachto er geweest van zo’n voorval? Hoe reageerde je? Betrap je jezelf wel eens op vooroordelen?
8 Welke vraag stel je je aan het einde van dit fragment?
9 Welk antwoord vermoed je op die vraag?
Bekijk het tweede deel van de kortfilm.
10 Heeft Alistair de job gekregen? Hoe kom je dat als kijker te weten?
11 Heeft Samir daardoor zijn macht misbruikt, vind je?
12 Bespreek ook deze ontmoeting.
ontmoeting # Korte inhoud: wat gebeurt er?
uiterlijk personages Alistair: Samir: machtspositie Samir Alistair ander: De macht wordt … misbruikt. positief ingezet.
13 Hoe toont de lmmaker zonder woorden dat Alistair amper geld heeft? Geef drie voorbeelden.
14 Vanuit welke emotie handelt Samir in ontmoeting 3 versus ontmoeting 4? Leg uit.
15 Hoe sta je tegenover de personages na het bekijken van dit fragment?
16 Geef je zelf wel eens geld of eten aan een dakloze? Waarom wel/niet?
Bekijk het laatste deel van de kortfilm.
17 Wanneer ontmoetten Alistair en Samir elkaar voor het eerst?
18 Bespreek deze ontmoetingen.
Korte inhoud: wat gebeurt er?
ontmoeting #
ontmoeting #
uiterlijk personages Alistair: Samir:
machtspositie Samir Alistair ander:
De macht wordt … misbruikt.
positief ingezet.
19 Hoe is de relatie tussen Alistair en Samir in de zandbak?
Alistair: Samir:
Samir
Alistair
ander:
De macht wordt …
misbruikt.
positief ingezet.
20 Waarom is onderstaande uitspraak van Alistairs moeder cruciaal voor het verloop van het verhaal? Wat maakt die uitspraak duidelijk?
‘We don’t want you catching germs.’
21 Welk zaadje plant de moeder in Alistairs hoofd met die uitspraak?
22 Hoe weet je in de laatste scène dat de oude Sammy Alistair herkent?
23 In ontmoeting 4 zei Samir het onderstaande. Is zijn hoop voor Alistair uitgekomen?
‘Make today the first day everything falls into place for you.’

1 In welk land speelt het verhaal zich af? Hoe weet je dat?
2 Een cashpoint of bankautomaat geeft twee keer een belangrijke wending aan Alistairs leven. Verklaar.
3 Wordt het verhaal chronologisch verteld?
De chronologie is de volgorde van alle gebeurtenissen in een verhaal. Bij een chronologische vertelling worden ze één na één weergegeven: je leest wat er eerst gebeurde, wat daarop volgde, hoe de gebeurtenis verderging en afliep.











Een auteur kan er ook voor kiezen om de chronologie door elkaar te gooien. De lezer krijgt scènes en moet ze in de juiste volgorde plaatsen. Bij een flashback krijg je een langere passage die iets vertelt over het verleden; bij een flashforward voegt de auteur een passage in die zich pas later in de verhaallijn afspeelt.






4 Waarom kiest de lmmaker voor die volgorde, denk je?

5 Hoe voel je je na het bekijken van de hele lm? Is je gevoel veranderd na het eerste deel? Omschrijf je gevoel in één woord.
6 Kunnen we spreken van een happy end?
7 Hebben we hier te maken met een gesloten of open einde?
8 Je hebt de personages bij het eerste fragment (ontmoetingen 2 en 3) omschreven. Hoe zou je ze nu omschrijven? Wees uitgebreid.
• Samir:
• Alistair:

9 Waarom heeft de regisseur de lm gemaakt, denk je?
Je bekijkt nu kort een fragment uit Het poppenonderzoek
10 Hoe gaat het onderzoek in zijn werk?
11 Welke vragen worden aan de kinderen gesteld?

12 Hoe oud zijn de kinderen? Waarom denk je dat?
13 Wat willen ze met die vragen nagaan?

14 Bevestigt dit onderzoek de algemene boodschap van de regisseur van de kort lm?
15 Via welke invloed kunnen die ideeën bij kinderen ontstaan volgens jou?
16 Uit dit lmpje blijkt dat de invloed van buitenaf ook positief kan zijn. Bij welk kindje merk je dat en hoe?
Of je racistische vooroordelen creëert, hangt dus heel erg af van wat je leert van de mensen en de maatschappij rondom jou. Alles begint met het bewustzijn van het feit dat er nog heel wat vooroordelen leven en er nog steeds veel ongelijkheid is.
1 Heb jij al eens gehoord van ‘white privilege’? Wat betekent het?

2 Bedenk samen met een medeleerling een aantal concrete voorbeelden van zulke privileges.
Bekijk nu onderstaande posts van de Instagrampagina veelgehoord
“Jou bedoel ik niet hoor, jij bent een van de goede!”
“Word je gedwongen om een hoofddoek te dragen?”
“Je mag ook niks meer zeggen tegenwoordig”
“Oh, universiteit? Dat had ik niet verwacht!”


























“Voor wie ben je als je land tegen Nederland speelt?”
“Waarom lijkt het altijd alsof jullie boos zijn als jullie met elkaar praten?”

3 Waarvan zijn dit voorbeelden?
4 Surf eens naar de Instagrampagina. Je ontdekt uitspraken met verschillende achtergrondkleuren. Waarom?
5 Zitten er uitspraken bij die jij zelf geregeld te horen krijgt? Welke?
6 Zitten er uitspraken bij die jij zelf zeker ook wel eens gedaan hebt? Was je je ervan bewust dat die uitspraak kwetsend of storend kan zijn?
7 Kies één thema waarvoor jij extra uitspraken wilt bedenken of bedenk een nieuw thema.
8 Ga samenzitten met leerlingen die rond hetzelfde thema willen werken. Zet tien nieuwe uitspraken op papier die jullie storend/beledigend vinden en maak er posters van.
9 Presenteer de posters aan de andere groepen en leg steeds uit waarom een uitspraak niet door de beugel kan.
10 Maak er een positieve campagne van op school. Bedenk een nieuwe naam voor jullie klasactie en verspreid de posters in de gangen van het schoolgebouw.

Je kunt een duidelijk en goed geformuleerd antwoord geven op een vraag 1
3
Je maakt correct gebruik van signaal- en verwijswoorden
ANTWOORDEN VERGELIJKEN
Je kunt een goed opgebouwde alinea schrijven
1 Stel je voor dat jij de leerkracht bent. Tijdens de les hebben drie leerlingen onderstaande antwoorden ingediend. Geef ze telkens een score en beargumenteer waarom je die score geeft.
Leerkracht Waarvoor staat de afkorting PIE? Leg het begrip kort uit in je eigen woorden.
Leerling 1




Taal. PIE = Proto-IndoEuropees
hypothetische voorouder van meerdere talen IndoEuropese talen / 3
Leerling 2
De afkorting PIE staat voor Proto-Indo-Europees. Dit is een hypothetische taal die de voorouder is van de IndoEuropese taalfamilie.
/ 3
Leerling 3
De hypothetische voorouder van de Indo-Europese talen is het Proto-Indo-Europees. Deze gereconstrueerde taal wordt afgekort als PIE. De Indo-Europese talen zijn een taalfamilie. De talen die tot die familie behoren, worden gesproken over de hele wereld. Het is een hypothetische taal omdat er geen bronnen in deze taal zijn overgeleverd, ze werd dus gereconstrueerd. / 3
1 Beantwoord onderstaande vragen om na te gaan hoe sterk je al bent in het formuleren van een goed antwoord. Denk bij het invullen terug aan feedback die je in het verleden kreeg van je leerkrachten.
1 Ik vind het moeilijk om een goed antwoord te formuleren.
a nooit
b soms
c meestal
d altijd
2 Ik antwoord naast de kwestie.
a nooit
b soms
c meestal
d altijd
3 Ik denk dat ik een goed antwoord heb gegeven, maar behaal toch slechte resultaten.
a nooit
b soms
c meestal
d altijd
4 Mijn antwoorden zijn te beknopt.
a nooit
b soms
c meestal
d altijd
5 Mijn antwoorden zijn te uitgebreid.
a nooit
b soms
c meestal
d altijd
6 Ik neem mijn antwoorden letterlijk over uit de tekst in plaats van ze in mijn eigen woorden te formuleren.
a nooit
b soms




c meestal
d altijd
Antwoordde je meestal c of d? Het formuleren van een goed en gestructureerd antwoord is voor jou nog een werkpunt. Gebruik deze les om je op weg te helpen.
Antwoordde je meestal a of b? Je bent al vrij sterk in het formuleren van een goed en gestructureerd antwoord op de vraag. Gebruik deze les om je vaardigheden nog te versterken.
Tips bij het formuleren van een goed antwoord
1 Analyseren van de vraag: lees de vraag grondig en markeer eventuele deelvragen.
2 Voorbereiden van het antwoord: denk na over wat je in je antwoord moet verwerken om het volledig te maken. Noteer dit eventueel in kernwoorden zodat je alle informatie hebt alvorens een samenhangend antwoord te formuleren.
3 Formuleren van een samenhangend en gestructureerd antwoord: gebruik volzinnen, geen telegramstijl in je uiteindelijke antwoord. Schrijf zakelijk en vermijd overbodige informatie. Maak bij een tekstvraag gebruik van een IMS-structuur met een duidelijke alineaopbouw en signaalwoorden.
2 Lees de volgende teksten en formuleer een antwoord op de bijhorende vraag.
Waarom is taalvaardigheid belangrijk bij verdere studies?
Afgelopen najaar is op de Radboud Universiteit een enquête over de taalvaardigheid van studenten uitgezet onder docenten. Het blijkt dat docenten taalvaardigheid zien als een knelpunt bij studenten, met name de schrijfvaardigheid.
Volgens Franke Teunisse, programmamanager toetsing bij Radboud in’to languages, geeft het onderzoek inzicht in de ervaringen en wensen van docenten: ‘Zij geven aan dat studenten vaak niet op het gewenste taalniveau zitten als ze instromen op de universiteit. Ze hebben moeite met redeneren en structuur aanbrengen, terwijl dat belangrijke vaardigheden zijn.’

Middelbare scholen krijgen hier vaak de schuld van volgens Teunisse, maar ook de universiteit heeft een taak in het verbeteren van de taalvaardigheid: ‘Waar eindigt het voortgezet onderwijs en begint academisch onderwijs? Je hoort weleens dat het voortgezet onderwijs niet goed genoeg zou zijn, maar ik weet niet of dat zo is. Er moet op de universiteit ook nog aan die taalvaardigheid geschaafd worden.’ Teunisse merkt wel op dat er in het middelbaar onderwijs minder aandacht is voor schrijfvaardigheid, omdat het eindexamen gericht is op tekstverklaring.
Daarnaast heerst er een hardnekkig beeld dat jongeren steeds nonchalanter met taal omgaan. Teunisse stelt dat dit mogelijk een gevolg is van de diverse schoolpopulatie en de aanwezigheid van spellingcontrole op elektronische apparaten, maar dat er nog geen onderzoek is dat aantoont dat het taalniveau ook werkelijk omlaaggaat.
Projectleider taalbeleid bij Academic Affairs Inez Vereijken vult aan dat het wel duidelijk is dat een slechte taalvaardigheid een probleem is: ‘Binnen een academische opleiding moet je goed kunnen redeneren, samenvatten en kritisch analyseren. Als je daar veel moeite mee hebt, maakt dat je studie veel zwaarder.’
Onder leiding van hoogleraar Nederlands en Academische Communicatie Marc van Oostendorp gaat de faculteit Letteren taaltoetsen vergelijken en onderzoeken hoe het nu écht gesteld is met de taalvaardigheid van studenten.
Bron: onzetaal.nl




het knelpunt: moeilijkheid het voortgezet onderwijs: term die in Nederland gebruikt wordt om naar het secundair onderwijs te verwijzen

Waarom is taalvaardigheid belangrijk bij verdere studies?
STAP 1: de vraag analyseren
Welke informatie heb je nodig om de vraag te beantwoorden?
de moeilijkheden van jongeren die het gevolg zijn van slechte(re) taalvaardigheid
de oorzaken van de slechte(re) taalvaardigheid van jongeren
oplossingen om de taalvaardigheid van jongeren te verbeteren
het belang van taalvaardigheid voor verdere studies
STAP 2: je antwoord voorbereiden
Welke elementen moet je in je antwoord verwerken?
a Welke moeilijkheden – omwille van een slechte taalvaardigheid – worden aangehaald in het artikel?
b Wie haalt die moeilijkheden aan?
STAP 3: een volledig en gestructureerd antwoord formuleren
Wat is het verband tussen werken met gereedschap en een beter begrip van zinsbouw?



Uit een serie experimenten van Franse en Zweedse onderzoekers blijkt dat werken met gereedschap weleens zou kunnen helpen bij het verbeteren van het begrip van zinsbouw.
Binnen het onderzoek moesten proefpersonen een nijptang van dertig centimeter gebruiken om kleine pinnen in de juiste gaten te steken. Behalve deze fijn-motorische opdracht kregen de proefpersonen zinnen voorgelegd waar zij vragen over moesten beantwoorden. Hierbij werden ook zinnen gebruikt met een wat complexere zinsbouw zoals: ‘De schrijver die de dichter bewondert, schrijft een opstel.’
Tijdens het uitvoeren van de taken werd de hersenactiviteit van de proefpersonen gemonitord in een MRI-scanner. Daaruit bleek dat zowel het uitvoeren van de precisietaak met de nijptang als het verwerken van de zinnen met complexe zinsbouw hetzelfde gebied in de hersenen activeert: de basale ganglia, een regio betrokken bij het verstand, de gevoelens en de bewegingscoördinatie. Verder bleek dat proefpersonen die eerst de zinsverwerkingstaak kregen gevolgd door de gereedschapstaak, bij het opnieuw uitvoeren van de zinsverwerkingstaak beter scoorden dan een controlegroep die niet met gereedschap werkte.

Volgens de onderzoekers leert dit ons misschien iets over de ontwikkeling van de menselijke taal: het is mogelijk dat het gereedschapsgebruik van onze voorouders heeft bijgedragen aan de vorming van complexere zinnen. De gevonden resultaten kunnen ook nuttig zijn bij de ontwikkeling van protocollen die mensen met taalstoornissen helpen betere zinnen te produceren.
monitoren: controleren, toezicht houden
Wat is het verband tussen werken met gereedschap en een beter begrip van zinsbouw?
STAP 1: de vraag analyseren
Welke informatie heb je nodig om de vraag te beantwoorden?
de invloed van gereedschapsgebruik op de ontwikkeling van menselijke taal
de resultaten van het onderzoek
hoe mensen met taalstoornissen geholpen kunnen worden om betere zinnen te formuleren
STAP 2: je antwoord voorbereiden
Welke elementen moet je in je antwoord verwerken?
STAP 3: een volledig en gestructureerd antwoord formuleren
Een alinea is een thematisch afgebakend onderdeel van een tekst dat bestaat uit een kernzin en uitwerkingszinnen. Een kernzin wordt doorgaans opgesteld aan de hand van het TAS-principe, waarbij TAS staat voor: thema (T), afbakening (A), standpunt (S).
De taalvaardigheid van studenten aan hogescholen gaat erop achteruit.
De alinea wordt afgesloten met een slotzin of een overgangszin die zorgt voor een vlotte overgang naar de volgende alinea. Om verbanden tussen verschillende alinea’s te leggen, maak je gebruik van signaalwoorden.
1 Lees de volgende alinea uit het krantenartikel Academici luiden alarmbel over desastreuze vaardigheden in hogeronderwijs en duid de kernzin aan.
De nadruk leggen op communicatief taalonderwijs kan volgens Valcke gerust ook leiden tot een betere schrijfvaardigheid. ‘Het hangt er maar van af hoe je dat als school invult. Zie je dat enkel als converseren, of lees je samen teksten? Laat je de leerlingen die teksten analyseren, er opdrachten over schrijven en ze presenteren in de klas? Dan werk je wel degelijk aan een betere taalbeheersing. In sommige scholen wordt in het zesde middelbaar amper nog een boek gelezen.
Bron: demorgen.be - 16/08/2010


2 Waarom is deze zin de kernzin en de rest van de alinea de uitwerking?
3 Wat is de relatie tussen de kernzin en de rest van de alinea?
4 Markeer de kernzin in onderstaande tekst.
De hedendaagse samenleving vraagt daarnaast ook nieuwe vaardigheden: zogenaamde ‘21st century skills’. Meer dan ooit moeten we kunnen samenwerken, creatief zijn, beschikken over digitale geletterdheid, problemen kunnen oplossen, kritisch kunnen denken, onszelf kunnen sturen én sociaal en cultureel vaardig zijn. In het verwerven en versterken van die vaardigheden is taalvaardigheid – en schrijfvaardigheid als belangrijk onderdeel daarvan – een vereiste.
Bron: fragment uit het adviesrapport Schrijfonderwijs in de schijnwerpers van de Nederlandse Taalunie uit 2015, taalunie.org
5 Wat is de relatie tussen de kernzin en de rest van de alinea?
6 Onderstaande alinea uit het opiniestuk We kunnen dalend taalniveau bij jongeren weer opkrikken werd door elkaar gehaald. Zet de zinnen opnieuw in de juiste volgorde en markeer de kernzin.
a Veel andere nuttige en nodige vaardigheden – zoals kennis van specifieke technologische tools –kun je relatief snel en eenvoudig bijspijkeren terwijl je al aan de slag bent.
b In bijna elke functie kan enkel wie voldoende taalvaardig is, een duidelijke meerwaarde betekenen voor een organisatie.
c Taal biedt ook een economisch toegangsticket.
d Inzicht in hoe je een tekst ontrafelt of opbouwt, hoe (interculturele) communicatie verloopt, hoe je dubbele bodems in een boodschap herkent … kun je niet op een-twee-drie verwerven.
Naar: tijd.be - 21/05/2019
7 Onderstaande alinea komt uit het artikel OESO waarschuwt: studenten doen te lang over studie hoger onderwijs, maar de kernzin werd weggelaten. Bedenk een goede kernzin voor deze alinea.
Zo kondigde diezelfde KU Leuven midden augustus aan de deliberatie van studenten terug meer in eigen handen te nemen, de Gentse universiteit wil studenten sneller heroriënteren als het moeilijk loopt en de Antwerpse en Brusselse universiteit nodigen studenten dan weer uit voor een begeleidingsgesprek als de resultaten tegenvallen.
Bron: demorgen.be - 10/09/2019




8 Vergelijk onderstaande alinea’s. Welke alinea leest vlotter volgens jou? Beargumenteer.
Uit onderzoek van An De Moor blijkt dat de taalvaardigheid van studenten aan de hogeschool daalt. An De Moor geeft hiervoor meerdere oorzaken. An De Moor spreekt over een diverse instroom in vergelijking met universiteiten. De schoolachtergrond van de studenten is ook een oorzaak. Gedaalde leesvaardigheid is ook een oorzaak. Dit zijn, volgens De Moor, de oorzaken van de gedaalde taalvaardigheid van de studenten aan de hogeschool. Er is meer dan één oorzaak voor dit probleem.
Uit onderzoek van An De Moor blijkt dat de taalvaardigheid van studenten aan de hogeschool daalt. De Moor geeft daarvoor meerdere oorzaken. Eerst wijst ze naar de diverse instroom van hogescholen in vergelijking met universiteiten. Daarnaast speelt de schoolachtergrond van de studenten volgens haar ook een belangrijke rol. Ten slotte is ook de gedaalde leesvaardigheid van de studenten volgens De Moor een oorzaak van de gedaalde taalvaardigheid. Met andere woorden, er ligt meer dan één oorzaak aan de grondslag van dit probleem.
OESO: Organisatie voor Economische Samenwerking en Ontwikkeling; samenwerkingsverband van 38 landen om sociaal en economisch beleid te bespreken, te bestuderen en te coördineren

Een tekst leest doorgaans vlotter wanneer er gebruik wordt gemaakt van signaal- en verwijswoorden. Die woorden zijn structuuraanduiders.
Verwijswoorden voorkomen herhalingen omdat ze verwijzen naar iets wat eerder gezegd werd of naar iets wat nog komt.
Lucy heeft een verjaardagscadeau gekocht voor Kevin. Ze wil het morgen graag aan hem geven.
Signaalwoorden geven aan welk verband er tussen zinnen en/of tekstdelen bestaat.
Kevin wil geen huisdieren omdat hij hun appartement te klein vindt. (= reden)
9 Schrijf een alinea die als verduidelijking bij onderstaande gra ek geplaatst kan worden.
10 Bekijk je eigen alinea kritisch aan de hand van onderstaande criteria.

mijn alinea
Mijn alinea bevat een kernzin.
Ik maak correct gebruik van signaalwoorden.
Ik maak correct gebruik van verwijswoorden.
Mijn alinea vormt een thematisch geheel.
Mijn alinea vormt een afgerond geheel of heeft een vlotte overgang naar een volgende alinea.
In les 18 ga je verder aan de slag met tabellen en grafieken.
De alinea wordt correct opgebouwd (kernzin + uitwerking).
De alinea wordt gedeeltelijk correct opgebouwd, maar:
- de kernzin sluit niet aan bij het thema.
- de uitwerking sluit niet aan bij de kernzin.
De alinea wordt niet correct opgebouwd:
- de kernzin ontbreekt.
- de uitwerking van de kernzin ontbreekt.
De alinea vormt een thematisch geheel.
duidelijkheid
De informatie uit de grafiek wordt correct geïnterpreteerd en duidelijk weergegeven in de alinea.
De spelling van het eindresultaat is (nagenoeg) foutloos.
Bepaalde informatie uit de grafiek wordt correct geïnterpreteerd, maar niet duidelijk weergegeven in de alinea.
De tekst bevat enkele spellingfouten die - de communicatie niet hinderen; - de boodschap niet in de weg staan.
gepastheid
Het gebruikte register sluit aan bij de opdracht.
Het gebruikte register sluit meestal aan bij de opdracht, maar af en toe is het taalgebruik te (in)formeel.
De alinea vormt geen thematisch geheel.
De informatie uit de grafiek wordt niet correct geïnterpreteerd en ook niet duidelijk weergegeven in de alinea.
De tekst bevat te veel en/of te opvallende spellingfouten.
Het gebruikte register sluit niet aan bij de opdracht.
Een register is een term voor taalgebruik dat past bij een bepaalde situatie. Als taalgebruiker leer je om het geschikte register te gebruiken. Die keuze maak je op basis van de communicatieve situatie waarin je je bevindt. Tijdens een gesprek met de directeur kiest de leerling een meer formeel taalregister, terwijl die leerling met vrienden in de jeugdbeweging kiest voor een informeel taalregister.
Aanvullende commentaar:

In het Kennisoverzicht op p. 406 vind je een overzicht van de soorten tekstverbanden en signaalwoorden.
1 Verbind de zinnen met een signaalwoord. Breng genoeg variatie in de tekstverbanden die je uitdrukt en de signaalwoorden die je gebruikt.
a Vandaag zijn we niet op school. De leerkracht en bijna de helft van de klas is ziek.
b De professor zet alle materialen en stoffen klaar. Hij doet zijn labojas aan. Hij overloopt de werkwijze van het proefje.
c De meeste Belgen eten om zes uur. Belgische vrijgezellen eten meestal om half acht.
d Tsjechië is een mooi land. Ik wil er niet wonen.
e Voor roeien heb je sterke arm- en beenspieren nodig. Ik doe veel aan krachttraining.
f Ik wil niet mee op vakantie. Ik heb er geen zin in. Ik heb er geen geld voor. Het mag niet van mijn ouders.
g In veel landen is het verboden mensen te discrimineren op basis van ras. In Nederland is dit het geval. h In de meeste pretparken worden attracties goed gecontroleerd. Achtbanen moeten dagelijks gecontroleerd worden door technisch personeel.
2 Deel onderstaande signaalwoorden op in groepen. Geef aan welk tekstverband ze uitdrukken.
3 Schrijf een gepaste eigenschap bij de volgende uitspraken. Hieronder kun je kiezen uit een aantal woorden.
materialistisch – nonchalant – ambitieus – narcistisch – impulsief – achterdochtig – loyaal – gelijkmoedig – bescheiden –stoutmoedig
a ‘Ik vertrouw die jongen voor geen haar, volgens mij voert hij heel wat in zijn schild!’
b ‘Wat leuk dat het jullie gesmaakt heeft, maar een keukenprinses ben ik echt niet, hoor!’
c ‘Ik vind dat mijn vriend me voor mijn verjaardag een cadeau van minstens 100 euro moet kopen, anders ziet hij mij niet graag!’
d ‘Ook al ben ik het niet met alle uitspraken van Trump eens, hij kan ook volgende keer op mijn stem rekenen!’
e ‘Door dagelijks te mediteren, slaag ik erin om niet bij iedere tegenslag het noorden kwijt te zijn. Ik aanvaard de dingen zoals ze komen.’
f ‘Ik heb vandaag een mindere dag gehad op het werk, dus ik ga een busje kopen en de wereld rondreizen!’
g ‘Tegen mijn 25e wil ik op zijn minst twee masters behalen en een buitenlandse ervaring opdoen!’
h ‘Ik weet van mezelf dat ik meer te bieden heb dan anderen. Ik ben nu eenmaal én intelligent én knap. Geef toe, wie zou er nu niet in mijn buurt willen zijn?’
i ‘Ik heb drie van de vijf huistaken voor morgen gemaakt, dat zal wel volstaan.’
j ‘Niet bang zijn, ik zal buiten gaan kijken of er een inbreker is. Voor je het weet, ben ik terug!’
4 Welk woord is een synoniem voor de volgende persoonskenmerken? Ga ernaar op zoek in de woordzoeker.
excentriek ingenieus innemend intrigerend rechtschapen paranoïde pathetisch pedant
KJRFGTEIMPRAMBA
HGVINTEGERGHBMR
ASCHERPZINNIGMG
UTHGWPCSITAMARW
TPAEFLAMBOYANTA
ADRAMATISCHASCN
IWMMAHNQEZDCGYE
NLAZBLLHIZOLMHN
TLNNFASCINEREND
KYTEXBEOCVJKPSJ
5 Onderstaande afbeeldingen stellen telkens een uitdrukking voor.


a Welke uitdrukking herken je?
b Koppel de juiste karaktereigenschap aan de uitdrukking (er blijven twee woorden over).
Kies uit: vergevingsgezind – toegeeflijk – furieus – authentiek – genereus – optimistisch –afwachtend – tolerant




uitdrukking:
karaktereigenschap:
uitdrukking:
karaktereigenschap:
uitdrukking:
karaktereigenschap:
uitdrukking: karaktereigenschap:
uitdrukking:
karaktereigenschap:
uitdrukking:
karaktereigenschap:
6 Verbind de antoniemen met elkaar.
welgesteld
meedogenloos
bedachtzaam
• • uitbundig
• • marginaal
• • empathisch
markant


geïntegreerd
extravert
ingetogen
altruïstisch
• • introvert
• • onopvallend
• • narcistisch
• • impulsief
• • onaangepast
7 Vul de onderstaande tekst aan met behulp van de onderstaande woorden.
normen en waarden – beoordelen – voorkomen – vooroordelen – potentieel – verplaatsen – realistisch – gelijkenissen – kleingeestig – ervaringen – karakter – gebruiken – persoonlijkheid – referentiekader – xenofobisch – klederdracht –horizon – perceptie – gemoedsgesteldheid – origine – ruimdenkend – opinie – leefwereld

Wanneer we iemand voor het eerst zien, creëren we op basis van zijn/haar al snel een beeld van zijn/haar of . Nochtans klopt die eerste van een persoon niet altijd. We laten ons immers onbewust leiden door . Iemands , of spelen bijvoorbeeld vaak een rol. Onze over iemand wordt ook bepaald door onze eigen en ons De en culturele waarmee je opgroeit en de die je meemaakt, beïnvloeden hoe je iemand waarneemt of . Het is belangrijk om ons daarvan bewust te zijn, zodat we leren te zijn bij een (eerste) ontmoeting. Anders lopen we het gevaar of zelfs te worden. In de kennismaking met mensen die op één of andere manier anders zijn dan jezelf, schuilt veel Je verruimt je , je leert je te in een ander, je ontdekt waar je ze misschien niet verwachtte en je creëert een wereldbeeld.

8 Ga in de onderstaande rasters steeds op zoek naar trio’s die samen verwijzen naar één woord. Welk woord zoeken we? De eerste letter is gegeven.
Sorry! geschil dispuut ophef schuldinzicht oproer opschudding twist mea culpa
v c c
Alle blondjes zijn dom! profilering prestige aanzien Vrouwen kunnen niet rijden! berucht Franstaligen kunnen geen Engels! befaamd beroemd
v i n
9 Vul het kruiswoordraadsel aan.
horizontaal
6 het toppunt van menselijke schoonheid binnen een bepaalde cultuur
7 gezichtsexpressie
verticaal
1 knappe man
2 lichaamsbouw
3 evalueren
4 buitenkant van een mens
5 massa
Wanneer komt een nieuw woord in het woordenboek?
Een woord wordt opgenomen in de Dikke Van Dale als de redactie dat woord gedurende langere tijd regelmatig aantreft in kranten, tijdschriften, boeken en op internet (inclusief blogs en sociale media). Het woord moet algemeen bekend zijn, het moet ingeburgerd zijn. Verder moet het woord in veel verschillende soorten teksten voorkomen. Woorden die uitsluitend gebruikt worden in een bepaald vakgebied, in bepaalde kringen of in een bepaalde regio, worden niet opgenomen. Daar zijn weer andere (gespecialiseerde) woordenboeken voor.

Kan ik een woord laten toevoegen aan het woordenboek?
Heb je de indruk dat een bepaald woord ten onrechte ontbreekt, dan kun je dit aan Van Dale meedelen. Suggesties voor nieuwe woorden zijn altijd welkom via het reactieformulier. Alle bijdragen worden bekeken. De hoofdredactie bepaalt of een woord daadwerkelijk in het woordenboek komt. Over de voortgang en de uitslag kan helaas niet worden gecorrespondeerd. In de Dikke Van Dale Online wordt het woord het eerst zichtbaar, want die editie herzien ze permanent.
Kan ik een woord dat ik bedacht heb, laten registreren op mijn naam?







Nee, dit is niet mogelijk. Personen kunnen de eigendomsrechten op een woord niet claimen. Dat zou ook eigenlijk een beetje vreemd zijn, want taal is nu eenmaal het gereedschap van iedereen. Los daarvan is het in veel gevallen niet goed mogelijk om te traceren hoe een woord is ontstaan. Het komt geregeld voor dat verschillende mensen tegelijk op hetzelfde idee zijn gekomen. Een uitzondering wordt gevormd door productnamen die een gedeponeerde handelsnaam zijn.
Ik heb bezwaar tegen een woord. Kunnen jullie dit schrappen uit het woordenboek?
Het belangrijkste uitgangspunt van de redactie is dat zij niet wil voorschrijven welke woorden mensen wel of niet mogen gebruiken, zij richt zich puur op het beschrijven van de woorden die je in de taal van alledag tegenkomt. Zolang mensen een woord (hoe aanstootgevend ook) in een bepaalde betekenis gebruiken, zullen andere mensen die betekenis willen opzoeken en zal een zichzelf respecterend woordenboek die betekenis vermelden.
Dat betekent overigens niet dat de vermelding in het woordenboek een vrijbrief is om beledigende en krenkende woorden te gebruiken. Bij scheldwoorden, vloeken, schuttingtaal en dergelijke plaatsen we een label (vulgair, beledigend, informeel enz.), zodat gebruikers van het woordenboek kunnen zien dat het geen neutraal woord is. Uiteindelijk bepalen mensen zelf of ze zo’n woord wel of niet willen gebruiken.
Naar: vandale.nl
1 Lees de tekst Veelgestelde vragen aan de redactie en beslis of onderstaande woorden in de volgende Van Dale kunnen komen. Geef argumenten op basis van de informatie uit de tekst. ja nee
een vloek
een woord dat uiting geeft aan weinig respect voor bv. vrouwen
een zelfbedacht woord
Lezen: Verslaafd aan spanning: waarom we zo van thrillers houden
Je leest zo meteen het artikel Verslaafd aan spanning: waarom we zo van thrillers houden op p. 140-142.
2 Bekijk de titel, de tussentitels en de afbeeldingen. Waarover denk je dat dit artikel gaat? Wees zo speci ek mogelijk.
3 Lees jij graag thrillers? Waarom wel/niet? Geef minstens twee argumenten.
Zo meteen oefen je leesvaardigheid op drie niveaus: structuur, woordenschat en inhoud. Je kunt ervoor kiezen om het artikel drie keer te lezen en telkens je focus te verleggen naar een ander leesniveau. Je kunt er echter ook voor kiezen om het artikel eerst globaal te lezen en nadien, aan de hand van zoekend en intensief lezen, de antwoorden op de vragen te vinden.
4 Welke methode verkies jij? Waarom?
5 Structuur: In het artikel zie je dat enkele woorden gemarkeerd zijn. Waarnaar verwijzen die woorden? Wees zo speci ek mogelijk.
a En daarna heb ik een kater dat ik ‘m al uit heb.
b Dat zegt ook thrillerauteur Michael Berg (61), pseudoniem van Michel van Bergen Henegouwen.
c Hij vergelijkt het met het kijkcijfersucces van het tv-programma Ik vertrek
d Dat maakt het moeilijk om de verschillende boeken met elkaar te vergelijken. Dat maakt het moeilijk om de verschillende boeken met elkaar te vergelijken.
e Daar moet je ook voor zorgen als thrillerauteur.
f Het is ontzettend eervol om door zo’n jury te worden genomineerd.
g Het bleef me verrassen, zit heel goed in elkaar en is ook nog lekker dik.
6 Woordenschat: In het artikel staan enkele moeilijke woorden. Die zijn vetgedrukt. Gebruik de context, woordbouw, woordfamilie … om de betekenis te achterhalen en plaats ze in de correcte voorbeeldzin. Let op: er zijn meer woorden aangeduid dan je nodig hebt.
recenseren – nomineren – vereenzelvigen – diverse – verkneukelen – realiseren – pseudoniem – bij de kladden grijpen –stereotype – plot – format – onderhuids – trilogie – idealiter – gelaagdheid – een doorn in het oog – shortlist
a In 2003 verscheen de laatste film van The Lord of the Rings. Die film was de afsluiter van de . De twee andere films verschenen in 2001 en 2002.
b voorwerpen uit de collectie van het museum waren uitgeleend.
c komt hij volgende week uit het ziekenhuis naar huis. In het slechtste geval daarentegen, moet hij nog enkele dagen extra blijven ter observatie.
d De Nederlandse schrijver Multatuli, van Eduard Douwes Dekker, werd vooral bekend met zijn boek Max Havelaar
e Spoiler alert! Hij heeft net de hele verraden.
f In Vlaanderen blijken waarbij mensen op televisie op zoek gaan naar een partner steevast een succes.
g De losliggende stoepstenen in onze straat zijn al jarenlang .
h Toen onze leerkracht een flagrante spelfout maakte op het schoolbord, konden wij niet anders dan ons te
i De Belgische inzending Filles de joie heeft de voor de Oscar voor beste internationale film niet gehaald.
j De voorbije jaren hield de journalist zich bezig met het van de nieuwste Hollywood-films. Hij zag er minstens 500 en beoordeelde ze allemaal.
7 Inhoud: Zijn de stellingen juist of fout? Kruis aan. De foute stellingen verbeter je. Bij de juiste stellingen noteer je de regelnummers die de stelling bewijzen.
a Jos van Cann recenseert en analyseert thrillers.
b Nicci French is een succesvolle thrillerschrijfster.
c Berg is liefhebber van ronde (uitgewerkte) hoofdpersonages.
d Thrillers krijgen minder subsidies en beurzen dan andere genres.
e De meeste boeken die verkocht worden, zijn thrillers.
f Jos van Cann kan leven van zijn schrijfwerk.
g Jos van Cann is geen fan van thrillers die rond een vrouwelijk hoofdpersonage draaien.
h De meeste van Bergs hoofdpersonages zijn vrouwen.
i Broertje is de beste Nederlandse thriller.
j Berg vindt het belangrijk zich tijdens het schrijven te vereenzelvigen met de moordenaar in zijn roman.

Thrillers zijn al jaren de meest uitgeleende boeken in de Nederlandse bibliotheken en ook in de boekhandels zijn ze niet aan te slepen. Waarom houden we toch zo van spannende verhalen?
Yvonne Iglesias-Koobs (53) verslindt bijna een thriller per week. ‘Als er een nieuwe uitkomt, zoals de laatste van Nicci French, lees ik die binnen twee dagen uit. En daarna heb ik een kater dat ik ‘m al uit heb. Ik ben mezelf aan het trainen om wat langzamer te lezen, zodat ik er iets langer van kan genieten. Op een gegeven moment kom je op een punt dat je niet meer terug kunt. Dan zit ik er helemaal in en moet ik eerst weten hoe het afloopt voordat ik iets anders kan doen.’ Ook Silvie van der Zee (32) is verknocht aan het genre. Ze recenseert spannende boeken voor Bol.com en heeft al diverse misdaadauteurs mogen ontmoeten, zoals Karin Slaughter, David Baldacci en Nicci French. ‘Thrillers laten je echt even ontsnappen naar een andere wereld, waar je je in kunt verliezen en even kunt loskomen van je dagelijkse dingetjes.’
Thrillerrecensent Jos van Cann (64) verdiept zich al sinds de jaren 70 in misdaadromans en bracht er verschillende naslagwerken over uit. Dat we zo graag misdaadromans lezen, komt volgens hem omdat mensen het prettig vinden om te beseffen hoe goed ze het eigenlijk hebben. ‘Het gevaar dat ze soms voelen, zien ze terugvertaald in zo’n boek, maar dan op veilige afstand. Tijdens het lezen kan hen niets gebeuren.’

Angsten bezweren
Dat zegt ook thrillerauteur Michael Berg (61), pseudoniem van Michel van Bergen Henegouwen. Zijn laatste boek Broertje is genomineerd voor De Gouden Strop, de prijs voor de beste Nederlandstalige thriller. ‘Bij thrillers krijgen mensen een inkijkje in de grote boze wereld waarin we leven. Misschien is het om onze eigen angsten te bezweren, van: God, wat een ellende, gelukkig overkomt mij dat niet en zit ik in een Vinexwijk waar geen stalker voor het raam staat.’ Hij vergelijkt het met het kijkcijfersucces van het tv-programma Ik vertrek ‘Daarbij zit je je te verkneukelen over andermans ellende. “Gelukkig zitten wij hier veilig op de bank”, dat. Maar je wilt het wel meemaken, daarom lezen mensen thrillers, denk ik.’
Toch weet niet elke thriller je als lezer bij de kladden te grijpen. Wat maakt een thriller goed? Voor Silvie is het allereerst belangrijk dat een personage goed wordt uitgewerkt en niet oppervlakkig blijft. ‘Het stereotype van de kettingrokende rechercheur die gescheiden is en leeft voor zijn werk kennen we nou wel. Ik laat me graag verrassen. De plot mag best een beetje ingewikkeld zijn. Boeken van Suzanne Vermeer vind ik te eenvoudig, dat is een format, al haar boeken lijken op elkaar. Ik wil vermaakt worden, op het verkeerde been worden gezet, worden meegesleept in een race tegen de klok, een kat-en-muisspel of in de vraag wie de moordenaar is. Ik houd ook van de psychologie achter de misdaad: wat drijft mensen tot moord? Dat vind ik interessant.’
Dat geldt ook voor Yvonne. Een thriller is voor haar geslaagd als er een onverwachte plotwending in zit, als ze niet van tevoren al kan raden wie het gedaan heeft. ‘Er moet bij voorkeur iets gebeuren waardoor je echt op het verkeerde been wordt gezet. Bij minder goede schrijvers zie je de afloop soms al mijlenver aankomen, dat vind ik jammer. Ik geniet het meeste als het zo geschreven is dat je wordt meegezogen in het verhaal, één wordt met de hoofdpersoon en als het ware net zo bang wordt als diegene die al die ellende overkomt.’ Schrijvers als Nicci French, Karin Slaughter, Saskia Noort en Simone van der Vlugt beheersen die kunst, vindt ze. ‘Nicci French is mijn favoriet, daar heb ik alles van gelezen.’
Vrouwelijke auteurs als Saskia Noort, Simone van der Vlugt, Esther Verhoef en Marion Pauw leveren bestseller na bestseller af. Een deel van hun succes is te verklaren vanuit het feit dat het merendeel van de thrillerlezers bestaat uit vrouwen, denkt thrillerauteur Michael Berg. ‘Vrouwen lezen sowieso meer dan mannen. En een vrouwelijk publiek kan zich makkelijker vereenzelvigen met andere vrouwen.’ Zelf bedient hij ook graag een vrouwelijk publiek: in zes van de acht boeken die hij schreef, is de hoofdpersoon een vrouw. ‘Misschien heb ik onbewust die keuze gemaakt.’
Jos van Cann heeft juist niets met ‘oestrogeenthrillers’, zoals hij ze noemt. ‘Ik ben daar niet zo van gecharmeerd. De spanning die in die boeken beschreven wordt, beslaat vaak alleen maar de belevenissen van de hoofdpersoon, meestal een vrouw die iets vreselijks overkomt. Dat is voor mij niet genoeg. Ze beheersen het vak wel, maar het is niet mijn cup of tea. Wat ik dan weer wél fantastisch vond, is de serie boeken die Esther Verhoef samen met haar man schreef onder de naam Escober. Dat zijn uitstekende thrillers.’
Van Cann zit dit jaar in de jury van De Gouden Strop. Bij het beoordelen van de inzendingen let hij op drie elementen: spanning, plot en stijl. ‘Die drie moeten goed in balans zijn. Om die spanning te realiseren moeten de plot en de stijl van de auteur goed zijn. Maar een actiethriller moet weer aan andere eisen voldoen dan een psychologische thriller. Die eerste moet veel vaart hebben, terwijl bij de tweede de spanning zich ook onderhuids kan ontwikkelen in de psyche van de hoofdpersoon. Dat maakt het moeilijk om de verschillende boeken met elkaar te vergelijken.’
Denken als een moordenaar
Auteur Michael Berg zoekt tijdens het schrijven altijd naar iets om de situatie mee op scherp te zetten. ‘Dat heb je nodig, anders heb je geen thriller. Pas bij een conflict wordt het interessant.’ Hij probeert, zoals Yvonne als lezer ook graag ervaart, één te worden met zijn personages. ‘Je moet kunnen denken als een moordenaar om een goede thriller te kunnen schrijven. Een van mijn personages was een huurmoordenaar die nog een laatste klus moest doen. Ik vond het fantastisch om in de huid van die man te kruipen en mensen om te leggen. Er was geen weg terug, ik wás hem op dat moment. Begrijp je? Het is echt een vorm van acteren.’

Zelf is hij een groot liefhebber van de boeken van René Appel, Charles den Tex en Patricia Highsmith. Een thriller is voor hem geslaagd wanneer je ‘m als lezer niet weg kunt leggen. ‘Als het verhaal zo dwingend is dat je móét doorlezen. Idealiter blijft het verhaal nog lang in je hoofd naspoken. Daar is een bepaalde gelaagdheid voor nodig, een achterliggend thema dat goed is uitgewerkt. In een goede thriller moeten personages ook een ontwikkeling doormaken, ze moeten gaan leven. Anders zijn het poppetjes van bordkarton. Dan kan een verhaal nog zo spannend zijn, maar dan ben ik het daarna onmiddellijk vergeten. Ik moet wel het gevoel hebben dat ik met mensen te maken heb gehad.’
De whydunnit-vraag vindt hij interessanter dan whodunnit. ‘Waarom mensen dingen doen is voor mij veel interessanter. Bij mij ligt de focus meer op de personages dan op de plot. Spannende stukken schrijven hoort natuurlijk ook bij het ambacht, je wilt de lezer een goede tijd bezorgen. Als er een tijd lang niets gebeurt, is dat dodelijk. Je hebt als lezer toch een bepaalde verwachting van een thriller. Bij een roman weet je niet waar het heengaat, een thriller lees je om vermaakt te worden. Daar moet je ook voor zorgen als thrillerauteur.’
Minderwaardig?
Dat over misdaadromans vaak neerbuigend wordt gedaan in de literaire wereld, is veel auteurs en liefhebbers een doorn in het oog. Jos van Cann: ‘Misdaadromans worden weggezet als minderwaardig, maar de beste thrillers doen echt niet onder voor goede literaire romans. Met name voor auteurs is dat lastig, want daardoor kost het ze vaak meer moeite om subsidies en beurzen te krijgen.’
Berg herkent dat. ‘Er wordt altijd een beetje spastisch gedaan over dat onderscheid, alsof het één minder is dan het ander. Terwijl een goede thriller en een goede roman volgens mij dicht bij elkaar komen. Een goed verhaal is altijd spannend, een spanningsboog heb je in elk goed boek. Alleen drijft een thriller nog meer op die spanning. De spanning die je in een thriller per definitie hebt, is een mooi middel om de lezer van pagina naar pagina te sleuren. Tegelijkertijd schrijf je natuurlijk gewoon een roman.’

Erkenning is voor hem niet onbelangrijk. ‘Van mijn laatste vier boeken zijn er drie op de shortlist terechtgekomen voor De Gouden Strop, dat is toch een teken dat je boeken van niveau aflevert. Het is ontzettend eervol om door zo’n jury te worden genomineerd. Dan is dat gestoei thuis toch de moeite waard.’

In 2013 won hij zijn eerste Gouden Strop met zijn boek Nacht in Parijs. Dat betaalde zich uit in de verkoopcijfers. ‘De dag nadat ik won, verkocht ik drie keer zoveel boeken als in het hele jaar daarvoor. Sinds dat moment kan ik er min of meer van leven. Zo’n prijs helpt enorm. Ik ben bij het grote publiek nog niet superbekend, maar ik zou het niet erg vinden als daar verandering in komt. Als je in thrillerland een grote naam bent, dan gaat het min of meer vanzelf.’




Jos van Cann: ‘De genomineerden voor De Gouden Strop zijn allemaal aan te bevelen. Het boek van Michael Berg heb ik met veel plezier gelezen, hij is een van de beteren in Nederland. Daarnaast zijn er wat trilogieën in omloop die zeker de moeite waard zijn. Rebound van Willem Asman, de Bling Blingreeks van de Vlaamse auteur Jan Van der Cruysse en Drie seconden, Drie minuten en Drie uur van de Zweedse schrijver Roslund Anders. Een fantastische trilogie.’


Silvie van der Zee: ‘Ik ben Pelgrim van Terry Hayes is een van de beste boeken die ik ooit heb gelezen. Niet gloednieuw, maar erg goed. Een debuut ook nog, heel knap als je dan gelijk zo’n goed boek schrijft. Het zit heel briljant in elkaar met veel onverwachte plottwists. Als je veel thrillers leest heb je op een gegeven moment al snel een idee waar het verhaal zich naartoe beweegt, maar dat was bij dit boek helemaal niet. Het bleef me verrassen, zit heel goed in elkaar en is ook nog lekker dik.’
Naar: www.rtlnieuws.nl
Deze opdracht sluit aan bij les 5. Je maakte daar kennis met het genre crime fiction en las het kortverhaal Vrienden van Pieter Aspe. In deze creatieve schrijfopdracht ga je samen met een medeleerling aan de slag. Volg dit stappenplan en kom tot een angstaanjagend verhaal.
1 Ga op zoek naar artikels of nieuwsberichten over een misdaad.
2 Kies een bron waarmee jullie graag aan de slag gaan om een verhaal te schrijven.
3 Pik uit jullie bron enkele elementen die het uitgangspunt vormen voor jullie verzonnen verhaal.
• Welk(e) personage(s) willen jullie aan bod laten komen?
• Wie is de verteller?
• Hoe willen jullie dat het verhaal eindigt: positief of negatief; open of gesloten?
• Wat als de dader het slachtoffer was of omgekeerd?
• Wat als het verhaal zich in de vorige eeuw of op een andere plaats had afgespeeld?
•
4 Overleg met je medeleerling en kies het scenario waarmee jullie willen werken.
5 Bedenk het verhaal in grote lijnen. Zo zorgen jullie ervoor dat jullie niet vastlopen tijdens het schrijfproces en zo weten jullie wat het eindpunt van het verhaal is.
6 Gebruik geen concrete namen of gegevens uit het originele artikel.
7 Schrijf een verhaal van ongeveer 600 woorden (1 A4).
8 Zorg voor de nodige spanningsopbouw. Dat kunnen jullie onder andere doen door …
• van verteller te wisselen;
• het verhaal op verschillende plaatsen te laten afspelen;
• met flashbacks of flashforwards te werken;
• informatie achter te houden;
• de lezer op het verkeerde been te zetten;
•
9 Verzin een boeiende titel voor jullie verhaal.
10 Leg jullie tekst even weg. Overloop daarna de evaluatiematrix op p. 144.
11 Laat jullie verhaal nalezen door twee andere leerlingen en vraag hun om feedback.
12 Herschrijf nu je tekst.
a Hou rekening met de suggesties die jullie van jullie medeleerlingen kregen.
b Bekijk nogmaals de evaluatiecriteria.
Je verhaal bevat een duidelijk te volgen structuur met een helder begin, een uitwerking en een einde.
Je spelling van het verhaal is foutloos. Alle woorden worden correct geschreven en ook de zinsbouw klopt steeds.
Je verhaal is duidelijk te volgen, maar bevat (een of enkele kleine) inhoudelijke fouten.
Je maakte geen zware spellingfouten. De zinnen zijn over het algemeen correct gebouwd. Let op voor:
De structuur van je verhaal is onduidelijk.
Je verhaal is boeiend en meeslepend. Je hebt een origineel uitgangspunt bedacht.
Je zorgt voor spanningsopbouw: niet alleen de inhoud is spannend, ook de technieken die je gebruikt om het verhaal te vertellen, zorgen voor extra spanning.
Je varieert in woordkeuze en je tekst bevat omschrijvingen of beeldspraak die het verhaal spannend maken of ervoor zorgen dat de lezer kan meeleven met de personages.
gepastheid
Je verhaal is geschreven voor leeftijdsgenoten en bevat geen ongepaste inhoud.
Aanvullende commentaar:
Je zorgt voor een degelijk verhaal dat beantwoordt aan de opdracht. Je verhaal mist originaliteit.
De spanning wordt matig opgebouwd.
Je tekst bevat zware spellingfouten. OF Door de vele spelling- en taalfouten is de tekst moeilijk te begrijpen.
Je taalgebruik is correct, maar verrast niet.
Je verhaal is onvoldoende creatief. Het volgt het krantenartikel te letterlijk.
Je gebruikt geen technieken om spanning bij de lezer op te roepen.
Je taalgebruik is te eenvoudig en bevat opvallend veel herhaling.
Sommige elementen in je verhaal kunnen ongepast zijn voor leeftijdsgenoten.
Je leert wat een neologisme is 1
Je leert hoe neologismen ontstaan
Je ziet in waarom neologismen in onze taal komen en ook weer verdwijnen
Wist je dat er nog elke dag nieuwe Nederlandse woorden bijkomen? Nieuwe woorden noemen we ‘neologismen’: ‘neo’ is Grieks voor nieuw, ‘logos’ voor woord. Elk jaar kiezen Van Dale en Ketnet het (kinder-)Woord van het Jaar: een woord dat het voorbije jaar ergens is opgedoken en door heel wat mensen werd overgenomen.
1 Ken je onderstaande woorden nog? Markeer de woorden die je kent in het groen. De woorden die je niet kent, markeer je in het rood.
2 Hoe kun je verklaren dat je sommige woorden niet (meer) kent?
3 Op welke manier komen die nieuwe woorden in onze taal terecht? Hoe worden ze ‘gemaakt’?
4 Welk woord werd dit jaar tot Woord van het Jaar verkozen? Zal het woord over vijf jaar nog steeds gebruikt worden? Waarom (niet)?
5 In les 6 (Waarom woordenschat belangrijk is) leerde je hoe je nieuwe woorden opslaat in je geheugen. Wat gebeurt er in onze hersenen? Kies een woord uit het lijstje bij opdracht 1 om je antwoord concreet te maken.
1 Waar komen neologismen vandaan?
a Lees op p. 148 op welke manieren een neologisme kan worden gemaakt.
b Vul de tekst aan met voorbeelden. Zet deze woorden op de juiste plaats in de tekst. Kies uit: brokkelbrein – onument – alcomobilist – ceremini – zeeleeuwen – toekomstbomen –reken-je-rijkfilosofie – carrière – e-mail – een-zes-is-binnenmentaliteit – computeren – bionade –gedeletet – voetballen – weet-je-nogverhalen – hen – überhaupt – biefstuk
c Sluit je boek en noteer op een apart blad nog eens duidelijk de drie categorieën van neologismen die je leerde kennen in de tekst.
d Zoek zelf nog vijf neologismen. Binnen welke categorie kun je ze plaatsen?
2 Bekijk het interview uit VRT NWSlaat met Veronique De Tier van het Instituut voor de Nederlandse Taal en beantwoord de vragen.
a Het woordenboek is ‘een spiegel van de maatschappij waarin we leven’. Op welke twee manieren wordt dat uitgelegd?
-
b Uit welke drie bronnen haalt het woordenboek nieuwe woorden?
c Welke woorden komen in het woordenboek?
3 Lees het artikel uit De Standaard naar aanleiding van de verkiezing van het Woord van het Jaar.
a De tekst bevat heel wat moeilijke woorden. Probeer de betekenis af te leiden uit de context of zoek ze op.
b Vat de tekst in je eigen woorden samen in maximaal zeven volzinnen.
ONZE
Elk jaar verkiezen we een Woord van het Jaar. In Vlaanderen won ‘knaldrang’ en Franstalig België heeft zijn favoriet gekozen: de tongbreker ‘ultracrépidarianisme’. Maar wat winnen we precies met zo’n woord? – Sarah Vankersschaever
Ultracrépidarianisme. Blijven oefenen: ultracrépidarianisme. Tot de letterbrij opheldert. Al zullen we het woord uiteindelijk toch vergeten, ultracrépidarianisme. Want als je iets zo vaak moet oefenen, is het geen blijver.
En ‘de Woorden van het Jaar’ zijn vaak geen blijvers, weet Rik Vosters, hoofddocent Nederlandse taalkunde aan de VUB. ‘Het winnende woord is vaak spitsvondig, het klinkt goed door alliteraties of een vormelijke speelsheid, maar het hele circus is wat artificieel. De winnende woorden zijn meestal niet natuurlijk in onze taal gekiemd om er dan evident hun plek in te vinden en te behouden. Neem nu “knaldrang”: niet toevallig een samenstelling, iets waar de Nederlandse taal zich goed toe leent en wat vaak tot heel leuke vondsten leidt. Een creativiteit die ik toejuich, want taal is er niet alleen om over te zeuren. Maar het reflecteert toch vooral de vluchtige actualiteit.’ Zodra de knaldrang verzadigd is, verdwijnt het gevoel en dus ook de aanleiding om het woord te gebruiken.
Vosters ging samen met enkele van zijn studenten na wat de houdbaarheidsdatum is van winnende woorden. Conclusie: ‘Ze pieken doorgaans in het verkiezingsjaar en zinderen nog na in het jaar daarop maar nadien vervliegen ze omdat de actualiteit vervliegt.’
Naar: www.standaard.be
We zijn bijzonder creatief in het maken van neologismen. Sommige neologismen zijn echt originele vondsten.
- Een voorbeeld daarvan is de : een ceremonie in miniformaat, vaak in eigen huis met alleen de dichtste vrienden en familie.
- Een ander voorbeeld is het : een herdenkingsmonument waarvan het basisontwerp een onderbroken cirkel is. Die staat symbool voor de familie- en vriendenkringen waaruit dierbaren zijn weggevallen. De beginletter verwijst ook naar de cirkelvorm.

Taal verandert voortdurend: oude woorden verdwijnen, maar er komen ook dagelijks nieuwe woorden of ‘neologismen’ bij.
1 Veel neologismen zijn minder nieuw dan ze lijken, omdat twee al bestaande woorden worden samengevoegd tot een nieuwe samenstelling
- Mensen met een kunnen zich niet lang concentreren op één taak, als gevolg van de voortdurende stroom aan digitale prikkels.
- Verschillende steden en gemeenten investeren in . Dat zijn bomen die zowel boven als onder de grond veel ruimte krijgen om te groeien, zodat ze heel groot en meer dan 120 jaar oud kunnen worden.
Er zijn ook veel nieuwe samenstellingen waarin bestaande woorden verkort zijn, zoals in:
-
= automobilist die onder invloed van alcohol rijdt
-
= biologische limonade
Er bestaan ook hele lange samenstellingen, zoals:
--
Denk eraan dat je een samenstelling altijd als één woord schrijft.
2 Een tweede categorie van neologismen zijn de leenwoorden. We ontlenen woorden uit andere talen. Een vreemd woord is een leenwoord dat we letterlijk overnemen en niet aan de Nederlandse uitspraak of spelling aanpassen. Een aantal voorbeelden van vreemde woorden zijn:
Het verschil met een bastaardwoord is dat zo’n woord wel werd aangepast aan de spelling, uitspraak of woordvorming van het Nederlands.
- = beefsteak, een steak van een rund
Werkwoorden worden ook vaak aangepast aan het Nederlands, zoals in:
- Zit je nu weer te ?
- Oh nee, ik heb per ongeluk dat bestand !
Leenwoorden komen tegenwoordig heel vaak uit het Engels. Vroeger namen we vooral woorden over uit het Frans en nog langer geleden uit het Latijn.
3 We spreken ook van neologismen als bestaande woorden een nieuwe betekenis krijgen. Die extra betekenis is vaak een figuurlijke betekenis.
- Het woord kan ook ‘het betere voetballen’ betekenen in zinnetjes als ‘Ik vind dat ik nog te weinig aan voetballen toe kom’ (van een speler die net terug is na een blessure).
- Een ander voorbeeld is : een pesterige tactiek waarmee iemand een discussie probeert te winnen door op een schijnbaar vriendelijke manier eindeloos door te vragen naar argumenten. De benaming komt uit een Amerikaanse strip uit 2014, waarin een zeeleeuw een vrouw die haar afkeer van zeeleeuwen heeft laten blijken, op die manier lastigvalt.

De meeste neologismen zijn zelfstandige naamwoorden, bijvoeglijke naamwoorden of werkwoorden. Het is uitzonderlijk dat er nu ook een persoonlijk voornaamwoord als neologisme opduikt.
Het Nederlands kende tot voor kort geen aparte voornaamwoorden voor non-binaire personen. Naar een man verwees je met ‘hij’ en ‘hem’, naar een vrouw met ‘zij/ze’ of ‘haar’. Een non-binair
persoon kun je nu ook met benoemen, zoals in de zin ‘Kim is niet thuis; ik zag hen net lopen in de stad’.
1 Wat heb jij onthouden over neologismen? Noteer minstens drie volzinnen.
De woordenschat van een taal is niet vast: soms verdwijnen er woorden, soms komen er woorden bij. Een neologisme is een nieuw woord of een bestaand woord dat een nieuwe betekenis krijgt. Vaak ontstaan nieuwe woorden als er een uitvinding gebeurt of een grote verandering plaatsvindt.
Zo ontstonden in maart deze nieuwe woorden voor samen online iets drinken: beeldborrelen, e-peritieven, apperitieven
Je kunt de relevante informatie in een bron selecteren 1
Je kunt relevante informatie uit een bron schematisch weergeven


Je kunt de hoofd- en bijzaken van elkaar onderscheiden
1 Wanneer ik informatie in een tekst aanduid,
a vind ik het moeilijk om niet alles / te veel informatie aan te duiden.
b duid ik vaak te weinig informatie aan.
c slaag ik erin om enkel de belangrijke informatie te selecteren.
2 Ik heb bij het lezen/beluisteren van een bron
a vaak moeite om de hoofd- en bijzaken en voorbeelden van elkaar te onderscheiden.
b soms moeite om de hoofd- en bijzaken en voorbeelden van elkaar te onderscheiden.
c geen moeite om de hoofd- en bijzaken en voorbeelden van elkaar te onderscheiden.
3 Wanneer ik een tekst lees,
a zie ik zelden of nooit de verbanden tussen de verschillende tekstonderdelen.
b zie ik soms de verbanden tussen de verschillende tekstonderdelen.
c zie ik meestal de verbanden tussen de verschillende tekstonderdelen.
4 Wanneer ik studeer,
a maak ik nooit een schema van de leerstof.
b maak ik soms een schema van de leerstof (dat is bijvoorbeeld afhankelijk van het type of de hoeveelheid leerstof).
c maak ik altijd een schema van de leerstof.
5 Een doorlopende tekst schematiseren
a is voor mij een uitdaging.
b lukt me soms goed, maar is afhankelijk van het soort tekst.
c lukt me meestal goed.



Gebruik het stappenplan om na te gaan wat je nog kunt verbeteren.
Antwoordde je voornamelijk c? Een bron schematiseren lukt je al aardig.
relevante informatie te selecteren en op een overzichtelijke wijze weer te geven.
moeilijk voor jou. Ga aan de slag met het stappenplan om zo stapsgewijs de
Antwoordde je voornamelijk a of b? Het schematiseren van een tekst is nog
2 Geef twee voordelen van het schematiseren van een bron.
3 Hoe begin jij aan het schematiseren van een tekst? Bespreek met een medeleerling hoe jullie dat zouden aanpakken en maak een kort stappenplan.








HOE
Voor je aan een schema kunt beginnen, is het steeds belangrijk om je bron aandachtig te bestuderen. Je kunt hiervoor volgend stappenplan gebruiken.
Hoe schematiseer je informatie?
Voor het lezen
1 Bekijk de inhoudstafel van de tekst.
2 Bekijk de titel en tussentitels. Hou daarbij rekening met het niveau van elke (tussen)titel.
3 Bepaal het centrale thema van de tekst aan de hand van de informatie die je kunt afleiden uit de inhoudstafel, de titel en de tussentitels.
4 Bekijk de overige gegevens die informatie geven over de tekst (afbeeldingen, grafieken, bron, publicatiedatum, auteur ...)
5 Ga – aan de hand van de inhoudstafel, titel en tussentitels – na of de tekst is opgesteld aan de hand van een vaste tekststructuur.
Tijdens het lezen
6 Markeer de kernzin van elke alinea.
7 Omcirkel de elementen (signaalwoorden) die de samenhang en structuur van de tekst weergeven.
8 Noteer, waar relevant, een of meerdere kernwoorden over de inhoud van de alinea naast de alinea.
9 Onderstreep de zinnen die extra informatie geven over de kernzin van de alinea. Kernzinnen zijn meestal abstract geformuleerd en geven onvoldoende informatie.
10 Duid – naast de reeds aangeduide informatie – alle overige elementen in de tekst aan die volgens jou belangrijk zijn.
Uit onderzoek blijkt dat jezelf vragen stellen een uitstekende methode is om leerstof beter te leren en om de leerstof beter te onthouden. Het zorgt ervoor dat je de leerstof actief verwerkt.
Bedenk tijdens het bestuderen van de bron al enkele vragen om de informatie tussendoor of later op alinea- of tekstniveau te herhalen. Beantwoord vervolgens die vragen op basis van wat je je nog herinnert.
Op p. 156-158 vind je de tekst Als u dit leest, word u boos. Aan de hand van het stappenplan haal je zelf alle relevante informatie uit de tekst. Uiteindelijk maak je een schema op basis van die informatie.
Voor het lezen
Zonder de tekst volledig te lezen, kun je al heel wat informatie achterhalen. Beantwoord de volgende vragen voordat je de tekst leest. Doe dit door enkel te kijken naar de lay-out en structuur van de tekst.
1 Heeft de tekst een inhoudsopgave? ja nee
2 Som de titel en tussentitels van de tekst op. Hou daarbij rekening met het niveau van elke (tussen) titel.
3 Bekijk nu aandachtig die titel en tussentitels.
a Wat is volgens jou het centrale thema (het basisidee) van de tekst?
b Welke informatie over de inhoud kun je afleiden?
c Welke voorkennis heb je reeds over dit onderwerp?
4 Bekijk de overige gegevens die informatie geven over de tekst.
a Zijn er naast de tekst nog andere gegevens die je informatie geven (afbeeldingen, grafieken, bron)? ja nee
b Welke informatie kun je hieruit afleiden over de tekst?
c Welk teksttype verwacht je? Waarom denk je dat?
reclameboodschap klachtenbrief verslag krantenartikel gebruiksaanwijzing
bijdrage aan een boek andere …
5 Welke tekststructuur verwacht je? Motiveer je keuze. probleemstructuur maatregelstructuur evaluatiestructuur handelingsstructuur onderzoeksstructuur chronologische structuur
6 Markeer de kernzin van elke alinea.
Bekijk de vaste tekststructuren in het Kennisoverzicht op p. .
7 Omcirkel de elementen (signaalwoorden en uitdrukkingen) die de samenhang van de tekst weergeven.
8 Schrijf naast elke alinea een of meerdere kernwoorden over de inhoud van die alinea.
Weetje: Grondlegger van de dt-regel is Arnold Moonen, een predikant uit Deventer, van wie het hart eigenlijk meer bij de taalkunde dan bij het prediken lag. In 1706 stelde hij in zijn Nederduitsche Spraek-kunst voor om <d> te schrijven in ik word, maar <dt> in hij wordt Dat voorstel deed hij naar analogie met de spelling van werkwoorden waarvan de stam niet op ‘d’ eindigt. Je schrijft hij werkt, met werkwoordstam werk plus uitgang ‘-t’, en daarom schrijf je ook hij wordt, met werkwoordstam word plus uitgang ‘-t’, ook al hoor je in dat laatste geval enkel [t]. Zo legde Moonen, meer dan driehonderd jaar geleden, de basis van onze werkwoordspelling volgens het gelijkvormigheidsprincipe [► p. 206]: werkwoordsvormen die eenzelfde grammaticale functie uitdrukken, bijvoorbeeld ‘derde persoon enkelvoud’, spel je ook op een gelijkaardige manier.
Waarom we soms vergeten dat ik nooit ‘t’ drink
Vraag je professoren naar de fouten die hen het meest storen in teksten van studenten, dan blijken spelfouten voor de grootste ergernis te zorgen. Toch blijkt uit onderzoek dat studenten eigenlijk de meeste fouten maken in de structuur van hun tekst, en daarnaast moeite hebben om een consistente academische stijl aan te houden. Aan een spelfout wordt dus zwaarder getild dan aan een andere tekstfout, al zit er gradatie in de ergernis. Occasionele tikfoutne, klassieke instinkers als adellijk of fouten tegen de tussen-n worden nog weleens door de vingers gezien. Op een dt-fout staat, bij wijze van spreken, niets minder dan de doodstraf, omdat de dt-regels zo helder zijn. Toch blijven we met z’n allen zondigen tegen die regels. Hoe komt dat?
Alle inzichten uit dit thema zijn een samenvatting van veel uitgebreider onderzoek dat werd uitgevoerd door psycholinguïst Dominiek Sandra en zijn onderzoeksgroep aan de Universiteit Antwerpen.
De dt-regel:
hoe gaat die ook alweer?
De dt-regel is het beruchtste en meest gevreesde onderdeel van de werkwoordspelling. Het Groene Boekje heeft ruim zes pagina’s nodig om die werkwoordspelling uit de doeken te doen. Toch is bijna iedereen het erover eens dat de dt-regels doorzichtig en makkelijk te beschrijven zijn. In de eerste plaats mag aan de werkwoordstam, doorgaans is dat de infinitief (luisteren, antwoorden) zonder ‘-en’, niet worden geraakt bij de vervoeging. Luister blijft luister, antwoord blijft antwoord Bovendien moet eenzelfde grammaticale functie, derde persoon enkelvoud bijvoorbeeld, altijd met dezelfde uitgang worden uitgedrukt – een <t> in dit geval: hij luister-t, zij antwoord-t. Dat wordt het gelijkvormigheidsprincipe genoemd. [► p. 206]

DE DT-REGEL SAMENGEVAT
Het dt-experiment:
wat was de opzet?
De dt-regels worden al in het lager onderwijs aangeleerd. Toch blijkt vroeg begonnen hier niet half gewonnen, zelfs niet met de zware sancties die tijdens de schoolcarrière vaak aan dit soort overtredingen zijn verbonden. We blijven dt-fouten maken, ook wie beweert er nooit te schrijven. Om te onderzoeken hoe dat komt, ontlokte de onderzoeksgroep psycholinguïstiek van de Universiteit Antwerpen dt-fouten aan proefpersonen via een dictee. Dat was een gatentekst, waarin proefpersonen ontbrekende woorden moesten invullen: niet-evidente werkwoordvormen (waar het onderzoek om draaide) of een ander moeilijk woord als parallellogram (om de aandacht af te leiden van het eigenlijke onderzoeksonderwerp). Daarna gingen ze kijken of er een systematiek in de werkwoordfouten zat.
Eén ding hielden de onderzoekers bij het experiment voor ogen: ze wilden weten wat er gebeurt als mensen de spellingregels níét bewust kunnen toepassen en daarmee de kans op dt-fouten toeneemt. Heb je veel tijd,
Je schrijft: En dus schrijf je ook: Kortom, de regel luidt:
ik luister ik antwoord stam + 0
jij/hij/zij luister-t jij/hij/zij antwoord-t Je hoort een [t], maar schrijft toch <dt> omdat de werkwoordstam antwoord bewaard moet blijven.
wij/jullie/zij luister-den wij/jullie/zij antwoord-den Je hoort slechts één [d], maar schrijft ze dubbel als <dd> omdat je de eerste, tweede of derde persoon meervoud in de verleden tijd altijd uitdrukt met <den> die je aan de stam antwoord plakt.
wij hebben ge-luister-d wij hebben ge-antwoord
Volgens de gelijkvormigheidsregel zou je hier geantwoord-d verwachten, maar geen regel zonder uitzondering: in het Nederlands schrijf je geen dubbele medeklinker aan het einde van een woord.
stam + t
stam + den
ge + stam + d
dan heeft je werkgeheugen ruim de tijd om je mentale grammatica open te slaan, de dt-regels op te roepen en ze zorgvuldig toe te passen. (Alleen echt nonchalante spellers nemen bij voldoende tijd daarvoor de moeite niet.) Door proefpersonen veel bedenktijd te geven, zouden onderzoekers enkel te weten komen hoe goed mensen de regels beheersen (en hoezeer ze zich inspannen om geen fouten te maken). Dat moesten ze dus vermijden.
Daarom werd bij het experiment de capaciteit van het werkgeheugen zo veel mogelijk onder druk gezet. De proefpersonen kregen (te) weinig tijd voor het dictee, zodat ze niet lang konden nadenken en nauwelijks konden nalezen. Spellen verloopt dan reflexmatig en niet volgens ‘de regels van het spel’. Bovendien kregen ze enkel de uitdagendste werkwoordvormen invullen. Zolang mensen moeten schrijven wat ze horen, gaat het namelijk goed. Klankzuivere vormen als hij loop-t of zij speel-t zijn geen probleem, omdat de uitspraak helpt bij de spelling. Risicovormen zijn de homofonen: werkwoordvormen die hetzelfde klinken, maar die je anders kunt spellen. Voorbeelden zijn word-wordt, vermoed-vermoedt en herhaalt-herhaald, verhuist-verhuisd. Veel homofoonparen zijn er niet: hun aantal maakt slechts 5tot 10
procent uit van alle Nederlandse werkwoordvormen en ook hun frequentie in teksten bedraagt maar 5 tot 10 procent van alle werkwoordvormen. Toch veroorzaakt die minderheid net de grootste problemen. Om de juiste spelvorm van homofonen uit te kiezen, moet je een zin immers grammaticaal gaan analyseren. Dat kost tijd die de proefpersonen in het experiment dus niet kregen.
3


Het dt-experiment: wat waren de resultaten?
Als mensen snel moeten spellen, zo blijkt uit de fouten in het proefdictee, dan laten ze zich leiden door hun mentale lexicon en kiezen ze voor de spelvorm van een homofoonpaar die het frequentst voorkomt. Dat fenomeen heet ‘homofoondominantie’



Dat zit zo. Onze hersenen slaan niet alleen spellingregels op, ze bevatten ook een gigantisch woordgeheugen. Dat woordgeheugen bewaart enerzijds woorden zoals ze in het woordenboek (een lexicon) worden opgenomen, vandaar: mentaal lexicon. Voor werkwoorden is het woordenboeklemma steeds de onverbogen vorm, bijvoorbeeld herhalen. Anderzijds onthoudt het woordgeheugen ook vaak voorkomende vormen van woorden, bijvoorbeeld herhaal, herhaald en herhaalt. Dat is een






Bij tijdsdruk loopt het woordgeheugen het werkgeheugen voor de voeten.
enorme hulp bij het schrijven: zonder die opgeslagen individuele woordvormen zouden taalgebruikers spellen als zesjarigen, die over de schrijfwijze van elk woord moeten nadenken.
Bij weinig tijd, zoals in dit proefdictee, maar ook tijdens een chatsessie bijvoorbeeld, roept het woordgeheugen die vaak voorkomende werkwoordvormen sneller op dan het werkgeheugen de spellingregels kan oproepen die van toepassing zijn. Omdat het mentale lexicon bovendien gevoelig is voor woordfrequentie, zitten woordvormen die we het frequentst tegenkomen het best ingeprent. Daarom schrijven proefpersonen die dominante homofonen vaker op dan de niet-dominante tegenhangers als ze snel moeten beslissen. In het Nederlands komen de dominante homofonen herhaald en wordt meer voor dan de niet-dominante spelvormen herhaalt en word. Daarom komt een dt-fout als hij herhaald meer voor dan ik heb herhaalt, en een dt-fout als ik wordt meer dan hij word

Het experiment onderstreepte ook het belang van het werkgeheugen. Hoe méér dat belast wordt, hoe minder capaciteit er overblijft om de spellingregels toe te passen. En dat resulteert in dt-fouten. Naast tijdsdruk zorgden de onderzoekers ook voor een andere belastende factor in een aantal van de proefdicteezinnen. In sommige zinnen plaatsten ze bewust véél woorden tussen de homofone werkwoordvorm en het onderwerp, in andere zinnen volgde het werkwoord gewoon op het onderwerp. De proefpersonen maakten significant meer dt-fouten in zinnen waar onderwerp en werkwoordhomofoon niet naast elkaar stonden, zoals in langere, complexe zinnen als “Ik vind het een tikkeltje beschamend dat ik ook jaren na dat voorval in de middelbare school nog steeds verdrietig wordt bij de herinnering”. Hoe verder het onderwerp verwijderd is van het homofone werkwoord, hoe tijdrovender het zoekproces in het werkgeheugen naar het onderwerp en hoe meer kans dat het woordgeheugen de dominante, maar nietcorrecte vorm wordt suggereert.

Het dt-experiment:








wat is de moraal van het verhaal?
De vraag blijft of die verklaring voor dt-fouten de fouten ook legitimeert. Sommige pedagogen vinden dat we maar beter tolerant moeten zijn: de spelling van werkwoordvormen sluit gewoon niet aan bij hoe het geheugen van taalgebruikers werkt. Anderen zijn van mening dat we juist wél zwaar moeten blijven tillen aan dt-fouten. Die fouten ontstaan doordat de capaciteit van het werkgeheugen te klein is om de dt-regel snel genoeg toe te passen. Er zit niets anders op dan teksten met
aandacht na te lezen. Zo krijgen je hersenen de tijd om de (op zich heldere en makkelijke) dt-regels op te roepen en om fouten tegen die regels te detecteren en te corrigeren. Dt-fouten verraden volgens hen dus dat je een tekst in de gauwte hebt geschreven, zonder nalezen. En die nalatigheid roept ergernis op.
Pragmatici, tot slot, stellen voor om de ernst van een dt-fout te laten afhangen van de schrijfsituatie en het type speller. Dt-fouten moeten volgens hen meer in rekening worden gebracht wanneer de schrijver tijd heeft gehad om de tekst na te lezen, bijvoorbeeld bij een bachelorproef, en minder streng worden beoordeeld wanneer de tekst onder schrijfdruk geschreven is, zoals bij een examen of een e-mail. Ook het type speller is van belang. Gaat het om beroepsschrijvers, zoals talenstudenten, journalisten, vertalers en leerkrachten Nederlands, dan moeten dt-fouten zwaarder doorwegen dan bij niet-professionele taalgebruikers.
Weetje: Onze natuurlijke neiging om onder tijdsdruk de frequentste vorm te schrijven, leidt vaker níet dan wel tot dt-fouten. We moeten immers per definitie vaker de meest voorkomende vorm opschrijven. Alleen: tot een foutloze dt-parcours leidt die reflex niet en dat wordt wel van tekstschrijvers verlangd.
Het woordgeheugen begint individuele woordvormen op te slaan zodra we als kind leren schrijven. Als volwassenen beschikken we dus over een flinke verzameling woordvormen-stoorzenders. Dat is ook de vermoedelijke reden waarom anderstaligen soms beter scoren bij werkwoordspelling. Hun Nederlandse woordgeheugen bevat niet zoveel woordvormen als dat van de gemiddelde Vlaming of Nederlander. Daardoor worden ze er minder door beïnvloed en passen ze de pas geleerde Nederlandse spellingregels bewust toe. Wellicht verklaart dat ook waarom Nederlandstaligen soms beter Engels of Frans spellen dan een Engelsman of Fransman: het Nederlandse woordgeheugen bevat minder Franse en Engelse stoorzenders.


9 Kernzinnen zijn meestal abstract geformuleerd en geven niet voldoende informatie. Duid de zinnen aan die extra informatie geven over de kernzin van de alinea.
10 Welke elementen zijn nog belangrijk volgens jou? Duid die aan in de tekst.
11 Vergelijk alle elementen die jij aanduidde met die van een medeleerling.
a Hebben jullie dezelfde elementen aangeduid?
b Bespreek de verschillende keuzes die jullie hebben gemaakt.
ZELF AAN DE SLAG: DE BRON IN EEN SCHEMA
Het doel van een schema is de inhoud van een bron korter weergeven. Daarnaast verduidelijkt een schema ook de verbanden tussen tekstdelen.
1 Wat zijn volgens jou de vormelijke en inhoudelijke kenmerken van een goed schema?
Aan de hand van de vorige opdrachten ben je actief aan de slag gegaan met de informatie uit Als u dit leest, word u boos. De volgende stap is deze informatie weergeven in een duidelijk schema.
2 De leerkracht toont je enkele veelvoorkomende schema’s. Welke methode verkies jij om deze tekst schematisch weer te geven? Motiveer je keuze.
3 Maak op p. 160 een schema van de tekst aan de hand van de door jou gekozen methode. Je hebt dit schema in een latere les nog nodig.
4 Bekijk de evaluatiematrix op p. 161.
a Laat jouw schema door een medeleerling beoordelen.
b Beoordeel ook zelf het schema van een medeleerling.
c Formuleer ook een suggestie die volgens jou het schema beter zou maken.
5 Maak een nieuwe versie van je schema aan de hand van de feedback die je kreeg.
GOED VOLDOENDE ONVOLDOENDE
volledigheid en duidelijkheid
Je haalt alle relevante informatie uit de brontekst.
- Je vermeldt het merendeel van de relevante informatie uit de brontekst, maar vergeet enkele zaken.
- Je vermeldt naast de relevante informatie ook enkele zaken die niet relevant zijn.
- Je schema bestaat uit te veel irrelevante informatie.
- Je schema bevat onvoldoende relevante informatie.
- De informatie is duidelijk gestructureerd.
- Hoofd- en bijzaken worden van elkaar onderscheiden. Er wordt duidelijk aangegeven wanneer iets een voorbeeld is.
De verbanden tussen de verschillende tekstonderdelen zijn duidelijk weergegeven.
vorm
- Je schema is geen doorlopende tekst. Je maakt geen gebruik van volzinnen, maar van een goede telegramstijl.
- Je maakt gebruik van duidelijke symbolen.
De omvang van je schema is niet te uitgebreid.
Aanvullende commentaar:
- De informatie is grotendeels duidelijk gestructureerd.
- Er wordt niet altijd duidelijk weergegeven wat een hoofdzaak, bijzaak of voorbeeld is.
De verbanden tussen de verschillende tekstonderdelen zijn meestal duidelijk weergegeven.
- Je schema is geen doorlopende tekst, maar je maakt af en toe nog wel gebruik van volzinnen.
- Je maakt doorgaans gebruik van duidelijke symbolen.
De omvang van je schema is net niet te uitgebreid.
- De informatie is niet duidelijk gestructureerd.
- Je maakt onvoldoende onderscheid tussen hoofdzaken, bijzaken en voorbeelden.
De verbanden tussen de verschillende tekstonderdelen worden onvoldoende weergegeven.
- Je schema is een doorlopende tekst. Je maakt geen gebruik van telegramstijl.
- Je gebruikt onduidelijke symbolen.
De omvang van je schema stemt niet overeen met de opdracht.
Je maakt kennis met Poëzieweek en Gedichtendag

Je leert te genieten van eenvoudige gedichten
2020
Je denkt na over de thema’s die in de gedichten aan bod komen
Komt wel goed























4 Scroll eens door de Instagrampagina van de drie dichters. Noteer hieronder nog een gedicht dat je ontroert of aanspreekt.


5 Noteer ook één gedicht dat je naar iemand zou willen sturen.
Waarom stuur je me dit gedicht?

6 Volg jij een Instagrampagina van iemand die poëzie of teksten schrijft of deelt? Welke?
7 Ben je gevoelig voor de kracht, de impact van woorden? Ben je gemakkelijk ontroerd door iets wat iemand zegt of schrijft?
8 Wat maakt volgens jou dat mensen graag gedichten lezen?
9 Wat weet je over Gedichtendag? Probeer eerst samen met een medeleerling zoals in De Slimste Mens ter Wereld minstens vijf dingen te bedenken. Wanneer jullie niet verder geraken, lees dan het Onderweg-kader en haal er de belangrijkste woorden uit.
POËZIETIPS



Sinds wordt elk jaar eind januari poëzie extra in de kijker gezet. Op initiatief van Poetry International werd de laatste donderdag van januari uitgeroepen tot Gedichtendag. Een breed samenwerkingsverband van dichters, literaire organisaties, scholen, bibliotheken en andere verenigingen zorgde ervoor dat de donkere januaridagen in Vlaanderen en Nederland een poëtische invulling kregen.
De campagne van de eerste Gedichtendag in werd afgetrapt met de verkiezing van het mooiste gedicht. Na een breedgedragen stemcampagne haalde Denkend aan Holland van Hendrik Marsman het van onder meer De moeder de vrouw van Martinus Nijhoff.
Bij elke editie werd aan een dichter gevraagd om tien gedichten te schrijven die aansloten bij het thema van Gedichtendag. De eerste Gedichtendagbundel werd geschreven door Toon Tellegen. Later volgden onder meer nog Hugo Claus, Tom Lanoye, Remco Campert, Judith Herzberg, Antjie Krog …
Door het grote succes van Gedichtendag werd in beslist om Gedichtendag uit te werken tot een volledige Poëzieweek. Hierbij aansluitend werd de Gedichtendagbundel omgedoopt tot het Poëziegeschenk. Met een bundeling van grote en klein poëzie-activiteiten willen de organisatoren een groter bereik creëren voor poëzie.
Bron: www.poezieweek.com
1 Schrijf jij soms gedichten? Wanneer?
2 Lees jij soms gedichten? Wanneer?
3 ‘Schenk’/stuur je soms iemand een gedicht? Wanneer?
4 Bij welke momenten en gelegenheden komen gedichten goed van pas?
5 Lees samen met een medeleerling de negen gedichten op deze en volgende pagina’s een eerste keer door.
a Zet meteen een kruisje bij de gedichten die je leuk vindt.
b Bij welke gelegenheid passen deze gedichten? Plaats ze in de tabel.
c Plaats ook de gedichten van Lars van der Werf, Rupi Kaur en Ruth Van de steene op p. 162 bij een categorie.
afscheid verjaardag liefde (zelf)reflectie andere
6 Kies samen drie gedichten uit die jullie de mooiste vinden en beantwoord de bijhorende vragen.
Zondag
Zondag had ik me voorgesteld in de hangmat door te brengen tussen de stevige stammen van de bomen dicht boven de aarde en van de hemel ver genoeg verwijderd om me een mens op zijn plaats te voelen.
Maar het regende.
Remco Campert. Bij hoog en bij laag, 1959, De Bezige Bij
a Wat is voor jou het ultieme zondagsgevoel?
b Heb jij soms een voorstelling van hoe je wilt dat iets gaat verlopen en vind je het dan moeilijk als dat niet zo gebeurt?
c Wat zou de dichter bedoelen met ‘om me een mens op zijn plaats te voelen’?
Kingsize
Je zou geen kind kunnen krijgen om het geenkind te leren dat ook die keuze bestaat, daarvoor zou het wel een meisje moeten zijn – om het die vrijheid mee te geven. Als het geenkind een jongen is, zou je het leren hoe met meisjes om te gaan.
Je zou geen kunnen krijgen en het ook aan andere vrouwen willen laten zien, op het terras, de werkvloer, wanneer je op vakantie bent.
Anderen zullen eerst denken dat het welkind bij opa oma slaapt, dat je gescheiden bent, of nee
het geenkind komt als allerlaatste.
Je zou keer op keer het nietkind naar voren schuiven, als de keuze die je hebt gemaakt en hoe je die met lege handen draagt.
Laurine Verweijen. Gasthuis
a Waarover gaat dit gedicht?
b Hoe noemt de dichter het kind dat er niet is?
c Welke emotie lees je tussen de regels van het gedicht door? Verklaar die emotie.
d Leg uit: ‘en hoe je die met lege handen draagt.’
e Heb jij een kinderwens?
Het zinneloze geraaskal van moederloze moeders
Voor Annemarie en Ilse
Mijn zus en ik praten niet over de dood van mijn moeder
Elk jaar als het Moederdag haar verjaardag
Haar sterfdag
Kerstfeest wordt sturen we elkaar berichten
Gecodeerd in het onvermogen elkaar te troosten
Hoi
Mán oké
Oké
Yep
Xieje
Ik hou van jou
Ik ook van jou
Het zinneloze geraaskal
Van moederloze moeders
Alfred Schaffer (origineel: Ronelda S. Kamfer). Mammie
a Wat willen de woorden die de zussen naar elkaar sturen eigenlijk zeggen?
b Is het erg dat ze die woorden niet vinden?
c Wie zijn Annemarie en Ilse? Waarom draagt ze het gedicht aan hen op, denk je?
d Dit gedicht draagt een paradox in zich. Leg uit.
e Ben jij al een dierbare verloren? Vind je het moeilijk om daarover te praten?
Mensen zeggen
Mensen zeggen; als jij geen vlees eet
Kun je net zo goed geen vis eten
Kun je net zo goed geen plant eten
Kun je net zo goed niet in een stoel gaan zitten
En zo is het:
Het is wreed om in een stoel te gaan zitten
Die niet in jou kan gaan zitten.
Ilse Starkenburg. De boom valt op mij, 2017, De Arbeiderspers
a Waarover gaat dit gedicht?
b Waarom ‘zeggen mensen’ die dingen zo vaak, denk je?
c Wat wil de dichteres aantonen met die laatste, absurde zin, denk je?
d Hoe sta jij tegenover vegetarisme?
Kijken naar koffie die doorloopt Maakt dat genoemde koffie Trager doorloopt En lekkerder wordt.
Zo ongeveer gaat het ook Met andere zaken.
Ik kijk naar je, ik kijk naar mij, dat is iets heel anders.
Overal zijn in schitterende werking intrigerende processen, erop gericht ons te ontroeren.
a Welke link heeft TikTok met dit gedicht?
b Waarnaar kun jij uren kijken? Welk intrigerend proces kan jou soms ontroeren?
c Waarom sluit dit gedicht niet echt aan bij de tijdsgeest?
Vandaag eens geen gedonder aan mijn hoofd
Zeker: het is weinig opwekkends
Wat de avondbladen ons melden
(om van de ochtendbladen nog maar te zwijgen)
Maar de zon schijnt
En ik loop door de wereld
Op mijn eerste en mijn laatste benen
Cees Buddingh. Zo is het dan ook nog weer eens een keer
a Cees Buddingh schreef dit gedicht in 1963. Stel je voor dat dit een recent gedicht was, door welke woorden zou je avond- en ochtendbladen dan vervangen?
b ‘Ik loop door de wereld op mijn eerste en laatste benen’. Wat wil de dichter daarmee zeggen?
c In zijn boek De meeste mensen deugen schrijft Rutger Bregman het volgende.
Stel: er komt morgen een nieuwe drug op de markt. Hij is extreem verslavend, en verspreidt zich binnen de kortste tijd onder de bevolking. Wetenschappers doen grondig onderzoek en concluderen dat de drug gepaard gaat met, ik citeer, ‘misperceptie van risico’s, angst, negatieve gevoelens, aangeleerde hulpeloosheid, vijandigheid ten opzichte van anderen en afstomping’. Zouden we het middel gebruiken? Zouden onze kinderen het mogen proberen? Zou de overheid het legaliseren? Het antwoord is drie keer ja. Ik heb het namelijk over een van de grootste verslavingen van onze tijd. Over een drug die we dagelijks innemen, die zwaar wordt gesubsidieerd en op enorme schaal aan onze kinderen wordt verstrekt: het nieuws!
Op welke manier zijn de boodschap van Cees Buddingh en Rutger Bregman gelijkaardig?
d Ben je het daarmee eens?
Er was mos. Het levende bewijs dat je kunt groeien zonder wortels.
Tjitske Janssen. Koerikoeloem
a Welke hoopgevende boodschap zit er in dit superkorte gedicht vervat?
b Welk beeld gebruikt ze daarvoor?
c Kun je zelf een soortgelijk hoopvol gedichtje bedenken?
Wellicht zijn de draken in ons leven, uiteindelijk wel prinsessen die er in angst en beven slechts naar haken, ons eenmaal dapper en schoon te zien ontwaken.
Wellicht is alles wat er aan verschrikking leeft, in diepste wezen wel niets anders, dan iets dat onze liefde nodig heeft.
Rainer Maria Rilke
a Dit gedicht roept op tot een bepaalde emotie, welke?
b Bedenk een ‘draak’ in jouw leven die mogelijk een prinses zou kunnen worden, als die wat meer liefde zou krijgen.
c Bedenk een moment waarop je zelf vervelend hebt gedaan tegen anderen, terwijl je je eigenlijk gewoon ongelukkig voelde en begrip wilde krijgen.
Lichter kon je me niet op pad sturen, Je nam me nog eens vast en zei
Dichter mag ik je niet bij me houden
Ik droeg je met me mee, maar vond Herinneringen onderweg, onder de baan
In kelders, metrostations en riolen
Lichter kon je me niet op pad sturen, Verder mocht je me niet laten gaan.
Abel Dossche
a Bedenk een moment waarvoor dit gedicht zeer geschikt zou zijn.
b ’Dichter mag ik je niet bij me houden’, wat bedoelt de ‘je’ daarmee in het gedicht?
c Soms geven mensen de reiziger iets mee; gebeurt dat in dit gedicht?
d Toch denkt de avonturier geregeld aan de ander, hoezo?
e Verklaar de laatste zin: ’Verder mocht je me niet laten gaan’.
1 Lees de woorden die hieronder staan. Markeer de woorden die jij oprecht mooi vindt.
2 Laat je je vooral leiden door de klank, de betekenis of de vorm van de woorden?
3 Bedenk samen met een medeleerling zelf nog vijf woorden die jullie opvallend mooi vinden.
4 Gebruik de woorden die je gemarkeerd én zelf neergeschreven hebt als inspiratie om samen een gedicht te schrijven. Uiteraard kun je ook nog andere woorden gebruiken. Je mag om beurten een woord toevoegen aan het gedicht. De lijntjes die er staan, zijn het aantal woorden dat het gedicht telt. Het is de structuur van jullie gedicht. Zorg ervoor dat de zinnen van je gedicht uiteindelijk kloppen: vervoeg de werkwoorden, pas enkelvoud aan naar meervoud … Succes!
5 Maak de vorige opdracht gerust een aantal keren totdat jullie tevreden zijn over jullie duo-gedicht. Het mooiste gedicht dragen jullie voor aan de klas.
6 Eén van Vlaanderens bekendste gedichten is verdwenen. Gebruik je kennis over poëzie, los samen met je medeleerlingen de raadsels op en puzzel het verdwenen werk tevoorschijn.

In fictie, reclame en zelfs in ons dagelijks taalgebruik gebruiken we vaak beeldspraak om iets onder woorden te brengen. We gebruiken woorden dan niet in hun letterlijke betekenis, maar proberen aan de hand van een beeld iets duidelijker of emotioneler onder woorden te brengen.
Vergelijking en metafoor
Bij een vergelijking breng je woorden met elkaar in verband omdat er een overeenkomst is. Je beschrijft de gelijkenis tussen beide woorden om de boodschap duidelijker, mooier of poëtischer te maken. Vaak gebruik je hierbij als, zoals, lijkt op, is als, maar die kunnen ook weggelaten worden. haar voeten zijn zo koud als ijs (of voeten als ijs – voeten van ijs – haar voeten, koud als ijs …)
Ook bij een metafoor is er sprake van vergelijking, maar daar wordt enkel het beeld nog genoemd. De heks stond al in het lokaal. (= kwade lerares)
De tomaat liep de kamer uit. (= iemand die fel bloost)
Personificatie
Bij een personificatie kent de dichter menselijke eigenschappen toe aan dingen of abstracte ideeën. Anders geformuleerd: iets ‘niet-levends’ krijgt menselijke eigenschappen.
De toekomst lacht je toe.
De wenskaart keek hem dreigend aan.
Synesthesie
Bij synesthesie vermengt de schrijver of spreker indrukken van twee zintuigen. Het maanlicht ritselt in een plas.
In die zin worden zicht (het maanlicht), en gehoor (het ritselen) vermengd om de weerspiegeling in een plas weer te geven.
Synesthesie komt ook geregeld voor in het ‘gewone’ taalgebruik. Warme kleuren zijn hip dit jaar. (= gevoel en zicht)
Hij houdt van de frisse geur van gemaaid gras. (= gevoel en geur)
Metonymie
Een metoniem is een vorm van beeldspraak waarbij een woord vervangen wordt door een ander woord op basis van een gemeenschappelijk verband. Dat is geen gelijkenis (zoals bij de metafoor); de woorden bij een metoniem hebben een relatie. Als je bijvoorbeeld zegt Geef me nog een glas, dan bedoel je niet een leeg glas, maar vooral de inhoud daarvan. Andere voorbeelden zijn:
De vloot van kapitein Mercado telde twintig zeilen (= schepen; hier benoem je een deel om het hele voorwerp aan te duiden.)
Ons museum heeft drie Van Goghs en een Rubens (= schilderijen; hier noem je de maker in plaats van het voorwerp.)
Maximus trok zijn ijzer en versloeg de andere gladiator. (= zijn zwaard; hier noem je het materiaal waarvan iets gemaakt is om het voorwerp aan te duiden.)
Rijm is de klankovereenkomst tussen woorden of lettergrepen die in elkaars buurt staan. plicht – gezicht, kast – mast
Als in een gedicht de versregels rijmen, kun je een rijmschema opstellen. Met letters geef je dan aan welke regels uit het gedicht met elkaar rijmen.
• gepaard rijm /aabb/
• gekruist rijm /abab/
• omarmend rijm /abba/



Een voorbeeld van een gepaard rijm /aabb/ vind je in deze strofe:
Een voorbeeld van een gekruist rijm /abab/ vind je in deze strofe:
Een voorbeeld van een omarmend rijm /abba/ vind je in deze strofe:
Herman Gorter. Verzen
oor
En je neus en je mond en je haar en je ogen en je hals waar je kraagje zit en je oor met je haar er voor.
Hij zei tot alle and’re spinnen: Vreemd, ik weet niet wat ik heb, Maar ik krijg zo’n drang vanbinnen Tot het weven van een web.
Annie M.G. Schmidt. Sebastiaan
Ik droeg nog kleine kleren, en ik lag Languit met moeder in de warme hei, De wolken schoven boven ons voorbij en moeder vroeg wat ‘k in de wolken zag.
Martinus Nijhoff. De wolken
Een dichter kan ook letterrijm gebruiken. In dat geval wordt niet de hele lettergreep herhaald, maar enkel de klinkers of de medeklinkers.
Assonantie is de opvallende herhaling van klinkers in opeenvolgende woorden of lettergrepen. Een ander woord voor assonantie is klinkerrijm
Ik wil haar graag vragen
Blijf jij hier bij mij
Alliteratie is de herhaling van de beginmedeklinkers in opeenvolgende woorden of lettergrepen. Een ander woord voor alliteratie is medeklinkerrijm
Velden vol met engelhaar
Zon en zee en feestgewoel
mijn miniatuurmensje
Lay-out
Heel vaak herken je een gedicht aan de vorm. De tekst loopt niet zoals bij een alinea van de linker- tot rechtermarge op de pagina. Een gedicht is opgebouwd uit verzen en strofes.
Ritme
Ritme is de indruk van beweging in gesproken taal. Het ritme in een gedicht wordt bepaald door de klemtonen en de opeenvolging van lange en korte klanken.
Rap is eigenlijk een poëzievorm op muziek. Hier is ritme heel belangrijk; om alles vloeiend en boeiend te laten klinken is een goed ritme cruciaal.
In België zijn de nummers van Tourist LeMC, Zwangere Guy, Slongs Dievanongs en Het hof van Commerce bekende voorbeelden.
In een gedicht is herhaling een krachtig middel om de nadruk op bepaalde woorden te leggen. Wanneer een woord op een beperkt aantal regels vaak vermeld wordt, komt het volop in de aandacht van de lezer te staan.
In Ik wou ik wou dat ik papier was van P. Mandelbaum krijgen de wens en het droomelement de volle nadruk door de herhaling van Ik wou aan het begin van de meeste regels en vaak ook binnen eenzelfde regel.
Ik wou ik wou dat ik papier was.
Ik wens mezelf van dik karton.
Ik wou ik wou dat ik je boek was.
Ik wou dat je me lezen kon.
Ik wou ik wou dat ik een kaft had.
Ik wens mezelf een sprookje groot.
Ik wou ik wou dat ik je boek was.
Ik wil zo graag bij jou op schoot.
P. Mandelbaum. Ik wou ik wou dat ik papier was
Cliché
Soms wordt een beeld zo vaak gebruikt dat het zijn originaliteit kwijt is en voorspelbaar wordt.
Mijn liefde voor jou is zo diep als de zee. Jij bent als de zon voor mij.
Contrast
In poëzie en reclame worden twee tegengestelde elementen vaak tegenover elkaar geplaatst. Het verschil beklemtoont de kenmerken van beide elementen. Zo lijkt iets moois nog mooier wanneer er een lelijk voorwerp tegenover staat. In fictie wordt contrast vaak gebruikt om de emoties van een personage nog sterker in de verf te zetten.
Een voorbeeld is iemand die droevig of eenzaam is op een moment dat alle anderen feestvieren of iemand die op een belangrijke dag een vriend of familielid verliest.
Hyperbool

Je gebruikt een overdrijving of je gaat een situatie groter voorstellen. Vaak doe je dat om irritatie of emotie uit te drukken.
Ik sta hier al uren te wachten.
Iedereen mag altijd alles doen, maar als ik ook maar één keer één woord zeg, dan ziet ze dat. Dat mens haat mij!
Het bewuste gebruik van een woord of woorden in verschillende betekenissen. Het is vaak komisch bedoeld en dus letterlijk een ‘spel met taal’. was ik maar een dichter, dan kon ik dichter bij jou zijn Stef Bos. Ik heb je lief
Je kunt een graphic novel herkennen en definiëren


Je kunt de verschillen tussen een graphic novel en een stripboek benoemen




Je bespreekt enkele fragmenten uit een graphic novel

1 Bekijk de fragmenten en beantwoord de vragen.
Het Verhaal van de Dienstmaagd
a geschiedenis, dystopie, identiteit
b vriendschap, afscheid, verlies
c zelfbeeld, overgewicht, autobiografie




de dystopie: verhaal waarin een negatief beeld van de toekomst wordt geschetst. Dat negatieve beeld geldt doorgaans als waarschuwing voor de gevolgen van bepaalde maatschappelijke ontwikkelingen. de autobiogra e: verhaal dat iemand schrijft over zijn/haar leven of over een aantal belangrijke periodes daaruit

Je gaat aan de slag met het artikel Volwassen geworden striproman biedt stof tot nadenken op de volgende pagina.
1 Lees de titel en de lead en bekijk de afbeeldingen. Duid aan welke termen volgens jou bij een graphic novel passen.
luchtig grappig kinderen
moeilijke thema’s volwassenen zoals een stripboek
2 Lees de tekst en beantwoord de vragen.
a Geef een synoniem voor een graphic novel.
b Wanneer verscheen de eerste graphic novel in Europa?
c Benoem drie vooroordelen over graphic novels die in het artikel benoemd worden.
d Hoe ondersteunen de tekeningen het verhaal in een graphic novel?
e Bekijk de cartoon en leg uit waarom die bij de titel van het artikel past.
‘Ik ben te oud voor prentenboeken.
Hebben jullie graphic novels?’

Bijna veertig jaar nadat de eerste graphic novel verscheen, lijkt het genre een vaste plaats te hebben verworven in de literaire wereld. De striproman is volwassen geworden.

Twee pagina’s met ogenschijnlijk eenvoudige lijntekeningen in basale kleuren. Geen tekstwolkje of begeleidend schrijven. Niets. De eerste pagina’s van Sabrina oogsten verwarring en nodigen vooral uit om goed plaatjes te kijken. Toch is dit niet zomaar een stripverhaal. De vuistdikke graphic novel werd vorig jaar bijna bekroond met de prestigieuze Man Bookers Prize en was daarmee niet het eerste boek in zijn soort dat hoge ogen gooide. Toch is de grens tussen stripverhaal en striproman flinterdun.

Nadat in 1972 de eerste roman in stripvorm in Europa verscheen, gebeurde er aanvankelijk niet veel. De ballade van de zilte zee van de Italiaanse striptekenaar Hugo Pratt vormde dan wel het startpunt van een heel nieuw genre, maar de striproman bleef lange tijd een buitenbeentje. Graphic novels zouden niet het literaire gehalte van een traditionele roman hebben, een veredeld stripverhaal voor volwassenen zijn of de leesluiheid bevorderen.
Toch veroverden ze langzamerhand de harten – en niet alleen die van lezers die het liefst een plaatjesboek bekijken. De verhaallijnen van de hedendaagse stripromans zijn dan ook te complex om ze snel even tussendoor te lezen. Complexiteit en herkenbare thema’s blijken een beproefd recept in het genre van de striproman. De Duitse striptekenaar Barbara Yelin werkt in de vuistdikke graphic novel Irmina een populair onderwerp op meeslepende wijze uit. Ingewikkelde levensvragen komen aan bod. De thematiek – goede en foute keuzes die zijn ingegeven door de omstandigheden – is zeker niet oppervlakkig, maar nodigt de lezer uit om zich te bezinnen over de tragiek van het leven. De zorgvuldig uitgewerkte tekeningen schetsen letterlijk een beeld dat ondersteunend is aan het verhaal en geven een haarfijne voorstelling van de context waarin de dialogen en gebeurtenissen plaatsvinden.
Precies dát is een van de grote verschillen tussen een stripverhaal en een striproman. Waar stripverhalen veelal zijn bedoeld als luchtige tussendoortjes, bieden veel graphic novels een volledige maaltijd. Geen lauwe hap of uitgekauwde onderwerpen, maar stof tot herkauwen en overdenken.
Dat vereist wel de nodige extra pagina’s, waardoor de stripromans zich niet beperken tot de 48 pagina’s die een niet-literair stripverhaal over het algemeen telt. Een van de weinige overeenkomsten tussen beide geïllustreerde verhaalvormen is de bladgrootte. Een gewoon boekformaat leent zich immers niet voor illustraties die een substantiële bijdrage leveren aan het verhaal. Die uitvoering heeft wel haar weerslag op de boekenprijs. Deze ligt gemiddeld tussen de twintig en de dertig euro, waarmee het genre iets duurder is dan een gemiddelde roman. De graphic novel wordt daardoor dan ook nadrukkelijk gepositioneerd voor lezers die er de waarde van inzien – en het bijhorende bedrag er dus voor neer willen tellen.


De toenemende creatieve vrijheid van de graphic novelists droeg in recente jaren bij aan de toenemende waardering van de graphic novel. Ze leverde complexe verhalen op waarin beeld en tekst dienstbaar zijn aan elkaar. Ondanks de platte en ogenschijnlijk simpele tekeningen gebeurt er in Sabrina zo veel dat het verhaal niet af is als de laatste bladzijde is uitgelezen. Een goede graphic novel zet de lezer aan het denken en nodigt uit om verder te kijken dan op het eerste gezicht kan worden waargenomen. Tekst en beeld zijn onmisbaar om het verhaal goed te begrijpen. De scheidslijn tussen strip en striproman blijft dun, maar de graphic novel is zeker geen voer voor luie lezers. Zij kunnen hun tanden stukbijten op personages, verhaallijn en diepgang – en de daarmee gepaard gaande romandikte.

Naar: Pieter Beens, www.rd.nl
zie opdrachten 4, 5 en 6 op p. 179





3 Onderzoek welke kenmerken stripboeken en graphic novels gemeenschappelijk hebben en welke niet. Vul het venndiagram in met behulp van de tekst. strip graphic novel


De Booker Prize is een belangrijke literaire prijs in de Engelstalige wereld. Jaarlijks kiest een jury de beste roman van het jaar die geschreven en gepubliceerd is in het Verenigd Koninkrijk en Ierland. Naast het winnen van een bedrag van £ (ongeveer € ), verandert die prijs de carrière van de auteurs. Zo stijgt hun boekverkoop enorm en krijgen ze een wereldwijd lezerspubliek.
Bron: thebookerprizes.com
onderweg

4 Lees de zinnen uit de tekst en duid aan wat de betekenis van de onderstreepte woorden is door naar de context te kijken.
a Twee pagina’s met ogenschijnlijk eenvoudige lijntekeningen in basale kleuren. Geen tekstwolkje of begeleidend schrijven. Niets.
eenvoudige kleuren felle kleuren donkere kleuren
b De vuistdikke graphic novel werd vorig jaar bijna bekroond met de prestigieuze Man Bookers Prize.
zeer bekend respectabel ontroerend
c De verhaallijnen van de hedendaagse stripromans zijn dan ook te complex om ze snel even tussendoor te lezen.
kinderlijke gloednieuwe van deze tijd
5 Geef een synoniem voor de woorden die tussen haakjes staan. Kies uit: ellende – literatuur – onlangs – uitbrengen
a Bijna veertig jaar nadat de eerste graphic novel verscheen, lijkt het genre een vaste plaats te hebben verworven in de (literaire wereld).
b De graphic novel wordt daardoor dan ook nadrukkelijk (gepositioneerd) voor lezers die er de waarde van inzien – en het bijhorende bedrag er dus voor neer willen tellen.
c De thematiek – goede en foute keuzes die zijn ingegeven door de omstandigheden – is zeker niet oppervlakkig, maar nodigt de lezer uit om zich te bezinnen over de (tragiek) van het leven.
d De toenemende creatieve vrijheid van de graphic novelists droeg (in recente jaren) bij aan de toenemende waardering van de graphic novel.
6 Koppel de uitdrukkingen aan de juiste verklaring.
1 De eerste pagina’s van Sabrina oogsten verwarring en nodigen vooral uit om goed plaatjes te kijken.
2 De vuistdikke graphic novel werd vorig jaar bijna bekroond met de prestigieuze Man Bookers Prize en was daarmee niet het eerste boek in zijn soort dat hoge ogen gooide
12
7 Formuleer in je eigen woorden wat een graphic novel is.
a allerlei zaken door elkaar halen been goede kans maken op iets cervoor zorgen dat je niet goed kunt volgen d van de gelegenheid gebruikmaken
Op iDiddit staat een verdiepende opdracht waarbij je je mening formuleert bij het artikel Beeldverhaal ontgroeit zijn puberteit

1 Bekijk de cover van de graphic novel en bespreek de vragen.

a Spreekt de cover je aan? Waarom wel/niet?
b Waarover zal het verhaal volgens jou gaan? Geef minstens vier trefwoorden.
2 Lees hieronder de korte inhoud van het boek en beantwoord na elk fragment de bijhorende vraag.
Phaedra kijkt in de spiegel en wil iets anders zien dan wat ze ziet. Daarenboven is ze de vooroordelen van de mensen meer dan beu.
a Waarover zouden de vooroordelen gaan waarover ze het heeft?
Ze neemt een ingrijpende beslissing om tot een normaal leven te komen: een …
b Welke ingrijpende beslissing zou ze nemen?
… maagverkleining. Van de onzekere aanloop naar de operatie tot de reacties van haar vrienden nadien: in deze openhartige graphic novel vertelt Phaedra hoe haar gewicht haar relatie met eten heeft verziekt, en hoe ze tot het radicale besluit kwam om haar leven grondig een andere richting op te sturen ...
c Beantwoord de vragen opnieuw nu je de volledige beschrijving gelezen hebt.
3 Wat verwacht je van het verhaal? Duid de bijvoeglijke naamwoorden aan die volgens jou bij het verhaal zouden passen of vul zelf aan. Leg uit waarom je dat denkt.
dapper droevig egoïstisch eenzaam intiem onzeker spannend sensueel trots verward veilig vrolijk
4 Lees het fragment uit Doorsnee op iDiddit en beantwoord de vragen.
a Waarom moet Phaedra op consultatie bij een psychiater?
b Geef twee incidenten die ertoe hebben geleid dat Phaedra voor een maagverkleining koos.
c Hoe is Phaedra’s band met haar ouders?
5 Waarom staan er in het fragment golven afgebeeld?

In fictie gebruiken we vaak beeldspraak om iets onder woorden te brengen. We gebruiken woorden niet in hun letterlijke betekenis, maar proberen aan de hand van een beeld iets duidelijker of emotioneler weer te geven.
Aangezien graphic novels met beelden werken, maken auteurs daar regelmatig gebruik van. Ze kiezen er dan voor om dit in hun tekeningen op te nemen: beeldspraak wordt zo visueel weergegeven. Gevoelens kunnen een beeld krijgen, zoals de grote golf in Doorsnee van Phaedra Derhore.
Een voorwerp kan een beeld krijgen. Zo krijgt het beroemde dagboek van Anne Frank – dat in het oorspronkelijke boek ook al de naam ‘Kitty’ krijgt – in de graphic novel een echt beeld.

6 Bespreek klassikaal onderstaande vragen.
a Begrijp je waarom Phaedra voor een maagverkleining kiest?
b Hoe zouden jouw gezinsleden reageren op zulke gebeurtenissen?








DE ZOMER VAN HAAR LEVEN (2018)

Barbara Yelin en Thomas von Steinacker
Gerda, een oude dame, woont in een verzorgingstehuis en beseft dat haar leven ten einde loopt. Ze denkt na over haar leven en of ze wel de juiste keuzes heeft gemaakt. Ze blikt terug op haar jeugd in de jaren zestig, toen ze gepest werd. Maar ook naar de zomer waarin ze de keuze moest maken tussen de liefde van haar leven en een carrière in het buitenland.
NIMONA (2015)








Noelle Stevenson
Nimona is een jonge gedaantewisselaar die haar talent gebruikt om schurkenstreken uit te halen. Ze sluit zich aan bij slechterik Ballister Zwarthart, maar hun plannen lopen niet helemaal zoals gehoopt. Zo blijkt dat Nimona’s talenten gevaarlijker zijn dan voorzien en dat Zwarthart toch ook een goede kant heeft. In deze graphic novel wordt de dunne lijn tussen goed en kwaad behandeld.
VERZWELG ME! (2010)
Nate Powell
Rute en Perry zijn anders dan andere kinderen. Ze hebben deels een leventje zoals de anderen: op school, thuis en buiten, maar daarnaast horen en zien zij ook andere dingen. Dit komt omdat zij schizofrenie hebben, wat hun waarneming vertekent.
In het boek word je als lezer meegezogen in een wereld die niet alledaags is, maar onbekend, geheimzinnig en verleidelijk.
DANSEN DRINKEN BETALEN (2014)

Adriaan Van Aken en Philip Paquet
Een jong meisje loopt weg van huis naar de stad. Ze ontfutselt sleutels van een jongen die op reis is en gebruikt zijn flat als uitvalsbasis voor haar escapades in het nachtleven. Maar dan loopt het mis. De jongen komt weer thuis. Is hij wie zij denkt dat hij is?
In dit boek vind je ook een cd, je kunt het boek lezen terwijl je luistert naar de muziek.
MIKEL (2016)

Judith Vanistendael en Mark Bellido
Het verhaal speelt zich af in het Baskenland, Spanje, waar de dorpen geteisterd worden door de terreur van de ETA. Mikel is een snoepverkoper, maar dan wordt hij bodyguard om politici te beschermen. Eerst lijkt die job saai, maar dan komt het grote gevaar.
HEARTSTOPPER (2021)

Alice Oseman en Niels van Eekelen
Charlie heeft een moeilijk schooljaar achter de rug: zijn klasgenoten kwamen te weten dat hij homo is en hij werd gepest. Nu start hij in een nieuwe klas en hij is vastberaden om er het beste van te maken. Hij ontmoet Nick en ze worden vrienden. Charlie merkt dat hij meer voor Nick voelt dan alleen maar vriendschap. En Nick valt enkel op meisjes. Of toch niet?
SAPIENS (2020)
Yuval Noah Harari






Het beeldverhaal van de bekende novel Sapiens. Op een nieuwe manier wordt de geschiedenis van de mensheid verteld. Honderdduizend jaar geleden waren er wel zes verschillende menssoorten. Nu is er maar één soort over. Hoe komt dat?

Beeldverhaal
Een beeldverhaal is een mengvorm van afbeeldingen en tekst. Waar je bij een cartoon maar één afbeelding krijgt met tekst, volgen de afbeeldingen in een beeldverhaal elkaar op en vertellen ze zo een verhaal.
Populair zijn de strips rond bekende mediafiguren. Van de Amerikaanse comics zijn bij ons vooral de superheldenverhalen bekend. Ook manga’s kun je in België makkelijk terugvinden. Dat zijn Japanse strips, meestal in zwart-wit met veel actie, hevige emoties en erotiek.
Al die voorbeelden zijn vooral bedoeld als ontspanning. Er zijn ook beeldverhalen die langer zijn en een boodschap willen brengen. In graphic novels plaatst de maker een ernstig onderwerp centraal en zal hij experimenteren met de vorm om die boodschap naar de lezer te brengen.
Je herkent nieuwe vormen van reclame 1
Je bespreekt hoe er in jouw omgeving reclame wordt gemaakt 3 4
Je legt in je eigen woorden het effect van influencers op hun doelgroep uit
Je kunt de belangrijkste informatie uit een informatieve tekst selecteren
Reclame is een vorm van communicatie met als doel potentiële klanten te overhalen om producten of diensten aan te schaffen.
1 Neem je smartphone en open de drie apps die je het meest gebruikt.
a Hoelang duurt het voor je reclame ziet in die apps?
b Vul de tabel in. app 1 app 2 app 3
media
Wat is de naam van de app?
producent Wie maakt de reclame? product Waarvoor wordt er reclame gemaakt?
doelgroep
Voor wie is de reclame bedoeld?
2 Bespreek de tabel met een medeleerling en formuleer een conclusie.











1 Welke manieren van reclame maken ken je?
2 Met de komst van nieuwe media verschijnen er ook nieuwe reclamevormen.
a Verbind onderstaande termen met de juiste definitie.
b Plaats de afbeeldingen van p. 185 bij de juiste term. Let op, er zitten twee overbodige afbeeldingen tussen.
1 advergame
2 behavioral targeting
3 influencer marketing
4mobile advertising
5 native advertising
6 preroll ad
7 product placement
8 zoekmachinemarketing
ahet inzetten van influencers om via hun blogs, foto’s, posts ... hun merk/ product bekend te maken
b artikel dat dezelfde stijl en vorm heeft als een krantenartikel, maar wel reclame maakt voor een product. Het is te herkennen door de vermelding ‘sponsored’ of ‘advertorial’, ‘ad(vertorial)’, ‘aangeboden door’ ... cgratis online spelletje waarbij een merk of product voortdurend te zien is d wanneer een bedrijf betaalt om bovenaan in de zoekresultaten te komen e wanneer een merk, product of logo heel duidelijk in beeld komt in een televisieprogramma, film of game; op televisie zie je het ‘PP-logo’ verschijnen felke keer als je toestemming geeft voor ‘cookies’ wordt de reclame aangepast aan jouw voorkeuren en surfgedrag gfilmpje dat automatisch afspeelt voor je het filmpje van je keuze kunt bekijken. Soms kan het na enkele seconden worden weggeklikt. hreclameboodschap die je te zien krijgt bij het gebruiken van een gratis app. Enkel door een aankoop kun je de reclamevrije versie gebruiken.
3 Analyseer de reclametechnieken voor een merk.
a Kies je favoriete merk (mode, sport, technologie, auto’s, bromfietsen, muziek …).
b Zoek op hoe dat merk reclame maakt en gebruik de juiste termen.
c Bedenk nu zelf vier andere manieren om reclame te maken voor dat merk.
d Bespreek je reclametechnieken met de klas.
Kijken
Je bekijkt het nieuwsfragment Influencers beïnvloeden het koopgedrag van jongeren
1 Welke doelgroep onderzocht de Arteveldehogeschool?
2 Wat zijn in uencers? Geef een de nitie.
3 Zijn de volgende stellingen juist of fout? Verbeter indien fout.
a 85% van de jongeren volgt minstens één influencer op sociale media.
b Drie vierde van de jongeren geven aan dat ze de voorbije maanden iets gekocht hebben door toedoen van een influencer.
c Door corona is het sociale leven nog meer verschoven naar digitale kanalen.
d TikTok is nummer één op vlak van socialemediabereik.
Lezen
4* Aan welke voorwaarden moet iemand volgens jou voldoen om een succesvolle in uencer te worden?
5 Hieronder lees je vijf tips die in het artikel Hoe word je een succesvolle social media in uencer? op p. 188-189 worden gegeven.
a Bespreek wat de tips volgens jou betekenen.
Hoe word je een succesvolle influencer?
Creëer een persona.
Wees actief.
Werk aan je contentstrategie.
Vind je niche. Volg de regels.
b Lees het artikel en zet de vijf tips nu als tussentitels in het artikel.
* Het antwoord op deze vraag hoef je niet te noteren.
Ooit – nog niet zo lang geleden – moest je een notoire beroemdheid zijn om geld te verdienen met je naam. Vandaag de dag is dat een stuk makkelijker geworden, door social media. Een influencer worden op social media is een perfecte manier om andere mensen te bereiken, te inspireren en te informeren.


In de afgelopen jaren hebben innovatieve influencers hun platform gebruikt om duizenden volgers te bereiken. Het schrijven van blogposts en het maken van vermakelijke video- of fotocontent is voor deze influencers de manier om hun volgers aan zich te binden en nieuwe volgers te bereiken. De makers profiteren van de transparantie van het internet; iedereen kan een influencer worden!
Wanneer je hebt besloten dat je een influencer wilt worden, moet je erkennen dat een online présence bouwen heel veel tijd kost. Je moet een strategie verzinnen die verklaart wat je post, wanneer je het post, waarom je het post en waar. Jouw volgers moeten met regelmaat relevante content van jou te zien krijgen. De kwaliteit van je content is immers de sleutel naar het ontwikkelen van een band met je volgers.
Zorg dat je vaak genoeg post zodat je volgers je niet vergeten, maar val ze ook niet lastig! Op Instagram bijvoorbeeld zien we dat de top 55 van merken gemiddeld 1,5 keer per dag iets post. Kwalitatieve content maken kost een hoop tijd, maar helpt je wel om een merk te worden waarmee volgers zich kunnen identificeren. >




notoir: algemeen bekend innovatief: vernieuwend de transparantie: helder van opzet, makkelijk te doorzien erkennen: toegeven relevant: van belang, met betekenis

Het belangrijkste is dat je content maakt vanuit een passie. Het enige wat écht onderscheidend is, is iets dat persoonlijk en authentiek is. Een niche zoeken is dus belangrijk: anders ben je ‘maar’ een food- of fashion-blogger. Kijk liever alleen naar kleding van organisch katoen of alleen naar Italiaanse wijnen!
Positioneer jezelf als expert, autoriteit of icoon binnen een bepaalde industrie en word méér dan iemand met een populaire Instagram-pagina. Word een échte influencer. Op Instagram zijn er influencers die gespecialiseerd zijn in bijna alles. Of het nu fashion, travel, fitness of comedy is, je moet je onderscheiden van de rest. Dat is de enige manier om op te vallen en jouw eigen merk te creëren.
Hoewel het belangrijk is om je passie te delen op een authentieke manier, is het ook slim om een ‘persona’ te maken. Creëer een karakter dat bij mensen blijft hangen – je verkoopt immers jezelf meer dan een idee of een product. De grondslag van marketing is dat je een identiteit moet creëren die overeenkomt met je doelgroep.
Als je maximaal resultaat wilt als influencer is het belangrijk dat je altijd met je volgers blijft communiceren. Ga op zoek naar andere mensen met kennis binnen je niche, antwoord op comments, deel je content ook op andere kanalen en ga zelf op zoek naar merken die bij jou passen.
Door een netwerk te creëren dat verder gaat dan alleen je posts word je een waardevol lid van je community. Op deze manier met anderen omgaan zorgt ervoor dat jij snel nieuwe fans hebt die jouw content weer kunnen delen. Juist die shares van andere invloedrijke leden van de community zijn heel waardevol.


Er zijn uiteraard ook enkele regels voor vloggers en influencers. Zo moet reclame altijd vermeld worden. Dat kan door een bekende hashtag zoals #spon of #ad, maar een tekst zoals ‘gekregen van bedrijf X’ of ‘deze video is in samenwerking gemaakt met bedrijf X’ mag ook.
Voor kinderen is er een speciale regeling: reclame mag niet gericht zijn op kinderen onder de twaalf jaar. Zij zijn immers heel snel beïnvloedbaar en zouden volgens de overheid hiertegen beschermd moeten worden.
Naar: join.marketing


authentiek: betrouwbaar, geloofwaardig, echt de niche: specifiek deel van een groep, een doelgroep

6 Ga nu zelf aan de slag. Er zijn twee mogelijkheden.
A Zoek een influencer die voldoet aan alle regels. Als je inspiratie nodig hebt, zoek je eerst op wie belangrijke influencers zijn.
B Vraag een kaartje aan je leerkracht en creëer zelf een personage dat voldoet aan alle eisen.
tip influencer
Wat is je naam als influencer?
Werk aan je contentstrategie.
• Is de content relevant?
• Hoe frequent wordt er iets gepost?
Vind je niche.
• Welke specialisatie heb je?
Creëer een persona.
• Welk(e) karakter/identiteit heb je?
Wees actief.
• Op welke manier communiceert de influencer met volgers?
• Worden er andere kanalen gebruikt?
Volg de regels.
• Wordt het steeds vermeld als er reclame wordt gemaakt?
Je maakt nu zelf drie fictieve Instagramposts als (fictieve) influencer. De post bestaat telkens uit een foto en een aantrekkelijke beschrijving waarin je meer uitleg geeft over de foto. Je eindigt met een duidelijke boodschap.
• Bereid je voor door de tips in te vullen.
Wat is je naam als influencer?

Werk aan je contentstrategie.
• Is de content relevant?
• Hoe frequent wordt er iets gepost?




Vind je niche.
• Welke specialisatie heb je?
Creëer een persona.
• Welk(e) karakter/identiteit heb je?
Wees actief.


• Op welke manier communiceert de influencer met volgers?
• Worden er andere kanalen gebruikt?
Volg de regels.
• Wordt het steeds vermeld als er reclame wordt gemaakt?
• Deel de posts met je leerkracht.
A Je kunt in een apart document afbeeldingen toevoegen en het bijschrift typen.
B Je kunt screenshots nemen van je eigen Instagrampagina als je de posts echt geplaatst hebt.
Wie zelf niet graag in beeld komt, kan meer verhalend werken en een Instagrampost op Canva maken.
Je maakte drie waardevolle posts.
Je posts - hebben een duidelijke context,
- passen binnen de persona (karakter) en de niche die je hebt voorbereid, - volgen de wetgeving.
Je taalgebruik is zo goed als foutloos: je spelling is correct en alle zinnen zijn helder en juist opgebouwd.
Aanvullende commentaar:
Je maakte drie posts. Je maakte slechts twee of minder posts.
Je posts beantwoorden aan twee van de drie vooropgestelde criteria.
Je posts beantwoorden niet of slechts aan één van de drie vooropgestelde criteria.
Je maakt enkele fouten tegen spelling of zinsbouw. Je tekst bevat opvallende spellingfouten, te veel herhaling en/of foute zinnen. Daardoor is het moeilijk om je tekst te begrijpen.
Taal: persoonlijk en bezittelijk voornaamwoord
1 Verbeter de volgende zinnen en verklaar je antwoord.
a Kun je jou taak nogmaals doorsturen? Ik vrees dat ze niet in mijn mailbox zit.
verklaring:
b Ten slotte wil ik graag me familie bedanken, ze liggen me nauw aan het hart.
verklaring:
Persoonlijk voornaamwoord en bezittelijk voornaamwoord
Het persoonlijk voornaamwoord verwijst naar een zelfstandig naamwoord (personen, dieren, zaken).
Wij zien hem en jou graag.
Jullie willen het niet begrijpen.
Geef ze ons!
onderwerp niet als onderwerp
hen/ze/hun
Bezittelijke voornaamwoorden zeggen aan wie iets of iemand toebehoort. Mijn ouders verkochten hun auto aan onze buurvrouw.
Een bezittelijk voornaamwoord kun je zelfstandig of bijvoeglijk gebruiken.
persoon bijvoeglijk gebruiktzelfstandig gebruikt
1e mijn de/het mijne
2e jouw de/het jouwe
enkelvoud
2e beleefd uw de/het uwe
3e zijn/haar het zijne/het hare
1e onze/ons de/het onze
2e jullie/je die van jullie
meervoud
2e beleefd uw de/het uwe
3e hun de/het hunne
2 Verbeter de fouten in de volgende zinnen.
a Mag ik ook naar u feestje komen, of mag dat niet van hen?
b De zusjes waren heel blij met hen cadeau dat ze van de tante en nonkel van hun beste vriend hadden gekregen.
c Het is een grote fout die uw dochters gemaakt hebben en hun vinden het niet eens erg.
d Zij gaat mee met ik naar het park.
Die computer is van jou. → Het is jouw computer. (= bezittelijk voornaamwoord) U hebt een computer. → Het is uw computer. (= bezittelijk voornaamwoord)
Op iDiddit vind je aanvullende oefeningen op het bijvoeglijk en zelfstandig gebruik van bezittelijke voornaamwoorden.
Taal: contaminaties









3 Verbeter de volgende zinnen.
a Wil je me vanavond rond 20u optelefoneren om de resultaten van je bloedonderzoek te bespreken?
verklaring:
b Wil je me de nieuwe presentatie van de leerkracht laten tonen?
verklaring:

Bij contaminatie haal je twee begrippen of uitdrukkingen door elkaar. Ze besmetten (= ‘contaminer’) elkaar en vormen zo een stijlfout.
Dat kost duur.
Je maakt die foute constructie van de twee correcte constructies dat kost veel en dat is duur
4 Verbeter de fout(en) in de volgende zinnen.
a Je mag het tegen niemand vertellen, maar ik ben stiekem verliefd op de blonde jongen van mijn klas.
b Ik moest twee volle zakken van wel 20 kilogram mee naar huis dragen: dat woog erg zwaar, mijn armen begonnen erg veel pijn te doen.
c Ik heb aan Mo gevraagd om mijn taak af te printen.
d Deze kleine schroef maakt onderdeel uit van een grotere kast.
e Je weet wat ze altijd zeggen: de beste reclame is mond-op-mondreclame.
Op iDiddit vind je aanvullende oefeningen op contaminaties.
Taal: sterke en zwakke werkwoorden
5 Verbeter de volgende zin. Mijn vriend bedriegde me terwijl ik erbij stond, hij fluitte zonder schroom naar een zonnebadend meisje.
verklaring:

Sterke en zwakke werkwoorden

Bij zwakke werkwoorden hebben de verleden tijd en het voltooid deelwoord dezelfde klank als bij de infinitief en de tegenwoordige tijd.
spelen: Ik speel – ik speelde – gespeeld
antwoorden: zij antwoordt – zij antwoordde – geantwoord hopen: wij hopen – wij hoopten – gehoopt
Bij sterke werkwoorden vinden we in de verleden tijd een andere klank terug dan in de infinitief en de tegenwoordige tijd.
vergeten: ik vergeet – ik vergat – vergeten nemen: hij neemt – hij nam – genomen
Let op: sommige werkwoorden hebben beide vormen. Je kwam waarschijnlijk zowel zegde als zei al tegen als verleden tijd van zeggen. Ook klaagde en kloeg worden allebei gebruikt, net als wilde en wou
6 Verbeter de fouten in de volgende zinnen.
a Hij loopte een hele marathon dankzij de steun van zijn vriendin, die hem aanmoedigde en hem succes toeriep.
b De steen was zo zwaar dat hij die niet kreeg opgehoffen.
c Het gevecht liep erg uit de hand: de vechtersbaas slaagde zelfs per ongeluk op een toevallige voorbijganger.
d Ik werd erg boos toen hij de poster van de muur trekte.
e Na zijn winst stak hij zijn armen in de lucht en joeg om zijn ploeg die gewonnen had.
Op iDiddit vind je aanvullende oefeningen op zwakke en sterke werkwoorden.
Woordenschat: gevoelens uitdrukken
7 Welke emotie past bij welke uitspraak?
a Plaats onderstaande woorden bij de bijhorende uitspraak. Kies uit: timide – argwanend – sceptisch – rancuneus – melancholisch – perplex – euforisch –dankbaar
b Geef voor iedere emotie een synoniem. Kies uit: verbouwereerd – verlegen – achterdochtig – wraakzuchtig – zielsgelukkig – terughoudend – droefgeestig – erkentelijk
1 ‘Ik zie het allemaal niet meer zitten. Wat heeft het nog voor zin? Ik heb er geen energie meer voor.’
emotie: synoniem:
2 ‘Volgens mij schuilt er nog een addertje onder het gras. Er klopt iets niet en ik ga uitzoeken wat het is!’
emotie: synoniem:
3 ‘Het is de mooiste dag van mijn leven!’
emotie: synoniem:
4 ‘Dat hij maar niet denkt dat ik dit zo zal laten! Hij zal voelen wat hij heeft aangericht! Oog om oog, tand om tand.’
emotie: synoniem:
5 ‘Wel heb je ooit, dit kan ik écht niet geloven! Zoiets heb ik nog nooit gezien.’
emotie: synoniem:
6 ‘Zonder jou was ik nooit zo ver geraakt. Je steun betekent zo veel voor mij!’
emotie: synoniem:
7 ‘Ik weet het niet. Kies jij maar …’
emotie: synoniem:
8 ‘Ik ben nog niet overtuigd van dit voorstel. Is er lang genoeg over nagedacht? Ik wacht liever nog wat af.’
emotie: synoniem:
8 Vervolledig het kruiswoordraadsel.
horizontaal
5 afgunst
6 ergernis
8 een toestand van buiten zichzelf zijn door verrukking
verticaal
1 empathie

2 intens verlangen naar vroeger
3 geestdrift
4 afkeer, afschuw
7 onverschilligheid
9 Welke uitdrukkingen die te maken hebben met ‘gevoelens’ herken je hieronder? Schrijf er ook steeds bij wat de uitdrukking betekent.


uitdrukking:
betekenis:
uitdrukking:
betekenis:
uitdrukking:
betekenis:
uitdrukking:
betekenis:
uitdrukking:
betekenis:
uitdrukking:
betekenis:




uitdrukking:
betekenis:

10 Vul de werkwoorden in op de juiste plaats.
uitdrukking: betekenis:
Kies uit: beseffen – ervaren – lijden – ondervinden – identificeren – genieten – teleurstellen –waarderen – ontroeren – walgen
a Zij heeft die dag helemaal anders dan jij, als ik de verhalen zo vergelijk.
b Een personage is goed uitgewerkt wanneer je je als lezer in zijn/haar gevoelens kunt inleven. Je moet je kunnen
c Ik heb tranen met tuiten gehuild bij die film, ik was enorm .
d Ik het ten zeerste dat je je komt excuseren, dat getuigt van volwassenheid.
e De studente te laat dat ze de achterkant van haar toets niet had gemaakt.
f De genodigde al gauw dat hij de enige was die de verkeerde dresscode had gekregen.
g Wanneer gaat hij zich nu eindelijk eens douchen? Ik van hem!

h De jongeman had het aan zijn vriendinnetje beloofd en is zijn belofte niet nagekomen. Hij heeft haar uiteraard
i Wanneer de zon schijnt en ik alleen in mijn tuintje lig met een boek en een cocktail in de hand, dan ik.
j De oude man voelt zich niet gelukkig. Iedere dag opnieuw ervaart hij als een marteling, hij
11 Er zijn zes basisemoties die je op de foto’s ziet. Bijna alle andere emoties zijn daaronder thuis te brengen.


a Plaats de woorden hieronder in de juiste categorie.
b Bedenk zelf nog één woord voor iedere categorie.
furieus – opgetogen – onthutst – depressief – nerveus – gedegouteerd – monter – driftig – enthousiast – jolig – benauwd – levendig – miserabel – walgen – troosteloos – tevreden – geïrriteerd – gefascineerd – ontsteld – verbluft – neerslachtig –snibbig – verwonderd – somber – nors – schuchter – radeloos – hysterisch – zwaarmoedig – huiverig – chagrijnig




12 Je gevoelens in woorden uitdrukken is niet voor iedereen evident, zeker niet wanneer de juiste termen ervoor niet bestaan. Wist je dat er woorden in andere talen zijn die een emotie omschrijven waarvoor we in het Nederlands geen vertaling hebben?
a Kun jij raden wat de onderstaande woorden betekenen? Doe beroep op de talen die je kent.
b Welk woord vind je het mooiste? Waarom?
c Ken je nog zo’n anderstalig woord? Welk?
d Voor welk gevoel zou je zelf graag een woord creëren? Bedenk samen met een medeleerling zo’n woord.
1 Fernweh (Duits)
2 saudade (Portugees)
3 ya’aburnee (Arabisch)
4 Waldeinsamkeit (Duits)
5 forelsket (Noors)
6 dépaysement (Frans)
7 duende (Spaans)
8 hygge (Deens)
9 tosca (Russisch)
ahet onverklaarbare gevoel van een grote spirituele angst
bhet verlangen om op reis, naar het buitenland te gaan
c de aanwezigheid van afwezigheid; het verlangen naar iets of iemand waar we goede herinneringen aan hebben, maar waarvan we ook weten dat het waarschijnlijk tot het verleden zal blijven behoren
dhet gevoel dat je je niet thuis voelt in je thuisland: je een vreemde voelen in je eigen land
ehet gevoel van eenzaamheid en verbinding met de natuur als we alleen zijn in het bos
fde euforie wanneer je net verliefd bent op iemand
ghet gevoel dat je wilt sterven voor je geliefde, omdat je niet kunt leven zonder hem/haar
heen gevoel van gezelligheid en sfeer
ihet ontroerende gevoel wanneer kunst je echt raakt
123456789
Woordenschat: reclame
13 Lees de zinnen en verbind ze met de betekenis van het onderstreepte woord.
1 Je moet een notoire beroemdheid zijn om een merk te maken van je naam.
2 Innovatieve influencers hebben hun platform gebruikt om duizenden volgers te bereiken.
3 Contentcreators profiteren van de transparantie van het internet: iedereen kan influencer worden.
4 Je moet erkennen dat een online présence bouwen heel veel tijd kost.
5 Jouw volgers moeten met regelmaat relevante content van jou te zien krijgen.
6 Het enige wat écht onderscheidend is, is iets dat persoonlijk en authentiek is.
7 Een niche zoeken is dus heel belangrijk.
a betrouwbaar, geloofwaardig, echt
b een specifiek deel van een groep, een doelgroep
c vernieuwend
d toegeven
e algemeen bekend
f van belang, met betekenis
g helder van opzet, makkelijk te doorzien
14 Vul het juiste woord aan in de zin. Gebruik de woorden uit de vorige oefening.
a Vroeger was gamen een , maar nu valt er geen vaste doelgroep meer aan vast te hangen: jong of oud, mannen en vrouwen.
b De jongeren gingen betogen voor het klimaat: ze wisten dat het maatschappelijk was voor de samenleving.
c Die YouTuber is voor zijn riskante trucs met zijn skateboard.
d Op TikTok gaan vaak recepten viraal, zoals de feta-pasta en de airfryermaïs.
15 Formuleer drie zinnen met elk woord uit de linkse kolom. Daag jezelf uit door in elke zin minstens één woord uit de rechterkolom toe te voegen.
transparantie erkennen authentiek
doelgroep posts persona content blogger
LUISTEREN: BEN JE SOMS ZO LUI OMDAT JE TE SLIM BENT?
Je kijkt straks naar de lezing Ben je soms zo lui omdat je te slim bent? van professor doctor Tessa Kieboom en neemt notities tijdens het kijken. Nadien stelt je leerkracht enkele vragen over de inhoud ervan en over jouw ervaring met het luisteren en noteren.
Je beantwoordt eerst klassikaal een aantal vragen.

1 Onderstaande woorden en uitdrukkingen komen aan bod in de lezing. Vul de zinnen correct aan. Kies uit: cognitief – het antwoord schuldig blijven – iemand achter de veren zitten – het hek is van de dam – selffulfilling prophecy – doemscenario – potentieel.
a Bij het verwerken van informatie heb je je geheugen nodig, maar ook taal, oriëntatie, aandacht en het vermogen om problemen op te lossen, concepten te vormen en dingen voor je te zien. Daarnaast zijn redeneren, rekenen, lezen en schrijven, plannen maken en initiatieven nemen functies. Je gebruikt je vaardigheden dus voortdurend.
b Het spijt mij. Ik weet het gewoon niet. Ik moet u
c Als je wilt dat die karwei in huis nog voor de zomer afgewerkt is, dan moet je de aannemer . Anders zul je nog lang kunnen wachten.
d Toen de scheidsrechter die zware tackle niet bestrafte met een rode kaart, was . De spelers haalden elkaar voortdurend zwaar onderuit.
e Je kent het moment wel dat je wakker wordt uit een vervelende droom en denkt: ‘Ik heb het gevoel dat dit een slechte dag zal worden’. Aan het eind van de dag blijkt je voorspelling uitgekomen doordat je onderbewustzijn zijn acties eraan zal aanpassen. Je lette vooral op de dingen die misliepen en zag niet meer dat er ook fijne momenten waren. We noemen dit – in het Engels –
f In rampenfilms gaan de scenaristen vaak uit van een of de slechtst denkbare loop van de gebeurtenissen tot net voor het einde, want een happy end verkoopt beter. g Er zit veel in die jongeren, maar ze moeten het leren gebruiken.
In dit deel oefen je bewust je manier van noteren. Dit is een belangrijke vaardigheid die je nog vaak nodig zult hebben. Het fragment wordt geregeld gestopt om je de kans te geven je luisteren en noteren bij te sturen via tips van medeleerlingen en/of de leerkracht.
Op basis van je notities zul je nadien een aantal vragen moeten beantwoorden. Na de test krijg je de kans om jouw notities te vergelijken met de notities van een expert.
Hoe beluister/bekijk je een lezing van een expert?
In het leerwerkboek staan enkele oefeningen waar je leert luisteren en kijken naar een expert. Je oefent daar het (snel) nemen van notities. Een vaardigheid die in het hoger onderwijs heel belangrijk is. Je krijgt hier een aantal tips.
Wat is een goede voorbereiding?
• Zorg dat je kunt noteren. Heb je een blad papier en een pen nodig of noteer je meteen op je laptop of tablet?
• Noteer de titel, de naam én de functie van de spreker.
Waarom noteer je …
… de titel? Op een test of examen gebruikt men soms alleen die voor de vraag.
… de naam van de spreker? Soms heb je verschillende sprekers over hetzelfde onderwerp.
… de functie? Dit bewijst de betrouwbaarheid (of onbetrouwbaarheid) van de spreker!
… de bron? Dit kan belangrijk zijn als je ernaar moet verwijzen in je bibliografie.
… die gegevens correct? Mensen appreciëren het dat je correct verwijst naar hun naam en functie.
• Denk al eens na over de titel en het onderwerp. Wat is je voorkennis? Welke informatie verwacht je? Ken je de spreker? Ken je een aantal woorden die te maken hebben met het onderwerp? Moest je vooraf iets lezen?
• Bekijk hoelang de lezing / de opname / de podcast duurt. Dat helpt om je te concentreren. Je weet zo beter wat je kunt verwachten.
• Weet je welke opdracht je achteraf krijgt? Wordt het een klassieke test of krijg je nog een verwerkingsopdracht? Moet je veel details kennen of enkel de grote lijnen?
Hoe neem je notities tijdens een lezing?
Soms kun je een lezing herbeluisteren en dus stilzetten en terugspoelen. Bij een lezing of een college aan een hogeschool of een universiteit kan dat niet altijd. De tips die we geven, gaan ervan uit dat je niet kunt herbeluisteren.
Iedereen ontwikkelt uiteindelijk een eigen noteerstijl. Toch geven we enkele belangrijke tips.
• Noteer zo snel mogelijk. Laat witruimte wanneer je iets niet kunt/kon noteren. Vul nadien je notities aan.
• Werk schematisch.
inleiding (I) – midden (M) – slot (S)
Gebruik insprongen zodat je ziet dat iets onderdeel is van een idee, alinea.
• Gebruik kernwoorden en eigen en officiële afkortingen.
A (aantal), ↔ (tegenstelling), → (gevolg), vb. (voorbeeld), CONCL (conclusie)
• Maak een onderscheid tussen voorbeelden en theorie.
De Cornell-methode
Dit systeem is een belangrijke manier om te noteren. Je gebruikt de linkerkolom om de inhoud met kernwoorden samen te vatten. In de rechterkolom noteer je ideeën en voorbeelden uitgebreider.
Waarom moeten we nog leren als Google alles weet? Daarop geeft
Tim Surma een antwoord. Bij het beeldfragment vind je hierna een voorbeeld van notities nemen volgens de Cornell-methode.
titel Waarom nog leren als Google alles weet? kernwoord (deelonderwerp) informatie
kennis ≠ informatie kennis = verwerkte informatie die in je hoofd zit Wat je weet (kennis) bepaalt wat je ziet (informatie).
bv. niet-schaker kijkt anders naar schaakbord dan schaker
2 geheugens – werkgeheugen (= om na te denken): ruimte is beperkt, dus makkelijk overbelast
– langetermijngeheugen (= stockage voor alles wat je weet en kunt): komt het werkgeheugen te hulp
klaspraktijk basiskennis = belangrijk want je bouwt erop voort
bv. maaltafels nog nodig in middelbaar
bv. grote woordenschatkennis beter tekstbegrip samenvatting
Kennis zorgt ervoor dat je makkelijker en sneller nieuwe informatie leert. Daarom is blijven leren belangrijk (ook in tijden van Google).
Wat doe je onmiddellijk na het luisteren?
• Structureer je notities en vul ze aan.
• Gebruik nu ook vet of onderstrepingen om zaken in het oog te laten springen.
• Herschrijf meteen die stukken of zinsdelen die na enkele dagen, weken moeilijk leesbaar zouden zijn en dus niet bruikbaar om een test of examen voor te bereiden.
• Zoek bij twijfel de correcte spelling en eventueel de verklaring van moeilijke kernbegrippen op.
Je kunt veel leren over jouw manier van noteren door je notities te vergelijken met die van anderen. Soms loont het zeker de moeite om ze te vergelijken met die van een expert.
2 Antwoord op de volgende vragen. Soms zijn verschillende antwoorden mogelijk, maar kies telkens het antwoord dat het beste weergeeft wat de spreekster zei en bedoelde. De verschillen tussen de gesuggereerde antwoorden zijn soms klein. Je moet dus ook de nuances leren zien.
a Hoeveel hoogbegaafden zijn er?
55 000 volwassenen in België
55 000 in Vlaanderen, Brussel en Wallonië samen
minimaal 1 kind per klas in Vlaanderen
maximaal 1 kind per klas in België
b Bij wie veroorzaakt hoogbegaafdheid problemen?
alleen kinderen
alleen kinderen en tieners
alle leeftijdsgroepen
jongeren in Vlaanderen
c De spreekster mag zich een experte noemen, want …
ze is professor aan een universiteit.
ze is al 22 jaar bezig in Vlaanderen.
ze is al 22 jaar bezig in Vlaanderen en Nederland.
ze heeft al meer dan 10 000 hoogbegaafden met problemen begeleid.
d Hoogbegaafden krijgen normaal pas problemen …
vanaf de derde graad van het lager onderwijs.
na de eerste graad van het middelbaar onderwijs.
in de loop van het middelbaar onderwijs.
in het hoger onderwijs.
e Het zwaard van Damocles hangt boven het hoofd van …
de ouders, want zij vragen zich voortdurend af of ze genoeg doen.
de hoogbegaafden, want die beseffen al heel lang dat ze te weinig doen.
de scholen, want die moeten uiteindelijk toegeven dat ze de hoogbegaafden niet kunnen helpen.
de ouders en de hoogbegaafden, want beide groepen grijpen te laat in.
f Waarom heeft de spreekster het over Jef en Stan?
Ze wil duidelijk maken dat je als ouder beter een sportief kind hebt dan een hoogbegaafd kind.
Ze wil duidelijk maken dat ouders hun hoogbegaafd kind moeten aanmoedigen om te sporten.
Ze wil duidelijk maken dat je als ouder de aanpak van een sportief kind moet aanpassen aan dat van een hoogbegaafd kind.
Ze wil duidelijk maken dat je als ouder de aanpak van een hoogbegaafd kind moet aanpassen aan dat van een sportief kind.
g Heb je een hoogbegaafd kind, dan kun je als ouder best …
achter de vodden van je kind zitten.
hem/haar zo snel mogelijk doorverwijzen naar het expertisecentrum.
vertrouwen hebben in zijn/haar potentieel.
hem/haar niet laten afhaken.
h Wat zijn de tips die de spreekster aan ouders meegeeft?
Hoogbegaafde kinderen moeten leren doorgaan, ook als het niet onmiddellijk lukt.
Hoogbegaafde kinderen moeten leren tennissen, dan komt alles in orde.
Hoogbegaafde kinderen zijn lui, dus je moet ze voortdurend aanporren.
Hoogbegaafde kinderen moeten leren falen, dus geef ze opdrachten boven hun niveau.
i Labelen doe je volgens de spreekster best …

niet, want er zijn te weinig onderzoeken en die spreken elkaar ook nog tegen.
wel, want dan kunnen ouders correct inspelen op de noden van hun kind.
alleen met hoogbegaafde kinderen.
met alle kinderen.
j Voor wie is haar lezing vooral bedoeld?
Voor de jongeren, ze zitten in de zaal.
Voor de jongeren en de ouders, ze zitten in de zaal.
Voor de ouders van hoogbegaafde kinderen, zij krijgen de meeste tips.
Voor iedereen die iets wil weten over hoogbegaafdheid.
k De afsluitende opmerking van de inleider ...
is stom, want het sluit helemaal niet aan bij de inhoud van de podcast.
is grappig, want het speelt in op de inhoud van de podcast.
is misplaatst, want het versterkt het beeld van de hoogbegaafde als luierik.
maakt duidelijk dat hij een hoogbegaafde volwassene is.
3 Bespreek klassikaal volgende vragen.
• ‘No sweat, no glory’ is de slogan van Club Brugge, maar pushen sporttrainers, leerkrachten en bedrijven jongeren niet te veel?




• Je potentieel ten volle benutten doe je niet alleen door voluit te focussen op het cognitieve, maar ook door tijd te maken voor ontspanning en creativiteit. Moeten volwassenen meer rekening houden met die drie tips?
UITDAGING: EEN GRAPHIC NOVEL LEZEN EN BESPREKEN
Oriënteren
Optie 1

Je schrijft een tekst van minstens 200 woorden waarin je een graphic novel bespreekt. Je gaat daarin na of die aan de kenmerken van een graphic novel voldoet. Nadien bespreek je jouw graphic novel met een medeleerling die een andere graphic novel las.
Optie 2
Je geeft voor de klas een korte bespreking waarin je een analyse geeft van een graphic novel. Je bespreekt of die wel of niet aan de geziene kenmerken van een graphic novel voldoet.
1 Lees de korte inhoud van de vier graphic novels en kies uit welke graphic novel jij een fragment wilt lezen.

Floor zit in haar laatste schooljaar en komt overal hopeloos te laat. Ze komt de lessen door met haar tegendraadse vrienden Arlo en Sil. Op een rommelige herfstochtend wordt de wereld van Floor volledig omgegooid.
Arlo is een krachtige beeldroman over verlies. Met haar ongecompliceerde tekenstijl en taal creëert Floor Denil een autobiografisch debuut dat onder de huid kruipt.

€ 22,00 – 220 p.









Bron: www.standaardboekhandel.be
Liefde en hartstocht, daarover gaat het in het tweeluik van de Vlaamse tekenaar Judith Vanistendael. In het eerste deel, Papa en Sofie, observeert een vader de liefde tussen zijn dochter Sofie, economiestudente, en Abou, politiek vluchteling uit Togo. Aanvankelijk ziet de vader de relatie van zijn dochter niet zitten, maar zijn afkeer verdwijnt gaandeweg. Uiteindelijk vertrouwen vader en moeder op het koppige kompas van hun dochter, en heel langzaam, haast onmerkbaar, gaan ze Abou zelfs waarderen. In deel twee, Leentje en Sofie, blikt de inmiddels wat oudere Sofie terug op haar relatie met Abou. Ze komt hem tegen op straat en haar dochtertje vraagt haar wie die meneer is. Dan kan Sofie eindelijk haar kant van het verhaal vertellen. Leentje en Sofie gaat diep in op vragen die in het eerste deel nog onbeantwoord bleven.
€ 19,90 – 296 p.
Bron: www.standaardboekhandel.be

© Uitgeverij Oogachtendauteur: Maarten vande Wiele
Drie vriendinnen willen het in de Parijse glamourwereld maken. Hope heeft een geschonden gezicht, maar droomt er toch van topmodel te worden. Faith aast op een carrière als zangeres en deinst er niet voor terug vuile spelletjes te spelen als die haar maar verder kunnen helpen. Chastity wil rijk en beroemd worden, het maakt niet uit hoe, en zet haar mooie lichaam in om te krijgen wat ze wil. Alledrie betalen ze de tol van de roem.
‘Paris van Maarten Vande Wiele is een must voor elke die-hard fashionista, graphic novelista, én de rest van de bevolking.’ –Walter Van Beirendonck & Dirk Van Saene

€ 19,90 – 200 p.
Bron: Uitgeverij Oogachtend - auteur: Maarten vande Wiele
Persepolis is het meermaals bekroonde levensverhaal van Marjane Satrapi, die opgroeit na de Islamitische Revolutie in Iran, naar het westen uitwijkt om te studeren en vervolgens terugkeert naar haar vaderland. De geschiedenis van haar land wordt aan de hand van haar eigen verleden met zowel humor als ernst verteld. Dit stripverhaal werd tussen 2000 en 2003 in vier delen gepubliceerd in Frankrijk en was meteen een groot succes. In Nederland is het een van de bestverkochte graphic novels aller tijden. In deze editie zijn alle delen bijeengebracht.

€ 20,00 – 352 p.

Bron: www.standaardboekhandel.be
kenmerk toepassing meer literair
complexere verhaallijnen
prijs
afbeeldingen verschillen van grootte meer dan vijftig pagina’s

3 Naargelang je gekozen uitwerking schrijf je de tekst nu uit of geef je je mondelinge bespreking.
inleiding Stel het boek kort voor. midden Som op wat er typisch is aan het boek. slot Trek een conclusie. Waarom is het boek duidelijk (g)een graphic novel?
Evaluatiematrix – Schrijven: een graphic novel
- Je schrijft een tekst van 200 woorden waarin je de kenmerken bespreekt.
- Je hebt alle kenmerken van een graphic novel aangehaald.
- Alle kenmerken werden gelinkt aan het fragment dat je gelezen hebt.
correctheid
Je taalgebruik is zo goed als foutloos: je spelling is correct en alle zinnen zijn helder en juist opgebouwd.
aantrekkelijkheid
- Je tekst is aangenaam om te lezen.
- Je tekst is opgedeeld in alinea’s.
- Je tekst bevat een inleiding, een midden en een slot.
Aanvullende commentaar:
- Je schrijft een tekst van 200 woorden waarin je de kenmerken bespreekt.
- Je hebt niet alle kenmerken van een graphic novel aangehaald.
- Niet alle kenmerken worden gelinkt aan het fragment dat je gelezen hebt.
Je maakt enkele fouten tegen spelling of zinsbouw.
- Je schrijft een tekst van minder dan 200 woorden.
- Je bespreekt minder dan de helft van de kenmerken.
- Je linkt minder dan de helft van de kenmerken aan het fragment dat je gelezen hebt.
Je tekst bevat twee van de drie gevraagde elementen.
Je tekst bevat opvallende spellingfouten, te veel herhaling en/of foute zinnen. Daardoor is het moeilijk om je tekst te begrijpen.
Je tekst bevat slechts één of geen van de gevraagde elementen.
volledigheid
- Je hebt alle kenmerken van een graphic novel aangehaald.
- Alle kenmerken werden gelinkt aan het fragment dat je gelezen hebt.
- Je hebt niet alle kenmerken van een graphic novel aangehaald.
- Niet alle kenmerken worden gelinkt aan het fragment dat je gelezen hebt.
aantrekkelijkheid en correctheid
- Je praat vlot.
- Je gebruikt standaardtaal.
- Je bespreking bevat een inleiding, een midden en een slot.
Aanvullende commentaar:
Je bespreking bevat twee van de drie gevraagde elementen.
- Je bespreekt minder dan de helft van de kenmerken.
- Je linkt minder dan de helft van de kenmerken aan het fragment dat je gelezen hebt.
Je bespreking bevat één of geen van de gevraagde elementen.
Je kunt een informatief artikel lezen en begrijpen 1
Je kunt inschatten
Je kunt via lees- en woordenschatstrategieën de betekenis van onbekende woorden achterhalen
hoe ons Nederlands evolueert na de pandemie
In maart 2020 stond de wereld plots stil. Het coronavirus schopte stevig om zich heen en veel mensen raakten besmet, werden ziek, of erger nog, overleden ten gevolge van dit virus. Landsgrenzen gingen dicht, regeringen namen drastische maatregelen zoals het inperken van onze bewegingsvrijheid, het afstand houden van familieleden en vrienden, het sluiten van de horeca, scholen … Enkel noodzakelijke boodschappen konden nog. Ieder land nam andere maatregelen, afhankelijk van de ernst van de situatie aldaar. Al snel domineerde covid-19 de hele media en beïnvloedde het langs die weg zelfs ons dagelijks taalgebruik.
De krant De Standaard staat in een uitgebreid artikel stil bij de invloed die de pandemie had op ons dagelijks taalgebruik. Lees de tekst op p. 213-214 een eerste keer globaal en bespreek klassikaal volgende vragen.
1 Als je de titel en de tussentitels bekijkt, kun je dan besluiten waarover de tekst gaat?
2 Wat is het hoofddoel van de tekst?
3 In de tekst staan verschillende moeilijke woorden. Je vindt hieronder een selectie. Orden onderstaande woorden in vier groepen. Gebruik voor elke groep een andere markeerkleur.
A woorden die ik nog nooit heb gehoord
B woorden die ik al gehoord heb, maar die ik niet begrijp
C woorden die ik begrijp als ik ze hoor/lees, maar zelf niet zou kunnen gebruiken
D woorden die ik begrijp en die ik zelf in een betekenisvolle zin zou kunnen gebruiken
massaal – nestelen – kruisbestuiving – vakjargon – iets duiden – alternatief – circuleren – forceren – krakkemikkig –territorium – vrijpostig – stoutmoedig – fenomeen – tsunami
4 Wat verwacht je dat een journalist denkt over de Engelse woorden in het Nederlands?
5 De auteur van het artikel behandelt de taal Nederlands op een bijzondere manier. Leg dit uit aan de hand van de titels en tussentitels.
6 In de tekst verwijst de auteur naar het woordenboek Van Dale. Wat is volgens jou de betrouwbaarheid van deze bron?
7 Hoeveel woorden zijn er bijgekomen in het Nederlands naar aanleiding van de pandemie?
ALS BESCHERMING TEGEN AL DAT CORONA-ENGELS:

‘Alle “preteaching”, “videocalls”, “home working” en “contact tracers” ten spijt, als we ons niet massaal aan de “social distancing” houden, raken we nooit uit deze “lockdown”.’ Het ene virus moet een ander hebben voortgebracht: samen met de verspreiding van sars-CoV-2 heeft zich een hardnekkig corona-Engels genesteld in ons Nederlands. Sommigen zullen het niet eens opgemerkt hebben, maar heel wat mensen krijgen er eczeemachtige jeuk van aan hun taalgevoel. Wat is er dan aan de hand met dat Engels in de krant en daarbuiten?





Engels - Nederlands: een kruisbestuiving?
Eerste geruststelling. Met het coronavirus is niet alleen een bataljon Engels onze taal ingeslopen. Hoofdredacteur van Van Dale Ton den Boon verzamelde in zijn online Coronawoordenboek heel wat termen, waarvan de meeste Nederlandstalig.

‘Een maatschappelijke verandering brengt nu eenmaal nieuwe termen mee. Gaat het daarbij om een internationale crisis, zoals deze, dan volgen er automatisch internationale termen, zoals “lockdown” of “flatten the curve”. Als er voor een concept een gat is in onze taal, dan moet dat gevuld worden’, verklaart taalkundige Eline Zenner (KU Leuven). ‘Maar volgens mij storen mensen zich er meer aan dat er vaker vakjargon gebruikt wordt, dan dat het om Engels gaat. Belangrijk is dat de media zulke nieuwe woorden goed duiden. Dat er eerst wat terughoudendheid is om zo’n vakterm naar het Nederlands te vertalen, is begrijpelijk. Je wilt niet nog méér verwarring zaaien.’
‘De toegankelijkheid van een tekst kan alleen maar winnen bij een goed Nederlands alternatief ’, vindt taalkundige Johan De Caluwe (UGent). ‘Op voorwaarde dat de remedie niet erger is dan de “kwaal”. Liever een Engels woord dat internationaal circuleert dan een geforceerd, krakkemikkig Nederlands alternatief. Hoe langer het duurt voor je een krachtige vertaling te pakken hebt, hoe meer kans dat de Engelse term al zowat het hele territorium heeft ingenomen. Zeker als die kort en krachtig is, en zijn succes in de brontaal al heeft bewezen.’
Nederlands als overwinnaar?
Nederlanders staan erom bekend dat ze vrijpostiger met onze taal durven om te gaan dan Vlamingen. Maar of ze daarom stoutmoediger corona-Engels in Nederlands durven om te zetten, of omgekeerd, zonder wroeging meer Engels gebruiken? De Nederlandse historisch taalkundige en leenwoordspecialiste Nicoline van der Sijs (Radboud Universiteit Nijmegen) ziet weinig verschil. ‘Bij een nieuw fenomeen zie je eerst meer leenwoorden, maar als de coronacrisis nog lang duurt, zul je merken dat we vanzelf naar meer Nederlands gaan.’
En of journalisten over het algemeen meer Engels gebruiken dan vroeger? Van der Sijs haalt er de cijfers bij. Zij onderzocht de toename van het aantal Engelse leenwoorden in krantenteksten over een periode van 50 jaar en stelde vast dat er hoegenaamd geen sprake van een tsunami aan Engelse leenwoorden is in krantenteksten.’
‘Engelse woorden in onze taal zijn erg vluchtig, want ze hangen vaak samen met nieuwigheden. Na dertig jaar is een derde weer verdwenen. Nu stikt het van de coronawoorden, maar daar zullen er weinig van overblijven. Bovendien, zodra je een Engels leenwoord gebruikt, is het gewoon Nederlands: je spreekt het vaak op zijn Nederlands uit, je geeft het een meervoud en verkleinwoord en je vervoegt het volgens de regels van het Nederlands – “kom je mee hangouten?”’
Bron: www.standaard.be - 11/05/2020
Lees het krantenartikel nu grondig.
1 Maak een woordenlijst met de moeilijke woorden uit de tekst.
2 Welk zelfstandig naamwoord herken je in de volgende woorden?
a massaal
b nestelen
c circuleren
3 Bekijk onderstaande leenwoorden.
a Gaat het om een vreemd woord of een bastaardwoord?
b Uit welke brontaal komen de woorden?
videocallen – contact tracer – territorium – preteachen – lockdownen – tsunami – circuleren


brontaal vreemd woord bastaardwoord
Engels Latijn
alternatief – circuleren – (iets) duiden – fenomeen – forceren – krakkemikkig – kruisbestuiving – massaal – nestelen –stoutmoedig – territorium – tsunami – vakjargon – vrijpostig
a Ze zich met een goed boek onder haar fleecedekentje.
b De getuige zijn verklaring met sms’jes als bewijskracht.
c Een gezonder voor suiker is stevia.
d Een dier bakent zijn vaak met urine af om indringers op een afstand te houden.
e In Italiaans probeerde ik deze zomer een ijstaart te bestellen in San Gimignano. Tja, na een semester Italiaans dacht ik al veel beter mijn plan te kunnen trekken in deze mooie taal.
f Toen bleek dat Sara de sleutel van haar locker kwijt was, probeerde ze het slot te met een schroevendraaier. Dat tikte haar schoolrekening echter flink aan.
g ‘Wat een saaie les!’, riep de nieuwe leerling. Zo’n opmerking kon maar op weinig waardering rekenen bij de leerkracht.
h Tijdens de jaarlijkse natuuravond van onze vereniging verviel de professor al snel in zo’n danig dat nog maar weinig mensen mee waren met zijn uitleg.
i Op wijze trotseerde de brandweerman de brandende loods om een nest kittens van een gewisse dood te redden.
5 De auteur laat een aantal mensen aan het woord.
a Wie komt er vooral aan het woord in de tekst?
b Waarom laat de auteur net die mensen aan het woord?
Leenwoorden zijn woorden die het Nederlands uit andere talen heeft overgenomen. We kennen twee soorten: vreemde woorden en bastaardwoorden
• Vreemde woorden zijn leenwoorden die hun oorspronkelijke spelling en uitspraak behouden hebben.
e-mail, carrière, mecanicien
• Bastaardwoorden zijn leenwoorden die aan het Nederlands zijn aangepast. Vaak zie je aan die woorden niet meer zo goed dat ze uit een andere taal komen.
solden, biefstuk, sigaar, rugzak
6 Er werden veel Engelstalige coronaleenwoorden in het Nederlands opgenomen.
a Welke verklaring geeft het artikel hiervoor?
b Waarom worden de Engelse termen niet gewoon naar het Nederlands vertaald?
c Zijn die Engelse leenwoorden blijvertjes?
7 Wat heb je op dit moment geleerd?
Een maatschappelijke verandering heeft een onmiddellijke invloed op ons taalgebruik. Waar aanvankelijk vooral Engelse leenwoorden in de berichtgeving worden gebruikt, verliezen die nadien aan belang en kiezen taalgebruikers voor Nederlandse alternatieven.
Bij de berichtgeving is het essentieel dat de boodschap begrepen wordt. Soms is een leenwoord gewoon beter, vollediger, maar toch worden ook deze al gauw ‘vernederlandst’.
1 Je leerkracht deelt een reeks woorden met de klas. Ontdek samen welke coronatermen de pandemie hebben overleefd.
2 Welke woorden of zinsdelen houden verband met elkaar? Als je vier goede combinaties maakt, krijg je meteen ook vier ‘coronawoorden’ verklaard.
social distance quarantainebubbel nieuwe leerstof eigen gezin
vast aantal personen live herhalen 1,5 meter preteaching
contact tracers afstand besmet persoon contacten
opsporen PPT of filmpjes onbelemmerd zien overdracht virus beperken
3 Hieronder zie je twee klavertjes. Drie woorden hebben telkens een link. Welke link zoeken we?















binnen blijven
4 Welke woorden herken je in de afbeeldingen?
5 Welke woorden uit opdracht 4 worden nog e ectief gebruikt?
6 Hoe komt het dat bepaalde woorden verdwenen zijn?



7 Kun je kort samenvatten wat je in deze les over taalevolutie geleerd hebt?









Je herkent en definieert een podcast 1
2
Je selecteert relevante informatie uit een podcast
1 Beluisterde jij al eens een podcast? Waarom wel/niet?
Uitbreiding: je maakt een podcast aan de hand van een voorbeeld
2 Zijn volgende stellingen volgens jou juist of fout? Duid aan in de kolom ‘voor het lezen’. voor het lezenna het lezen
a Een podcast beluister je via de radio.
b Uit een onderzoek van mei 2022 blijkt dat ongeveer 30% van de Belgen naar een podcast luistert.
c Een podcast bestaat enkel uit audio.
d Het doel van een podcast is informeren.
3 Lees het artikel Podcast killed the radio star? op de volgende pagina. a Waarom is een podcast een soort van audio blogging’?
juist fout juist fout
juist
fout
juist fout
juist fout juist fout
juist
fout juist fout
b Om welke drie redenen verkiezen luisteraars een podcast boven een radio-uitzending?
c Wat betekent het woord ‘associatie’ in de voorlaatste alinea van het artikel?
29% van de Belgen luistert naar podcasts en de helft van de Belgische podcastluisteraars luistert liever naar podcasts dan dat ze de radio nog opzetten. Wat is dit relatief nieuwe medium dat de concurrentie aangaat met programma’s op de radio?


Een podcast is een informatief programma dat beluisterd wordt wanneer het de luisteraar uitkomt, ofwel ‘on demand’. Meer dan de helft van de podcasts worden thuis beluisterd, gevolgd door in de vrije tijd, op het openbaar vervoer, in de wagen en vlak voor het slapengaan.
Een podcast bevat uitsluitend audio en geen video. Sommige podcasters filmen hun programma en maken dit beschikbaar via een videoplatform zoals YouTube. Samengevat is een podcast een soort ‘audio blogging’ of ‘radio on demand’.

De term podcast is afgeleid van de woorden ‘iPod’ en ‘Broadcast’. ‘iPod’ verwijst naar audio en ‘broadcast’ staat voor uitzending. Toen de podcasts als nieuw medium verschenen in 2004, waren ze enkel beschikbaar voor de iPod van Apple. Tegenwoordig worden podcasts voornamelijk via smartphones beluisterd. Eigenlijk zou de naam aangepast moeten worden, maar de term is een soortnaam geworden – de associatie met de iPod is er niet meer.
Traditionele radio is zo breed mogelijk, terwijl podcasts net de diepte opzoeken. De meeste podcasts focussen op een specifiek onderwerp zoals sport, misdaad, technologie of gezondheid. Voor deze onderwerpen is er op de traditionele radiostations vaak geen of onvoldoende ruimte. 8 op 10 luisteraars vindt dat de podcast meer kennis en duiding geven. Meer nog, nieuwsconsumenten beschouwen podcasts als een geloofwaardiger medium dan radio, tv en kranten. ‘Audio on demand’ eist zo een steeds belangrijker deel van het medialandschap op.
Naar: www.trustmedia.be en www.radioviainternet.nl
4 Ga terug naar opdracht 2 op de vorige pagina en beantwoord de vragen opnieuw.
5 Je krijgt van de leerkracht een thema. Zoek online een podcast die over dat thema gaat. a Vul de informatie in.
b Uitbreiding: beluister de podcast en noteer vijf zaken die jij hebt geleerd.
1 Je beluistert een deel van de podcast over het onderwerp ‘de metaverse’ uit de reeks #weetikveel met Kobe Ilsen. Omcirkel de woorden waarvan jij denkt dat je ze zult horen.

avatar beleggen cinema fantasie literatuur meta misdaad nft’s r&b token VR-brillen
2 Lees de de nitie van ‘de metaverse’ en formuleer drie vragen waarop jij graag het antwoord zou willen weten na het beluisteren van de podcast.
Met ‘de metaverse’ wordt doorgaans een virtuele wereld bedoeld waarin mensen online met elkaar in contact kunnen komen. Het is een netwerk van virtuele 3D-ruimtes waarin gebruikers allerhande activiteiten kunnen uitvoeren via een avatar, een digitale dubbelganger
Bron: multimedia.tijd.be
3 Luister naar het fragment uit de podcast en beantwoord de vragen. a Welke drie eigenschappen moet een metaverse volgens Jeroen Baert hebben?
b Wat staat er het dichtst bij de metaverse op het moment dat de podcast werd opgenomen?
c Welke belofte maakte Mark Zuckerberg eind 2021 over de metaverse?
d Wat kun je in de metaverse meer dan in de analoge wereld?
4 Zou jij interesse hebben in een ervaring met de metaverse? Wat zou je dan willen meemaken/doen? Bespreek enkele opties met een medeleerling.
5 De podcast werd al enige tijd geleden opgenomen. Zijn er al veranderingen omtrent de ‘metaverse’? Zoek informatie op het internet en schrijf een korte tekst waarin je de verschillen en/of gelijkenissen beschrijft.
• Staat er al iets anders dichter bij de metaverse (vraag b)?
• Kwam Mark Zuckerberg zijn belofte ondertussen al na (vraag c)?
6 Volg de owchart op p. 222 om te bekijken welke podcast bij jou zou passen.
a Bij welke podcast kwam je uit?
b Heb je deze podcast al beluisterd? Ben je van plan om deze podcast te beluisteren?
Waarom? Daarom!
Reden: te saai?
Reden: te lang?
Reden: te moeilijk?
liever over sport liever grappig liever over muziek










liever over misdaad





liever over seks en vriendschap liever geen podcast











In #weetikveel gaat presentator Kobe Ilsen op zoek naar toffe en verrassende weetjes over boeiende onderwerpen.
Bij de Universiteit van Vlaanderen delen wetenschappers de meest spannende wetenschappelijke inzichten en ontdekkingen.
Waarom is de lucht blauw? Waarom kunnen schepen drijven? In Waarom? Daarom! schakelen Maarten & Dorothee van Q-Music de hulp in van de man die alle antwoorden heeft: Lieven Scheire.
De koers is van ons is een podcast vol actuele analyses, opvallende verhalen en een dagelijkse ‘trip down memory lane’ over het wielrennen.
De Tribune is een uurtje podcast, twee gasten met een mening en de meest brandende sportactualiteit van de afgelopen week.
In de wekelijkse podcast Welcome tot the AA gaat comedian Alex Agnew samen met partner in crime Andries Beckers op zoek naar mensen of onderwerpen die deel uitmaken van hun leefwereld. Mosselen om Half Twee is een humoristische podcast door Vlaamse comedian Xander De Rycke.
In Thank you, boomer trapt Thibault Christaensen muziekliefhebbers op de teentjes door enkele tijdloze artiesten in twijfel te trekken. Hij gaat in gesprek met bekende superfans.
Stijn Van de Voorde laat elke week zijn licht schijnen over het popnieuws in De Popcast van de Week . Hij krijgt daarbij de hulp van een bekende gast.
De Kroongetuigen is een reeks over waargebeurde verhalen. Iedere aflevering belicht een misdaaddossier uit de Vlaamse geschiedenis op basis van getuigenissen van de toenmalige speurders en betrokkenen.
In De volksjury speculeren Laura en Silke op een onverantwoorde manier over onopgeloste moordzaken.
Vraag het aan Rika is de relatiepodcast waar geen enkele vraag over vriendschap, liefde en andere relaties te veel is.
Vriendinnen Kawtar en Anushka delen levenslessen waar niemand hen ooit eerder voor waarschuwde in de podcast Bless
The Mess
1 Je zult een gesprek beluisteren uit Interne Keuken. Lees op p. 224 de algemene informatie over het programma en kies het onderwerp dat je het meest interesseert.
A Je beluistert een tafelgesprek uit Interne Keuken met de auteur Linda Polmans over het boek Death Row Dollies. Waarom kiezen sommige vrouwen voor een relatie met een man die veroordeeld is tot de doodstraf?
B Kim Van de Perre, journaliste bij De Morgen, spreekt over de nationale Afghaanse vrouwenvoetbalploeg. Zij gebruiken de sport om op te komen voor gelijke rechten.
C Altijd weer opnieuw zijn er mensen die zich luidop afvragen of een ‘pedagogische tik’ toch niet moet kunnen. Die vraag neemt Philippe Noens als vertrekpunt voor een boeiend gesprek over opvoeden.
D Bitcoins kopen: ja of nee? Gwen Busseniers legt uit hoe dat hele circus precies in elkaar zit. woord
toenmalig: van die tijd speculeren: hier: ergens mogelijkheden voor bedenken
Interne Keuken is een Vlaams programma op Radio gepresenteerd door Koen Fillet en Sven Speybrouck. Zij interviewen wekelijks vier gasten tijdens een tafelgesprek over de actualiteit.

3 Luister naar het interview en probeer het zo te verwerken dat je achteraf de essentie ervan kunt reconstrueren. Duid aan hoe je te werk zult gaan.
onmiddellijk een schema maken (eenvoudige tabel, flowchart, mindmap, losse woorden, ander)
achteraf een schema maken
aantekeningen maken tijdens het luisteren (zinnen of woorden)
het interview gewoon beluisteren, eventueel verschillende keren
tekeningen maken
achteraf in volzinnen opschrijven wat je er nog van weet ander
• Schrijf nooit dingen letterlijk over.

• Focus op de hoofdzaken en noteer kernwoorden.
• Maak gebruik van afkortingen, pijlen en tekens.
Een schema is bedoeld om informatie te ordenen of overzichtelijk en visueel weer te geven. Iedereen heeft een eigen manier om schema’s en notities te maken. Belangrijk is dat je kernelementen van een tekst op een voor jou gestructureerde en duidelijke manier weergeeft.
4 Luister naar het interview en noteer minstens acht woorden/begrippen die je moeilijk vindt. Maak een woordenlijst en verklaar de woorden aan de hand van de context van het interview. Lukt dat niet, zet dan een hulplijn in: een medeleerling, andere persoon, (online) woordenboek, internet, leerkracht … begrip verklaring
5 Beantwoord onderstaande vragen na het beluisteren van het interview.
a Wat was de directe aanleiding om dit onderwerp te behandelen of om deze gast uit te nodigen?
b Hebben de interviewers ook de vragen gesteld die jij wilde stellen? ja nee
c Welke vragen zou jij na het beluisteren van het interview nog aan de gast willen stellen?
d Wat heb je bijgeleerd met dit interview? Geef minstens twee voorbeelden.
Je neemt als afsluitende opdracht zelf een podcast op van vijf minuten.
1 Vorm een duo met een medeleerling en kies een hoofdstuk van een ander vak dat jullie interesseert.
2 Vul onderstaande tabel in om de podcast voor te bereiden.
Teaser
Stel enkele essentiële vragen over het onderwerp waarop de luisteraar een antwoord zal krijgen.
Intromuziek
Kies een fragment dat past bij het onderwerp.
Welkom bij … Geef de naam van je podcastreeks en het onderwerp.
Inhoud
Maak een opsomming van de zaken die je wilt vertellen over het onderwerp.
Conclusie
Geef een antwoord op de vragen die je in de teaser stelde.
Outromuziek
Kies een fragment dat bij het vorige fragment past.
3 Kies een rol: een van jullie is de programmamaker, de andere is de gast.
4 Neem de podcast op.
5 Maak gebruik van de evaluatiematrix op de volgende pagina om jullie podcast te beoordelen. Pas de podcast nog aan waar nodig.
Je podcast is volledig en elk onderdeel is goed uitgewerkt.
- Je vermeldt de naam van de podcastreeks en het onderwerp van de podcast.
- Je stelt enkele vragen waarop de luisteraar het antwoord zal krijgen.
- Je geeft een antwoord op de vragen die je in de teaser stelde.
- Je podcast heeft passende intro- en outromuziek.
Je podcast is volledig, maar één of twee onderdelen zijn niet goed uitgewerkt.
De podcast is niet volledig.
duidelijkheid en aantrekkelijkheid
Je podcast is inhoudelijk sterk. Je brengt de informatie op een gestructureerde manier over.
Je taalgebruik is nagenoeg foutloos. Je spreekt Standaardnederlands.
Aanvullende commentaar:
De podcast is inhoudelijk in orde, maar de structuur kan beter. OF De structuur van de podcast is prima, maar de inhoud kan beter.
Je gebruikt soms tussentaal en/of dialect.
De structuur van de podcast is niet goed.
Je uitspraak is onverzorgd (dialect, tussentaal) en leidt de aandacht af van de boodschap.
Je kunt tabellen en grafieken correct interpreteren 1 Je kunt verschillende soorten tabellen en grafieken herkennen
Je kunt misleidende tabellen en grafieken herkennen 3
Je kunt zelf tabellen en grafieken maken
1 Je leerde als kind je moedertaal spreken zonder hiervoor naar school te gaan.
a Weet jij wat je eerste woordje was?
b Wanneer begon je zinnen te gebruiken?
c Op welke manier leerde je andere talen, zoals Frans, Engels, Spaans of Duits?
Je bekijkt alvast een filmpje om wat meer te weten te komen over taalverwerving.
2 Je krijgt op deze en volgende pagina drie gra eken en een tabel over moedertaalverwerving bij kinderen. Bekijk deze eerst aandachtig.
1 Grafiek Taalverwervingslijn
2 Grafiek Woordenschatverwerving
3 Grafiek Normale taalontwikkeling
spraak van het kind
eerste woordjes
zegt en woorden
tweewoordzinnen
driewoordzinnen
verhaaltje vertellen
samengestelde zinnen
volledig verstaanbaar
4 Tabel Moedertaalontwikkeling
fase leeftijd* activiteiten voorbeeld
voortalige fase 0-0;7 spraakklanken waarnemen en geluidjes maken eieieiei, tatatata, sjsjsjsj, riiiiiiii brabbelfase 0;7-1;0 klanken nabootsen en oefenen dedadedadada, memememe, bakagoegoe
eenwoordfase 1;0-1;6 met losse woorden wordt een zin bedoeld mama, papa, naan (banaan)
meerwoordfase 1;6-2;6 korte zinnetjes en combinaties van woorden
differentiatiefase 2;6-9;0 uitbreiding van de woordenschat en ontwikkeling van de grammatica
* 0;7 betekent: 0 jaar en 7 maanden
3 Bekijk volgende uitspraken.
a Zijn de uitspraken waar of niet waar? Duid aan.
pop hebben, pop muts hebben, Katelijn pop muts hebben
Ik heb onze goeie auto terug vont; het paard klimde op de stoel, en toen viel het, en toen huilde het.
b Noteer het nummer van de grafiek of de tabel waar je de informatie vond. waar
1 Grammaticale ontwikkeling start later dan woordenschatverwerving bij een kind.
2Wanneer een kind samengestelde zinnen kan gebruiken, is het ook volledig verstaanbaar.
3Vanaf de leeftijd van 18 maanden kan een kind 10 woorden gebruiken.
4Een kind tussen 5 en 6 jaar kent zo’n 2 600 woorden.
5Kinderen leren meer taal tussen de leeftijd van 0 en 6 jaar dan tussen de leeftijd van 6 en 11 jaar.
6Kinderen ‘spreken’ al voor ze hun eerste woord gebruikt hebben.
7Tussen de leeftijd van 3 en 5 jaar evolueert de woordenschat van een kind van ongeveer 900 woorden naar 2 100 woorden.
8Volwassenen bieden kinderen van 7 jaar meer talige context aan dan kinderen van 5 jaar.
4 Bespreek je antwoorden met een medeleerling.
a Komen jullie tot dezelfde conclusies?
b Op welk gebied ondervond je moeilijkheden bij het lezen en interpreteren van de gegevens?
c Zijn er cijfers die je verbazen?
5 Moedertaalontwikkeling maakt deel uit van de volledige ontwikkeling van kinderen. Je vindt hier een gra ek over de kritische periodes van ontwikkeling bij kinderen en een bijhorende bespreking. Welke fouten merk je op in de bespreking? Markeer ze in de tekst en verbeter ze.
Grafiek Kritische periodes van ontwikkeling
zintuiglijke ontwikkeling motorische ontwikkeling
spraaktaalontwikkeling
sociaal-emo onele en cogni eve ontwikkeling
De verschillende vormen van ontwikkeling starten allemaal meteen na de geboorte van een kind. De zintuiglijke ontwikkeling evolueert het snelst, gevolgd door de spraaktaalontwikkeling. De motorische ontwikkeling van een kind is het opmerkelijkst rond de leeftijd van 1 jaar, terwijl dit bij de sociaalemotionele en cognitieve ontwikkeling pas veel later is. De talige ontwikkeling is op haar hoogtepunt rond de leeftijd van 2 jaar.
Verbetering: 1 2 3
6 In de vorige opdrachten kwam je een aantal moeilijke woorden tegen.
a Verbind de woorden met de bijpassende zin.
b Markeer nadien de kernwoorden in de omschrijving die je leiden naar de betekenis van het moeilijke woord.
1 cognitieve ontwikkeling
2 grammatica
3 taalverwerving
4 motorische ontwikkeling
5 kritische periode
6spraaktaalontwikkeling
7sociaal-emotionele ontwikkeling
8 moedertaal
aOnderzoekers stellen vast dat je enkel tot op een bepaalde leeftijd in staat bent een taal te verwerven tot op het niveau van een moedertaalspreker.
bLeren hoe je met je eigen gevoelens en die van een ander omgaat, is niet evident. Die ontwikkeling start daarom eerder laat.
cBaby’s leren eerst kruipen, rollen … alvorens ze met hun vingertjes fijne bewegingen leren maken.
d Kinderen starten al in de baarmoeder met het cognitieve leerproces waarbij ze hun moedertaal leren.
e Een taalsysteem laat woorden combineren met andere woorden tot woordgroepen en hele zinnen, ieder met hun eigen betekenis, en dat werkt precies hetzelfde in alle talen van de wereld. (Zeijlstra)
fKinderen die doof geboren worden, hebben soms moeite met het correct leren uitspreken van woorden.
gDeze taal leer je automatisch en heel erg snel. Bovendien begint dit proces al op erg vroege leeftijd.
h Het verwerven, verwerken, opslaan en vervolgens toepassen van kennis bij de mens start erg vroeg, maar is niet direct zichtbaar voor de buitenwereld. 12345678
Er bestaan heel wat soorten grafieken en elke soort drukt andere informatie uit. Door het soort grafiek te analyseren kom je dus al heel wat te weten over de boodschap die de grafiek wil overbrengen.
1 Op p. 232 krijg je enkele gra eken te zien.
a Plaats alle grafieken bij de juiste grafieksoort.
b Achterhaal nadien wat de functie is van de grafiek: een vergelijking, evolutie of correlatie
grafiektype functie voorbeeld
staafdiagram
(horizontaal of verticaal)
gestapeld staafdiagram
(horizontaal of verticaal)
taart- of cirkeldiagram
lijndiagram
spreidingsdiagram
Deze grafieken geven een vergelijking / een evolutie / een correlatie weer.
Deze grafiek geeft een vergelijking / een evolutie / een correlatie weer.
Deze grafiek geeft een vergelijking / een evolutie / een correlatie weer.
Correlatie geeft de mate van samenhang tussen twee variabelen. Bij een hoge correlatie komen beide verschijnselen relatief vaak samen voor zonder dat daarbij noodzakelijk sprake is van een oorzakelijk verband. Het verband kan ook toevallig zijn of beïnvloed worden door een externe factor. Voorbeelden:
• positieve correlatie: We zien een correlatie tussen de temperatuur en het aantal ijsjes dat wordt verkocht: hoe warmer het buiten is, hoe meer ijsjes er worden verkocht. (De variabelen nemen samen toe of af.)
• negatieve correlatie: Hoe hoger je stijgt boven het zeeniveau, hoe lager de temperatuur is. (De ene variabele neemt toe, de andere neemt af.)
• geen correlatie: Er blijkt geen verband te zijn tussen het aantal uren dat iemand fietst per dag en het aantal uren dat deze persoon televisie kijkt.
• correlatie zonder oorzakelijk verband: Hoe meer ijsjes er worden verkocht, hoe meer mensen er verdrinken.

Toetsscore van alle leerlingen uit een klasgroep ten opzichte van studietijd
Talen in Brussel
Woordenschatontwikkeling bij kinderen
Bron: Appel, Kuiken & Vermeer (2001), Nederlands als tweede taal in het basisonderwijs
Antwoord op de vraag: waarom heb je een nieuwe taal geleerd?
Aan de ene kant hoor je wel eens vertellen dat cijfers niet liegen, maar vaak genoeg is al aangetoond dat cijfers slechts een deel van de waarheid vertellen. Godfried Bomans verwoordde het mooi:
‘Een statisticus waadde vol vertrouwen door een rivier die gemiddeld één meter diep was. Hij verdronk.’
Ook Winston Churchill geloofde niet in de kracht van statistieken:
‘Ik geloof alleen de statistieken die ik zelf vervalst heb.’
1 Je leerkracht toont je een beeldfragment. Daarin worden verschillende manieren aangehaald waarop gra eken gemanipuleerd worden. Noteer de vier vormen van manipulatie die aan bod komen.
Uitslag Nederlands referendum over de Associatieovereenkomst tussen de


























2 Leg kort uit op welke manier de gra eken op p. 234 misleidend zijn. Benoem eveneens het type gra ek.
AFSLUITENDE OPDRACHT: EEN GRAFIEK OPSTELLEN
Grafieken zijn onontbeerlijk om cijfermateriaal duidelijk weer te geven. Je ziet hier een tabel die aangeeft op welke leeftijd kinderen met een taalontwikkelingsstoornis aangemeld werden voor extra ondersteuning.
leeftijd (jaar; maand) aantal aangemelde kinderen
Je kunt in je tekstverwerkingsprogramma heel gemakkelijk zelf grafieken genereren. Kies bij ‘Invoegen’ de optie ‘Grafiek ’. Overweeg eerst nauwkeurig welk type grafiek je selecteert en vul de gegevens in de Excel-tabel in. Proberen maar!

1 Werk deze gegevens uit tot een overzichtelijke en correcte gra ek.
a Welke soort grafiek kies je om de gegevens te verduidelijken?
b Teken de grafiek. Je kunt de opdracht op papier of digitaal maken.
Sinds 2018 is een alcoholslot verplicht voor bestuurders die betrapt werden met meer dan 1,8 promille in hun bloed. Er worden dus al maatregelen genomen om het alcoholgebruik van bestuurders te verminderen. Je moet niet iedereen straffen omdat sommige mensen hun eigen grenzen niet kennen.
Volgens de website van de Vlaamse Stichting Verkeerskunde speelt alcohol een rol in 1 op 4 van de ongevallen. Ze stellen dat vanaf een alcoholpercentage van 0,5 promille in het bloed, het risico op een ongeval met 40% stijgt. Het risico op een ongeval bij jonge bestuurders met hetzelfde alcoholpercentage in het bloed, ligt volgens de VSV zelfs nog hoger. Op basis van die cij fers kan er enkel gezegd worden dat een nultolerantie een goed idee is.
Op de website van de Vlaamse Stichting Verkeerskunde hebben ze een overzicht van wat alcohol met je lichaam doet. Alcohol vertraagt je reactietijd van ongeveer 1 seconde of minder tot 2 of 3 seconden en het zorgt ervoor dat je meer moeite hebt om te focussen op de weg waardoor je mogelijk gaat slingeren over de baan. Wanneer iemand alcohol drinkt en vervolgens de fiets naar huis neemt, kan die een gevaar vormen voor zichzelf, maar ook voor anderen op de weg. Het is dus nodig om een nultolerantie voor fietsers in te voeren.







Mijn beste vriendin werd aangereden door een dronken autobestuurder. Als er al eerder een nultolerantie was ingevoerd, was dit misschien nooit gebeurd.













De lever heeft gemiddeld 1,5 uur nodig om een doorsnee glas alcohol af te breken. Een nultolerantie is dus noodzakelijk.
Een nultolerantie is te gek voor woorden. We verbieden iemand toch ook niet om een dessert te eten omdat dit gevaarlijke gevolgen kan hebben?
Mogen we nog iets hebben in ons leven? Dit is de zoveelste pestactie van politici, ze willen enkel een nultolerantie zodat ze extra boetes kunnen uitschrijven om zo de door hen gecreëerde staatsschuld te verminderen.
In 1 op 4 van de ongevallen is er sprake van alcoholmisbruik, in de andere 3 op 4 gevallen liggen slechte wegen en gsm-gebruik mogelijk aan de oorzaak van het gevaar.
Het is belangrijker om op die factoren te focussen.















Nultolerantie voor alcohol in het verkeer hanteren, gaat in tegen elke erkende logica van verkeersveiligheid. Bijna overal in Europa geldt er een limiet van 0,5 promille. In Engeland, Ierland en Malta ligt de grens zelfs wat hoger met 0,8 promille. Wat blijkt? Die landen scoren veel beter op vlak van verkeersveiligheid. Dat bewijst dat er geen link is tussen het aantal en het type ongevallen in een land, en de toegelaten alcohollimiet.’
Het is moeilijk in te schatten wanneer iemand de toegestane limiet van alcoholgehalte in het bloed heeft bereikt. Hoeveel kan iemand drinken alvorens een bepaald promille te hebben? De enige manier om daar duidelijkheid over te krijgen, is om een nultolerantie in te voeren.
1 Op de vorige pagina lees je enkele reacties van mensen op de vraag of er een nultolerantie voor alcohol zou moeten komen in het verkeer. Rangschik die reacties op het continuüm op basis van hun argumentatie.
zwak argument sterk argument ONTHOUDEN
Een continuüm is een doorlopende lijn tussen twee uitersten waarop bepaalde zaken geplaatst kunnen worden die in meer of mindere mate voldoen aan de criteria van de uitersten. Afhankelijk van de visie van een persoon kan een bepaald gegeven meer naar het ene of naar het andere uiterste neigen.
2 Vergelijk jouw rangschikking met die van twee medeleerlingen. Hadden jullie hetzelfde idee? Beargumenteer telkens je keuze.
3 Wie heeft jou het meest van zijn/haar standpunt kunnen overtuigen? Waarom?
STANDPUNT, ARGUMENT, FEIT EN MENING
Om iemand te kunnen overtuigen, is een goede argumentatie noodzakelijk. Alvorens de argumentatie van een partij te kunnen beoordelen, is het belangrijk om de argumenten en het standpunt van een partij van elkaar te kunnen onderscheiden.
1 Wat is het verschil tussen een standpunt, een argument en een tegenargument?
Een standpunt is
Een argument is
Een tegenargument is
2 Markeer het standpunt van de spreker en onderstreep het argument dat gebruikt wordt om het standpunt te verdedigen.
a In het verkeer is een nultolerantie voor verdovende middelen noodzakelijk, want elk jaar worden er meerdere ongelukken veroorzaakt door autobestuurders die rijden onder invloed.
b Omwille van het toenemende hitte-eilandeffect overal in de binnensteden is het belangrijk om in binnensteden extra bomen te planten.
c Ik ga liever met de trein op vakantie, omdat het vliegtuig veel schadelijker is voor het milieu.
d Om de begrijpbaarheid van dialogen te garanderen, is het belangrijk dat acteurs steeds Algemeen Nederlands spreken.
e Omdat de boekentassen van de schoolgaande jeugd te zwaar zijn, pleit ik voor het gebruik van digitale schoolboeken op tablets.
Signaalwoorden die vaak gebruikt worden in combinatie met een argument zijn omdat, doordat, aangezien en want
3 Wat is het verschil tussen een feit en een mening?
Een feit is
Een mening is
4 Bepaal of het om een feit of een mening gaat.
Water kookt bij 100°C.
In België wordt de lekkerste chocolade gemaakt.
Het praktische rijexamen is te moeilijk.
Tijdens een voetbalwedstrijd begint elke ploeg met elf spelers op het veld.
Er zou geen huiswerk gegeven mogen worden tijdens een vakantie.
5 Is een goed argument volgens jou doorgaans gebaseerd op een feit of een mening? Waarom?
1 Hieronder vind je een overzicht van soorten argumenten die gebruikt kunnen worden wanneer je iemand wilt overtuigen. Bij elk type argument staat een voorbeeld. Zoek samen met een medeleerling nog een extra voorbeeld voor elke soort.
Deugdelijke argumenten
Een deugdelijk argument is een argument waar niets op aan te merken valt, een goed argument.
Argumenten gebaseerd op een autoriteit
Je baseert je argument op een persoon/instituut die/dat gespecialiseerd is in een bepaald domein en dus met autoriteit kan spreken over het onderwerp.
Pieter Van De Craen, professor taalkunde aan de Vrije Universiteit Brussel, stelt dat leren in verschillende talen ervoor zorgt dat de talenkennis van leerlingen van zowel de vreemde taal als die van de moedertaal beter wordt.
Argumenten gebaseerd op cijfers en statistieken
Je geeft argumenten gebaseerd op cijfermateriaal (cijfers, statistieken, grafieken, tabellen ...).
In behaalden de Vlaamse jongeren ( jaar) een gemiddelde PISA-score van punten voor leesvaardigheid.
Argumenten gebaseerd op een vergelijking
Je baseert je argument op een vergelijking met een gelijkaardige situatie.
In Engeland, Ierland en Malta ligt de grens met , promille zelfs hoger dan in België. Wat blijkt? Deze landen scoren veel beter op vlak van verkeersveiligheid. Dat bewijst dat er geen link is tussen het aantal en het type ongevallen in een land, en de toegelaten alcohollimiet.
Argumenten gebaseerd op oorzaak-gevolg
Deze argumenten verwijzen vanuit een oorzaak naar een gevolg, of vanuit een gevolg naar een oorzaak.
Roken is ongezond, want het veroorzaakt longkanker.
Argumenten gebaseerd op een voorbeeld
Je verdedigt je standpunt door een voorbeeld te geven.
Er zijn al strenge straffen voor rijden onder invloed, zoals een alcoholslot
1 Bekijk onderstaande argumenten.
a Bepaal per argument of het om een deugdelijk argument of een drogreden gaat.
b Vermeld ook telkens over welke soort het gaat.
c Geef bij een drogreden telkens aan waarom het volgens jou om een drogreden gaat.
Een kind kan zo’n beslissing niet nemen omdat het nog niet volwassen is.
Waarom vertrouwt niemand politici?
Alcohol in het verkeer blijft een probleem. In 2017 gebeurden er nog 4 210 ongevallen waarbij een chauffeur onder invloed betrokken was.
Een week na het krijgen van een griepvaccin werd hij ziek, je wordt dus ziek van het griepvaccin.
Het ministerie van Volksgezondheid raadt mensen die werken in de gezondheidssector aan om zich te laten vaccineren tegen griep.
Omdat te snel rijden een probleem blijft in Vlaanderen, zijn er volgend jaar vier extra trajectcontroles gepland.
deugdelijk argument drogreden reden
Een deugdelijk argument is een argument waarop niets aan te merken valt, een goed argument.
Een drogreden is een argument dat gebaseerd is op een foutieve redenering.
Drogredenen zijn argumenten die – in tegenstelling tot deugdelijke argumenten – gebaseerd zijn op een foute redenering. Hieronder vind je een overzicht van veelvoorkomende soorten drogredenen.
Overgeneralisatie
Een uitspraak die gedaan wordt met te weinig gegevens om deze te staven. Mijn zus werd ooit gebeten door een grote hond, dus alle grote honden bijten.
Foutief oorzakelijk verband
Twee opeenvolgende gebeurtenissen waartussen een foutief verband gelegd wordt. Hij ontmoette Valerie vorige week en gisteren beëindigde hij zijn relatie met Sofie. Hij heeft zijn relatie dus stopgezet omwille van Valerie.
Het is niet omdat hij Valerie heeft ontmoet dat zij aan de oorzaak ligt van zijn beslissing.
Aanval op de persoon
De spreker speelt op de man in plaats van op de bal. De tegenpartij wordt persoonlijk aangevallen. De enige reden waarom je een nultolerantie een goed idee vindt, is omdat je zelf geen leven hebt en je anderen daarvoor wilt laten boeten!
Valse autoriteit
Er wordt gebruikgemaakt van een autoriteit die geen deskundige is binnen het relevante domein. De voorwaarden om nu een lening aan te gaan zijn uiterst geschikt, dat zegt mijn tandarts.
Ontduiken bewijslast
Het argument wordt niet bewezen, er wordt enkel een beroep gedaan op vermeende ‘algemene kennis’.
Iedereen weet toch dat jongeren vaak dronken achter het stuur kruipen, daar twijfelt niemand aan.
Suggestieve vraag
In de vraag wordt het antwoord van de andere partij al gesuggereerd. U zult het toch wel jammer vinden dat we, sinds het Pietenpact, enkel nog maar roetpieten in de straten zien in december?
Cirkelredenering
Een drogreden waarbij het standpunt herhaald wordt als argument. Je mag niet onder invloed achter het stuur kruipen, want dan ben je een dronken bestuurder.
Valse vergelijking
Twee zaken worden voorgesteld als gelijkend op elkaar zonder rekening te houden met belangrijke verschillen.
Waarom zou de schermtijd van kinderen beperkt moeten worden? Er staat toch ook geen beperking op de tijd van het lezen van boeken of het spelen in een boomhut?
Je kent de kenmerken van dialect en standaardtaal 1
Je kent de kenmerken van tussentaal 2
Je weet welke taalvariëteit je wanneer moet gebruiken
Je bekijkt een fragment uit In de gloria
1 Uit welke provincie komt de man?
2 Waarom wordt de man ondertiteld?
3 In welke taal spreekt de voice-over in het derde fragment?

4 Waarom wordt de voice-over niet ondertiteld?
5 Welk belangrijk verschil tussen dialect en standaardtaal leer je uit dit fragment?
6 Hou je eigen taalgebruik eens onder de loep. Welke taal spreek jij thuis met je ouders: standaardtaal of een dialect?

Je leest nu een artikel van de website Taaladvies




Standaardtaal, tussentaal, dialect (taalkundige termen)
Een man die zijn achtertuin gaat omspitten, doet dat niet in een duur pak. Hij trekt een tuinbroek en rubberlaarzen aan. Als diezelfde man ‘s avonds een feestelijk diner bijwoont, draagt hij zijn beste pak. En voordat hij onder de wol kruipt, trekt hij een pyjama aan. Dat vinden we vanzelfsprekend: in verschillende situaties draagt een mens nu eenmaal verschillende kleren.
Ook als taalgebruiker gebruik je verschillende soorten Nederlands, ook wel taalvariëteiten genoemd. De situatie waarin je je bevindt, bepaalt mee welke soort taal je gebruikt, wilt gebruiken of zou moeten gebruiken. Als je geen standaardtaal spreekt, kun je bijvoorbeeld dialect spreken of informele Vlaamse omgangstaal, die ook wel tussentaal wordt genoemd. De grenzen tussen die soorten Nederlands zijn niet altijd even duidelijk: standaardtaal loopt over in tussentaal en tussentaal loopt over in dialect.
informeel: niet-zakelijk, voor de privésfeer, losse omgang

De standaardtaal is het Nederlands dat algemeen bruikbaar is in alle belangrijke sectoren van het openbare leven, zoals het bestuur, de rechtspraak, het onderwijs en de media. In formele, officiële of zakelijke situaties wordt standaardtaal gebruikt: een leraar die voor de klas staat, een werknemer die een presentatie geeft, een nieuwslezer die berichten voorleest. Standaardtaal wordt ook gebruikt in situaties waarin de sociale afstand tussen de sprekers vrij groot is, bijvoorbeeld bij het eerste contact met onbekenden. Tijdens een sollicitatiegesprek kiezen de meeste sollicitanten bijvoorbeeld spontaan voor standaardtaal. Ook in zakelijke teksten schrijven en lezen we standaardtaal: een brief van de bank, artikelen in kranten en tijdschriften. Standaardtaal wordt ook wel Algemeen Nederlands of AN genoemd. Vroeger had men het over Algemeen Beschaafd Nederlands of ABN.
Een dialect is een lokale vorm van het Nederlands. Omdat elk dialect zijn eigen specifieke en plaatsgebonden kenmerken heeft – zoals een typische uitspraak, woordenschat en zinsbouw – is het maar in een beperkt aantal situaties bruikbaar: in contacten met mensen uit de directe omgeving, bijvoorbeeld thuis of bij familie, en in contacten met mensen uit hetzelfde dorp of dezelfde streek. Steeds minder Vlamingen spreken een zuiver dialect.


standaardtaal
Heb je nog een kop koffie voor me?
tussentaal
Ebde nog een tas koffie voor mij?
dialect
Édde nog een zjat kaffe veu maai?

Tussentaal is zowel de nette taal van Vlaamse dialectsprekers die geen standaardtaal kunnen of willen spreken, als de losse taal van Vlaamse standaardtaalsprekers die in persoonlijkere of informelere situaties geen dialect kunnen of willen spreken. Het is een sterk Brabants-Antwerps gekleurde omgangstaal, die zowel kenmerken heeft van standaardtaal als van dialect. In tussentaal vallen bijvoorbeeld vaak eindmedeklinkers weg (iet’, altij’, goe’), worden lidwoorden en voornaamwoorden verbogen (ne jongen, zijnen auto) en komen verkleinvormen op -ke voor (potteke, bloemeke). Tussentaal is niet duidelijk af te bakenen: er zijn verschillen van streek tot streek, van gebruiker tot gebruiker, van situatie tot situatie. Veel Vlamingen gebruiken tussentaal, meestal in alledaagse informele situaties zoals thuis, in het café, bij vrienden of familie.
Een taalgebruiker maakt in elke situatie – soms bewust, maar heel vaak onbewust – de keuze om standaardtaal, dialect of tussentaal te gebruiken. Hij kiest de taal die volgens hem het meest op zijn plaats is of het best het doel dient. Zo kan een leerkracht met zijn ouders dialect spreken, met zijn leerlingen in de klas standaardtaal en met sommige collega’s in de lerarenkamer tussentaal. Een taalgebruiker past zijn taal dus voortdurend aan de situatie en de gesprekspartner aan: hoe persoonlijker of informeler de situatie wordt, hoe groter de kans dat hij elementen van tussentaal of dialect gebruikt. Als de situatie formeler is, zal hij (dichter) bij standaardtaal uitkomen.
Naar: www.vlaanderen.be/taaladvies




formeel: zakelijk, officieel de sociale afstand: mate waarin personen of groepen elkaar als vreemd ervaren of zich net verbonden voelen

7 In het artikel gaat het over drie verschillende taalvariëteiten: standaardtaal, tussentaal en dialect. Wat is een taalvariëteit?
8 Praat jij altijd en met iedereen op dezelfde manier? Geef een voorbeeld.
9 Geef de drie grootste verschillen tussen standaardtaal en dialect. Vul onderstaande tabel aan. standaardtaal dialect regio situatie ontvanger
1 Beoordeel de volgende situaties. Welke taalvariëteit zou je moeten spreken?
a Je solliciteert en praat met je toekomstige baas.
b Je praat met je medeleerlingen over het weekend.
c Je praat thuis met je ouders over hoe je dag was.
d Je vraagt de weg aan een onbekende op straat.
e Je discussieert met een vriend(in) over een tv-programma.
dialect standaardtaal
dialect standaardtaal
dialect standaardtaal
dialect standaardtaal
dialect standaardtaal
2 In het artikel spreekt men over tussentaal. Wat is dat? Markeer de juiste kenmerken.
regiogebonden
Antwerps-Brabants gekleurd
taal tussen standaardtaal en dialect
een dialect uit Antwerpen voor formele situaties voor informele situaties
heeft woorden met dialectische klanken
heeft woorden met klanken uit het AN
een mix van AN en dialect
Bekijk de onderstaande situaties.
de baas van een groot bedrijf die een sollicitant interviewt tijdens een sollicitatiegesprek

vrienden die op café samenkomen na een pittige voetbaltraining

iemand die op straat de weg vraagt aan een vreemde
twee bejaarden in het rusthuis die een gesprek voeren tijdens de wekelijkse activiteit

de burgemeester die met een gemeenteraadslid ideeën uitwisselt over een nieuw wetsvoorstel
3 Kies samen met een medeleerling een van bovenstaande situaties (of bedenk zelf een andere situatie). Verzin samen een scenario en ga met elkaar in dialoog. Opgelet: voor deze opdracht is het belangrijk dat je de verkeerde taalvariant gebruikt.

Je leest op p. 248 een fragment uit het artikel De dialecten gaan achteruit, gelukkig houdt de Atlas van het dialect in Vlaanderen ze bij
1 Hoe komt het dat dialecten verdwijnen? Geef twee redenen.
2 Bespreek met de klas: is het goed of slecht dat dialecten verdwijnen?

Niet meer te redden
De Tier denkt dat de echt oude dialecten zullen verdwijnen en dat de tussentaal in de plaats zal komen. Tussentaal is een taal die tussen het dialect en het Standaardnederlands in zit. ‘Het is een soort nieuw dialect.’ Dat komt omdat ouders de dialecten niet meer doorgeven aan hun kinderen. ‘Opvoeden in het dialect zou leuk zijn, maar ik vrees dat de jonge ouders nu niet meer de echte dialectsprekers zijn die het nog kunnen doorgeven.’
Niet meer met de paplepel doorgeven
‘De 50’ers en 60’ers kregen het dialect nog mee van hun ouders en die spreken het ook nog, maar ze werden mobieler, kwamen met verschillende dialecten in aanraking, trouwden met iemand die een heel ander dialect sprak en zo schakelden ze over op een gemeenschappelijke taal.’ Dat kon een tussentaal zijn, of het Standaardnederlands, legt de wetenschapster uit.
Psychologisch

Ze raakt ook een psychologisch aspect aan dat meespeelde in de achteruitgang van de dialecten. ‘Er was een tijd dat het niet goed was voor de carrière van je kinderen als je ze in het dialect zou opvoeden.’ ‘Dat klopt niet’, zegt ze. ‘Dialect is niet slecht voor je carrière. Het kan zelfs een verrijking zijn als je de standaardtaal spreekt én dialect. Je spreekt dan twee talen, maar je moet wel weten wanneer je wat spreekt.’ Op café onder vrienden of in je gezin past het dialect beter dan tijdens een speech op het werk.
Bron: www.vrt.be/vrtnws
Er zijn heel veel verschillende meningen over het gebruik van dialect, standaardtaal en tussentaal. Bekijk een fragment uit Volt en los de bijhorende vragen op.
Axel Daeseleire is een Belgische acteur. Hij speelde onder meer in de televisieseries Matroesjka’s en Flikken, en in de films Team Spirit en De Hel van Tanger. Hij maakte ook de documentaire Axel gaat binnen
Mia Doornaert is een journaliste. Ze schrijft geregeld voor De Standaard en is dikwijls te gast in De Afspraak op Canvas. Ze werd in voorzitter van het Vlaams Fonds voor de Letteren. Dat fonds beslist onder andere welke schrijvers er een werkbeurs krijgen.
3 Waarom is Axel Daeseleire vóór het gebruik van tussentaal in televisieseries?
4 Waarom is Mia Doornaert tégen het gebruik van tussentaal in televisieseries?

5 ‘Wat willen ze doen? De taal vastzetten in een bankschroef? Dan gaat ze dood, de taal.’ Wat bedoelt Daan Hugaert hiermee?
6 Wat is volgens Ruud Hendrickx het verschil tussen standaardtaal en stadhuistaal?
7 Vind jij het belangrijk dat je op school standaardtaal leert? Waarom wel/niet?
8 Welke mening deel jij? Waarom?
Axel Daeseleire: de geloofwaardigheid van een personage is belangrijker dan AN spreken op televisie.
Mia Doornaert: een personage zou altijd AN moeten spreken, ook dat kan geloofwaardig zijn.
9 Wat is het belangrijkste element voor een kind om taal te leren? Duid het juiste antwoord aan.
televisie/media
interactie
Wat is het verschil tussen Standaardnederlands en dialect?
Standaardnederlands is de officiële vorm van de Nederlandse taal. Die variant is vastgelegd in officiële woordenboeken en spellingsboeken en wordt gebruikt in zakelijke situaties.
Dialect is een lokale vorm van het Nederlands en is gebonden aan een specifieke plaats of regio. Elk dialect heeft zijn eigen typische uitspraak, woordenschat en zinsbouw. Het dialect gebruiken we alleen tijdens informele situaties.
Tussentaal zit tussen het Standaardnederlands en het dialect in. Het is een informele taal met haar eigen specifieke kenmerken. Deze taalvariant wordt vooral gebruikt door:
• Nederlandstalige dialectsprekers die de standaardtaal niet of slecht kunnen spreken;
• Nederlandstalige standaardtaalsprekers die in informele situaties geen of slecht dialect kunnen spreken.
Ook tussentaal varieert, net zoals dialecten, van streek tot streek.
Taal: onthoudwoorden
Het Nederlands heeft heel wat spellingregels. Ook de klanken van specifieke woorden kunnen je op weg helpen bij het spellen van een woord. Dat is echter niet altijd het geval. Woorden waarvan de spelling niet gebeurt op basis van spellingregels of letter-klankovereenkomsten, noemen we onthoudwoorden. Daarmee ga je in de volgende oefeningen aan de slag.
1 Vul de ontbrekende woorden in.
a We waren om na het eten van een te weten te komen dat deze zaak geen voeding ter meer mag aanbieden omwille van de gebrekkige
b De militair niet wanneer zijn niet openging. Hij opende zijn extra valscherm dat als diende bij problemen.
c De zat er naast toen bleek dat de niet zou bevallen van een zoon, maar van tweelingmeisjes.
d Het van de thuisploeg werd tijdens het wedstrijdje snel getemperd nadat de topspeler, die in het dagelijkse leven is, werd.
e De kende geen toen hij dat geen op zijn pleidooi zouden mogen geven.
2 Vul de ontbrekende letters aan.
a De j rnalist vroeg tijdens het interv w met de ju rouw van het zesde leerjaar waarom ze zo onpro e ioneel handelde bij het oteren van haar leerlingen.
b De de i u ie was groot toen bij de prem re bleek dat de a oestiek in de i e eeuwse a edraal ronduit slecht was. Toch wilde de dirigent het zangspe ta el per s laten doorgaan, terwijl de koorleden eerder onmi e ijk wilden ophouden.
c De anti r verkocht de mooie affiche van een ca ou el met een vals ertifi aat.
d De stag r stelde voor om bro o i op de barbe te leggen. Hij beweerde dat dit ve u elijk was.
e De politiepatro e leek in een sc ne van een spe ta ul re spiona efilm terechtgekomen toen ze de co i aris moesten schaduwen.
Gebruik woordenlijst.org om de spelling van (onthoud)woorden te raadplegen.
3 In de volgende zinnen staan in totaal vijftien fouten.
a Onderstreep de vijftien fouten en verbeter ze. Maak eventueel gebruik van woordenlijst.org
b Markeer bovendien alle woorden die een moeilijke spelling hebben.
1 In februarie werd de copiloot ontslagen nadat hij een exotische coctail dronk tijdens de vlucht met de nieuwe legerhelicopter.
2 De qualiteit van de koteletten in die traiteurzaak is erbarmerlijk, maar de mozarellakroket die erbij geserveerd werd, bleek een echte delicatesse.
3 Mischien is er wel sprake van sabotage aan de carrosserie van dat voertuig. Ik hoorde namelijk dat de ranquneuze mekanicien zijn ex-werkgever wilde treiteren.
4 Toen Fenna een paralellogram moest tekenen, wist ze niet precies wat ze moest doen. Ze tweifelde om de leerkracht in te lichten, want ze vond haar onkunde nogal genant.
5 Het was intressant om in de fabriek te kunnen aanschouwen hoe mayonnaise gemaakt werd. Nadien werden we getracteerd op frietjes en saus à volonté.
4 Wat is er hier afgebeeld? Gebruik de hints.









a zelfstandig naamwoord, meervoud:
b werkwoord:
c zelfstandig naamwoord, enkelvoud:
d zelfstandig naamwoord, enkelvoud:
e zelfstandig naamwoord, enkelvoud:
5 Bekijk het raster.
a Vorm de uitdrukkingen die erin verborgen zitten.
b Link de uitdrukkingen aan de juiste betekenis.
1 een appeltjea komt om zijn loontje
A Je doet je voor als een zwartkijker bij een overleg of discussie: je stelt kritische vragen en maakt opmerkingen vanuit een zo negatief mogelijk standpunt om een beeld te krijgen van wat er allemaal mis zou kunnen gaan.
2 je biezenb thuis bestB Je bent kwaad op iemand en wilt hem/haar op het matje roepen of met gelijke munt terugbetalen.
3 advocaat c in de doofpot stoppen
4 het bloedd van de duivel spelen
5 boontje e met iemand te schillen hebben
C Vluchten, ervandoor gaan; (ook) weggaan omdat je weggestuurd wordt.
D Iemands echte karakter verloochent zich niet; een oude voorkeur gaat nooit helemaal weg.
E Na een periode van tegenslag, komt er een betere tijd.
6 na regen f peren zitten F Iemand krijgt zijn verdiende straf; eigen schuld, dikke bult.
7 met de gebakken g op het droge hebben
G Waar je ook bent, thuis voel je je beter op je gemak.
8 oost west, h pakken H Je zit met de onaangename gevolgen van eerdere gebeurtenissen.
9 een zaak i kruipt waar het niet gaan kan
10 zijn schaapjes j komt zonneschijn
I Je hebt genoeg geld verdiend om rustig te kunnen leven en hoeft niet meer (hard) te werken.
J Opzettelijk niet meer over een zaak spreken, er geen verdere ruchtbaarheid aan geven.
123456789 10
De term uitdrukking is een algemene term die we gebruiken als verzamelnaam voor spreekwoorden en zegswijzen.
• Spreekwoorden kun je niet veranderen; ze hebben vaak het uitzicht van een volledige zin. Spreekwoorden zijn vaak kernachtig. De meeste spreekwoorden zijn wijsheden die van generatie op generatie worden doorgegeven. Soms verwijzen ze naar gewoontes of gebruiksvoorwerpen die we niet altijd meer kennen.
Waar rook is, is vuur.
Ieder huisje heeft zijn kruisje.
Vele handen maken licht werk.
• Zegswijzen kun je aanpassen; het zijn woordgroepen die je aan de situatie kunt aanpassen door een onderwerp te kiezen, het werkwoord te vervoegen of ze negatief te gebruiken.
In deze discussie hield zij het been stijf. (zegswijze: het been stijf houden)
1 De titel van het artikel dat je zo meteen leest, luidt: Daarom zijn alle coronatermen in het Engels.
a Op welke vraag krijgt de lezer een antwoord?
b Om welke tekstsoort gaat het hier, denk je?
informatieve tekst
prescriptieve tekst
persuasieve of beïnvloedende tekst narratieve of verhalende tekst
opiniërende of overtuigende tekst


2 Lees nu de tekst Daarom zijn alle coronatermen in het Engels.
Social distancing, lockdownparty, fl atten the curve, preteaching … De uitbraak van het coronavirus in ons land zorgde voor heel wat nieuwe termen en uitdrukkingen. Meestal gaat het om Engelstalige woorden. Hoe komt dat?
Elke dag worden we in het nieuws met verse, Engelse woorden rond de oren geslagen. Volgens VRT-taaladviseur Ruud Hendrickx zijn de termen vooral Engelstalig omdat het om een internationale verspreiding van het virus gaat. ‘De Wereldgezondheidsorganisatie (WHO) lanceert dan woorden als “social distancing” en hup, de hele wereld is vertrokken’, zegt hij bij VRT NWS
Anderhalvemeteren
Moeten we op zoek naar Nederlandse alternatieven? Hendrickx vindt dat alvast een goed idee. Meestal duurt het wel een tijdje voor we een vervangwoord vinden. ‘Kranten gebruiken al heel vaak “afstand houden”. Ik hoop dat we op termijn tot een overeenstemming komen over hoe we “social distancing” in het Nederlands gaan noemen’, zegt de expert. Zelf is hij fan van het woord “anderhalvemeteren”, dat hij in de krant las. ‘Het is wel wat lang, maar toont duidelijk waar het over gaat. Bij “social distancing” moet je anderhalve meter afstand houden.’ Voor “preteaching” bedacht VRT-journalist Chris De Nijs het Nederlandse “aanloopleren”. Het woord wordt gebruikt om te zeggen dat leerlingen nieuwe leerstof krijgen vanop afstand die later nog eens in de klas herhaald zal worden.
Bron: nl.metrotime.be

a Waarom zijn alle coronawoorden in het Engels?
b Wie lanceert deze termen?
c Wat valt er op als je naar Nederlandse alternatieven zoekt?
d Wat kan hier het gevolg van zijn, denk je?
e Waarom is de VRT-journalist fan van het woord ‘anderhalvemeteren’?
f Wat vind jij van de voorgestelde Nederlandstalige alternatieven?
De Belgische cartoonist Kamagurka gaat in een aflevering van Kama voorspelt aan de slag met enkele coronawoorden. Het is de bedoeling dat je probeert te raden welk woord hij getekend heeft.
3 Noteer hieronder de woorden in de eerste kolom.
4 Wat toont Kamagurka ons?
5 Wat valt er op in de berichtgeving van het coronanieuws?
6 Hoe denk je dat Kamagurka tegenover die nieuwe woordenschat staat? Motiveer je antwoord.
7 Welke taalfout heb je in het beeldfragment ontdekt?
8 Verdeel de woorden uit opdracht 3 in vier groepen. Gebruik voor elke groep een andere markeerkleur.
a woorden die ik nog nooit heb gehoord
b woorden die ik al gehoord heb, maar die ik niet begrijp
c woorden die ik begrijp als ik ze hoor/lees, maar zelf niet zou kunnen gebruiken
d woorden die ik begrijp en die ik zelf in een betekenisvolle zin zou kunnen gebruiken
9 Noteer in de tabel bij opdracht 3 nu ook de betekenis van de woorden. Gebruik de woordleerstrategieën (zie p. 82-83) om de betekenis te achterhalen.
Nooit eerder kon je zo snel informatie over een bepaald onderwerp vinden als in onze huidige maatschappij. Kennis over elk onderwerp is maar een klik van iedereen verwijderd.
1 Je leerkracht geeft je een onderwerp waarover je binnen een minuut informatie moet opzoeken. a Noteer die informatie hieronder.
b Vergelijk jouw antwoorden enerzijds met leerlingen die informatie opzochten over hetzelfde onderwerp en anderzijds met leerlingen die informatie opzochten over een ander onderwerp. Wat valt op?
2 We leven volop in het informatietijdperk. Zoek die term op en noteer aan de hand van vier kenmerken wat dit is.
De laatste vijftien jaar is er meer informatie gecreëerd dan in de volledige geschiedenis van de mensheid daarvoor.
3 Voor veel mensen vormt het een uitdaging om alle informatie die ze te verwerken krijgen overzichtelijk te houden en te structureren. Sommigen hebben zelfs te kampen met informatiestress of informatiemoeheid. Is dat iets waarin jij je herkent?
Vorig jaar leerde je de betrouwbaarheid en bruikbaarheid van een bron te beoordelen. In het volgende onderdeel ga je actief met die kennis aan de slag. We frissen even op hoe je dat kunt aanpakken.
Informatie ordenen en beoordelen
1 Het doel bepalen
Als je een algemeen beeld over een onderwerp wilt krijgen, zul je andere bronnen gebruiken dan wanneer je een literatuurstudie over datzelfde onderwerp wilt schrijven. Alvorens je naar informatie op zoek gaat, is het belangrijk om te weten met welk doel je die informatie verzamelt.
Doel: je wilt je voorbereiden op een schrijfopdracht over de gevaren van het gebruik van elektrische steps.
2 Het onderwerp verkennen
Noteer de kerninformatie over je onderwerp. Welke voorkennis heb je al? De topische vragen (wie, wat, waar, waarom, wanneer en hoe) kunnen je hierbij helpen.
Je gaat op zoek naar informatie over de gevaren van elektrische steps.
a Wat zijn elektrische steps?
b Welke voordelen zijn er verbonden aan elektrische steps?
c Welke nadelen zijn er verbonden aan elektrische steps?
3 Informatie beoordelen en selecteren
Je gaat op zoek naar bronnen die interessant kunnen zijn voor jouw gekozen onderwerp. Bekijk de bronnen aandachtig en beoordeel of de informatie betrouwbaar en bruikbaar is aan de hand van onderstaande tabel.
Je hebt drie interessante bronnen over elektrische steps gevonden en beoordeelt nu de bruikbaarheid en betrouwbaarheid van elke bron.
Bron 1 Elektrische step voortaan pas vanaf jaar: zie p.
Bron 2 Tien goede redenen om een e-step te kopen: zie iDiddit
Bron 3 Wankeler dan een fiets, maar hoe gevaarlijk zijn e-steps?: zie iDiddit
Betrouwbaarheid en bruikbaarheid van een bron beoordelen
Is het onderwerp van de bron hetzelfde als het onderwerp van mijn opdracht?
Welke instantie publiceerde de bron?
Wie is de zender (auteur/maker)?
• Is de zender een kenner op vlak van het onderwerp?
Is de bron objectief of subjectief ?
• Gebruikt de zender gekleurd taalgebruik?
• Gebruikt de zender voornamelijk feiten of meningen?
• Is de zender onpartijdig?
Is de informatie nog actueel?
• Is de bron niet verouderd?
• Is de informatie niet achterhaald?
ja nee
objectief subjectief
actueel
Bevat de bron verwijzingen naar andere bronnen?
• Zijn die verwijzingen relevant?
• Zijn die andere bronnen betrouwbaar?
Wat is het doel van de zender?
informeren
beïnvloeden, aanzetten om iets te doen
overtuigen, opiniëren
voorschrijven
vertellen, ontspannen, amuseren, ontroeren
Conclusie
De bron is betrouwbaar / onbetrouwbaar en bruikbaar / onbruikbaar voor mijn opdracht.
4 Informatie selecteren uit de bronnen
Je markeert alle bruikbare informatie voor je opdracht. Gebruik verschillende markeerkleuren.
a Je markeert de voordelen van elektrische steps in het blauw.
b Je markeert de nadelen van elektrische steps in het groen.
c Je markeert overige belangrijke en objectieve informatie in het geel.
4 Pas de theorie uit het Onthouden-kader toe op bron 1.
https://magazine.vab.be/op-weg/mobiliteit/nieuwe-regels-elektrische-step/

Door Johan Dillen - 16 maart 2022
De elektrische step is niet meer weg te denken uit de steden. Handiger dan de benenwagen, hip bij jongeren. Maar ook: hoe meer e-steps, hoe meer ongevallen. De politiek heeft daarom een reeks nieuwe maatregelen uitgewerkt. Zo moet de bestuurder minstens 16 zijn en mag de e-step niet langer op het trottoir rijden.
De elektrische step is een blijver, daarover heerst intussen een brede consensus. Vooral voor de ‘last mile’ kan hij belangrijk zijn: om van de randparking naar het centrum te reizen, om van het station naar de werkplek te pendelen of gewoon om van thuis naar school te sjezen. Jongeren vinden de elektrische step cool, een ouder publiek vindt hem vooral handig. Gemakkelijker mee te nemen in de auto of op de trein dan een elektrische fiets en een stuk sneller dan je te voet te verplaatsen.
Niet meer op de stoep
Daarnaast heeft de e-step nog meer voordelen: voor de meest courante modellen is in de praktijk geen bijkomende verzekering nodig, de klassieke familiale verzekering dekt de gebruiker indien de step begrensd is op 25 kilometer per uur. Dit geldt ook voor deelsteps. De verschillende mobiliteitsministers in ons land hebben net een akkoord bereikt dat het gebruik van de elektrische step verduidelijkt. Zo zal je minstens 16 jaar moeten zijn om met een e-step te rijden. Er is één uitzondering voorzien: kinderen mogen wel met een elektrische step rijden op de zeedijk en in speelstraten, omdat deze omgevingen veiliger zijn.
Verder mag de elektrische step niet langer op het voetpad rijden. De regel dat de e-step de snelheid van de voetgangers moest aanhouden, bleek in de praktijk niet na te leven. En dus verhuist de elektrische step definitief naar het fietspad. Of rechts op de rijweg indien er geen fietspad is. Op de openbare weg moet de e-step over verlichting beschikken: een wit of geel licht vooraan, een rood licht achteraan. Een helm is niet verplicht. Wie toch op het trottoir stept, riskeert een boete van 58 euro. Ook mag je niet met twee (of meer) op een e-step rijden.
Meer ongevallen met de step
‘We willen nieuwe mobiliteitsvormen zoals de e-step blijven stimuleren’, horen we bij het kabinet van federaal mobiliteitsminister George Gilkinet (Ecolo). Maar de stijging in de statistieken van het aantal ongevallen met elektrische steps was ook daar opgevallen. In 2020 stelde het Belgisch Instituut voor Verkeersveiligheid (VIAS) vast – vermoedelijk door het vele telewerk en de corona-lockdown – dat het aantal auto-ongevallen met gewonden 24 procent lager lag dan in 2019. Ook het aantal ongevallen met gewonde fietsers daalde: -3% bij de gewone fietsers, -2% bij de elektrische fietsen en -1% bij de speed pedelecs. Maar bij de ‘gemotoriseerde voortbewegingstoestellen’ waarbij de e-steps horen, waren in 2020 liefst 36 procent meer ongevallen met gewonden geregistreerd.
Bovendien gaat het vaker om zware verwondingen in vergelijking met fietsongevallen, zo laten verschillende artsen van spoeddiensten weten. De kleine wielen van de steps, het hoge zwaartepunt en het ontbreken van een valhelm vormen een verhoogd risico op zware letsels bij een ongeval. De stijging heeft zich in 2022 alleen maar doorgezet. Voor het eerst zijn in Vlaanderen meer dan duizend ongevallen met gewonden geregistreerd waarbij elektrische steps betrokken waren. Daarbij ook vier ongevallen met dodelijke afloop. De nieuwe maatregelen drongen zich dan ook op.
Daarnaast heeft de politiek een oplossing bedacht voor de wildgroei aan her en der gedumpte e-steps in het straatbeeld. Er komen parkeerzones voor steps en zones waar ze absoluut niet mogen worden achtergelaten. Daarnaast zullen er ook zones zijn waar e-steps mogen staan zonder de doorgang te belemmeren. Wie zijn elektrische step fout parkeert, kan een boete van 116 euro krijgen.
Bron: magazine.vab.be
5 Waarom is het correct verwijzen naar je bronnen belangrijk ?
Er zijn verschillende manieren om correct naar je bronnen te verwijzen. Een van deze manieren is de APA-methode; een set van referentieregels opgesteld door de American Psychological Association.
• Boeken
Familienaam auteur, initiaal voornaam auteur. (jaartal) Titel. Uitgeverij. De Vlieger, J. () Geen vogels voor de kat. Vollemans.
• Websites
Familienaam auteur, initiaal voornaam auteur. (jaartal, maand dag indien vermeld) Titel. webadres Mertens, H. () Boektoppers in het secundair onderwijs. http://www.vanin.be/boektopperssecundair
Je moet dus op heel wat details letten (cursieve titel, juiste leestekens, volgorde …). Gelukkig bestaan er hulpmiddelen om je bronnen correct te vermelden. Zo kun je op de website www.scribbr.nl de APA-generator gebruiken.
Maar ook via Word kun je volgens de APA-methode correct verwijzen naar je bronnen. Dat doe je als volgt:

1 Klik op Verwijzingen in het lint bovenaan de pagina.
2 Klik op Citaat invoegen en kies voor de optie Nieuwe bron toevoegen
3 Selecteer het type bron en geef alle gekende informatie over de bron in.
4 Klik vervolgens op OK
Een overzicht van alle opgeslagen bronnen kun je terugvinden onder Bronnen beheren
5 Selecteer bij Stijl de methode die je wilt gebruiken om de bronnen te vermelden, bv. de APA-methode.
6 Klik op Bibliografie en kies de opmaak die je wilt gebruiken.
Wil je later de bibliografie aanpassen omdat je nieuwe bronnen hebt toegevoegd? Klik met de rechtermuisknop op je bibliografie en kies Veld bijwerken
6 Geef bij volgende bronnen een correcte bronvermelding volgens de APA-methode.
https://www.vsv.be/pers/elektrische-steps-nieuwe-regels-vanaf-1-juli/

Bronvermelding:
Bronvermelding:



• Wil je in een tekst verwijzen naar een bron, vermeld dan de auteur(s) en datum van de bron: (De Tier, ). De volledige bronvermelding noteer je dan alfabetisch in je literatuurlijst achteraan.

• Zijn er meerdere auteurs? Vermeld dan de eerste keer alle auteurs en vermeld bij verdere verwijzingen de eerste auteur gevolgd door ‘et al’: (De Caluwe et al., )

• Als de datum van een bron niet gekend is vervang je de datum door ‘z.d.’, dit staat voor ‘zonder datum’.














De ene mop vind je grappig, de andere niet. Die ene stand-upcomedian brengt je ouders aan het lachen, maar vind jij misschien maar flauw. Dat is niet zo verwonderlijk. Smaken verschillen en er bestaan nu eenmaal heel wat vormen van humor.
1 Bekijk en bestudeer de cartoons op p. 261-264.
a Beantwoord per cartoon de bijhorende vragen.
b Vul daarna de correcte humorvorm bij de cartoon in.
cartoon humorvorm
1 • Zegt Hagar de Viking echt wat hij bedoelt?
• Zijn reactie op de vergadering is realistisch / overdreven / ingehouden.
2 • Wat maakt deze cartoon grappig: het beeld / de tekst?
• Leg de dubbele betekenis uit.
3 • Verwijst deze situatie naar een bestaand werk (boek, film …)?
4 • Zie je in deze cartoon een herkenbare situatie?
• Deze situatie is onmogelijk / realistisch / vreemd.
5 • Wat zegt de man indirect aan zijn vrouw?
• Hoe zal de vrouw reageren als ze hoort dat het een urne is, denk je?
6
• Wat is het onderwerp van deze cartoon?
• Mag je met dat onderwerp lachen?
7 • Wat is het onderwerp van deze cartoon?
• Mag je met dat onderwerp lachen?
8 • Verwijst deze situatie naar een bestaand werk (boek, film …)?
9 • Zie je in deze cartoon een herkenbare situatie?
• Deze situatie is onmogelijk / realistisch / vreemd.
10 • Met wie lacht de figuur in de cartoon?
• Wat bedoelt ze als ze zegt: ‘Wat ben ik toch lief’?
11 • Zijn Fokke en Sukke echt blij met de verdubbeling van de verkoop?
• Wat klagen ze aan? Waarmee lachen ze?
12 • Heeft de cartoonist een extra doel met deze cartoon, denk je? Welk?
• Hoe zou je deze cartoonist omschrijven?
vrolijk – kritisch – hilarisch – bitter – ontspannend – hard
13
• Wat zegt de man indirect aan zijn buurvrouw?
• Hoe zal de vrouw reageren, denk je?
14 • Wat of wie is het onderwerp van deze cartoon?
• Waarom wil hij een ander land?
15 • Heeft de cartoonist een extra doel met deze cartoon, denk je? Welk?
• Hoe zou je deze cartoonist omschrijven?
vrolijk – kritisch – hilarisch - bitter – ontspannend – hard
Humor
Een zender kan gebruikmaken van verschillende soorten humor. Meestal zijn die gebaseerd op iets onverwachts (een vreemde situatie of een grappige combinatie van gebeurtenissen) of op het contrast tussen wat er letterlijk staat en wat de zender bedoelt.
Als dat hier nog lang gaat duren, dan zal het hier rap gedaan zijn.
Ironie is een milde vorm van humor die niet kwetsend bedoeld is. De zender zegt het tegenovergestelde van wat hij bedoelt.
‘Wat ben jij vroeg vandaag!’ tegen iemand die ongelooflijk te laat komt.
Sarcasme
is bijtende spot. Sarcasme kan erg lijken op ironie, maar is directer en bitterder. Meestal neemt het de vorm aan van een grove, kwetsende formulering, maar sarcasme kan ook subtiel zijn. Mooie jurk, mama. Kleurt goed bij je spataderen.
Absurde humor
vertrekt van onrealistische ideeën. Soms worden die helemaal ‘tot in het absurde’ uitgewerkt. Wat is sneller: een fiets of een tram?
Een lantaarnpaal, want een kip legt ook eieren.
Cynisme
is de hardste vorm van spot. Wie cynische opmerkingen geeft, doet dat vaak uit ontgoocheling of wantrouwen tegen andere mensen en de maatschappij.
Trouwen is liegen dat je bij elkaar blijft.
Youp van ‘t Hek
Taalhumor
is een vorm van humor waarbij je een grappig effect bekomt door met taal te spelen. Dat kan door woordspelingen, dubbelzinnigheden, overdrijvingen … Tijdens de openhartoperatie zei de cardioloog plots: ‘Hier klopt iets niet’.
Een parodie
is een grappige nabootsing van een film, een lied, een verhaal, een tv-programma, een bekende figuur … Er worden typische kenmerken (taalgebruik, kledij, uiterlijke kenmerken) van het origineel geïmiteerd om een grappig effect te krijgen. Een parodie maakt vaak gebruik van overdrijvingen.
In het televisieprogramma Tegen de Sterren Op worden heel wat bekende Vlamingen geïmiteerd zoals Regi, K, Natalia en de personages uit FC De Kampioenen
Satire
is humor waarbij een publiek persoon (bv. een politicus) of een maatschappelijke (wan)toestand wordt bekritiseerd. Een satire kan verschillende soorten humor combineren, maar het is meestal duidelijk dat de kritiek op publieke personen of maatschappelijke toestand het belangrijkste is.
Op speld.nl verscheen volgende krantenkop:
Handig: stel kan van hun gasrekening hele winter de open haard aanhouden
Zwarte humor
bevat onderwerpen die in het dagelijkse leven tot de taboesfeer behoren.
Breek nooit iemands hart. Een mens heeft er maar één. Breek in plaats daarvan zijn botten. Een mens heeft er 206.
2 Misschien verbond je wel een andere humorvorm aan een bepaalde cartoon. Hoe komt dat, denk je?
3 Heb jij naast gevoel voor humor ook verstand van humor? Test je humorkennis samen met je medeleerlingen in het spel Grappen op trappen.

1 Lees de de nitie van stand-upcomedy en duid de belangrijkste kenmerken aan.
Stand-upcomedy is een humoristische theatervorm waarbij een comedian rechtstreeks een live publiek aanspreekt. Stand-upcomedy lijkt op een dialoog, maar is in feite een monoloog (eenrichtingsverkeer). Stand-upcomedians praten meestal over de maatschappij waarin ze leven en over hun eigen leven, al zijn de autobiografische verhalen vaak aangedikt met fictieve elementen. Vergeleken met cabaret zijn de theatrale elementen bij stand-upcomedy eerder beperkt. In een cabaretvoorstelling zit meer muziek (liedjes), dans en acteerwerk (typetjes …).
Bekende Vlaamse stand-upcomedians zijn onder andere Alex Agnew en Philippe Geubels. Els De Schepper en Urbanus zijn dan weer bekende cabaretiers.

Stand-upcomedy is meer dan alleen grappige teksten schrijven …
Je bekijkt een fragment uit de voorstelling Unfinished Business van Alex Agnew.
2 Vul de tabel in.
observatie Welke opvallende zaken zie je?
kledij
gezichtsuitdrukkingen
houding en gebaren
observatie Welke opvallende zaken hoor je?
geluiden van de acteur/ performer zelf
taalvariatie
3 Vergelijk jouw observatie met die van een medeleerling.
4 Zoek en beschrijf in volgende tabel de verschillende vormen van humor die Alex Agnew gebruikt.
ironie
sarcasme
cynisme
absurde humor
taboehumor
taalhumor
situationele humor
karakterhumor
1 Bekijk het fragment uit De klas met Philippe Geubels. Hoe gaat Philippe Geubels te werk om een mop te verzinnen?
2 Bekijk de fragmenten uit Loslopend wild en Wat als?. Welke humortechnieken uit het Tip-kader hieronder herken je?
Haal nu de stand-upcomedian in jezelf naar boven. Je krijgt een onderwerp toegewezen.
3 Brainstorm in groepjes over wat jullie positief en negatief vinden aan het onderwerp.
4 Nog inspiratie nodig? Bekijk het lmpje van comedian Serine Ayari. Waaruit haalt Serine inspiratie?
5 Probeer nu uit jullie brainstorm grappen te bedenken. Gebruik de humorsoorten en -technieken die je in deze les al zag: overdrijf, stel zaken minder erg voor, veralgemeen, maak absurde combinaties, boots bepaalde situaties na …
Deze veelvoorkomende technieken geven je tekst of voordracht de nodige humor.
• Gebruik stereotypen.
Mijn Nederlandse buurman is gierig. Onze blonde secretaresse is dom.
• Veralgemeen.
Alle vrouwen zijn koopverslaafd. Alle blanken zijn racistisch.
• Doorbreek sociale verwachtingen.
Mijn grootmoeder is verslaafd aan Fortnite. Onze slager is vegetariër.
• Bedenk vreemde combinaties.
Herman Brusselmans schreef een liefdesgedicht voor Queen Elisabeth. Ik ben dol op chips met confituur.
Je bekijkt een fragment uit De Klas
1 Welke vorm van taalhumor herken je in de mop van Nikam?
2* De mop van Dani over een Turk zorgt voor commotie.
a Kan die mop voor jou? Waarom wel/niet?
b Verzamel enkele argumenten voor en tegen die mop.
3* Grappen over mensen met een fysieke beperking plaatsen we onder de noemer taboehumor.
a Welke andere taboeonderwerpen zijn er nog volgens jou?
b Mag je met die onderwerpen lachen volgens jou?
Je leest nu het fragment Waarom er geen grens is aan grappenmakerij op de volgende pagina.
4 Markeer wat er over de grenzen van humor wordt gezegd.
5 Wat leert dit artikel ons over de grenzen van humor? Vat kort samen.
6 Welke andere factoren bepalen of er gelachen wordt met een mop?
7 Verklaar: ‘Bij de islam zijn grappenmakers vaak pragmatisch.’
8 Wat is vaak een groot misverstand bij humor?
* Het antwoord op deze vraag hoef je niet te noteren.
Waar liggen de grenzen van humor, vragen sommigen zich af. ‘Dat eeuwig zoeken naar die grenzen is zo absurd geworden dat mijn nieuwe show erover gaat’, reageert comedian Alex Agnew. Humoronderzoekers beamen: dé grenzen gaan we nooit vinden.
Hoe moet dat, humor beoefenen binnen de grenzen, en waar liggen die grenzen dan? De vraag moet zo oud zijn als de eerste mop. Professionals moeten er eens goed mee lachen. Want het heeft iets komisch: zoeken naar iets wat eigenlijk niet bestaat.
‘Humor zoekt grenzen op en doorbreekt ze. Dat is net de bedoeling’, zegt filosofe en communicatiewetenschapper Marlies Debrael (KU Leuven), die er onderzoek naar doet. ‘En wat die grenzen zijn, is voor iedereen anders. Net daarom vindt de ene de pruikengrap hilarisch en de andere wansmakelijk. Veel hangt af van wie de grap maakt en bij wie ze terechtkomt. Wel is het zo dat grappen die één individu viseren en die niet zijn bedoeld om een taboe te doorbreken maar vooral om uit te lachen, doorgaans veel meer tegen de borst stoten.’
Tussen serieus en satire
Ook Mark Boukes, assistent-professor communicatiewetenschappen (Universiteit van Amsterdam) en gespecialiseerd in humor, benadrukt hoe door slaggevend het is wie de grap maakt.
‘Comedians krijgen doorgaans alle ruimte om ver te gaan, politici, journalisten of gewoon medeburgers veel minder. Omdat de afspraak tussen comedians en het publiek is dat zij grappen maken en het niet per se menen, terwijl je dat bij de meeste andere mensen helemaal niet weet. Professionele grappenmaker Alex Agnew benadrukt daarnaast hoe zelfs grote taboeonderwerpen vlot naar binnen glijden als de grap maar heel goed is. ‘Als je maar grappig genoeg bent, kun je met alles lachen.’
Terminaal ziek
Hij geeft het voorbeeld van de grap die Geubels in zijn programma maakte over iemand die terminaal ziek is. De dokter zegt hem dat hij goed en slecht nieuws heeft en het goede nieuws is dat FC de
Kampioenen een derde film maken en hij die niet meer zal zien. ‘Je zou denken: lachen met terminaal zieken kan niet’, zegt Agnew. ‘Maar hier lach je niet met die zieke, maar met het gegeven dat zelfs dood zijn minder erg is dan die film te moeten zien. Humor is gelaagd en niet eenduidig, waardoor er geen regels vast te leggen zijn.’
Daarnaast is wat er leeft in de maatschappij door slaggevend. Begin twintigste eeuw werden moppen over seks niet en grappen over etnische verschillen wel aanvaard, nu is het omgekeerd, zo geeft Debrael aan. Boukes: ‘Uiteraard gaan comedians omzichtiger om met islam, omdat dat nu een thema is dat de maatschappij erg polariseert in politieke zin, wat je van transgenders niet kunt zeggen. De grappenmakers zijn daarbij ook pragmatisch. Het is niet omdat je met alles mag lachen dat dat ook moet. En iedereen weet dat grappen over de islam heel veel gedoe en risico’s kunnen opleveren.’
In veel hoofden zit niet alleen steeds meer veront waardiging, maar er broeien ook misverstanden. Marlies Debrael: ‘Het valt op dat mensen het onderscheid niet maken tussen een grap over iets maken, en het eens zijn met een stelling. Onderzoek toont duidelijk dat het niet is omdat je een seksistische of racistische grap maakt of ermee lacht, dat je een seksist of racist bent.’
Wie zich toch blijft afvragen of er geen paal en perk aan bepaalde grappenmakerij moet worden gesteld, staat volgens Agnew best stil bij het volgende: ‘De enige wereld waarin niemand ooit beledigd kan zijn door humor, is een totale dictatuur waar permanente censuur heerst, zelfs over bananenschillen.’
Bron: www.demorgen.be






eenduidig: ondubbelzinnig, duidelijk etnisch: wat een volk betreft polariseren: tegenstellingen vormen pragmatisch: gericht op feiten, praktisch ingesteld de dictatuur: bestuur door een alleenheerser met onbeperkte macht die een schrikbewind voert de censuur: boeken, films, programma’s … verbieden of delen eruit schrappen
Je vertelt hoe je een verhaal ervaart
Je bespreekt het effect van een (on)betrouwbare verteller
Je analyseert het gebruik van humor in een verhaal
Je reflecteert over het thema van het kortverhaal en je neemt in een discussie een standpunt in en beargumenteert je eigen mening (uitbreiding)
1 De titel van het kortverhaal dat je straks leest, is Familiaal bezoek.
a Welke associaties roept een familiebezoek bij je op?
b Noteer een vijftal kernwoorden en vergelijk nadien met een medeleerling.

2 Voorspel wat er in het verhaal zal gebeuren. Denk daarbij aan volgende vragen:
a Wie is het hoofdpersonage (leeftijd, geslacht, karakter)?
b Welke gebeurtenis staat centraal?
c Wie vertelt het verhaal? Hoe vertelt die het verhaal?
d Wat is de overheersende sfeer of het belangrijkste gevoel in het verhaal?
3 Vergelijk jouw voorspelling met die van een medeleerling.
Christophe Vekeman (Temse, december ) schrijft romans, poëzie, essays, columns en af en toe een theatertekst. Hij is ook een performer op literaire evenementen als Saint-Amour en De Nachten. Hij werkt ook geregeld mee aan boekenprogramma’s op de radiozender Klara. Hij is een liefhebber van countrymuziek en schreef een biografie van de beruchte Johny Paycheck.
Het kortverhaal wordt in verschillende stukken verteld. Na elk deel beantwoord je een aantal vragen.
Familiaal bezoek
Inleiding

1
Op een dag – dat zul je immers altijd zien – sloeg pardoes het noodlot toe. Mijn wagen gaf de geest, mijn hond ging dood, mijn vrouw verliet me voor een man die voetbal speelde, maar vooral toch gaf diezelfde dag mijn moeder telefonisch te kennen dat ze nog eens op bezoek wilde komen.
1 Op welke manier doorbreken de eerste zinnen al meteen het verwachtingspatroon van de lezer? Vergelijk je antwoord met de associaties en voorspellingen die je maakte in de inleidende opdrachten.
2* Welke wending zal het verhaal nemen volgens jou? Waarom denk je dat?
Lees nu deel 1 van het verhaal op p. 276.
3 Typeer in een aantal kernwoorden het gedrag en karakter van de vader en moeder.
4 Hoe zou je de relatie tussen de zoon en zijn ouders kunnen omschrijven? Geef telkens een voorbeeld om dit concreet te maken.
5 Welke gevoelens heb jij tegenover de verteller? Leg ook kort uit waarom je daarvoor hebt gekozen. Kies uit: sympathie (je voelt met hem mee) – apathie (laat je onverschillig) – antipathie (wekt tegenzin op).
* Het antwoord op deze vraag hoef je niet te noteren.
'Hoe bedoel je,' vroeg ik, 'op bezoek?' 'Ja, gewoon,' zei ze, 'gezellig.'
'O, sorry,' zei ik, 'ik had verstaan dat je nog eens op bezoek wilde komen.'
Twee dagen later al was het zover. Fel vermagerd deed ik open. Mijn vader was er ook bij, zag ik.
'Dag vader', sprak ik hartelijk. 'Is Linda thuis?' vroeg hij.
'Nee,' moest ik spijtig bekennen, 'Linda heeft mij helaas daarnet verlaten voor een man die voetbal speelt.'
'Dat kind was veel te mooi voor jou', riep mijn moeder over haar schouder, boven het geluid van de stofzuiger uit.



'Die Linda was een lekker ding, jongen', knikte mijn vader van tussen zijn tanden. Hij bracht zijn handen op zowat een halve meter van zijn borst en maakte er langdurig knedende bewegingen mee, terwijl hij mij grinnikend de ene knipoog na de andere bleef geven. Ik sloot de deur en liet mijn vader de woonkamer in, waar mijn moeder ondertussen bezig was de ramen te wassen.
'Zo', zei ik. 'Willen jullie misschien een kopje koffie of zoiets?'
'Ik denk er niet aan', zei mijn moeder. 'Hou dat smerige bocht maar voor jezelf.'
'Is Linda thuis?' vroeg mijn vader.


'Nee,' bracht ik hem andermaal op de hoogte, 'Linda, die heeft mij in de steek gelaten.'
'Mijn eigen zoon', concludeerde mijn vader. 'Mijn eigen zoon blijkt impotent te zijn. Mocht een mens het allemaal op voorhand weten ...' Nog even, zo leek het warempel, en hij zou verteerd door schrille wroeging in een hevig snikken uitbarsten. Mijn moeder, verfrol in de hand, want zij was inmiddels bezig het plafond te witten, bleek het ook te merken.
'Kijk eens hoe je je vader weer teleurstelt', zei ze. 'Zou je niet als de wiedeweerga een kop koffie zetten voor die man? En ga je haar kammen. Waarom draag je trouwens altijd van die afschuwelijke kleren?
Een hond heeft meer stijl dan jij. Over honden gesproken, waar zit dat mormel van je?'
Stil deelde ik haar mede dat mijn trouwe vriend pas was overleden. Haar gezicht klaarde op.
'Heb je nog meer goed nieuws?' vroeg ze.
'Nee', antwoordde ik. 'Bovendien zit ik sinds kort zonder auto.’

Mijn moeder, echter, hoorde dit niet meer, daar zij zich in de tuin achter de grasmaaier bevond.
Ik schonk mijn vader een kop koffie uit.
'Vroeger deed Linda dat', merkte hij op.
'Ja,' zei ik, 'dat kan kloppen, maar Linda, kijk, die is dus weg.'
'Die is weg', mijmerde hij. 'Ze had nochtans erg goeie benen. Goeie kont ook. Heel goeie kont zelfs. Zwijg er mij van. Heb je geen Playboy in huis of zoiets?'
Op dat moment kwam mijn moeder weer binnen. 'Oeps, is het al zo laat, zeg?' deed ze. 'Dan hebben wij zeker onze laatste trein gemist.'
'Moeder, het is vier uur 's middags', wees ik haar terecht.
'Op gezelligheid staat geen tijd, jongen', protesteerde ze luid. 'Er zit niets anders op dan hier te blijven slapen. En trek niet zo'n gezicht, je bent van jezelf al lelijk genoeg.' De nacht was lang, de nacht was zwaar, vooral omdat mijn vader, blijkbaar in de hoop dat Linda ondertussen alsnog zou zijn teruggekeerd, voortdurend deed alsof hij aan het slaapwandelen was en almaar, om de haverklap, met de douchedeur in huis bleef vallen, waarbij hij telkens luidkeels 'Oeps!' en 'Duizendmaal excuus, schoonheid!' uitbracht. Maar alles gaat voorbij, gelukkig, en nadat ze nog gauw even de stoep had opgeblonken, vond mijn moeder het 's ochtends eindelijk tijd om te vertrekken. 'Tot over een paar maanden maar weer eens', wuifde ze mij ten afscheid toe.
'Ja, we zien wel', deed ik nonchalant. 'Altijd welkom, hè, dat weet je.' Het ligt achter de rug, dacht ik, het ligt achter de rug! Laten wij het leven vieren, laat ons pret maken à volonté! Ik sloot de deur en dook mijn kelder in, waaruit ik even later weer tevoorschijn kwam met in mijn handen een bourgogne die eigenlijk te duur was om te worden opgedronken. Joelend, juichend en jubelend – ik stelde mij echt aan als een idioot, moet ik bekennen – opende ik de fles, die ik vervolgens op de vloer plaatste om haar daar te laten fungeren als het middelpunt van een met diep gekromde rug en hoge knieën uitgevoerde rondedans, tijdens welke ik zeker niet naliet mijn vlakke hand met regelmaat tegen mijn luidruchtige getuite lippen terecht te laten komen. Het is voorbij, bleef ik inmiddels in gedachten herhalen, het ligt achter de rug, het behoort alweer voor heel erg lange tijd tot het verleden! Dat alles duurde ongeveer twintig minuten. Toen zag ik dat mijn moeder haar handtas had vergeten.
Een paar dagen later kwam mijn zus op bezoek. Mijn zus is vier jaar ouder dan ik en heeft in haar leven tot nog toe nooit ook maar de geringste tegenslag gehad, met als gevolg dat zij een vat vol zelfmedelijden is. Nu vertelde ze me dat haar echtgenoot bijzonder zwaar verkouden was. 'Dat moet mij weer overkomen', zei ze.
'Hoezo?' vroeg ik.
'Ik kan niet tegen dat gesnuf de hele tijd', zei ze. 'Hij loopt de hele tijd te snuffen en daar word ik hoorndol van. Vreselijk vind ik dat. Ik zei het hem daarnet nog: "Als ik een natte neus aantrekkelijk zou vinden, schat, dan was ik toentertijd wel met een hond getrouwd, hoor. Denk je zelf ook niet?"'
'Over honden gesproken,' deelde ik haar mee, 'mijn trouwe, beste vriend is helaas zopas overleden.'
Mijn zus begon zachtjes te huilen. 'Waarom zég je zulke dingen toch tegen mij!' verweet ze mij in tranen. 'Je wéét toch dat ik daar niet tegen kan! O God, hier zal ik weer minstens twee weken niet goed van zijn! Waarom moet je mij dat nu vertellen? Soms ben je toch zo'n egoïst …'
'Sorry, het spijt me werkelijk, Sarah', zei ik. 'Hoe kan ik het goedmaken? Was Linda hier nu maar om je te troosten!' Thans gingen bij mijn zus terstond alle sluizen wijd open staan. Nog even, leek het, en ze zou in haar broek zitten pissen van louter ellende en plaatsvervangend verdriet. 'Zeg dat het niet waar is!' schreide ze. 'Zeg niet dat Linda bij je weg is!'
'Nee, nee, nee, nee, nee,' wuifde ik wild, 'nee, geen denken aan. Linda bij me weg? Linda, die krijg je met geen stokken bij me vandaan, hoor, als je dat maar weet. Tussen Linda en mij, dat is geen liefde, nee, dat is je reinste lijm. Nee, geen paniek, hoor.'
'Waar is ze dan naartoe?'
'Even naar de garage', zei ik. 'Klein onderhoudje. Niets aan de hand.'
'Tja,' snibde mijn zuster, gelukkig weer enigszins gekalmeerd, 'daar zijn wij vrouwen goed voor, hè, om de wagen van mijnheer naar de garage te brengen. En om zijn zakdoeken te wassen, natuurlijk. Mij hoef je niets te vertellen. Wij vrouwen zijn altijd en overal het slachtoffer. Is altijd zo geweest en zal altijd zo blijven. De enige gelukkige vrouwen op deze wereld zijn de masochistes.'
'Sarah, overdrijf je nu niet een klein beetje?' waagde ik het te vragen.
'Nee,' sprak mijn zus beslist, 'ik overdrijf namelijk nooit. Ik heb nog nooit in heel mijn leven overdreven, zelfs geen fractie van een beetje en daar dan nog eens de driedubbele vierkantswortel van, en ik zal het ook nooit ofte nimmer doen, overdrijven, in geen vijfhonderdduizendmiljoenmiljard jaar. Ik ben de minst overdrijvende mens die er ooit heeft bestaan. Achter het lemma “overdrijven” in Van Dale zouden ze gerust als definitie kunnen zetten: "dat waar Sarah Vekeman zich hoe dan ook nooit maar dan ook echt nóóit aan bezondigt".'
'Oké', zei ik. 'Oké, al goed.'





'Christus,' riep mijn zuster hierop plotseling uit, en ze gebruikte haar beide handen om de halsrand van haar pull ver van haar keel vandaan te trekken, 'wat is het hier warm, zeg! Het is hier binnen zeker honderdtachtig graden. Straks beland ik nog in een coma!'
Ik kwam overeind van mijn stoel om de thermostaat, die op negentien graden stond, lager te zetten, maar mijn zus gebaarde hevig dat ik weer moest gaan zitten. 'Laat dat nu toch', zei ze. 'Als jij het behaaglijk vindt zo, dan is het toch goed? Ik offer mij wel op, hoor, dat ben ik gewoon. Hou vooral geen rekening met mij: straks word ik het nog gewend, stel je voor, en dan zit ik ermee.'
Maar toen de telefoon ging, stond ik toch op en liep naar de aanpalende kamer, waar ik mijn schoonbroer aan de lijn kreeg.
'Sarah is haar mobieltje weer vergeten, maar ik denk dat ze bij jou is, klopt dat?' wilde hij weten. 'Inderdaad,' zei ik, 'hoe gaat het voorts met je verkoudheid, Bart?'

'Ik ben helemaal niet verkouden,' zei hij, 'ik heb gistermiddag welgeteld één keer mijn neus moeten snuiten.'
Ik riep mijn zus erbij en gunde haar haar privacy. Toen zij een weinig later weer bij me kwam zitten, had ik een sigaretje opgestoken.
'Stop daar toch eens mee,' zei ze, 'straks ben je dood, en ik heb een hekel aan begrafenissen.'
'En? Wat had Bart nog te zeggen?' vroeg ik.
'Helemaal niets', zei mijn zus. 'Ik ben namelijk getrouwd, weet je wel, met een man die weliswaar een slordige 20 000 euro per maand binnenrijft, weergaloos goed is in bed, de monogamie hemelshoog in het vaandel draagt, elke dag vier boeketten rode rozen voor me koopt en bovendien niet te beroerd is om zelf zijn wagen naar de garage te brengen, maar helaas geen bál te zeggen heeft. De minst interessante man van de wereld. En dat is dan nota bene een professor in de filosofie die in zijn vrije tijd boeken schrijft over het ontstaan van de mensheid.
Ik vraag mij af waar ik het aan heb verdiend. Het is mijn eigen schuld, natuurlijk: ik had nooit "ja" moeten zeggen, daar in dat vijfsterrenhotel op Hawaï. Enfin, genoeg nu over mij. Hoe gaat het tegenwoordig nog met je hond?'
'Ja, die is dood,' zei ik, 'dat vertelde ik toch?'
'O ja, natuurlijk', zei ze. 'De mijne ook', voegde zij er treurig aan toe.
'Sarah,' zei ik, 'je hebt nooit een hond gehad.'
'Ja, dat komt dan toch op hetzelfde neer?' vroeg ze.

Nadat mijn zus was vertrokken, bleef ik alleen achter in de stilte van de eenzaamheid. Ik miste mijn vrouw, ik miste mijn hond en mijn wagen, en ik wist niet hoe het verder moest en of ik er ooit nog bovenop zou komen. Ach, kop op, het kan altijd nog erger, bedacht ik in een poging om mezelf te troosten. En ja hoor, meteen hierna ging eensklaps de bel en stond mijn broer voor de deur.
Je leest nu deel 2 van het verhaal op p. 277-278.

6 Typeer in een aantal tre ende kernwoorden het gedrag en karakter van de zus van de verteller.
7 Wat zou je kunnen besluiten als je de naam van de zus linkt aan die van de schrijver van het kortverhaal?

8 Welk gevoel roept het verhaal tot nu toe bij je op? Geef aan waarom je dat vindt. Dat doe je met een argument of een voorbeeld.
fascinerend afstandelijk emotieloos absurd wreed levensecht grappig zielig raadselachtig ongemakkelijk meelijwekkend onwerkelijk
9 Wat gaat er volgens jou gebeuren in het allerlaatste deel van het verhaal? Waarom denk je dat?
Hierna bezocht ik zelf iemand. Ze zei dat mensen zoals mijn zus, mijn broer, mijn moeder en mijn vader in de beste families voorkwamen.
‘Ja goed, dat kon dan wel zo zijn,’ antwoordde ik, 'maar aan mijn ooms en tantes scheelt óók van alles, hoor! Niet dat zij in gelijke mate gek, krankjorum, waanzinnig en van de ratten besnuffeld zijn als hun tientallen zonen en dochters, maar toch, wanneer zij over straat lopen, bijvoorbeeld, dan kijken alleen de blinden hen niet na. Nog gezwegen over mijn grootouders, uiteraard.'
'Wat is er met je grootouders?' wilde de therapeute weten. 'Het punt is,' negeerde ik haar, 'wat zegt dat allemaal over mij? Als mijn hele familie, van de eerste tot de laatste, zacht uitgedrukt aan een bepaalde vorm van geestesziekte lijdt, hoe kan ik er dan zeker van zijn dat ikzelf een uitzondering en bijgevolg wél normaal ben? God weet, ben ik net als zij, maar besef ik het gewoonweg niet!'
'Ach,' deed de therapeute schouderophalend, 'gek, niet gek, normaal of krankzinnig: wat is tenslotte het verschil? Is dat niet allemaal bijzonder relatief, mevrouw?'
'Mevrouw?' zei ik. 'Ik ben helemaal geen vrouw, ik ben een mán!'
De therapeute stond op. 'Jaha,' lachte zij kakelend, terwijl ze een radslag maakte, 'dat zeggen ze allemaal, natuurlijk!' Terneergeslagen en ten prooi aan hevige vertwijfeling verliet ik het vertrek en ging naar buiten. Het was kwart over zesendertig. De wereld lag als een dweil aan mijn voeten. Thuis bleek Linda boterkoeken te hebben gebakken.
Lees nu ten slotte hierboven deel 3 van Familiaal bezoek
10 Vergelijk wat je nu bij het verhaal voelt met wat je in opdracht 8 hebt geantwoord.
a Blijf je bij de gevoelens uit die opdracht?
b Heb je nu andere gevoelens?
c Welke gebeurtenissen hebben je ervaring bijgestuurd?
11* Stel dat de schrijver het allerlaatste deel niet had opgenomen. Was het verhaal dan geloofwaardiger geweest? Beargumenteer je antwoord.



12 Welke boodschap of diepere betekenis zou de schrijver van dit kortverhaal willen meegeven aan de lezer?
a Duid maximaal twee antwoorden aan.
b Vergelijk je antwoorden met die van je medeleerling(en) en beargumenteer waarom je daarvoor koos.
De schrijver wil met dit kortverhaal …
de lezer laten reflecteren over familiebanden; zijn visie op de medemens duidelijk maken: af en toe vertederend, maar meestal ridicuul; aantonen dat elke mens redenen heeft om zich eenzaam en ongelukkig te voelen; laten zien dat iedereen in zijn eigen wereld en realiteit leeft, waardoor mensen naast elkaar leven.
Christophe Vekeman staat erom gekend om veel humor te hanteren in zijn verhalen en boeken.
1 Hoe sta jij tegenover humor in literatuur?
Er kan wat mij betreft niet vaak genoeg gelachen worden!
Hoe platter, hoe beter.
Zo nu en dan een grap stel ik op prijs, maar een serieus boek waardeer ik meer.
Dat hoeft echt niet voor mij, humor en literatuur gaan niet samen.
2* Heeft dit kortverhaal je doen (glim)lachen? Waarom wel of niet?
3 Vooral de groteske overdrijvingen vallen in dit kortverhaal op.
a Hoe worden dergelijke stijlfiguren nog genoemd?
b Geef hiervan drie voorbeelden.
4 In dit kortverhaal vind je verschillende voorbeelden van bijtende en bittere spot terug. Het onderscheid tussen sarcasme en cynisme is wel niet altijd even makkelijk te maken en hangt soms nauw samen met het subjectieve gevoel van de lezer. Daarnaast hanteert de auteur ook absurde humor. Geef voor elk van die stijl guren een voorbeeld uit het verhaal en verantwoord je keuze.
5* Kon je je makkelijk identi ceren met de verteller van dit verhaal? Waarom wel of niet?
6 De vertellers in de verhalen en boeken van Christophe Vekeman zijn vaak onbetrouwbaar.
a Is dat ook zo in dit kortverhaal?
b Welk beeld van de verteller wordt op die manier gecreëerd?
c Wat is het effect van een dergelijke verteller op de lezer?
d* Hoe ervaar jij als lezer een verhaal als de verteller de verwachtingen op een bepaald moment volledig doorbreekt?
Op p. vind je meer informatie over het vertelperspectief van een verhaal.
Op het einde van het kortverhaal zegt de therapeute: ‘Gek, niet gek, normaal of krankzinnig: wat is tenslotte het verschil?’ Hieronder vind je een aantal citaten die verband houden met die uitspraak.
© Penta Springs / Alamy
1
Wie geheel normaal is, werpe de eerste steen. Ik buk wel.
© Colin McPherson / Alamy
3
De enige mensen die ons normaal lijken, zijn die mensen die we nog niet zo goed kennen.
Alain de Botton (Britse schrijver en filosoof, 1969)

© Classic Image / Alamy
5 Kom hier, en ik zal u tonen dat gij gek zijt.
Horatius (Romeinse dichter, 65-8 v.Chr.)


2
En er lopen altijd wel duizend identieke burgers over straat om elkaar de indruk te geven dat ze normaal zijn en om mij aan geboortebeperking te doen denken.
Herman de Coninck (Vlaamse dichter, 1944-1997)



4
Het enige verschil tussen mij en een gek is dat ik niet gek ben.
Salvador Dalí (Spaanse kunstenaar, 1904-1989)

/ Alamy





6
Iedereen is gek geworden en vindt alles maar normaal.
Youp van ’t Hek (Nederlandse cabaretier en columnist, 1954)
1 Lees de uitspraken op de vorige pagina.
a Denk na over de betekenis van elk citaat.
b Leg een verband tussen het citaat en het kortverhaal Familiaal bezoek
c Rangschik de uitspraken van minst mee eens tot meest mee eens.
2 Vergelijk je rangschikking met die van twee medeleerlingen.
a Beargumenteer waarom je voor die ordening koos.
b Ga in discussie met elkaar. Hou daarbij rekening met volgende spelregels.
Spelregels discussie
• Luister goed naar de mening en argumenten van anderen.
• Geef altijd duidelijk aan waarom je het eens of oneens bent met iemand.
• Val nooit iemand persoonlijk aan, blijf neutraal en schreeuw niet. Een aanvallende houding verraadt meestal dat mensen inhoudelijk weinig te bieden hebben.
Om je medeleerlingen te overtuigen, kan het interessant zijn om te wijzen op de mogelijke gevolgen van hun mening. Probeer aan te tonen waarom hun argument weerlegd kan worden.
3 Beoordeel nu je eigen deelname aan de discussie.
Ik luister naar de mening van anderen.
Ik laat anderen uitspreken.
Ik stel vragen wanneer iets me niet duidelijk is.
Ik stel me open en niet aanvallend op.
Ik onderbouw wat ik zeg met argumenten.
Ik geef duidelijk aan waarom ik het (on)eens ben met anderen.
4 Beoordeel een medeleerling op zijn/haar deelname aan de discussie. Formuleer één sterk punt en één suggestie.
beoordeling: sterk punt suggestie



Johnny Paycheck (1938-2003), ontegenzeggelijk een van de prominentste en talentrijkste ‘outlaws’ uit de geschiedenis van de countrymuziek, leidde een bestaan van excessen, duisternis, geweld, toestanden en hoogtepunten die enkel leken te worden bereikt om vervolgens des te dieper te kunnen vallen. Toch is zijn leven nooit vastgelegd, wat Christophe Vekeman op het idee bracht om dan maar zelf de biografie van Paycheck te schrijven, een ‘klassieke biografie’. Het liep anders. Johnny Paycheck werd wel degelijk een biografie, maar dan een uiterst persoonlijke, doordrenkt van uitzinnige Vekemansiaanse wendingen en gedachtesprongen. Bron: www.standaardboekhandel.be


Het zeventiende boek van Christophe Vekeman is niets minder dan de eerste musical in de geschiedenis van de wereldliteratuur. Carwash vertelt het verhaal van twee jonge geliefden die in een kleine truck een grote lading jeans naar ’t verre Bullet moeten brengen. Of is het toch iets anders dat zij vervoeren? Wie zal het zeggen? Eén ding staat vast: Carwash is een buitengewoon meeslepend boek dat onweerstaanbaar inviteert tot meeleven, lachen en zelfs meezingen. Een zonovergoten verhaal dat je zult verslinden, handenwrijvend en breed grijnzend, met eenzelfde zorgeloze gretigheid als waarmee je vroeger naar je favoriete jeugdserie op tv keek. Bron: www.singeluitgeverijen.nl
Eindelijk heeft Christophe Vekeman de pen aan de wilgen gehangen: hij zal geen boeken meer schrijven. Gevolg is wel dat hij zich nu een plaats op de arbeidsmarkt en in ‘het échte leven’ dient te verwerven, wat voor een ouder wordende zonderling als hij niet zeer evident is.




Om zich te bezinnen over zijn toekomst, beslist hij af te reizen naar het Noord-Nederlandse stadje L., waar hij voor de geplande duur van zeventien dagen in het aftandse Hotel Rozenstok intrekt. Van dan af lijkt de grens tussen zijn fantasie en de werkelijkheid alsmaar meer te vervagen. Of is ook dát maar schijn?
Hotel Rozenstok is een grandioze afrekening met de realiteit en de wereld, en een uitzonderlijk geestige, spannende ode aan de liefde en de verbeelding. Christophe Vekeman (1972) spaart niemand in dit boek, niet zichzelf, en niet de rest van de mensheid. Enkel Wanda. Bron: www.singeluitgeverijen.nl

Je kunt de kenmerken van een goede samenvatting afleiden aan de hand van een voorbeeld
Je kunt een samenvatting schrijven over een schriftelijke bron
Je kunt gekregen feedback verwerken in een definitieve versie
Afhankelijk van het doel van je samenvatting, kun je kiezen voor een erg beknopte of een erg gedetailleerde variant.
1 Plaats onderstaande situaties op het continuüm. Plaats uiterst links de situatie waarvoor je een zeer beknopte samenvatting zou gebruiken en uiterst rechts de situatie waarvoor je een zeer gedetailleerde samenvatting zou gebruiken.

a Ik wil een samenvatting maken om mijn examen van geschiedenis grondig voor te bereiden.
b Ik moet een presentatie geven en wil een duidelijk overzicht van de structuur zodat ik weet welke onderdelen ik in welke volgorde moet bespreken.
c Ik wil enkele ideeën uit een ander onderzoek integreren in mijn eigen presentatie.
d Ik wil een verslag schrijven over een theatervoorstelling waarin ik zowel achtergrondinformatie als mijn eigen bevindingen wil verwerken.
e Ik wil een boek samenvatten voor een literatuuropdracht.
2 Vergelijk met een medeleerling. Maakten jullie dezelfde keuzes? Beargumenteer waarom je die keuzes hebt gemaakt.
1 Lees op p. 287-288 de tekst Nog werk aan begrijpelijke overheidsteksten.
2 Op p. 288-289 vind je drie samenvattingen van die tekst. Welke samenvatting vind jij de beste? Motiveer.
De samenvatting is niet te kort of te lang.
De samenvatting vermeldt alle relevante informatie.
De samenvatting is ook duidelijk voor iemand die de originele tekst niet gelezen heeft.
De inhoudelijke verbanden zijn duidelijk.
De samenvatting is goed gestructureerd.
De samenvatting bevat geen taalfouten.
De samenvatting bevat geen subjectieve elementen.
De samenvatting is te kort of te lang.
De samenvatting vermeldt niet alle relevante informatie.
De samenvatting vermeldt te veel irrelevante informatie.
De samenvatting is niet duidelijk voor iemand die de originele tekst niet gelezen heeft.
De inhoudelijke verbanden zijn niet duidelijk.
De samenvatting is slecht gestructureerd.
De samenvatting bevat taalfouten.
De samenvatting bevat subjectieve elementen.
Dit vind ik de beste samenvatting:
omdat:
Overheidsinstanties sturen nog steeds moeilijke teksten aan mensen met schuldproblemen. De taal is in 62% van de gevallen moeilijk te begrijpen voor laagopgeleide lezers. Ook is het lang niet altijd duidelijk wat de lezer moet doen met een tekst. De teksten ontmoedigen de lezers door hun lengte, of zorgen voor veel stress door hun onbegrijpelijkheid.
Dat blijkt uit een onderzoek van de Universiteit Utrecht (UU) en de Hogeschool Arnhem Nijmegen (HAN), uitgevoerd in opdracht van het Ministerie van BZK en de Taalunie. Het onderzoek maakt deel uit van het programma Direct Duidelijk, dat tot doel heeft om overheidsteksten begrijpelijk te maken voor de doelgroep.
In het onderzoek werden 140 teksten gebruikt die gericht zijn aan mensen in een schuldhulptraject. Ze zijn afkomstig uit 14 Nederlandse gemeenten. Vaak gaat het om brieven, maar er zijn ook webpagina’s, folders en teksten met financiële en juridische afspraken onderzocht. Sommige teksten zijn zowel in een originele als in een herschreven versie getoetst. De begrijpelijkheid van de teksten is onderzocht met drie verschillende methoden:
- automatische tekstanalyse;







- tekstexperts die de Direct Duidelijk-checklist met tips voor duidelijk schrijven gebruikten;

- leesonderzoek met inwoners met een verschillend opleidingsniveau.
Automatische analyse van teksten
Bij de automatische analyse worden de teksten in vier moeilijkheidsniveaus ingedeeld. Alleen bij niveau 1 is het taalgebruik begrijpelijk voor alle Nederlanders, ongeacht hun opleiding. ‘We zien dat de gebruikte woorden en zinnen in 38% van de onderzochte teksten niveau 1 heeft. Bijna twee derde van de teksten is moeilijker dan niveau 1. Het taalgebruik is soms veel moeilijker. Teksten op niveau 4 zijn zelfs onbegrijpelijk voor hoogopgeleide lezers’, aldus Henk Pander Maat (UU). Maar herschrijven helpt, zo geeft Pander Maat aan. ‘Bij de herschreven versies zit 57% op niveau 1 en 43% op niveau 2. Een tekst is lastig als er onbekende woorden zijn gebruikt en de zinnen op een compacte manier heel veel informatie geven. Bij de automatische tekstanalyse geeft de computer aan welke woorden en zinnen dat zijn.’
Expert-analyse met checklist
Tien communicatie-experts hebben met de Direct Duidelijk-checklist problemen gesignaleerd die de lezers zouden kunnen krijgen met de teksten. Zij wijzen verschillende soorten tekstproblemen aan,
zoals moeilijke woorden, moeilijke zinnen, een onvriendelijke toon en onduidelijke kopjes. Verder vinden ze dat teksten alleen verstuurd moeten worden als ze een helder doel hebben, en dat de tekst alleen informatie moet geven die aansluit bij de situatie van de lezer.
De Taalunie en BZK zetten zich via het programma Direct Duidelijk in voor begrijpelijke overheidstaal. Ze helpen overheden op weg om hun communicatie met de burger begrijpelijker te maken. De inzichten uit dit onderzoek naar teksten uit schuldhulpverlening kunnen ook algemeen ingezet worden voor het begrijpelijk maken van overheidsteksten.
In het lezersonderzoek zijn vijf teksten bekeken met moeilijkheidsniveau 2. Die teksten zouden qua taalgebruik begrijpelijk moeten zijn voor lezers met een hogere opleiding dan mbo-1. Maar de teksten blijken toch veel problemen op te leveren, ook bij lezers met een hogere opleiding. Thea van der Geest, lector Media Design bij de HAN: ‘Veel mensen begrijpen de boodschap van de tekst verkeerd of twijfelen of ze het goed begrepen hebben. Teksten over schuldhulp roepen heel sterke emoties op die je niet kunt voorspellen met een automatische tekstanalyse of een groep van tekstexperts. Sommige teksten zijn ontmoedigend lang voor de lezers en worden daarom niet of slecht gelezen. Andere teksten leveren veel stress op. De lezers begrijpen het doel of de inhoud niet goed en zijn bang dat de tekst slecht nieuws brengt over hun geldproblemen.’
Verbeter teksten in drie stappen
Het rapport adviseert overheden om hun teksten te verbeteren in drie stappen.
1 Kijk via automatische analyse bij een grote groep teksten naar de begrijpelijkheid, en identificeer probleemteksten die niet goed te begrijpen zijn voor de doelgroep.
behulp van de Direct Duidelijk-checklist. Leg de verbeterde versies voor aan lezers met verschillende achtergrond en opleiding.

3 Als je zeker weet dat een tekstingreep ook echt werkt bij de lezers, pas hem dan toe in zo veel mogelijk andere teksten van je organisatie.
2 Selecteer een aantal teksten die als voorbeeld kunnen dienen. Laat de opstellers samen met tekstexperts die teksten verbeteren met
Bron: Nieuwsbericht Nog werk aan begrijpelijke overheidsteksten van de Taalunie uit 2021
Samenvatting 1

Onderzoek van de Universiteit Utrecht en de Hogeschool Arnhem Nijmegen, uitgevoert in opdracht van het Ministerie van BZK en de taalunie, toont aan dat overheidsinstanties helaas nog steeds moeilijke teksten naar mensen met schuldproblemen sturen. In 62% van de gevallen is de taal moeilijk te begrijpen voor laagopleide lezers. De teksten ontmoedigen lezers door hun langte, of zorgen voor veel onnodige stress door hun onbegrijpelijkheid.
Het onderozek maakt deel uit van het belangrijke programma Direct Duidelijk, dat tot doel heeft om overheidsteksten begrijpelijker te maken voor de doelgroep. Een zeer nobel doel.
Er werden 140 teksten uit 14 Nederlandse gemeenten onderzocht die gericht waren aan mensen in een schuldtraject. Deze teksten waren meestal brieven, maar ook andere teksten zoals webpagina’s kwamen aan bod. De begrijpelijkheid werd aan de hand van drie verschillende methodes onderzocht.
De eerste methode die gebruikt werd was een automatische tekstanalyse. Hierbij werden alle teksten in vier moeilijkheidsniveaus ingedeelt. Bij niveau 1 is het taalgebruik begrijpelijk voor alle Nederlands, ongeacht hun opleiding. Helaas is bijna twee derde van de tekst moeilijker dan niveau 1, soms is het taalgebruik zelfs veel moeilijker. Herschrijven lijkt wel te helpen. Onbekende woorden en zinnen die op een compacte wijze heel veel informatie geven, worden bij een automatische tekstanalyse door de computer aangegeven.
De tweede methode die gebruikt werd is de expert analise met cheklist. Hierbij hebben verschillende communicatie experts teksten geanalyseerd aan de hand van de Direct Duidelijk Checklist. Zij ontdekten verschillende problemen zoals moeilijke woorden, moeilijke zinnen, een onvriendelijke toon en onduidelijke kopjes. Daarnaast vonden de experts ook dat er te veel irrelevante informatie voor de lezers in de tekst stond. Informatie in de tekst zou enkel moeten aansluiten bij de individuele sitautie van de lezer.
Ten slotte werd er nog een derde methode gebruikt: het lezersonderzoek. Hierin zijn vijf teksten bekeken met moeilijkheidsniveau 2. Ze zouden dus vrij begrijpelijk moeten zijn, maar toch lijken ze veel problemen op te leveren, zelfs bij lezers met een hogeren opleiding. Dit komt onder meer doordat brieven over schuldhulp vaak heel sterke emoties oproepen, deze kan je niet voorspellen met een automatische tekstanalyse of een groep van tekstexperts.
Het rapport adviseerd overheden om teksten te verbeteren in drie stappen:
1 Gebruik automatische tekstanalyse om naar een grote groep teksten te kijken op vlak van begrijpelijkheid en identificeer probleemteksten die niet goed te begrijpen zijn voor de doelgroep.
2 Selecteer teksten die als voorbeeld kunnen dienen. Laat de opstellers de Direct-Duidelijk-checklist gebruiken en laat hen samenwerken met tekstexperts. Leg de verbeterde versies voor aan lezers met verschillende achtergronden.
3 Als je zeker weet dat een ingreep echt werkt bij lezers, probeer deze ingreep dan zo veel moeglijk toe te passen.
Onderzoek van de Universiteit Utrecht en de Hogeschool Arnhem Nijmegen, uitgevoerd in opdracht van het Ministerie van BZK en de taalunie, toont aan dat overheidsinstanties nog steeds moeilijke teksten naar mensen met schuldproblemen sturen. In 62% van de gevallen is de taal moeilijk te begrijpen voor laagopgeleide lezers.
Er werden 140 teksten uit 14 Nederlandse gemeenten onderzocht die gericht waren aan mensen in een schuldtraject. Deze teksten waren meestal brieven, maar ook andere teksten zoals webpagina’s kwamen aan bod. De begrijpelijkheid werd aan de hand van drie verschillende methodes onderzocht: een automatische tekstanalyse (hierbij werden teksten opgedeeld in 4 moeilijkheidsniveaus waarbij enkel niveau 1 begrijpelijk is voor alle Nederlanders), een expertanalyse met checklist en een lezersonderzoek (hierin werd er gekeken naar 5 teksten van niveau 2 die problemen opleveren).
Uit het onderzoek blijkt dat bijna twee derde van de teksten moeilijker is dan niveau 1. Experts wijzen op problemen als moeilijke woorden en zinnen, een onvriendelijke toon en onduidelijke kopjes. Zij pleiten er tevens voor dat een tekst enkel informatie bevat die relevant is de lezer.
Het rapport adviseert overheden om teksten te verbeteren in drie stappen.
1 Kijk via automatische analyse naar de begrijpelijkheid van teksten.
2 Selecteer een aantal gescreende voorbeeldteksten.
3 Werkt een ingreep? Pas hem dan frequent toe.
Het rapport adviseert overheden om teksten te verbeteren.
Onderzoek toont aan dat mensen met schuldproblemen nog steeds moeilijke teksten ontvangen. In veel gevallen is de taal moeilijk te begrijpen voor sommige lezers.
Er werden teksten uit Nederlandse gemeenten onderzocht. De begrijpelijkheid werd aan de hand van drie verschillende methodes onderzocht: een automatische tekstanalyse, een expertanalyse met checklist en een lezersonderzoek.
Uit het onderzoek blijkt dat sommige teksten moeilijker zijn dan niveau 1. Experts wezen op problemen als moeilijke woorden en zinnen, een onvriendelijke toon en onduidelijke kopjes. Zij pleiten er tevens voor dat een tekst enkel informatie bevat die relevant is de lezer.
In les 12 op p. 160 maakte je zelf een schema van de tekst Als u dit leest, word u boos. Aan de hand van dit schema ga je nu zelf een samenvatting schrijven van de tekst. Alvorens aan de slag te gaan, ga je na of jouw schema volledig genoeg is.
1 Beantwoord onderstaande vragen. Je mag daarvoor jouw schema gebruiken.
a Wat werd er onderzocht?
b Door wie werd het onderzocht?
c Wat zijn homofonen? Geef ook een voorbeeld.
d Welke twee mentale componenten spelen een rol bij het maken van dt-fouten?
e Leg uit wat het aantal woorden tussen de homofone vorm en het onderwerp als impact had op het aantal dt-fouten.
f Hoe komt dat?
g Vat de dt-regel samen.
h Pragmatici vinden dat de ernst van een dt-fout afhangt van de situatie en het type speller. Leg uit.
2 Re ecteer.
a Kon je aan de hand van jouw schema alle vragen bij opdracht 1 beantwoorden?
b Zou je na deze opdracht nog extra informatie toevoegen aan jouw schema? Zo ja, welke?
1 Maak een schrijfplan voor je samenvatting waarin je de relevante informatie uit je schema gebruikt. Geef in dit schrijfplan aan welke informatie je in de inleiding, de conclusie en in elke alinea wilt vermelden.
2 Hou tijdens het schrijven van een gedetailleerde samenvatting rekening met de volgende aandachtspunten.
• Schrijf een doorlopende tekst met een IMS-structuur.
• Zorg voor een logische opbouw binnen elke alinea: een kernzin en uitwerking.
• Maak de samenvatting niet langer dan een derde van de oorspronkelijke tekst.
• Maak gebruik van duidelijke signaal- en verwijswoorden.
3 Neem jouw samenvatting grondig door en beoordeel je eigen werk aan de hand van de evaluatiematrix op de volgende pagina..
GOED
VOLDOENDE ONVOLDOENDE
volledigheid en duidelijkheid
Je samenvatting is opgesteld aan de hand van een duidelijke IMS-structuur.
De tekst is opgebouwd volgens het IMS-principe. De inleiding en het slot zijn aanwezig, maar:
De tekst is niet opgedeeld volgens het IMS-principe. Inleiding en/of slot ontbreken of zijn te beperkt uitgewerkt.
De tekst is onderverdeeld in alinea’s. Die alinea’s werden correct opgebouwd (kernzin en uitwerking).
- De samenhang en structuur van de tekst wordt onderbouwd door signaalen verwijswoorden.
- De verbanden tussen verschillende tekstonderdelen zijn duidelijk.
Je verwerkt alle relevante informatie in je samenvatting met de nodige details.
De tekst is onderverdeeld in alinea’s. De tekstsamenhang (binnen de alinea en/of tussen alinea’s) is echter een werkpunt.
- Je maakt gebruik van signaal- en verwijswoorden, maar niet voldoende en/of niet altijd op een correcte manier.
- De verbanden tussen verschillende tekstonderdelen zijn meestal, maar niet altijd duidelijk.
Je verwerkt alle relevante informatie in je samenvatting maar geeft soms te veel/ weinig details.
De taal van het eindresultaat is (nagenoeg) foutloos.
De tekst bevat enkele taalfouten die
- de communicatie niet hinderen;
- de boodschap niet in de weg staan.
-De tekst werd niet opgedeeld in alinea’s.
-De alinea’s vormen geen geheel én vertonen geen onderlinge samenhang.
- Je maakt onvoldoende of geen gebruik van signaal- en verwijswoorden, daardoor mist je tekst structuur en samenhang.
- De verbanden tussen de verschillende tekstonderdelen zijn niet duidelijk.
-Je verwerkt niet alle relevante informatie in je samenvatting.
-Je verwerkt te veel irrelevante informatie in je samenvatting.
De tekst bevat te veel en/of te opvallende taalfouten.
-De omvang van je samenvatting bedraagt niet meer dan een derde van de oorspronkelijke tekst.
- De lengte van de verschillende onderdelen is in verhouding tot de lengte van de oorspronkelijke tekst.
Aanvullende commentaar:
-De omvang van je samenvatting is net niet te uitgebreid.
- De lengte van de meeste onderdelen is in verhouding tot de lengte van de oorspronkelijke tekst, maar niet altijd.
-Je samenvatting is te beperkt of te uitgebreid.
- De lengte van de verschillende onderdelen is niet in verhouding tot de lengte van de oorspronkelijke tekst.
Hoe schrijf je een samenvatting?
Een samenvatting is een verkorte versie van de oorspronkelijke tekst. Je neemt enkel de hoofdzaken op en je herleidt de tekst tot de essentie.
Lees de tekst die je kreeg zorgvuldig door, duid kernzinnen aan en markeer signaalwoorden Gebruik steeds dezelfde kleuren of symbolen, zodat je in één oogopslag de structuur van de tekst ziet.
Breng alle kernideeën samen in een schema. Je kunt ervoor kiezen om de volgorde van de tekst te behouden of te vertrekken van een van de vaste tekststructuren om daarin alle gegevens samen te brengen.
Schrijf je schema uit tot een doorlopende tekst. Geef in een korte versie weer wat de auteur schrijft. Beperk je tot wat er staat: voeg zelf geen elementen toe. Kies voor objectieve woorden. In een samenvatting geef je weer wat de idee van de auteur is, je geeft geen interpretatie, mening of opmerkingen.
Zorg er ook voor dat het eindresultaat vormelijk correct is. Vermijd spellingfouten, zorg voor een gepaste woordkeuze en een heldere zinsbouw.
Een goede samenvatting:
is korter dan de oorspronkelijke tekst;
✓
beperkt zich tot de kernelementen;
✓
geeft alle informatie correct en objectief weer;
✓
is duidelijk en volledig;
✓
✓
bevat geen taal- of spellingfouten.
Je kunt de nieuwswaarde van een gebeurtenis bepalen
Je kunt nepnieuws en framing definiëren en herkennen
Je kunt vragen over een tekst beantwoorden

Elke dag gebeurt er van alles over de hele wereld. Naast historische gebeurtenissen halen sommige andere, ogenschijnlijk onbelangrijke gebeurtenissen het nieuws. Wat nieuws is, is moeilijk definieerbaar. Toch is het voor velen van levensbelang.
Journalist en filosoof Rob Wijnberg vertelt in De nieuwsfabriek: hoe media ons wereldbeeld vervormen welke mechanismen mediavoorziening in stand houden. Hierin beschrijft hij een opmerkelijke gebeurtenis.

Toen de Amerikaanse senator en voormalige Republikeinse presidentskandidaat John McCain tijdens de oorlog in Vietnam vijf jaar opgesloten zat in de bunker van zijn gijzelnemers en hem nadien werd gevraagd wat hij al die tijd het meest had gemist, antwoordde hij niet voor niets: ‘Het nieuws.’ Hij zei niet: mijn familie, mijn vrienden of de buitenlucht. Nee, hij zei: het nieuws. Dat klinkt misschien vreemd, maar geeft precies aan welke cruciale functie het in onze samenleving vervult. Nieuws is onze belangrijkste verbinding met de wereld om ons heen.
1 Begrijp je McCains standpunt? Geef twee argumenten.
2 Kun jij zonder nieuws? Hoe vaak per dag check jij nieuwssites op je smartphone? Lees je de volledige artikels of enkel de krantenkoppen?
3 Wat maakt een gebeurtenis nieuws volgens jou? Waarom zijn bepaalde situaties wel nieuwswaardig en andere niet?
a Kies een vijftal woorden uit de woordenwolk om je antwoord te duiden.
b Vergelijk jouw gekozen woorden met die van een medeleerling. Komen jullie antwoorden overeen?
Rob Wijnberg filosofeert over het begrip ‘nieuws’ en komt tot het besluit ‘dat nieuws niet simpelweg een weergave is van wat er gebeurt in de wereld […]: nieuws is een selectieve (want uit uitzonderingen opgebouwde), conservatieve (want op het negatieve gerichte) en repetitieve (want eindeloos herhaalde) uitsnede van de wereld.’
4 Wijnberg kent hier drie kenmerken toe aan nieuws. Koppel de kenmerken aan de gegeven voorbeelden.
1 Nieuws is selectief. aJaarlijks worden er reportages gemaakt over de volgeboekte hotels aan zee tijdens de zomermaanden.
2 Nieuws is conservatief. bHooliganisme wordt voorgesteld als een voetbalprobleem, maar slechts 1 op 1000 supporters is ooit betrokken geweest bij voetbalgeweld.
3 Nieuws is repetitief. cDe Belgische belastingdruk is bij de hoogste van Europa.
d Regelmatig worden nieuwsberichten de wereld ingestuurd over de toenemende agressie in centrumsteden. eSinds de kredietcrisis heerst de perceptie (indruk) dat alle bankiers hebzuchtige graaiers zijn. Nochtans heeft het gros van de bankbedienden nog nooit een bonus gekregen of een dubieuze hypotheek verkocht. fLeg verschillende kranten naast elkaar en de kans is heel groot dat de voorpagina erg gelijkaardig is.
5 Bekijk onderstaande krantenkoppen.
a Gebruik jouw idee over nieuwswaarde en het idee van Wijnberg om de krantenkoppen te rangschikken volgens hun nieuwswaarde.
b Vergelijk nu jouw antwoorden met die van de rest van de klas. Argumenteer waarom je voor deze volgorde koos.
1 Negen doden bij bombardementen op luchthaven (Het Nieuwsblad )
2 Crash in ijskoud water wordt twee twintigers fataal: ‘Ze hadden misschien wel een mooie toekomst samen’ (Het Nieuwsblad )
3 Europese gasprijs stijgt met meer dan 70% naar nieuw record (HLN )
5 Verlenging kerncentrales geen taboe meer voor groenen (De Morgen)
7 Lotte Kopecky zet stap naar wereldtop met zege in eerste grote klassieker (De Morgen)
6 Deel van raket neergestort op de maan, zonder al te veel impact: ‘Typische slordigheid van de mens’ (De Morgen)
4 De 7 favoriete eetadresjes van chef Marcello Ballardin: ‘Deze chocoladekoeken en dit suikerbrood moet je geproefd hebben’ (HLN )
8 80-jarige Dirk woont plots alleen in het midden van rotonde in Mechelen: ‘Ik had geen zin om weg te gaan’ (vrt.be)
veel nieuwswaarde weinig nieuwswaarde
Wijnberg is niet de enige die onderzoek deed naar de nieuwswaarde van gebeurtenissen. onthouden
Twee Noorse onderzoekers, Johan Galtung en Mari Holmboe Ruge, voerden in de jaren zestig van de vorige eeuw onderzoek naar wat bepaalt welke gebeurtenissen nieuws worden en welke niet, met andere woorden wat een gebeurtenis nieuwswaardig maakt. Ze stelden een taxonomie op die bepaalt hoeveel nieuwswaarde een gebeurtenis heeft. Hoe meer factoren aangevinkt kunnen worden, hoe nieuwswaardiger de gebeurtenis.
Galtung en Ruge onderscheiden twaalf factoren die in drie categorieën geplaatst kunnen worden.
6 Verbind de verklaring met de correcte factor.
factor verklaring
1 drempelwaarde aGebeurtenissen die onverwacht, buitengewoon of zeldzaam zijn, worden eerder nieuws dan routines of weinig verrassende gebeurtenissen.
2 frequentie b Gebeurtenissen die plotseling plaatsvinden, zijn nieuwswaardiger dan gebeurtenissen die zich geleidelijk aan ontwikkelen. Langetermijntrends krijgen weinig aandacht.
3 negativiteit c Verhalen over wereldgrootmachten worden eerder nieuws dan soortgelijke verhalen over minder invloedrijke landen.
4 onverwachtheid dNieuws waarin één of enkele mensen centraal staan, zijn sneller nieuwswaardig omdat mensen zich beter kunnen identificeren met wat er gebeurt.
5 duidelijkheid e De media besteden eerder aandacht aan bekende dan aan onbekende mensen. Mensen identificeren zich graag met bekende mensen.
6 personalisatie fHoe grootser qua schaal of reikwijdte of hoe intenser de gebeurtenis, hoe nieuwswaardiger.
7 betekenisvolheid g Hoe minder vaag een gebeurtenis is, hoe nieuwswaardiger.
8 elitelanden h Wanneer een gebeurtenis als cultureel nabij wordt ervaren, wordt het sneller nieuwswaardig. Buitenlandse rituelen die wij niet begrijpen, zullen minder snel in het nieuws komen.
9 elitemensen iSlecht nieuws is nieuwswaardiger dan goed nieuws.
123456789
de taxonomie: de wetenschap van het indelen van individuen of objecten in groepen
7 De Amerikaanse journalist Charles Anderson Dana deed onderstaande uitspraak al in de negentiende eeuw. Op welke nieuwsfactoren van Galtung en Ruge heeft die uitspraak betrekking?
8 Bekijk de krantenkoppen aandachtig. Welke nieuwsfactor uit opdracht 6 komt hier het duidelijkst aan bod?
HET WAS EEN TITANENWERK, MAAR HET IS GELUKT: GENT
KRIJGT MAANDAG EEN BELANGRIJKE, NIEUWE BRUG
JAREN NA HET DODELIJKE ONGEVAL VAN DE NEDERLANDSE PRINS
FRISO: ZE LEVEN DOOR, ZO GOED EN ZO KWAAD ALS HET GAAT
OMGEKOMEN NA AARDSCHOK OP LOMBOK
9 Waarom zouden de volgende gebeurtenissen niet snel in het nieuws komen? Verwijs daarvoor naar de nieuwsfactoren van Galtung en Ruge uit opdracht 6.
a In Mexico wordt jaarlijks gedurende twee weken in juli Guelaguetza gevierd. Tijdens dit feest geven de Zapoteken producten uit de regio aan anderen door middel van een speciale dans.
b Na zestien jaar dakloos te zijn geweest, heeft de Brit Robert Douglas, genoeg kapitaal verzameld om zich een dak boven het hoofd te kunnen veroorloven.
‘When a dog bites a man that is not news, but when a man bites a dog that is news.’
‘Nieuws’ is duidelijk een erg breed begrip en het vertrouwen in nieuwsleveraars blijkt niet altijd even groot. Ook het onderstaande citaat toont dat aan.
1 Wie denk je dat die uitspraak deed?
Socrates, Grieks filosoof (470-399 v.C.)



Donald Trump, president van de VS (°1946)

2 Wat denk je dat er bedoeld wordt met die uitspraak? Ben je het daarmee eens?
De term ‘fake news’ of nepnieuws is zeker niet nieuw, maar sinds de Amerikaanse presidentsverkiezingen van 2016 is dit begrip alomtegenwoordig. 40% van de kiezers zou daarmee in contact zijn gekomen. Het ging vooral om de beïnvloeding van de Amerikaanse verkiezingen vanuit Rusland ten voordele van de Amerikaanse president, aan de hand van betaalde Facebookadvertenties onder de vorm van nepnieuws. Ook de berichtgeving rond de oorlog tussen Rusland en Oekraïne is niet vrij van nepnieuws.
3 Kwam jij al in contact met nepnieuws?



a Waarover ging dat?

b Vind je het gemakkelijk om nepnieuws te herkennen?

c Heb je het gevoel dat je beïnvloed wordt door nepnieuws?
4 Bekijk deze voorbeelden van nepnieuws aandachtig.
DRUGS HONDERDEN KILO’S COCAÏNE
Dit stelletje hoorde dat honderden kilo’s cocaïne aangespoeld waren op het Noordzeestrand bij het Engelse Great Yarmouth, dus gingen ze een wandelingetje maken. Je weet tenslotte maar nooit. Nou, dat hebben ze geweten!
‘If you don’t read the newspaper, you’re uninformed; if you do read the newspaper, you’re misinformed.’ Jonathan Safran Foer, auteur (°1977) Mark Twain, auteur (1835-1910)
De 16-jarige Zweedse klimaatactiviste Greta Thunberg kan volgens haar moeder Malena Ernman (48) CO2 met het blote oog zien. Dat schrijft ze in het boek Scènes uit het hart. Ons leven voor het klimaat dat ze samen met haar gezin heeft geschreven.
In dit artikel ontdek je hoe je snel calorieën verbrandt, zodat je er op de grote dag, je bruiloft, perfect uitziet…

Jase

5 De nieer het begrip ‘nepnieuws’ aan de hand van de voorbeelden.

6 Waarom zou nepnieuws verspreid worden? Ga op zoek naar twee redenen die de aanleiding kunnen zijn voor het verspreiden van nepnieuws.
Op deze foto lijkt het alsof Donald Trump op heldhaftige wijze een drenkeling helpt in de nasleep van orkaan Florence in . In werkelijkheid was president Trump helemaal niet te zien op deze foto. Het was een reddingswerker die de man in nood uit het water haalde in Texas. Een knap staaltje Photoshop dus.

‘Het 5G-netwerk helpt het coronavirus te verspreiden’
Dagelijks kom je in contact met verschillende soorten informatie. In sommige gevallen is er een duidelijke kwaliteitscontrole gebeurd (het nieuws op radio en televisie, schoolboeken, artikels in wetenschappelijke tijdschriften), in andere gevallen wordt een mening van een persoon snel als feit voorgesteld (posts op sociale media of reclameberichten die vermomd zijn als nieuwsitem). Bij alle bronnen die je gebruikt, is het belangrijk om na te gaan of ze correct, bruikbaar en betrouwbaar zijn.
• Correct: Kijk of de informatie juist en niet verouderd is. Vraag je af of er geen onwaarheden in een artikel staan. Je doet er goed aan om informatie die je in een bron vindt te vergelijken met een andere bron. Zo kun je zien of ze dezelfde feiten geven.
• Bruikbaar : Niet alle informatie is nuttig op elk moment. Vraag je af of je de bronnen die je vindt, kunt gebruiken voor de opdracht waarmee je bezig bent.
• Betrouwbaar: Kijk wie de tekst geschreven heeft en ga na of die persoon iets van het onderwerp afweet. Probeer ook te weten te komen waarom een tekst geschreven werd. De informatie kan misschien wel correct zijn, maar bijvoorbeeld maar één kant van de zaak belichten omdat de maker een bepaalde stelling wil aantonen.
Op een site van een filmproducent zul je bijvoorbeeld nooit negatieve informatie over de eigen films vinden. Je zult er misschien citaten van recensenten of kenners terugvinden, maar die zijn geselecteerd om de film te promoten, niet om de film kritisch te bespreken.
De vragen op de volgende pagina helpen je om te selecteren welke info betrouwbaar is en welke niet.
Voor het kijken
Je bekijkt straks een aflevering van Universiteit van Vlaanderen
1 Deze a evering heet Waarom geloof jij fake news?.
a Op welke vragen verwacht je een antwoord te krijgen in deze reportage?
b Op welke vragen wil je een antwoord krijgen in deze reportage?
2 De spreker is Ike Picone, media-expert van de Vrije Universiteit Brussel. Zal zijn uiteenzetting eerder objectief of subjectief zijn? objectief subjectief
Tijdens het kijken
Bekijk nu het fragment Waarom geloof jij fake news?
3 Welke twee doeleinden heeft nepnieuws voor Picone? Vul in: volgens hem zijn fake nieuwsberichten … verzinsels.
4 Picone stelt dat mensen nepnieuws veel ruimer zien dan enkel verzinsels. Welke drie vormen van nepnieuws bestaan er?
5 Wat bedoelt Picone met de ‘con rmation bias’?
6 Waar of niet waar? Kruis aan.
a De Franse president bindt de strijd aan tegen de verspreiding van nepnieuws via sociale media door de verspreiding ervan strafbaar te maken.
b Fact checkers gaan na hoeveel nepnieuws er verspreid wordt via sociale media.
c Wanneer er links naar geverifieerde inhoud staan bij nepberichten, klikken mensen nog steeds even vaak door en delen ze dit even vaak.
d Wanneer we overspoeld worden door informatie, is het moeilijk kritisch te reflecteren op een bericht.
7 Waarom is het moeilijk om nepnieuws volledig van het internet te halen?
8 Wat bedoelt Picone als hij zegt dat we het kind niet met het badwater mogen weggooien wanneer hij het heeft over het feit dat sociale media minder nieuws zullen doorlaten in de newsfeeds van mensen?


9 De leerkracht deelt verschillende stellingen met de klas. Wat is jouw mening? Bespreek ze klassikaal.
10 Nu is het aan jou om je klas in de val te lokken. Je presenteert aan je medeleerlingen mondeling twee nieuwsberichten over een gelijkaardig onderwerp. Eén bericht is waarheidsgetrouw, het andere is nepnieuws. Aan de rest van de klas om het fake news te herkennen.
Heb je weinig inspiratie? Kijk zeker eens op de satirische websites rechtzetting.be en speld.nl
Luchtfoto’s tonen villawijk die nooit in contact kwam met buitenwereld

KABINET: MAXIMUMSNELHEID
OP SNELWEG NAAR 30 KM/U

OM STIKSTOFUITSTOOT TE
BEPERKEN
De maximumsnelheid op de snelweg gaat omlaag naar 30 kilometer per uur. Lees verder
Bron: speld.nl
Ambtenaren van het departement Inheemse Volkeren hebben spectaculaire foto’s genomen van een wijk die nooit eerder contact had met de buitenwereld. De stam woont diep verscholen in de bossen van SintMartens-Latem.
Bron: rechtzetting.be


1 Hoe positief of negatief komen deze beelden en krantenkoppen op jou over? Beoordeel ze aan de hand van een score tussen 1 (= zeer negatief) en 5 (= zeer positief).

2 Nepnieuws gaat hand in hand met ‘framing’. Je krijgt vier bronnen. De nieer op basis daarvan het begrip ‘framing’.

Zuivelproducten met het weidemelklogo zijn gemaakt van melk afkomstig van koeien die tenminste 120 dagen per jaar, minimaal 6 uur per dag in de wei lopen.




Met andere woorden: weidemelkkoeien moeten 245 dagen per jaar in de stal blijven.

Label bij vlees in de supermarkt: er bestaat geen label met 3 ‘lege’ sterren.
3 Bekijk opnieuw afbeelding A uit opdracht 1. Wat zou het e ect zijn als er niet ‘65% minder vet’ zou staan, maar wel ‘10% vet’? Kun je dat verklaren nu je weet wat framing is en hoe het werkt?

Kruip in de huid van een personage wiens identiteit (karakter, manier van denken, geaardheid, sociale achtergrond) verschilt van jouw eigen identiteit.




 LUISTERFRAGMENTEN
LUISTERFRAGMENTEN




Edward van de Vendel
roman (1999)
Wat doe je als je leven radicaal omgegooid wordt? Vechten of volgen? Aanvallen of verdedigen? Stilstaan of meebewegen?
















Tycho is achttien en na zijn eindexamen gaat hij voor het eerst alleen op reis: hij wordt junior assistant in een Amerikaans kinderkamp. Daar sluit hij meteen vriendschap met de Noor Oliver, even oud als Tycho en voetballer. Het wordt een zinderende zomer die hun leven voor altijd verandert.






Macleigh laat de bedrukte sfeer van zijn ouderlijk huis en de voorspelbaarheid van saaie provinciestadje achter zich en gaat studeren aan de universiteit van Boston. In anonimiteit van de grootstad bloeit de teruggetrokken jongeman langzaam open: hij op eigen benen, maakt enkele intrigerende vrienden en komt in de ban van zijn bloedmooie studiegenote Rachella. Verlegen is, durft Tom haar niet aan te spreken verliest zich in dagdromen. Hij krijgt ook meer af te rekenen met onverklaarbare woedeaanvallen, waarbij hij het contact met werkelijkheid compleet verliest. Wanneer Rachella een donkere periode doormaakt, blijkt toevallig de juiste man op de juiste plaats. groeien gaandeweg naar elkaar toe. Wordt de voor Rachella Toms redding of ondergang? 12+ 14+ 16+

Ish Ait Hamou
HAMOU

psychologische roman, drama (2014)








we ons
Tom Macleigh komt uit een liefdeloos gezin. Hij laat de bedrukte sfeer van zijn ouderlijke huis en de voorspelbaarheid van zijn saaie provinciestadje achter zich om te gaan studeren aan de universiteit van Boston. Daar maakt hij vrienden en wordt hij voor het eerst verliefd. Na veel dagdromen durft hij de stap te wagen om op zijn droommeisje af te stappen. Wordt de liefde voor Rachella zijn redding of zijn ondergang?

Annelies Verbeke
Kortverhalen (2012)
Doordat we ons vaak eerder laten leiden door veronderstellingen dan door feiten, maken we slachtoffers. Of we ondervinden er zelf de vervelende gevolgen van. In vijftien prachtige verhalen toont Annelies Verbeke mensen die ten prooi vallen aan voorbarige conclusies. Of alleen achterblijven met veronderstellingen en gevolgtrekkingen die wél gegrond zijn.
17










Per Nilsson drama, familieroman (2003)

Er ligt een zeventienjarige jongen op de eerstehulpafdeling van het ziekenhuis. Hij stinkt naar drank, sigaretten en braaksel. Zijn ogen zijn dicht, maar hij ademt. Naast het bed zit Göran, zijn vader. Hij begint tegen zijn slapende zoon te praten over de tijd dat hij zelf zeventien was, in de jaren zeventig. Hij vertelt hoe hij de moeder van zijn zoon ontmoette. Hoe ze samen een kind kregen. En hoe hij zijn vrouw en kind uiteindelijk verliet. De vader wijdt uit over al zijn fouten in de hoop dat zijn zoon en hij elkaar opnieuw kunnen leren kennen.
Mark Haddon

roman (2003)
Christopher is vijftien en heeft een vorm van autisme. Hij weet veel van wiskunde, maar weinig van mensen. Hij houdt van lijstjes, patronen en de waarheid. Hij houdt niet van de kleuren geel en bruin. Hij is in zijn eentje nooit verder geweest dan het einde van de straat, maar wanneer blijkt dat de hond van de buurvrouw is vermoord, gaat hij op onderzoek uit. Hij begint aan een indrukwekkende reis die zijn veilige bestaan volledig overhoop gooit.
Tom Lanoye







autobiografie (1991)



Lanoye legt de verslavingen en de valstrikken bloot van de grote, allesverterende jeugdliefde die iedereen kent uit ervaring. Maar hij schildert ook zijn eigen afkomst en opvoeding: de slagerswinkel van zijn vader, de vier vrouwen die hem hebben opgevoed, de katholieke school die probeert overeind te blijven in de stormen van de moderniteit, de bejaarde priester-dichter die een inspirerende leraar Nederlands blijkt te zijn, de turners waaraan de jonge auteur zich vergaapt, en de stripverhalen waaraan hij zijn ogen kapot leest.
Zodoende legt Lanoye niet alleen zijn jeugd vast, maar graaft hij ook de bronnen op van zijn schrijverschap, zijn voorliefde voor het theater en zijn eeuwige zoektocht naar schoonheid, liefde en literatuur.
Margot Vanderstraeten







autobiografie (2017)



Zes jaar lang begeleidt auteur Margot Vanderstraeten de kinderen van de familie Schneider, een gesloten orthodox-joods gezin in Antwerpen, bij hun huiswerk. Via dochter Elzira en zoon Jakov krijgt ze geleidelijk aan toegang tot hun wereld. Hier heersen religieuze wetten en eeuwenoude tradities die de Vlaamse studente maar moeilijk kan rijmen met de tijd: de jaren negentig. Maar ook de joodse familie wordt beproefd door de open, maar kritische werkstudente. Dat zij ongehuwd samenwoont met haar Iraanse vriend Nima wekt achterdocht. Gaandeweg winnen – aan beide zijden – respect, nieuwsgierigheid en humor het van verontwaardiging en verwerping.

THE HATE U GIVE


Angie Thomas




roman (2017)




De zestienjarige Starr Carter gaat naar een dure, particuliere school, maar woont in een arme wijk vol drugs en straatbendes. De spanning tussen die twee werelden loopt op als Starr getuige is van een schietincident waarbij haar jeugdvriend Khalil door een agent wordt gedood.

Je leert hoe gesproken en geschreven taal iets vertellen over iemands identiteit
Je ziet gelijkenissen en verschillen tussen taalvariëteiten en toont respect voor verschillen
Je leert welke taalvariëteiten er bestaan en hoe divers ons taallandschap is
Stel: er liggen drie kledingstukken van medeleerlingen voor jou. Zou je de kledingstukken bij de juiste persoon kunnen plaatsen? De kans is groot. Iedereen heeft nu eenmaal zijn eigen stijl. Kleren dienen niet enkel om je te beschermen tegen de koude of de regen, je verklapt er ook een stukje van je identiteit mee.
Dat is net zo met taal: in het vierde jaar leerde je al dat iedereen een eigen spreek- en schrijfstijl heeft. Je taal kan verraden waar je vandaan komt, wat je leeftijd is, of je een man of vrouw bent ... Taal dient uiteraard om te communiceren, om een boodschap over te brengen, maar net zoals kledij is taal ook een manier om je identiteit uit te drukken.
Je kunt de vergelijking nog verder doortrekken: je zou aan kleding ook kunnen zien wat iemand gaat doen: zijn het kleren om naar een feestje te gaan? Of eerder voor een kamp met de jeugdbeweging? In short en slippers leg je geen mondeling proefwerk af. En in je feestjurk en hoge hakken lig je niet te chillen op je bed.
Net zoals je kledij is ook je taal aangepast aan de situatie: afhankelijk van de context, zul je eerder jongerentaal, standaardtaal of dialect gebruiken.
Dit is de taalkast van Ilias. Ilias groeide op in een Franstalige wijk in Brussel, maar volgde op school altijd les in het Nederlands. Zijn vader is van Marokkaanse afkomst; zijn moeder is een Franstalige Brusselse. Na zijn studies in Leuven verhuisde hij naar Antwerpen waar hij ook werkt.
in de voetbalclub in Antwerpen: tussentaal met Antwerps accent + voetbaljargon
als advocaat aan de balie: Standaardnederlands + beroepsjargon
met zijn broer: Frans en Berbers door elkaar
met zijn collega’s: tussentaal
met zijn vader en grootouders: Berbers
met zijn vrienden uit Leuven: tussentaal met Brabants accent
met zijn vrienden van de wijk in Brussel: Frans, jongerentaal
met zijn moeder: Frans
1 Ken je alle taalvariëteiten? Leg de begrippen in je eigen woorden uit.
- standaardtaal:
- tussentaal:
- accent: - jargon:
2 Kun je nog meer rollen of situaties bedenken waarin Ilias een andere taalvariëteit zal spreken?
3 Zal Ilias ook kunnen lezen en schrijven in al die taalvariëteiten? Waarom (niet)?
Spreek jij ook zoveel taalvariëteiten als Ilias? Misschien niet, maar iedereen heeft verschillende taaloutfits in de kast hangen.
4 Vul jouw kast in naar het voorbeeld van Ilias.
5 Bespreek jouw taalkast met die van een medeleerling.
a Heb je veel of weinig taaloutfits? Hoe verklaar je dat?
b Welke taalvariëteit gebruik je het vaakst?
c Welke taalvariëteit spreek je het liefst?
d In welke taalvariëteit lees en/of schrijf je het liefst?
A Uw voedselallergie kan een jeukend exantheem veroorzaken. Ik denk hier niet meteen aan constitutionele eczeem.



B Dat hondje heeft zo’n schattig snoetje. Ik wil hem wel een aaike geven.

E Ik wil gaarne enkele woorden wisselen met u over uw verkering met die deerne.

1 Wie zou de zinnen op p. 311 zeggen? Verbind elk citaat telkens met een afbeelding.
2* Ken je zelf voorbeelden van woorden of uitdrukkingen die eigen zijn aan een bepaalde groep mensen?
3* Gebruik je zelf woorden of uitdrukkingen binnen een bepaalde groep, bijvoorbeeld een sportclub, jeugdbeweging, vriendengroep …?
4 Gebruik je die woorden in elke context?
5 Waarom zouden mensen woorden of uitdrukkingen gebruiken die eigen zijn aan een bepaalde groep?
* Het antwoord op deze vraag hoef je niet te noteren.
Jongeren hebben ook hun eigen taaltje.
1* Welke woorden zou jij wel gebruiken onder leeftijdsgenoten, maar niet tegen je (groot)ouders?
2 Bekijk het lmpje van Supercontent over jongerentaal.
a Welke kenmerken van jongerentaal komen hier aan bod?
b Zijn de woorden in het filmpje nog steeds hip voor jongeren? Hoe verklaar je dat?
Naast jongerentaal heb je ook straattaal.
3 Beluister het nummer Straattaal van Nina. Wat is straattaal wel en wat is het niet, volgens Nina? Leg uit in je eigen woorden.
Noem het geen loze taal
Tis geen gewone taal
Het is geen mode taal
Ik noem het code taal
Het is verboden taal
Tis niet voor show, die taal


Wie verkoopt die taal?
De jeugd ownt die taal
Nina. Straattaal4 Wat is het verschil tussen straattaal en jongerentaal?

In Vlaanderen is het Cités de oudste straattaal.
5 Beluister een fragment uit Kinderen van de migratie over die citétaal en beantwoord de vragen.
a Hoe is citétaal ontstaan?
b Noteer twee kenmerken van citétaal.
Kijk nog eens naar jouw eigen taalkast. Welke taaloutfit/taalvariëteit maakt jou uniek? Kies er eentje uit waarvan je denkt dat je anderen er iets over kunt bijleren, bijvoorbeeld:
- Jij en je vrienden gebruiken een heel levendige jongerentaal.
- Je spreekt thuis een taal die niet veel medeleerlingen kennen, zoals Spaans, Turks, Russisch …
- Je spreekt nog vlot dialect met je ouders of grootouders.
- Na school spreek je straattaal met jongeren uit de buurt.
- Je volgt dictie of speelt toneel: je schakelt zonder problemen over op perfect Standaardnederlands.
- …
Over die taaloutfit maak je een filmpje van minimaal twee minuten waarin jij je kijkers kort de basics aanleert van jouw taalvariëteit. Zo creëren jullie met de klas een eigen YouTubekanaal. Je beoordeelt ook drie filmpjes van medeleerlingen.
Heb je het gevoel dat je taaloutfits grotendeels overeenkomen met die van je medeleerlingen? Dan kun je er ook voor kiezen om een expert uit te nodigen die met jou in gesprek gaat, bv. een grootouder (over zijn/haar dialect), een vriend(in) (over zijn/haar moedertaal) … Belangrijk is wel dat jullie beiden in beeld komen en dat jij de kijker aanspreekt en het gesprek leidt door hem/haar vragen te stellen over de gekozen taalvariëteit.
1 Bedenk een gepaste en originele titel voor je filmpje, zoals:
- Jongerentaal voor boomers
- Spaans leren in … uno, dos, tres!
- Plat kallen voor … generatie Z!
2 Maak een schriftelijke voorbereiding waarin je opschrijft wat je je publiek wilt aanleren. Je zorgt voor minstens tien woorden/uitdrukkingen/tips. Kies voor leuke, handige, grappige voorbeelden, je wilt je publiek boeien.
3 Bedenk een originele opening en slot. Vermijd:
- ‘Ik ben … en ik ga jullie nu wat … leren.’
- ‘Dat was het.’
Start met een opvallende zin in of een opvallende stelling over jouw taalvariëteit.
4 Ga op zoek naar een gepaste plek om je filmpje op te nemen. Je kunt de achtergrond laten aansluiten bij je taaloutfit of kiezen voor een neutrale, formele setting. Zorg er alleszins voor dat je goed verstaanbaar bent en er niet te veel achtergrondgeluiden zijn.
5 De uitleg over de taalvariëteit die je in je filmpje geeft, doe je in standaardtaal. De voorbeelden zijn uiteraard in jongerentaal, straattaal, dialect, vreemde taal … Zorg ervoor dat je je tot de kijker richt en in de camera kijkt.
6 Neem je filmpje op. Dat kan eenvoudig in one shot en met je smartphone, maar je mag naar wens technisch verfijnen: stukjes aan elkaar monteren, bijpassende muziek gebruiken, ondertiteling of een intro/outro toevoegen …
7 Bezorg ten laatste op het filmpje aan je leerkracht via
8 Bekijk de filmpjes van je medeleerlingen.
a Welk filmpje vond je het meest interessant?
b Welk filmpje vond je het meest verrassend?
c Van welk filmpje heb je het meest bijgeleerd?
d Welk filmpje vond je het mooist gemaakt?
9 Gebruik de evaluatiematrix op p. om de filmpjes van drie medeleerlingen te beoordelen.
Je filmpje duurt minimaal twee minuten en bevat minstens tien woorden, uitdrukkingen, tips … over jouw taalvariëteit.
Je filmpje bevat onvoldoende aantal woorden, uitdrukkingen, tips … of is niet lang genoeg.
Je filmpje beantwoordt helemaal niet aan de opdracht.
Je filmpje heeft een gepaste, originele titel.
De titel van je filmpje is weinig origineel.
Het bezorgen van het filmpje was qua timing of locatie slechts gedeeltelijk in orde.
Je gaf je filmpje geen of een ongepaste titel. Het filmpje werd op het gevraagde moment en de gevraagde manier doorgestuurd.
Je spreekt Standaardnederlands.
Je articuleert goed, je spreektempo is niet te snel of te traag en je spreekt voldoende luid.
De kwaliteit van de opname is goed, er zijn geen storende achtergrondgeluiden of -beelden.
De voorbeelden, woorden of tips die je geeft, zijn helder en goed uitgelegd.
Je filmpje is goed opgebouwd en volgt een logische structuur.
Je vertelt op een natuurlijke, spontane en enthousiaste manier.
Je filmpje heeft een originele insteek of aanpak. Je start en eindigt krachtig.
Je filmpje oogt professioneel en je voegde iets extra’s toe.
Aanvullende commentaar:
Je spreekt zo goed als je kunt Standaardnederlands.
Over het algemeen is je filmpje goed verstaanbaar, maar hier en daar kun je nog werken aan je spreektempo of -volume.
De kwaliteit van de opname kan beter, maar de achtergrondgeluiden of -beelden leiden niet af.
Niet alle voorbeelden, woorden of tips die je geeft, zijn helder en goed uitgelegd.
Er zit structuur in je filmpje, maar af en toe wordt die uit het oog verloren.
Je vertelt goed en doet je best, maar je kunt nog groeien in spontaniteit of enthousiasme.
Je hebt de opdracht goed uitgevoerd, maar je hebt weinig eigen inbreng toegevoegd.
Je filmpje ziet er fatsoenlijk uit, maar je hebt niets extra’s toegevoegd om het mooier vorm te geven.
Je stuurde je filmpje te laat door of plaatste het niet op de juiste plek.
Je doet geen moeite om Standaardnederlands te spreken.
Je bent moeilijk verstaanbaar doordat je niet goed articuleert, te snel, te traag of te zacht spreekt.
De kwaliteit van de opname is pover. Je filmpje wordt meermaals verstoord door achtergrondgeluiden of -beelden die afleiden.
Het is vaak onduidelijk wat je bedoelt of de kijker probeert aan te leren.
Er ontbreekt structuur in je filmpje.
Je komt niet enthousiast en ongemotiveerd over.
Je filmpje is weinig origineel.
Je filmpje is qua techniek ondermaats of slordig.
In dit deel vind je enkele veelgemaakte taalfouten. Zo worden er vaak fouten gemaakt tegen het gebruik van hoofdletters.
1 Verbeter de fout(en) en geef een verklaring.
a Van al die nederlandse taalregels krijg ik hoofdpijn!
reden:
Je vindt de theorie over het gebruik van hoofdletters in het Kennisoverzicht op p. .
b In de paasvakantie ga ik naar een optreden van angèle in antwerpen.
reden:
c Ik kijk erg uit naar de Kerstvakantie in december.
reden:
d De mannen uit de Middeleeuwen waren echte Casanova’s.
reden:
e aan de weersvoorspelling te merken, wordt het maandag toch geen aangename lentedag.
reden:
f De oorlog in oekraïne was erg, het doet me een beetje denken aan de Tweede Wereldoorlog.
reden:
g Mijn Papa leest elke dag de standaard, naast De Morgen zijn favoriete krant.
reden:
h Wanneer mijn vader en broer samen op reis gaan naar Havanna, roken ze graag een Havanna.
reden:
Op iDiddit vind je aanvullende oefeningen op het gebruik van hoofdletters.
Ook lidwoorden en (betrekkelijke) voornaamwoorden worden vaak verkeerd gebruikt.
2 Let op de lidwoorden en de voornaamwoorden in onderstaande zinnen. Verbeter de fout(en).
a Sluit je even de gordijn alvorens het klaslokaal te verlaten?
b Het meisje die daar aan de uitgang staat, wil de directeur spreken.
c De chips dat ik meehad naar het feestje, werden door de gasten gesmaakt.
d De museum dat we bezocht hebben, was erg interessant.
e Marie spreekt graag af met de jongen dat ze heeft ontmoet op een feestje vorige maand.
f Ik herinner me de moment dat ik die winnende goal scoorde nog erg goed.
g Vlak voor de brunch begon, legde hij nog snel bloemen op het tafel die al mooi gedekt was door zijn vrouw.
h De jongen legde het cadeau die hij van zijn zus gekregen had meteen op de keukentafel.
Op iDiddit vind je aanvullende oefeningen op het gebruik van het lidwoord en het betrekkelijk voornaamwoord.
Een zelfstandig naamwoord heeft een genus: mannelijk (m), vrouwelijk (v) of onzijdig (o).
• Je gebruikt het lidwoord ‘de’ voor mannelijke en vrouwelijke woorden.
auto (mannelijk) – de auto
grootmoeder (vrouwelijk) – de grootmoeder
• Je gebruikt het lidwoord ‘het’ voor onzijdige woorden. mes (onzijdig) – het mes
Een betrekkelijk voornaamwoord verwijst naar een woord dat er vlak voor staat of een woordgroep die er vlak voor staat. Wat ervoor staat, noem je het antecedent
• Na een het-woord volgt dat. Het geschenk dat (= betrekkelijk voornaamwoord) ik kreeg voor mijn verjaardag was een echte verrassing.
• Na een de-woord volgt die. De bagage die (= betrekkelijk voornaamwoord) niet mee was met de vlucht, werd later naar het hotel gebracht.
Woordenschat: taal van het nieuws
In les 25 stond je stil bij het nieuws. Bij het nieuws op televisie, in kranten en op websites hoort een bepaalde woordenschat.
3 Orden onderstaande woorden in vier groepen. Gebruik voor elke groep een andere markeerkleur.
A woorden die ik nog nooit heb gehoord
B woorden die ik al gehoord heb, maar die ik niet begrijp
C woorden die ik begrijp als ik ze hoor/lees, maar zelf niet zou kunnen gebruiken
D woorden die ik begrijp en die ik zelf in een betekenisvolle zin zou kunnen gebruiken
oorlogSjournalist – peR sconferentie – Autocue – duidIngsprogramma – bEtaalmuur – proDuctiehuis –sItcom – realiTyprogramma – Freelancer – Voice-over
De eerste 5 artikelen hebben we u cadeau gedaan. Ook dit artikel lezen?








Neem nu een abonnement bij NRC Dat is in een paar minuten geregeld.


4 Op de vorige pagina vind je een afbeelding of omschrijving bij de woorden uit opdracht 3.
a Noteer het juiste woord bij elke afbeelding/omschrijving.
b Noteer daarnaast ook een omschrijving van het woord.
5 Als je alle woorden uit opdracht 3 op de juiste plaats hebt gezet in opdracht 4, plak je de vetgedrukte letters aan elkaar. Welk woord bekom je? Weet je ook wat het betekent?
6 Bekijk onderstaande woorden en omschrijvingen.
a Verbind de woorden met de juiste omschrijving. Opgelet: twee omschrijvingen kun je niet gebruiken.
1 hoofdredacteur sVlaamse Radio- en Televisieomroeporganisatie
2 eindredacteur dtijdens de zomer, als het parlement niet aan het werk is en er weinig politiek nieuws te rapen valt
3 komkommertijd v tijdstip waartegen een journalist zijn artikel klaar moet hebben
4 persagentschap o verantwoordelijke voor het eindproduct
5 scoop cbedrijf dat nieuws verzamelt van over de hele wereld en dat tegen betaling doorstuurt naar nieuwskanalen zoals kranten, nieuwsredacties
6 VRT a als eerste een nieuwtje brengen; synoniem voor ‘primeur’
7 VMMa tVlaamse Mediamaatschappij (met o.a. VTM en Q-Music) i informatie overbrengen op een entertainende manier phoofd van de nieuwsdienst, die bepaalt welk nieuws er in het journaal, de krant of het tijdschrift komt en die de taken tussen de journalisten verdeelt
b Welk woord heb je gevormd als je alle letters op de juiste plaats zet? Weet je ook wat het betekent?
c Voor twee omschrijvingen was er geen woord. Kun je zelf het bijhorende woord raden?
7 Plaats de term bij de juiste de nitie.
1 inzettekst ahoofdtekst, de hele tekst van het krantenartikel, zonder koppen, quotes …
2 credit btiteltje bij een deel van het artikel
3 lead cingevoegde tekst bij een groter artikel
4 streamer dinleiding tot het artikel
5 broodtekst enaam van een fotograaf of een andere bronvermelding
6 tussenkopje fquote die vergroot tussen de tekst staat om de aandacht te trekken
8 Bekijk het artikel op de pagina hiernaast.
a Benoem de verschillende onderdelen van het krantenartikel uit opdracht . Noteer het nummer in het artikel.
b Welk van de begrippen uit opdracht zie je niet in het artikel?
Ken je dit fait divers? Het woord krant is afgeleid van het Franse courant, dat ‘gangbaar, actueel, lopend’ betekent.







PODCAST Er lopen gesprekken tussen de VRT en Mediahuis (De Standaard en Het Nieuwsblad ) over een gezamenlijk platform voor Vlaamse podcasts. Ook DPG Media toont interesse.
Een ‘Streamz voor audio’, dat idee lanceerde Koen Verwee, de CEO van Mediahuis (De Standaard, Het Nieuwsblad ) op de eerste dag van het allereerste podcastfestival in Oostende. ‘Moeten we als Vlaamse mediapartners niet nadenken over een Vlaams podcastplatform?’, opperde hij tijdens een debat over podcasts in Vlaanderen. ‘Belangrijk is dat we het platform zelf controleren. Alleen zo vermijden we dat advertentie-inkomsten naar het buitenland vloeien. Tijdens het debat gaf de Vlaamse minister van Media, Benjamin Dalle (CD&V), meteen aan ‘positief te staan tegenover zo’n initiatief’.

Verwee benadrukte in Oostende dat er nog geen uitgewerkt plan op tafel ligt. Maar de openbare omroep, die de laatste tijd ook fors inzette op podcasts, bevestigt wel al dat het over zo’n platform met Mediahuis in gesprek is. ‘Net zoals bij video zijn we op zoek naar slimme manieren om samen te werken rond audio en de markt te versterken’, zegt VRT-woordvoerder Bob Vermeir.
zit. We moeten kijken hoe we die podcastbeleving in Vlaanderen houden.’ Ook voor Verwee is het ‘cruciaal dat alle mediabedrijven, zeker de VRT, van bij de start van de onderhandelingen aan de tafel zitten over een gezamenlijk podcastplatform’. De CEO van Mediahuis ziet brood in een hybride model voor zo’n platform met zowel advertenties als abonnementen. ‘Het is een utopie te denken dat reclame alleen genoeg inkomsten zal opleveren’, aldus Verwee.
Voorlopig zit DPG Media – het moederbedrijf van onder meer HLN, De Morgen, VTM en Qmusic –nog niet mee aan tafel. Al lijkt het een kwestie van tijd vooraleer dat bedrijf ook mee aan tafel schuift. Iedereen lijkt ervoor open te staan. Om te beginnen DPG Media zelf. In Oostende reageerde Steve Van den Audenaerde van DPG Media alvast enthousiast op het voorstel. ‘Wij zijn zeker bereid om te bekijken of een gezamenlijk podcastplatform, mét de steun van de VRT, mogelijk is. We willen mee aan tafel gaan zitten’, zei hij. Na het debat voegde Van den Audenaerde daar nog aan toe dat ‘80 tot 95 procent van de consumptie van podcasts bij Apple en Spotify
Het Vlaams Audiovisueel Fonds (VAF) kent vanaf dit jaar subsidies toe voor de ontwikkeling en productie van podcasts. ‘Audiocreaties zijn de laatste jaren aan een stevige opmars bezig. De podcastsector wordt stilaan volwassen’, zegt de minister van Media Benjamin Dalle (CD&V). ‘Momenteel luistert al één Vlaming op de vier minstens één keer per maand naar een podcast’, voegt directeurintendant van het VAF Koen Van Bockstal daaraan toe. Dit jaar kan het VAF 250 000 euro aan de ondersteuning van podcasts besteden, vanaf 2023 wordt dat 340 000 euro. De mediaminister kondigde dat nieuws in december 2021 al aan, maar vestigde er in Oostende nog eens de aandacht op. Verhalende audiocreaties – zowel fictie als non-fictie – met een langetermijnwaarde komen in aanmerking. De eerste deadline voor projecten die VAF-steun willen, valt al op 12 mei.
Cathérine De Kock
Valerie DroevenBron: standaard.be - 02/04/2022
‘Het is cruciaal dat alle mediabedrijven, en zeker de VRT, van bij de start mee aan tafel zitten’
Koen Verwee, CEO MediahuisDebat op het podcastfestival in Oostende Foto: Christophe De Muynck
Lees onderstaand fragment uit een krantenartikel.
Op een doodgewone zaterdag startte de Franse tiener Mila een ‘live’ op Instagram over make-up en haar kapsel. Tijdens de ‘live’ maakte een jongen die meekeek avances. Mila, toen 16 jaar oud, had geen belangstelling. De jongen reageerde daar boos op. Hij noemde haar ‘een smerige racist’ en ‘een smerige lesbienne’. Mila nam daarna een video op en zette die ook op Instagram. ‘Ik haat religie, de islam is shit. Jullie God kan m’n rug op’, zei ze in het filmpje. En daarna brak de hel los.
‘Ik ontving 200 haatboodschappen per minuut’, zou Mila later zeggen. Ze kon niet meer naar school en kreeg permanente politiebewaking. Het leidde tot een fel debat in Frankrijk over vrijheid van meningsuiting en ook tot een strafzaak.
Er stonden dertien verdachten terecht. Tijdens de rechtszaak zeggen de meesten van hen in een opwelling iets te hebben opgeschreven. ‘De dag erna was ik het alweer vergeten. Ik moest mijn woede kwijt, maar ik zou Mila nooit echt iets hebben aangedaan.’
De rechter veroordeelde uiteindelijk elf mensen tot voorwaardelijke celstraffen van vier tot zes maanden. Ze krijgen daarnaast elk een boete van 1 500 euro. ‘Sociale media zijn de straat’, zei de rechter. ‘Wat je niet op straat doet, moet je ook niet doen op social media.’
Naar: www.hln.be




1 Bespreek onderstaande vragen.
a Het komt wel vaker voor dat er ophef ontstaat nadat iemand zijn mening uit. Ken je zelf voorbeelden?
b ‘De dag erna was ik het alweer vergeten. Ik moest mijn woede kwijt, maar ik zou Mila nooit echt iets hebben aangedaan’, zei een verdachte. Heb je zelf ooit al eens dingen op sociale media gepost die je niet echt meende?
c ‘Wat je niet op straat doet, moet je ook niet doen op social media.’ Ben je het eens met die uitspraak van de rechter?

2 Ben je het eens met onderstaande stelling? Noteer in kernwoorden argumenten voor (pro) en tegen (contra) de stelling.
Vrijheid van meningsuiting moet onbegrensd zijn.
Je leest hieronder een tekst die geschreven werd naar aanleiding van het incident met Mila.
Hoe ‘schuldig’ is een jongere als die een onbezonnen uitspraak doet op sociale media? En hoe kunnen we zaken als deze voorkomen? De vraag stellen is één ding, er een genuanceerd antwoord op formuleren iets anders. De hele kwestie rond Mila raakt aan datgene wat we in onze samenleving als bijzonder kostbaar goed beschouwen: de vrijheid van meningsuiting.
Benedikte Van Eeghem
Het wereldwijde web is ‘the place to be’ voor iedereen die een mening heeft en ze met de wereld wil delen. U doet het misschien, ik doe het sowieso, we doen het in wezen allemaal. Voor zover we niet ‘liken’ of ‘disliken’ wat er op sociale media gebeurt, bepaalt de selectie van wat we (niet) lezen hoe we tegen de wereld aankijken. En: hoe onze mening daardoor gevormd wordt, of we ze nu online gooien of niet.
Zoonlief
Feit is in elk geval dat volwassenen 100 procent verantwoordelijk zijn voor wat ze online posten en poneren. Maar bij jongeren en kinderen ligt het anders. Dat werd ‘bij ons thuis’ recent nog eens duidelijk, toen de jongste een flagrante haatmail ontving van een klasgenootje. Het bericht was verstuurd via de account van de school. In niet mis te verstane woorden stond er te lezen dat de afzender zoonlief niet moest. Het statement werd met een hoop uitroeptekens bevestigd, van een negenjarige, aan een negenjarige. Zoiets komt bij een ouder even hard binnen als wanneer een volgeling van deze of gene religie zijn geloof virtueel beledigd ziet worden.
Digitaal fatsoen
Je zou uiteraard kunnen opwerpen dat een haatmail in schoolcontext peanuts is in vergelijking met een meisje dat een hele geloofsgemeenschap provoceert. Point taken. We spreken over globale impact versus lokale impact. Instagram versus e-mail. Het tweede is stukken makkelijker in de kiem te smoren. Maar los daarvan gaat het wel twee keer om een impulsieve reactie, van (heel) jonge burgers.
Van hen weten we dat ze niet voortdurend weloverwogen beslissingen nemen: kinderen kunnen dat niet, jongeren evenmin. Precies daarom is het aan ons, volwassenen, om onze rol als opvoeder ter harte te nemen en het jonge volk duidelijk te maken hoe je de online discussie voert.
flagrante kluif. Lees: we moeten
Als slachtoffer van zo’n uitval heb je in wezen altijd de keuze. Ofwel ga je voor de frontale tegenaanval, katapulteer je haat in veelvouden terug en haal je desnoods nog wat betrokken partijen over de hekel. Ofwel kies je voor de gematigde respons, overschouw je de context en kaart je het voorval aan bij bevoegde instanties/leidinggevenden. Die laatste piste is de meest intensieve maar ook de meest raadzame. Het gezond verstand laten primeren, zeg maar.
Als we willen dat de ‘Mila’s’ in deze wereld van digitaal fatsoen een erezaak maken, hebben we aan die opdracht alvast een hele kluif. Lees: we moeten de doelgroep de ruimte aanreiken om te mogen blunderen, het krediet om zich te herpakken en de tijd om daar een levenshouding van te maken. Op het web en daarbuiten. Zo investeren we in een (digitale) attitude die de haat niet promoot, uitschuivers correct bijstuurt en iedereen de kans geeft om zich te herpakken. Alleen zo worden van de pot gerukte uitvallen systematisch tot hun ware proporties herleid.
Naar: vrt.be/vrtnws
onbezonnen: onbedachtzaam, ondoordacht, impulsief genuanceerd: waaruit blijkt dat je er goed over hebt nagedacht provoceren: iets doen of zeggen om een reactie uit te lokken in de kiem smoren: iets vanaf het begin bestrijden, iets voorkomen (uitdrukking)
3 We gaan dieper in op een aantal uitspraken uit de tekst.
a ‘Voor zover we niet “liken” of “disliken” wat er op sociale media gebeurt, bepaalt de selectie van wat we (niet) lezen hoe we tegen de wereld aankijken.’ Wat bedoelt de auteur daarmee?
b ‘Als slachtoffer van zo’n uitval heb je in wezen altijd de keuze.’ Verklaar ook deze uitspraak.
c Welke van de twee keuzes die de auteur hier schetst, krijgt jouw voorkeur? Heb je zelf al zo gereageerd?
d Duid nog een zin aan in de tekst die je moeilijk vindt om te begrijpen. Bespreek nadien met een medeleerling of jullie de zin aan elkaar kunnen uitleggen.
4 In de tekst worden enkele Engelse woorden en uitdrukkingen gebruikt. Wat betekenen ze? Leg ze uit in je eigen woorden.
a the place to be
b statement
c peanuts
d point taken
5 Kun je de betekenis van deze woorden uit de context a eiden?
a ‘Feit is in elk geval dat volwassenen 100 procent verantwoordelijk zijn voor wat ze online posten en poneren.’
b ‘(…) toen de jongste een flagrante haatmail ontving van een klasgenootje.’
c ‘(…) zonder publieke vingerwijzing of beschuldiging.’

d ‘Als we willen dat de “Mila’s” in deze wereld van digitaal fatsoen een erezaak maken, hebben we aan die opdracht alvast een hele kluif.’
6 Vat de mening van de auteur in maximaal twee zinnen samen.
7 Ben jij het eens met die mening?
8 Bekijk nu ook de video van KLAAR over vrije meningsuiting. a Vrijheid van meningsuiting is een basisrecht. Wat betekent dat?

b Ken je landen waar dat basisrecht niet geldt?
c Er zijn een aantal beperkingen op de wet op vrije meningsuiting. Welke?
d Gelden online dezelfde regels op vrije meningsuiting?
e Wat zijn moderators?
f ‘Wat je niet op straat doet, moet je ook niet doen op social media.’ Die uitspraak van de rechter in Mila’s proces blijkt in de praktijk niet altijd te kloppen. Welke verschillen tussen ‘de straat’ en ‘online’ worden in de video opgesomd?
9 Zijn de volgende uitspraken van toepassing op de tekst of de video? Zet een kruisje in de juiste kolom.
tekst video
a De inhoud is objectief.
b De inhoud geeft de mening van een persoon.
c De inhoud wil informeren.
d De inhoud probeert te overtuigen.
e Er wordt een oplossing voorgesteld voor het probleem.
f Er worden voorbeelden gegeven.
Stel: een medeleerling postte een racistische uitspraak en beledigde daarbij een van jouw vrienden. Jij vindt dat niet kunnen en je wilt reageren op die post.
10 Vind je een goed argument in de video of de tekst? Zo ja, welk?
UITDAGING: HET DEBAT
Introductie
1 Je bekijkt drie fragmenten. Zijn die volgens jou een voorbeeld van een (goed) debat? Geef telkens een argument waarom je dat wel of niet vindt.
a fragment uit Volt over frisdranken op school
b fragment uit Koppen over een aanrijding
c fragment uit Volt over standaardtaal
2 Formuleer zelf een de nitie voor de term ‘debat’.
3 Wat zijn belangrijke kenmerken van een goed debat volgens jou?
4 Wat is het doel van een debat?
In een debat zijn er twee partijen die het niet met elkaar eens zijn. Beide partijen geven argumenten voor hun standpunt. Ze proberen de argumenten van de andere partij te weerleggen.
Centraal in het debat is het standpunt of de debatstelling. Een goede debatstelling is voldoende controversieel, dat wil zeggen dat er duidelijke meningsverschillen over het standpunt kunnen zijn.
Een debat wordt gevoerd volgens duidelijke regels. Er zijn afspraken over wie er hoe lang het woord krijgt en in welke volgorde. Het debat wordt geleid door een moderator die eventueel hulp kan krijgen van een tijdsbewaker
5 Je leerkracht leest enkele stellingen voor. Ga naar de linkerkant van het lokaal als je het eens bent met de stelling. Ga naar de rechterkant van het lokaal als je het oneens bent met de stelling.
Jullie gaan nu zelf een debat voeren. De leerkracht geeft je drie stellingen die je moet voorbereiden.
6 Je zoekt zowel argumenten pro als contra. Een minuut voor de start van het debat krijg je pas te horen welke kant jij moet verdedigen.
• Let op de betrouwbaarheid van je gebruikte bron.
- Wie is de auteur?
- Is deze betrouwbaar?
- Is deze een autoriteit op het vlak van het onderwerp?
- Wat is de intentie van de auteur? Wil hij mensen overtuigen of informeren of …?
• Bekijk niet enkel de inhoud van de bronnen, maar ook de kwaliteit van de bronnen. Denk na over hoe je in het debat naar de bronnen zult verwijzen. Als je in een debat over energiebronnen de argumenten van vooraanstaande wetenschappers gebruikt, dan zet je dat in de verf.
• Denk na over hoe de tegenpartij jullie argumenten zal proberen te weerleggen.
• Denk na over welke argumenten de tegenpartij zou kunnen gebruiken. Je verzamelt dus eigenlijk al tegenargumenten.
• Oefen het debat al eens met iemand die stevig durft ingaan tegen jouw argumenten.
7 Elke partij bestaat uit drie leerlingen, elk debat duurt drie minuten.
a Je staat recht wanneer je het woord wilt.
b Je mag pas spreken wanneer de debatleider jou het woord geeft.
• Debatteer niet naast de kwestie.
• Val niemand aan.
• Let zowel op je taalgebruik als op je lichaamstaal.
• Om een goed debat te voeren, is het belangrijk om ook op de tegenpartij in te spelen en te reageren op eerder gegeven argumenten (het is niet louter een opsomming van je eigen argumenten, maar een wisselwerking tussen beide partijen).
1 De studiekeuze in het hoger onderwijs moet beperkt worden door de behaalde resultaten en de huidige knelpuntberoepen.
2 Alle steden moeten autovrij gemaakt worden.
3 Het vak Nederlands moet een minimum aantal lesuren per maand spenderen aan literatuur.
4 Ook niet-taalvakken moeten quoteren op spelling.
5 Er moet een instaptoets Nederlandse taalvaardigheid georganiseerd worden: grammatica en spelling met verplichte remediëring voor alle richtingen in het hoger onderwijs.
6 Vlaanderen moet centrale examens/staatsexamens inlassen.
7 Elke schooldag moet er minstens één lesuur ‘bewegen’ op het programma staan.
8 De dienstplicht moet opnieuw ingevoerd worden in België voor zowel mannen als vrouwen.
9 Er moet een Europees leger opgericht worden.
10 Het uitrusten van identiteitskaarten met vingerafdrukken is een schending van de privacy.
volledigheid en duidelijkheid
Je debatteert niet naast de kwestie.
Tijdens het debat vraag je meermaals het woord, je komt voldoende aan bod.
gepastheid
Je taalgebruik is niet kwetsend en/of verwijtend, je speelt op de bal en niet op de man.
Je lichaamstaal is afgestemd op de opdracht. Om het woord te vragen sta je recht, je zit rechtop, leest niet af …
Je onderbreekt geen andere sprekers en je houdt je reacties op wat anderen zeggen onder controle.
Je argumenten zijn deugdelijk en onderbouwd. De argumenten worden op de juiste momenten aangehaald en ook voldoende gekaderd zodat de neutrale partij de relevantie van het argument begrijpt.
Tijdens het debat speel je goed in op de argumenten van de tegenpartij. Je tegenargumenten zijn deugdelijk en onderbouwd.
Aanvullende commentaar:
Niet al je argumenten sluiten goed aan bij de stelling.
Tijdens het debat vraag je meermaals het woord, maar je zegt weinig/onvoldoende wanneer je aan bod komt.
Je taalgebruik sluit grotendeels aan bij de gegeven opdracht.
Je lichaamstaal is grotendeels afgestemd op de opdracht.
Je debatteert naast de kwestie.
Tijdens het debat vraag je zelden/nooit het woord. Wanneer je aan bod komt, zeg je ook onvoldoende.
Je taalgebruik is kwetsend en/ of verwijtend, je speelt op de man en niet op de bal.
Je lichaamstaal sluit niet aan bij de opdracht.
- Je onderbreekt af en toe de andere sprekers.
- Je hebt je reacties op de argumenten van anderen niet altijd onder controle (zuchten, lachen …).
- Je argumenten zijn deugdelijk, maar onvoldoende onderbouwd.
- Je argumenten worden niet op het juiste moment aangehaald.
- De argumenten worden wel op het juiste moment aangehaald, maar er ontbreekt omkadering.
Tijdens het debat speel je voldoende in op de argumenten van de tegenpartij, maar je tegenargumenten zijn onvoldoende onderbouwd.
- Je onderbreekt regelmatig de andere sprekers.
- Je laat je reacties op de argumenten van anderen duidelijk merken (zuchten, lachen …).
- Je argumenten zijn ondeugdelijk.
- Je argumenten zijn niet onderbouwd.
Je speelt zelden/nooit in op de argumenten van de tegenpartij. De tegenargumenten die je gebruikt, zijn ondeugdelijk en/ of onvoldoende onderbouwd.
Zo wordt een taal kapotgemaakt door zgn deskundigen. Het engels is nooit verandert van spelling en gramatica sinds Shakespeare. Nederlands van jaar geleden is daarentegen al moeilijk leesbaar geworden. Als we onze taal willen koesteren en niet compleet willen ver-engelsen, dan moet je ervanaf blijven
Bron: www.hln.be

Als et maar gemakkelijk wordt, vergeet de inspanningen om de taal correct te gebruiken. Ook DT wordt onbelangrijk. #Luiheid en #Taalverloedering!
Kristien Hemmerechts
‘Ons onderwijs heeft een enorme focus op die spelling, het is meetbaar en daar houden we van (...) Er zijn ook zo veel studenten die onze taal pas op latere leeftijd geleerd hebben, natuurlijk hapert er dan wat aan’, aldus Hemmerechts. Maar moet ‘hij word’, in plaats van ‘hij wordt’ dan gewoon kunnen? ‘Ik zeg niet dat de regel moet verdwijnen’, onderstreept Hemmerechts. ‘Maar ik zie het gewoon verdwijnen, voor veel jonge mensen is die dt-regel geen punt meer.’
‘Vooral in Vlaanderen denken we namelijk nog vaak dat we enkel Standaardnederlands mogen gebruiken in formele situaties. Maar we kunnen ons ook wat informeler uitdrukken in Standaardnederlands en dan kunnen we ook vormen gebruiken die we misschien niet zouden gebruiken als we een formele tekst zouden schrijven’, aldus Colleman, linguïst aan de UGent.
Eindtermen 2.0

Schoon schip met d/t? Uitstekend idee!
Geen hond die het snapt en wat ben je ermee?
En leestekens, och, wie bezigt ze nog?
Die kunnen we net zo goed weglaten. Toch?
En rekenen doet je smartphone zo goed dat jij je er niet meer mee pijnigen moet. Wat moeite kost, landt voorgoed aan de kant en wég is bij dezen de leerachterstand!
1 Bekijk de teksten op de vorige pagina.
a Wat is het onderwerp van de tekstfragmenten?
b Wat hebben de tekstfragmenten nog gemeenschappelijk?
c Rangschik de teksten van betrouwbaar naar minder betrouwbaar. Verduidelijk welke criteria je daarbij in acht hebt genomen.
d Kies een tekst waar je het (on)eens mee bent. Schrijf op die tekst een korte reactie van vijf zinnen waarin je jouw visie weergeeft.
Argumentatieve en opiniërende teksten hebben als doel een mening te geven of een idee te ondersteunen of te weerleggen. De schrijver van dergelijke teksten wil de lezer overtuigen door middel van sterke argumenten. Voorbeelden van dit soort teksten zijn reacties op een forum, een column in de krant of een televisiedebat.
Argumentatieve en opiniërende teksten verschillen echter op een aantal gebieden van elkaar. In argumentatieve teksten wordt een stelling of standpunt ondersteund of weerlegd. Dat gebeurt door middel van feiten en degelijk bewijsmateriaal, vaak in een eerder formele stijl. In opiniërende teksten komt de mening of het standpunt van de auteur aan bod. Die wordt ook met argumenten ondersteund, maar die zijn eerder persoonlijk en in een meer informele stijl.
2 Deze types argumentatieve teksten kunnen voorkomen in een tijdschrift of krant. Verbind het teksttype met de juiste de nitie.
1 recensie avaste rubriek waarin een auteur (op vaak humoristische wijze) zijn/haar mening weergeeft
2 opiniestuk buitgebreide tekst waarin een onderwerp uit een specifiek vakgebied wordt ondersteund met aantoonbare feiten
3 column c artikel waarin de auteur zijn/haar mening uitgebreid en eerder zakelijk uitlegt
4 lezersbrief dorale argumentatieve tekst waarin een controversieel onderwerp vanuit allerlei standpunten wordt belicht door verschillende sprekers
5 wetenschappelijke tekst epersoonlijke reactie op een artikel uit een krant of tijdschrift
6 opinieforum ftekst die potentiële klanten overtuigt om een product te kopen
7 mondeling debat g digitale ruimte waarin gebruikers informatie en meningen over een onderwerp uitwisselen
8 advertentie h kritische bespreking van een cultureel product, zoals een toneelvoorstelling, boek of muziekuitvoering 12345678
Het doel van een argumentatieve tekst is om de lezer te overtuigen. Het is dan ook belangrijk dat je dergelijke teksten kritisch leest. Daarom is het slim om met enkele aspecten van de tekst rekening te houden.
• autoriteit van de schrijver
Ga steeds na of de auteur van het artikel kennis van zaken heeft over het aangehaalde onderwerp. Dat kan bijvoorbeeld vanwege zijn/haar functie of affiniteit met bepaalde instituten of onderwijsinstellingen.
• bron of medium
Artikels in kwaliteitskranten of -tijdschriften kunnen vaak als betrouwbaarder beschouwd worden dan bijvoorbeeld een tweet of reactie op een internetforum. Kijk dus steeds vanwaar de tekst afkomstig is.
• kwaliteit van de argumenten
Auteurs van bijvoorbeeld opiniestukken of columns zullen jouw mening proberen te beïnvloeden met argumenten. Wees kritisch en onderzoek de sterkte van hun onderbouwing. Is de informatie juist? Wordt het probleem voldoende uitgelegd? woord
de a niteit: verwantschap, verbondenheid
3 Zoek voor elk teksttype uit opdracht 2 minstens één voorbeeld. Geef titel en auteur en vat vervolgens de inhoud in maximum twee zinnen samen.
Je leest zo meteen de tekst Niet zo positief, alstublief
1 Bekijk de tekst globaal zonder deze tot in detail te lezen en los onderstaande vragen op.
a Welke soort argumentatieve tekst is dit? Waarom denk je dat?
b Welke problematiek bespreekt de auteur?
c Wat is haar mening over die problematiek?
Niet ‘body positivity’ maar wel ‘body neutrality’ zal ons redden van de onzekerheid en zelfhaat, vindt Elisabeth Goemans. ‘Uiterlijk is maar één facet van het hele spectrum van onze identiteit.’
(1) ‘Bloating is normal and should be celebrated’, schreef iemand onironisch onder een Instagrampost deze week. Vanwaar die krampachtige drang om positief te doen over, zoals het citaat zelf al zegt, een volledig normaal menselijk proces? We geven toch ook geen feestje als we de hik hebben? Ik bedoel niet dat een opgeblazen buik of striemen lelijk zijn. Wat ik wel wil zeggen, is dat ze gewoon … zijn.
(2) De post waar ik hierboven naar verwijs, maakt deel uit van een myriade aan ‘body positivity’-berichten die dagelijks op mijn sociale media verschijnen. Goed bedoeld, maar ‘body positivity’ is een medicijn dat enkel symptomen verdoezelt in plaats van de ziekte erachter te genezen. ‘Body positivity’ verandert niets aan onze maatschappijbrede obsessie met uiterlijk, integendeel, het voedt die obsessie alleen maar. Het was een mooie eerste stap naar meer inclusie, dat wel. Maar om echt inclusief te zijn en van de obsessie af te komen, moeten we onze focus verleggen naar wat niet meteen met het oog waarneembaar is.
(3) In tegenstelling tot ‘body positivity’ is ‘body neutrality’ écht voor iedereen: het is namelijk nog steeds gemakkelijker om jezelf te leren accepteren zoals je bent als je uiterlijk dichter aanleunt bij het ene of andere schoonheidsideaal. ‘Body positivity’ is en blijft moeilijker als je niet in de zogezegde ‘one size fits all’-kleding van Brandy Melville past.






(4) Ik zal de eerste zijn om van de daken te schreeuwen dat uiterlijk geen rol speelt in de bepaling van wat een succes- of zinvol leven is. Toch betrap ik mijzelf erop dat mijn verwezenlijkingen op vlakken waar ik wél belang aan hecht regelmatig overschaduwd worden door de hardnekkige gedachte dat als ik niet knap en slank ben al die ‘successen’ niets waard zijn. Doodjammer, want zoveel van de kwaliteiten die we kunnen ontwikkelen en onderhouden, zullen op lange termijn tot minder frustratie leiden dan die constante aandacht voor onze lijn. Hoog tijd voor ‘body neutrality’, dus.
(5) Naast het feit dat meer ‘body neutrality’ zou kunnen leiden tot minder verdriet over onze buikomtrek is het niet ondenkbaar dat het ook op grotere schaal voordelen met zich meebrengt: als je focust op wie je bent in plaats van op hoe je eruitziet, dan is het moeilijk om jezelf nog enkel als individu te definiëren. Anders gezegd: wie we zijn, hangt voor een groot deel af van onze relaties tot anderen. Een mooi mens zijn, wil dan zeggen dat je – ik trap hier open deuren in, dat weet ik – vriendelijk, breeddenkend, medelevend in het leven staat. Als we minder aan geforceerde ‘selflove’ doen terwijl we in de spiegel turen, komt er meer tijd vrij om anderen lief te hebben (en dan gaan we onszelf automatisch liever zien, zeker van).




het facet: een aspect, een kant van een bepaald probleem het spectrum: een verscheidenheid aan verschillende dingen, meningen, objecten … de myriade: enorme hoeveelheid de inclusie: het idee van een samenleving waarin iedereen, ongeacht uiterlijk of afkomst, erbij hoort

(6) Ons lichaam verwensen omdat we op geen van beide Hadidzussen lijken, is uiteraard funest voor ons mentaal welzijn. Maar onszelf dagelijks kushandjes toewerpen voor de badkamerspiegel is niet het enige alternatief. Ik pleit er niet voor om van nu af aan uiterlijk voorkomen volledig te negeren of af te schrijven, wel dat we uiterlijk weer gaan zien voor wat het is, namelijk één facet van het hele spectrum van onze identiteit.
(7) Instagram staat nog steeds op mijn telefoon, ik heb vorige week nog een nieuw zomerkleedje gekocht en een vriendin gecomplimenteerd met hoe ze eruitzag. Dat mag allemaal geen probleem zijn, zolang de VRT NWS-app en Headspace ook binnen handbereik zijn, het grootste deel van mijn budget naar boeken blijft gaan, en ik met mijn kotgenoten het glas hef wanneer ze hun thesis hebben ingediend.

Lees de tekst een tweede keer. Je leest nu het geheel en dringt door tot de volledige boodschap van de
funest: zeer schadelijk

4 Beantwoord onderstaande vragen over de tekst.
a Wat is het verschil tussen ‘body positivity’ en ‘body neutrality’?
b Leg onderstaande concepten en namen uit de tekst uit in je eigen woorden.
• Brandy Melville
• Hadidzussen
• Headspace
5 Onderzoek de betrouwbaarheid van het artikel aan de hand van onderstaande vragen.
a Is auteur Goemans een expert in verband met de problematiek die zij aankaart? Leg uit.
b Wat kun je besluiten over de bron waaruit het artikel afkomstig is? Leg uit.
c Kies een alinea uit de tekst die jij een grote meerwaarde vindt voor het artikel. Kies vervolgens ook een alinea die volgens jou minder goed is. Motiveer voor beide alinea’s je keuze in minstens twee zinnen.
Je maakt kennis met poëzie die de dichtbundel overstijgt en leert wat een stadsdichter doet
Je leert creatief omspringen met de link tussen poëzie en locatie
Je herhaalt een aantal termen (rond rijm, beeldspraak, stijlfiguren) om gedichten te analyseren en drukt je persoonlijke voorkeur uit


1 Lees de onderstaande gedichten.

a Kies je favoriet.


b Verwoord waarom het gedicht je voorkeur geniet.
Witruimte zullen we open witte vlaktes want het lijkt alsof met de poolkappen ook de witruimte in onze bedrukte hoofden verloren gaat
zullen we de stralen van de A niet verzuren tot de schreeuwerige spetters van Leon Van der Neffe dat dit niet de stad van ’t schelden wordt
in al de talen waarin wij hier wonen ontplooien open witte vlaktes want het is in onze sprakeloosheid dat wij elkaar het best verstaan
Bron: Het stad in mij, door Maud Vanhauwaert, uitgegeven bij Das Mag
Ik zie je.
In de lege stoel aan de eettafel. In de winkel waar de rekkenvuller op je lijkt.
Op het familiefeest waar jij altijd de mensen bedient.
Ik zie je.
Ik zie je naast me liggen als ik me omdraai in bed.
Ik zie je overal want ik kan je niet lossen. Je bent nooit echt vertrokken.
Janan Daniels
De zon komt krols uit de fabrieken gerold en spreekt ons met de speelnaam aan. Huizen spuwen boeven en meisjes de straten in.
Ongeduldig trachten wij nieuwe geluiden te fluiten.
Als wij allemaal simultaan in dezelfde richting krachtig niezen, schuift de stad misschien een eindje op.
Nu nog een kant en een allergie kiezen want het is uitstekend weer om een opstand te beginnen, schrijft de krant. Blozend ontbrandt de stad
in miljoenen ontboezemingen. Woest bloed bloesemt in lichterlaaie wanneer wij zomer zaaien in elkaar.
De jarige stad gaat uit plunderen.
De kat trippelt naar huis met een halve muis, ontheemde vogels vallen als vorken aan, een voorbijganger bloeit onhoorbaar uit.
Maarten Inghels, Contact, De Bezige Bij, 2018
De gedichten die je zonet gelezen hebt, zijn allemaal het werk van zogenaamde ‘stadsdichters’. Dat zijn dichters die door een stad of een gemeente worden aangesteld om voor een bepaalde periode gedichten te schrijven over de stad en de gebeurtenissen die er plaatsvinden. Dikwijls krijgen die gedichten dan ook een plaats op openbare plaatsen, en niet (of toch niet in eerste instantie) in een bundel. Nederland kent die traditie al sinds 2001, Vlaanderen (vooral Antwerpen) volgde in 2003.
1 Waar zou jij de gedichten van p. 339 plaatsen in de openbare ruimte?
2 Heeft jouw stad of gemeente een stadsdichter? Zoek het even op.
3 Ben je in jouw stad al poëzie in het openbaar tegengekomen? Zo ja, waar (en eventueel: welk gedicht)?
Je leerkracht toont je waar de gedichten van p. 339 tot leven komen.
4 Wat vind je van de combinatie van jouw favoriete gedicht en de plaats waar het tot leven komt?
5 Je leerkracht geeft je nog wat speci eke vragen bij jouw gedicht.
Als creatieve opdracht ga je nu op zoek naar schoolpoëzie in plaats van stadspoëzie en maken we een poëziewandeling voor de school.
1 Je gaat op zoek naar een gedicht dat jou aanspreekt en dat doet denken aan (een bepaalde locatie op) school. Zorg voor een gedicht uit een gepubliceerde bundel, ga op zoek in je bib.
2 Denk nu na over de plaats waar je het gedicht wilt tonen of hangen. Dat kan de refter, jouw klas, het toilet … zijn.
3 Werk je gedicht ten slotte creatief uit. Het gedicht gewoon printen op een poster volstaat niet!
4 Op een of andere manier moet jouw gedicht tijdens de wandeling worden voorgedragen. Dat kan ‘live’ zijn, maar ook via een geluidsopname of een filmpje.
Bekijk de websites van Maarten Inghels en Maud Vanhauwaert ter inspiratie.
5 Bekijk de evaluatiematrix om na te gaan of je resultaat beantwoordt aan alle criteria.
Evaluatiematrix – Schrijven en spreken: schoolpoëzie
aantrekkelijkheid
- Je hebt het gekozen gedicht gelinkt aan een passende locatie.
- Je hebt duidelijk inzet getoond om tot een creatief resultaat te komen.
Je leest het gedicht expressief voor: goede intonatie, luid genoeg, zonder uitspraakfouten, vlotheid.
Aanvullende commentaar:
Je hebt het gekozen gedicht gelinkt aan een passende locatie, maar je hebt weinig inzet getoond om tot een creatief resultaat te komen (of omgekeerd).
Je leest het gedicht expressief voor, toch kan een van volgende criteria beter: goede intonatie, luid genoeg, zonder uitspraakfouten, vlotheid.
Je hebt het gekozen gedicht niet gelinkt aan een passende locatie en hebt weinig inzet getoond om tot een creatief resultaat te komen.
Je leest het gedicht niet expressief voor, meerdere van de volgende criteria kunnen beter: goede intonatie, luid genoeg, zonder uitspraakfouten, vlotheid.
Al eeuwenlang verlaten mensen vroeg of laat het ouderlijke nest om een eigen nestje te bouwen. Ook jij vliegt ooit uit om je eigen stekje in te richten. Ga je misschien op kot? Of ga je met enkele vrienden samenwonen? Of beslis je om alleen te gaan wonen? Of samen met je lief?

1 Welkom in de wereld van de immosites! Eerst testen we jouw immokennis. Je leerkracht is de quizmaster en zal enkele vragen stellen. Noteer het antwoord op een apart blad. Ben jij de beste immoquizzer?
Alle vogels hebben hun nestjes al gebouwd, behalve jij en ik. Waarop wachten we?
2 Surf nu naar een immosite en ga op zoek naar een studentenkamer die of een klein appartement dat te huur staat. Welke elementen kunnen jouw keuze mee beïnvloeden?
Bewaar de aanbieding die jouw voorkeur heeft. Daarin staan immers nuttige gegevens die je nodig hebt bij de volgende schrijfopdracht. Denk daarbij aan: de site waarop je de kamer / het appartement hebt gevonden, het tijdstip waarop je de advertentie hebt bekeken, wat je precies hebt gevonden …

Je hebt een studentenkamer of klein appartement gevonden. Je gaat nu contact opnemen met de verhuurder via een e-mail. Je wilt de studentenkamer of het appartement huren vanaf september en dit voor een volledig jaar.
Gebruik het schrijfkader hieronder en de evaluatiematrix op p. 344 om de opdracht tot een goed einde te brengen.
Deze is kort en to the point. De ontvanger weet ineens waarover het gaat. Je vermeldt in kernwoorden dat je een studentenkamer wilt huren. aanhef/aanspreking
Beste Geachte + heer / mevrouw + naam
inleidende alinea
In België plaats je geen komma na de aanspreking.
In deze alinea geef je kort de aanleiding van de e-mail en formuleer je een kernmededeling. Je zegt dus waarom je de e-mail schrijft.
Je wilt een studentenkamer huren in die bepaalde stad of gemeente.
Werk in de overige alinea’s de inhoud verder uit. Elke alinea is een thematisch geheel, bestaande uit een kernzin en de uitwerking van die kernzin (zie ook les 10 Formuleren).
§1 Vermeld wanneer en op welke site je de annonce gelezen hebt. Stel je kort even voor en zeg bijvoorbeeld welke studies je wilt volgen of welke job je uitoefent.
§2 Vanaf wanneer wil je de studentenkamer of het appartement huren? Hoelang wil je die/dat huren? Wat bevalt je zo aan die kamer of dat appartement?
§3 Heb je nog bijkomende vragen die niet beantwoord werden in de annonce, dan kun je die hier stellen.
afsluitende alinea
Sluit je zakelijke e-mail af met een duidelijke vraag of wens.
Je hoopt dat de studentenkamer of het appartement jouw nieuwe woonst wordt.
slotformule
Met vriendelijke groet
Met vriendelijke groeten + naam
Er komt geen komma na de slotgroet.
Het gebruikte taalregister sluit aan bij de opdracht.
Het gebruikte taalregister sluit gedeeltelijk aan bij de opdracht. Let op voor:
- informele constructies - te formele constructies
Je taalregister is niet afgestemd op de opdracht:
- Je bent te informeel en/of gebruikt chattaal.
- Je gebruikt te formele constructies voor de gegeven context.
- Je gebruikt een foute aanspreking en/of slotformule.
correctheid en aantrekkelijkheid
De spelling van het eindresultaat is (nagenoeg) foutloos.
Je gebruikt duidelijke en goed afgebakende alinea’s in je e-mail. Die alinea’s zijn correct opgebouwd (kernzin + uitwerking).
De opmaak van de e-mail komt overeen met de opmaak van een zakelijke e-mail.
volledigheid en duidelijkheid
De inhoud van je e-mail werd op een korte en bondige manier neergeschreven. Ook je onderwerpregel is to the point en overtuigend.
De tekst bevat enkele spellingfouten die de boodschap niet in de weg staan.
De tekst is onderverdeeld in alinea’s, maar die alinea’s zijn niet altijd correct opgebouwd.
De opmaak van de e-mail komt grotendeels overeen met de opmaak van een zakelijke e-mail.
- De inhoud van je e-mail is op een kernachtige manier neergeschreven, maar je onderwerpregel is te vaag of niet overtuigend genoeg.
- De kern van de inhoud wordt te laat duidelijk.
De tekst bevat te veel en/of te opvallende spellingfouten.
- De tekst is niet opgedeeld in alinea’s.
- De alinea’s zijn niet correct opgebouwd.
De opmaak van de e-mail komt niet overeen met de opmaak van een zakelijke e-mail.
- De e-mail is te uitgebreid. De kern van de e-mail is niet duidelijk en wordt te omslachtig verwoord.
- Het onderwerp geeft niet weer waarover de e-mail gaat.
- De inhoud van je e-mail is te kort, de ontvanger krijgt niet de nodige informatie.
- De inhoud van je e-mail sluit niet voldoende aan bij de opdracht.
Aanvullende commentaar:
Hoe schrijf je een mail?
Met vrienden en familie communiceer je vaak online. De stijl hierbij is informeel: je gebruikt afkortingen, afbeeldingen en memes, je laat hoofdletters en leestekens weg en je tekst is meestal niet opgebouwd uit alinea’s.
Voor school en later voor je stage of werk moet je soms communiceren met mensen die je niet kent of mensen die een hogere positie hebben. In dat geval maak je gebruik van een zakelijk bericht
Herman Verheijen
Gemiste deadline

Lana T.
Geachte heer Verheijen, Gisteren verstuurde u een e-mail om mij op de hoogte te brengen dat ik de taak over vraagstukken nog niet had ingediend.
Ik heb de opdracht eergisteren voorbereid, maar had deze nog niet ingediend bij u. Dit komt omdat ik mij zeer onzeker voelde over mijn antwoorden op de vragen. Toch wil ik een goed resultaat behalen voor uw vak. Daarom zou ik graag nog even de tijd nemen om mijn antwoorden goed na te kijken alvorens ik ze indien.
Ik begrijp dat dit mogelijk een ongemak voor u zou zijn, maar zou het voor u in orde zijn indien ik de taak vanavond bij u indien? Op die manier heb ik nog even tijd om mijn antwoorden door te lezen en aan te passen waar nodig.
Vriendelijke groeten, Lana
De onderwerpregel in zakelijke mails is kort en duidelijk. Je gebruikt een groep woorden die de inhoud van je bericht samenvat. Leestekens, woordgrappen of dubbele bodems zijn hier niet gepast.
Gebruik als aanspreking Geachte heer of Geachte mevrouw voor mensen die je niet kent. Je kunt de familienaam toevoegen (Geachte heer Demunyck of Geachte mevrouw Franck) of mensen met hun functie aanspreken: Geachte commissaris, Geachte mevrouw de directeur
Gebruik neutrale woorden, blijf altijd beleefd en schrijf positief. Vermijd geklaag, ook als je over een probleem mailt. Stel zelf (haalbare) oplossingen voor en geef aan dat je steeds wilt bellen of afspreken om dingen verder te bespreken.
Bij een mail is het belangrijk dat de tekst kort blijft. Bouw je bericht op uit alinea’s en voeg geen emoticons of memes toe.
Rond je mail op een vriendelijke manier af, zodat je op het einde een positieve indruk achterlaat.
Lees voor het versturen je bericht zeker na, zodat je geen storende spellingfouten laat staan.
Een goede zakelijke mail:
is kort en gericht op oplossingen;
is beleefd, zeker in de aanspreking en afsluiter;
bevat geen spellingfouten, memes of emoticons;
heeft een duidelijke onderwerpregel.
✓ ✓ ✓ ✓
Je kunt een formele tekst, zoals een huurcontract, lezen
Je weet hoe formeel taalgebruik verschilt van informeel taalgebruik
1 De leerkracht overloopt enkele uitspraken.
a Steek je hand op als de uitspraak voor jou waar is.
b Noteer hoeveel procent van de klas de uitspraak bevestigt.
a Ik heb al ooit gebruikersovereenkomsten geaccepteerd zonder ze te lezen (bv. bij het installeren van een app).
b Ik heb al ooit gebruikersovereenkomsten geaccepteerd waarin zaken vermeld werden die ik niet (volledig) begreep (bv. bij het installeren van een app).
c Ik heb al ooit gebruikersovereenkomsten geaccepteerd waarin zaken vermeld werden waar ik het niet mee eens was (bv. bij het installeren van een app).
d Ik heb al ooit een contract/overeenkomst ondertekend waarin zaken vermeld werden die ik niet (volledig) begreep (bv. abonnement van een telecomoperator, arbeidscontract, huurcontract …).

e Ik heb al ooit een contract/overeenkomst ondertekend waarin zaken vermeld werden waar ik het niet mee eens was (bv. abonnement van een telecomoperator, arbeidscontract, huurcontract …).
f Ik heb al ooit een contract/overeenkomst ondertekend zonder het volledig te lezen (bv. abonnement van een telecomoperator, arbeidscontract, huurcontract ...).
2 Waarom werd er volgens jou zo vaak ‘ja’ geantwoord op bovenstaande vragen?
3 Werd jij al ooit geconfronteerd met informatie die op een onnodig ingewikkelde manier geformuleerd werd?
4 Waarom zijn bepaalde documenten/toespraken zo moeilijk geformuleerd volgens jou?
5 Om welke taalvariant gaat het? formeel taalgebruik informeel taalgebruik
6 Geef een de nitie van ‘vakjargon’.
7 Gebruik je zelf vakjargon? Indien ja, kun je dan een concrete context geven?
8 Zijn er situaties waarin een bepaald vakjargon volgens jou noodzakelijk is? Geef minstens één argument.
Proficiat! Je hebt de studentenkamer gehuurd. Je huisbaas bezegelde jullie huurakkoord met een huurcontract.
Je leest enkele fragmenten uit het modelhuurcontract van Kotatgent.
ART. 2: PLAATSBESCHRIJVING


Een gedetailleerde plaatsbeschrijving van het studentenverblijf en de algemene delen is verplicht bij intrede en zal tegensprekelijk tussen partijen worden opgemaakt. Deze plaatsbeschrijving dient te worden gehecht aan deze huurovereenkomst. Bij beëindiging kan op vraag van één van beide partijen de uitgaande plaatsbeschrijving worden opgemaakt. De huurder verbindt er zich toe bij het einde van de huurovereenkomst het studentenverblijf in dezelfde staat als bij aanvang van de huurovereenkomst terug te geven.
De Vlaamse regering stelt een vulgariserende toelichting op, te raadplegen via www.woninghuur.vlaanderen, die informatie bevat over de regelgevende bepalingen met betrekking tot de volgende elementen: (1) de normen van gezondheid, veiligheid en bewoonbaarheid, (2) de aard van een dwingende regel, (3) de schriftelijke huurovereenkomst, de registratie ervan en de regeling van de kosten van de registratie, (4) het belang van een omstandige plaatsbeschrijving, (5) de duur van de huurovereenkomst, (6) de mogelijkheden om de huurprijs te herzien, de indexering, de kosten en de lasten, (7) de mogelijkheden voor de vermindering van de onroerende voorheffing voor huurder, (8) het regime inzake de huurherstellingen, (9) de verplichting van een brandverzekering, (10) de mogelijkheden om de huurovereenkomst te beëindigen, (11) het regime bij een verandering van eigenaar, (12) de mogelijkheden voor de partijen bij een geschil met hun tegenpartij.
1 Duid aan wat van toepassing is. Soms zijn er meerdere antwoorden mogelijk.
a Wat betekent ‘De plaatsbeschrijving zal tegensprekelijk tussen partijen worden opgemaakt’?
Zowel de huurder als de verhuurder maken samen in de studentenkamer een plaatsbeschrijving op.
De verhuurder maakt een plaatsbeschrijving op en de huurder kan hier alsnog wijzigingen aan toevoegen.
De verhuurder geeft de huurder een plaatsbeschrijving en deze laatste dient deze voor akkoord te ondertekenen.
b Een vulgariserende toelichting van de Vlaamse regering:
dienen zowel de huurder als de verhuurder na te leven.
geeft alle mogelijke informatie met betrekking tot wettelijke afspraken bij het huren van een woonst.
kun je steeds raadplegen mocht je twijfelen aan de wettelijkheid van de afspraken die de verhuurder je voorlegt.
De huurder moet het studentenverblijf persoonlijk betrekken. Het verblijf kan enkel gebruikt worden als studentenverblijf, met uitsluiting van elk gebruik voor handels- of beroepsdoeleinden. Het is de huurder niet toegestaan er zijn hoofdverblijf te nemen. Het is de internationale student wel toegestaan om zich in te schrijven op dit adres in het vreemdelingenregister, aangezien de hoofdverblijfplaats in het thuisland behouden blijft. Indien de huurder de bestemming van het goed wil wijzigen, moet hij daartoe de uitdrukkelijke toestemming van de verhuurder hebben.


De huurder verbindt zich ertoe:
het studentenverblijf als een goede huisvader te gebruiken en onmiddellijk de verhuurder te verwittigen indien er zich schade voordoet of dreigt voor te doen. De huurder staat in voor de schade rechtstreeks door hemzelf toegebracht of door anderen aan wie hij de toegang tot het studentenverblijf verleende, voor zover die schade niet het gevolg is van een normaal gebruik.
de verhuurder de toegang tot het studentenverblijf te verschaffen in geval van dringende noodzakelijkheid
zich te onthouden van alles wat de rust van de medebewoners of buren zou kunnen storen, zowel door hem/haar zelf als door derden aan wie hij toegang heeft verleend.
De verhuurder verbindt zich ertoe:



het studentenverblijf zo in te richten dat deze voldoende verlicht, verlucht en tegen geluid geïsoleerd is.
de privacy van de student te respecteren en zich enkel toegang tot het studentenverblijf te verschaffen na voorafgaande en schriftelijke toestemming van de huurder.
er zorg voor te dragen dat in het verblijf een minimale temperatuur haalbaar is van 20° tussen 7u en 24u en van 15° tussen 24u en 7u. Deze regeling is ook van toepassing tijdens de weekends en vakantieperiodes.
tijdens de verhuurperiode geen verbouwingswerken/wijzigingen aan te brengen aan het studentenverblijf die afbreuk doen aan het wooncomfort, de rust en de studiemogelijkheden van de huurder, tenzij dringende herstellingen die de huurder moet gedogen . Indien werken worden uitgevoerd, zullen de aangevraagde verbouwings- of veranderingswerken en de duur duidelijk omschreven moeten worden.
2 Duid aan wat van toepassing is. Soms zijn er meerdere antwoorden mogelijk.
a Wat houdt de uitdrukking ‘als een goede huisvader’ in?
Je neemt verantwoordelijkheid.
Je neemt initiatief als je schade opmerkt.
Je probeert schade te voorkomen.
b Wat betekent de uitdrukking ‘als door derden aan wie de huurder toegang heeft verleend’?
Dit is een groepje van minstens drie vrienden, dat op bezoek komt.
Dit is een bekende die geen huurder, noch verhuurder is, die op bezoek komt.
Dit is bijvoorbeeld de postbode, de pizzabezorger ... die aan de voordeur komt.
ART. 11: OVERDRACHT VAN DE HUUR EN ONDERHUUR
De overdracht van deze huurovereenkomst en onderverhuring zijn toegestaan indien de verhuurder voorafgaand schriftelijk toestemming geeft.
De verhuurder stemt in met de overdracht van deze huurovereenkomst of de onderverhuring aan een student als de huurder aantoont dat hij deelneemt aan een studie-uitwisselingsprogramma of een stage volbrengt. De verhuurder kan zich in dit geval alleen verzetten tegen de overdracht van de huurovereenkomst of de onderverhuring als hij daarvoor gegronde redenen aanvoert. De huurder dient de verhuurder voorafgaandelijk aan de ondertekening van een overdracht van de huurovereenkomst of onderverhuring, in het bezit te stellen van de identiteits- en contactgegevens van de overnemer of onderhuurder, zodat de verhuurder de mogelijkheid heeft te onderzoeken of hij gegronde redenen van verzet kan aanvoeren .
overdracht van deze huurovereenkomst of de
De huurder blijft bij onderverhuring van het goed aansprakelijk ten aanzien van de verhuurder voor het nakomen van de verplichtingen uit deze huurovereenkomst.
3 Wat is het verschil tussen een overdracht van een huurovereenkomst en onderverhuring aan een student? Duid aan wat van toepassing is. Soms zijn er meerdere antwoorden mogelijk.
Bij een overdracht draagt een student de huur over op een andere student.
Bij een overdracht verbreekt de oorspronkelijke huurder de huurovereenkomst.
Na een overdracht blijft de oorspronkelijke huurder verantwoordelijk voor toekomstige onkosten.
Na een overdracht betaalt de oorspronkelijke huurder de huur tot het einde van het oorspronkelijke contract.
Bij onderverhuring betrekt de oorspronkelijke huurder een ander pand.
Bij onderverhuring ontvangt de oorspronkelijke huurder een deel van de huur van de nieuwe student.
Bij onderverhuring vervallen alle verantwoordelijkheden van de oorspronkelijke huurder.
De verhuurder heeft het recht onderverhuring te weigeren.
ART. 12: VROEGTIJDIGE BEËINDIGING VAN DE HUUROVEREENKOMST
Beide partijen kunnen deze huurovereenkomst beëindigen na gezamenlijk akkoord over (cumulatief ):
datum van beëindiging
bezoekmomenten
Deze huurovereenkomst kan door de huurder worden beëindigd in de volgende gevallen:
1° voor de inwerkingtreding van de huurovereenkomst;
2° bij de beëindiging van zijn studie op voorlegging van een bewijsstuk van de onderwijsinstelling;
3° bij overlijden van een van de ouders of een andere persoon die instaat voor het onderhoud van de huurder, op voorlegging van een bewijsstuk.
In het geval 1° is een opzeggingsvergoeding verschuldigd van twee maanden huur als de huurovereenkomst wordt beëindigd minder dan drie maanden voor de inwerkingtreding van de huurovereenkomst. In de gevallen 2° en 3° bedraagt de opzeggingstermijn twee maanden. De opzeggingstermijn neemt een aanvang de eerste dag van de maand die volgt op de maand waarin de opzegging wordt gedaan.
Deze huurovereenkomst wordt van rechtswege ontbonden door het overlijden van de huurder op de eerste dag van de maand die volgt op het overlijden.
De verhuurder kan de huurovereenkomst doen ontbinden als de huurder het goed niet gebruikt conform de bestemming die bij de huurovereenkomst daaraan gegeven is.
Bij het beëindigen van deze huurovereenkomst moeten de sleutels aan de verhuurder bezorgd worden. De verhuurder moet de nodige schikkingen nemen om de sleutel in ontvangst te nemen. De sleutels moeten persoonlijk ‘tegen gedateerd ontvangstbewijs’ aan de verhuurder overhandigd worden. Het studentenverblijf moet ontruimd zijn van goederen van de huurder en in zindelijke staat, zoals bij ingebruikname en in overeenstemming met de plaatsbeschrijving, worden overgedragen.
4 Duid aan wat van toepassing is. Soms zijn er meerdere antwoorden mogelijk.
tegen
a Je studierichting is niet wat je ervan verwacht had. Je hoopte op meer praktijkervaring en stages en je beslist al snel dat je van richting wilt veranderen. Je gaat een praktische richting volgen in een onderwijsinstelling dichter bij huis. De lessen starten op 15 januari. Wanneer zeg je het best je studentenkamer op?
15 oktober
15 november
15 december
b Wat betekent de uitdrukking ‘tegen gedateerd ontvangstbewijs’?
Je schrijft een briefje met de vermelding dat de verhuurder de sleutels van jou kreeg.
De verhuurder schrijft een briefje met de vermelding dat hij de sleutels van jou kreeg en jij ondertekent dit.
Je schrijft een briefje dat je de sleutels aan de verhuurder gaf. Je ondertekent dit beiden en je noteert ook de datum.
c Wat betekent de uitdrukking ‘in zindelijke staat’?
zoals je de woning oorspronkelijk aantrof
netjes en in veilige toestand
opgefrist en opnieuw gedecoreerd
5 Bekijk de vetgedrukte woorden in hun context en duid de correcte verklaring(en) aan. Soms zijn er meerdere antwoorden mogelijk.
a De verhuurder verbindt zich ertoe de privacy van de student te respecteren en zich enkel toegang tot het studentenverblijf te verschaffen na voorafgaande en schriftelijke toestemming van de huurder.
betreden
inspecteren
de ingang repareren
b De verhuurder verbindt zich ertoe tijdens de verhuurperiode geen verbouwingswerken/wijzigingen aan te brengen aan het studentenverblijf die afbreuk doen aan het wooncomfort, de rust en de studiemogelijkheden van de huurder, tenzij dringende herstellingen die de huurder moet gedogen
uitvoeren
accepteren
verdragen
c Deze huurovereenkomst wordt van rechtswege ontbonden door het overlijden van de huurder op de eerste dag van de maand die volgt op het overlijden.
ineens
vanzelfsprekend
volgens de wet
d De verhuurder kan de huurovereenkomst doen ontbinden als de huurder het goed niet gebruikt conform de bestemming die bij de huurovereenkomst daaraan gegeven is.
verlengen – met het comfort
ongedaan maken – in overeenstemming met
laten ingaan – in tegenspraak met
e Beide partijen kunnen deze huurovereenkomst beëindigen na gezamenlijk akkoord over (cumulatief): datum van beëindiging / bezoekmomenten.
slechts eentje is mogelijk
beide zijn mogelijk
beide zijn sowieso van toepassing
f
… zodat de verhuurder de mogelijkheid heeft te onderzoeken of hij gegronde redenen van verzet kan aanvoeren
verhinderen
tegenin gaan
opsommen
6 Welk van de opgegeven woorden past bij de gegeven voorbeelden van de woordspin?
Kies uit:
- dwingende maatregel (in je huurcontract)
- dringende noodzakelijkheid (om het pand te betreden)
- afbreuk doen aan (het wooncomfort)
- gegronde reden (om verzet aan te voeren)
gasgeur


rookpluim bij afwezigheid huurder
lek in het dak de huurder wil hier permanent wonen
waterlek in de studentenkamer
lawaaierige chauffage






















vochtgeur in de woning


gebroken tegels in de badkamer je mag geen handel drijven in je kot
schimmelplekken op de muur
de huurder wil een winkeltje starten in de woonst de huurder wil zijn waarborg
de huurder wil illegaal onderverhuren
niet betalen
je dient een plaatsbeschrijving te ontvangen
je mag geen overbodig lawaai maken
van twee maanden
je betaalt een waarborg






7 Ga op zoek naar het grondwoord en achterhaal zo de betekenis.
a gedetailleerd Welk woord herken je?
b geschil Met welk woord associeer je dit?













c onderverhuring Welke woorden herken je?
d geïsoleerd Welk woord herken je?

8 Plaats de woorden uit opdracht 7 in de juiste zin bij de juiste afbeelding.
In dit studentenhuis wonen veel studenten. Sommigen delen een kot. Misschien doen ze wel aan ?

Deze mensen verschillen van mening. Zij hebben duidelijk een
Deze afbeelding is zo dat je de haartjes vrijwel kunt tellen.
Met de stijgende energieprijzen is het niet slecht om je dak onder handen te nemen. Een goed huis doet zeker de kosten dalen.

Nu je de woorden begrijpt, lees je de fragmenten uit het modelhuurcontract opnieuw.
9 Je krijgt in deze opdracht een aantal cases voorgesteld. Ga op basis van het contract na of de gegeven situaties kunnen of niet. Licht telkens je keuze toe en haal daarvoor bewijzen aan uit de tekst.
Dit kan! Dit kan niet!
a Je hebt de inrichting van je studentenkamer onder handen genomen. Dat oude bed en die krakende kast bracht je naar de kringloopwinkel en je richtte je kot moderner in.
b Na je studies blijf je gewoon op je studentenkamer wonen. Je kent immers de buurt door en door en bovendien valt de huurprijs bijzonder goed mee.
c Het kraantje in de keuken lekt sinds kort. Je kotbaas laat een loodgieter langskomen en wil jou de factuur laten betalen.
d Je kotbaas heeft, terwijl jij naar de les was, de lade van jouw badkamermeubel gerepareerd. Als verrassing heeft hij ineens ook een nieuw ijskastje geïnstalleerd.
e Ook al ben jij de volledige blokperiode niet op je kot aanwezig, toch moet je kotbaas ervoor zorgen dat je studentenkamer warm kan blijven.
f Jouw vriend wil tijdelijk bij jou op kot komen wonen. Aangezien je nog wat ruimte vrij hebt en hij bovendien in de kosten wil delen, ben je bereid een brief naar je kotbaas te sturen. De kans is groot dat jullie binnenkort een tijdje samenwonen.
g Je vriend woont sinds vorige week officieel bij jou mee op jouw kot. Hij liet echter de terrasdeur openstaan. Een windvlaag zorgde ervoor dat die met een smak dichtknalde waardoor het glas verbrijzelde. De huisbaas wil de onkosten nu op jou verhalen.
h Je huurt je studentenkamer vanaf 15 september. Alles is geregeld en betaald. Je krijgt begin juli de kans om vijf maanden als sportmonitor in het buitenland te verblijven, een droom die in vervulling gaat. Hierop beslis je je studies een semester uit te stellen. Je wilt je huurcontract dan ook verbreken.
i Je buurman volgt een kunstrichting. Hij werkt tot laat in de nacht aan zijn projecten en heeft een deel van de gemeenschappelijke ruimte ingericht als zijn atelier. Zijn laatste project is een graffiti-installatie waarin hij ook organische materialen recycleert. Met die installatie wil hij alle zintuigen van de mens prikkelen.
In de loop van het academiejaar leer je heel wat nieuwe vrienden kennen. Joan en Hannah huren een ruim appartement op enkele meters van de faculteit. Hun flatgenoot vertrekt op stage naar het buitenland en zij zoeken een nieuwe medehuurder. Hun appartement is luxueus ingericht en beschikt over twee badkamers, een grote living, vier slaapkamers, een erg ruim terras … en als de kosten gedeeld worden, kom je goedkoper uit dan bij je studentenkamer. Je beslist om je studentenkamer op te zeggen en schrijft een brief naar je huisbaas.
10 Beantwoord ter voorbereiding van je brief volgende vragen.
a Wie is de ontvanger van je brief?
b Wat is het doel van je brief?
c Welke taalregister gebruik je?
Enkele aandachtspunten bij het schrijven van een zakelijke e-mail of brief Hoofdlettergebruik bij het persoonlijk voornaamwoord ‘u’
Het persoonlijk voornaamwoord ‘u’ wordt enkel met een hoofdletter geschreven wanneer er verwezen wordt naar een godheid of een heilig persoon.
Vroeger werd ‘u’ ook met een hoofdletter geschreven wanneer het als aanspreekvorm gebruikt werd, dat is nu niet meer het geval.
Zeer geachte, geachte, beste of dag?
‘Zeer geachte’ wordt ervaren als een zeer formele aanhef, die kan bv. gebruikt worden bij het aanschrijven van een notaris.
Zowel ‘geachte’ als ‘beste’ kunnen gebruikt worden voor een zakelijke standaardbrief, al wordt ‘beste’ doorgaans als minder formeel beschouwd. ‘Geachte’ heeft de voorkeur in een professionele context wanneer een bericht gericht is aan cliënten of derden.
‘Dag’ wordt beschouwd als een informelere aanhef. Die kan gebruikt worden wanneer de ontvanger een bekende is, bv. een naaste collega.
De aanhef wordt telkens gevolgd door ‘mevrouw/heer’ en de naam van de ontvanger (indien deze gekend is).
Hoogachtend of met vriendelijke groeten?
‘Hoogachtend’ en ‘met de meeste hoogachting’ kunnen gebruikt worden bij ‘zeer geachte’ en ‘geachte’ in zeer formele e-mails.
Wanneer ‘beste’ of ‘geachte’ als aanhef gebruikt wordt, gaat de voorkeur uit naar ‘met vriendelijke groet(en)’.
Vermijd archaïsmen
Archaïsmen zijn verouderde woorden of taalvormen. Men kan archaïsmen gebruiken om een bepaald stilistisch effect te bekomen, maar doorgaans maakt het gebruik van archaïsmen een tekst onnodig zwaar.
gemaal, gaarne, de mening toegedaan zijn, dientengevolge … Bijlage
Soms wil je een bestand als bijlage toevoegen aan je e-mail. Verwijs dan in je e-mail telkens naar de bijlage die je meestuurt. Om daarnaar te verwijzen kun je gebruikmaken van ‘als bijlage’, ‘in de bijlage’ (standaardtaal in het hele taalgebied) of ‘in bijlage’ (standaardtaal in België).
In een zakelijke brief verwijs je naar een bijlage met ‘Bijlage: …’
In les 28 op p. 343 vind je een schrijfkader voor een zakelijke e-mail of brief. Vul aan de hand daarvan onderstaand overzicht aan met de inhoudelijke kenmerken van een zakelijke brief. Datum
Voornaam en naam afzender
Straat en huisnummer
Postcode en GEMEENTE
Telefoonnummer afzender
E-mailadres afzender






Voornaam en naam ontvanger (functie en afdeling) (bedrijf/organisatie)
Straat en huisnummer
Postcode en GEMEENTE
De gemeente wordt volgens de NBNnormen in hoofdletters geschreven, zowel in het adres van de afzender als dat van de geadresseerde.
Onderwerpregel: een duidelijke omschrijving van het onderwerp, zonder het woord ‘onderwerp’
Aanhef:
Eerste alinea:
Midden:
Afsluitende alinea:
Slotgroet:
Handtekening
Voornaam Naam
Bijlage:
Je huurt de kamer sinds 15 september en je wilt in februari bij je vrienden intrekken. Hou rekening met de opzegtermijn en kijk in het huurcontract na of je extra kosten dient te betalen. Alex, een student uit je studiejaar, wil je kamer overnemen.
11 Schrijf nu een brief naar je huisbaas (= je leerkracht) en verbreek het huurcontract.
12 Bekijk onderstaande checklist en pas waar nodig je brief aan.
Checklist
Ik heb de NBN-normen correct toegepast.
Ik heb alle noodzakelijke informatie vermeld.
Mijn alinea’s zijn thematisch afgebakend en bestaan uit een kernzin en de uitwerking daarvan.
Mijn taalregister is afgestemd op de opdracht.
Ik blijf steeds beleefd en respectvol in mijn brief.
Ik heb mijn tekst nagelezen op taal- en typfouten.
13 Laat je brief nu nalezen door één van je medeleerlingen en laat hem/haar onderstaande evaluatie invullen.
Peerevaluatie
Je hebt de NBN-normen correct toegepast.
Je hebt alle noodzakelijke informatie vermeld.
Je alinea’s zijn thematisch afgebakend en bestaan uit een kernzin en de uitwerking daarvan.
Je taalregister is afgestemd op de opdracht.
Je blijft steeds beleefd en respectvol in je brief.
Er staan weinig/geen spellingfouten in je brief.
Aanvullende commentaar:



Je leert Ilja Leonard Pfeijffer, zijn schrijfstijl en zijn succesvolle roman Grand Hotel Europa kennen 1
Je denkt na over de maatschappelijke impact van toerisme
3
OP REIS. HEMEL OF HEL?
2
Je beantwoordt vragen op basis van een interview
4
Je analyseert enkele literaire fragmenten
1 Stel je voor dat je onbeperkt mag reizen. Welke keuzes maak je? Duid aan.
BESTEMMINGEN
VERVOERMIDDELEN
2 Hoe zou je jezelf omschrijven als reiziger? Welk type vakantieganger ben jij? ontdekkingsreiziger









3 Lees deze meningen.
‘Seneca fulmineert tegen de misvatting dat men zijn zorgen kan vergeten door op vakantie te gaan. Mensen beseffen volgens hem niet dat hun zorgen hun oorsprong vinden in hun hoofd en dat mensen hun hoofd niet thuis kunnen laten, anders dan op straffe van een definitieve verlossing van hun zorgen. Maar die misvatting en de gewoonte om hersenloos vakantie te willen vieren, waren kennelijk wijd genoeg verbreid om de gestrenge aandacht van Seneca op zich te vestigen.’
a Leg in één zin uit wat de boodschap van deze commentschrijver is.
b Ben je het daarmee eens? Reageer op deze comment.
‘In je zoektocht naar een authentieke en unieke ervaring imiteer je de authentieke en unieke ervaringen van anderen. Als toerist die toeristen wil vermijden, reis je andere toeristen na naar plekken waar zij met succes toeristen hebben vermeden. De implicatie hiervan is dat je haast moet maken, want voor je het weet komen er nog meer toeristen zoals jij op het idee om toeristen te mijden op diezelfde plek en wordt het daar net zo toeristisch als elders.’
c Welk fenomeen wordt hier aangekaart?
d Maak jij graag deel uit van dat fenomeen of vermijd je het liever? Waarom?
Ook veel Europese cultuursteden kreunen onder het massatoerisme.

fulmineren tegen: heftig uitvaren tegen

Voor vele toeristensteden in Europa geldt tegenwoordig het credo: zorg dat we niet worden zoals Venetië. Met het credo ‘zorg dat we niet worden zoals Venetië’ bedoelen andere landen niet dat ze wegzinken in het water, maar verzuipen onder het massatoerisme. Met een toeristentaks hoopt de dogestad het onheil af te wenden. Zal dat werken en, zo ja, wie volgt dan het Venetiaanse voorbeeld?
Venetië kreunt onder haar eigen schoonheid. Op de Rialtobrug, voor het Dogepaleis of op San Marco bijvoorbeeld, krioelt het dagelijks van de toeristen. Is de zon van de partij, wordt het mierennest nog voller. ‘Niemand wil nog zoals Venetië zijn’, schreef onlangs het Spaanse portaal El Confidencial in een artikel over het problematisch geworden massatoerisme. Het Brugge van het Zuiden hoopt echter een pasklare oplossing te hebben: entreegeld. Dat is ‘een maatregel die je nergens anders ter wereld vindt’, stelt burgemeester Luigi Brugnaro.

Wanneer het initiatief in de praktijk wordt gebracht, staat nog niet vast, maar voor Brugnaro mag het deze zomer al ingevoerd worden. Lukt dat, dan moet elke bezoeker aan de Lagunestad dit jaar drie euro betalen. Volgend jaar moet dat bedrag stijgen tot zes euro. Naargelang het seizoen of een uitzonderlijke toeristische overdaad kan dat bedrag oplopen tot acht euro. In ‘luwe’ tijden, daarentegen, valt de entree terug op drie euro. Wie een hotel in de stad heeft geboekt, hoeft de toeristentaks niet te betalen; hij/zij hoest immers al de lokale belasting op.
4 Hoe kijk jij aan tegen massatoerisme?
Nu weet burgervader Brugnaro ook wel dat toeristen niet massaal op de vlucht slaan voor een eurootje meer. Het is hem erom te doen de stad uiteindelijk weer leefbaar te maken, zowel voor de bewoners als de toeristen. De stad moet ‘verdedigd’ worden, zegt hij, opdat zij haar eigenheid kan blijven ademen en ook voor de volgende generaties leefbaar blijft.
De inkomsten van de toeristentaks moeten gebruikt worden voor het in stand houden en proper maken van de historische stad. Brugnaro heeft al diverse telefoontjes gekregen van collega’s uit andere trekpleisters, die willen weten hoe zijn plan er concreet gaat uitzien. Het probleem van toeristische overdaad stelt zich immers ook in steden als Amsterdam, Barcelona of Dubrovnik.
Al die steden zitten tussen wal en schip: enerzijds zorgen toeristen voor flink wat extra inkomsten, anderzijds voor prijsstijgingen en veel, heel veel vuilnis. Behalve de plaatselijke middenstand ergert de plaatselijke bevolking zich met de dag blauwer aan de toeristeninvasies.
Naar: weekend.knack.be



a Is het een zegen voor de lokale overheden of eerder een pest?
b Hou je er zelf van om te vertoeven tussen veel andere toeristen?
c Ben je naar aanleiding van dit artikel van mening veranderd (opdracht 3)? Bespreek klassikaal.


het credo: lijfspreuk, motto krioelen: in een menigte naar alle kanten door elkaar heen bewegen

Je gaat zo meteen aan de slag met Grand Hotel Europa, een lijvig werk van Ilja Leonard Pfeijffer. Reizen en massatoerisme komen prominent aan bod als thema’s.
1 Bekijk de cover aandachtig en noteer op een apart blad binnen één minuut tien woorden die in je opkomen.
2 Spreekt de cover jou aan? Leg aan de hand van twee argumenten uit waarom wel/niet.
Je leest nu een eerste fragment uit het boek.

Fragment 1




Tijdens mijn wandelingen observeerde ik toeristen, om mijzelf te amuseren en omdat het zo goed als onmogelijk was andersoortige mensen te observeren bij gebrek aan hun aanwezigheid. Zoals een kunstschilder schetsjes maakt van de schilderachtige personages die hij in de bar ziet zitten, zo schreef ik in mijn opschrijfboekje kleine impressies van de toeristen die ik op mijn tochten tegenkwam. Ik concentreerde mij daarbij op mijn landgenoten en ik probeerde hen onder te verdelen in verschillende standaardtypen. Ik speelde met de gedachte dat ik mijn reeks toeristentypen misschien zou kunnen verkopen aan een Nederlandse krant of een tijdschrift als Vrij Nederland, bij wijze van amusante zomerlectuur in de periode dat de redacties zaten te schreeuwen om kopij.
Een van de frequentst voorkomende standaardtypen was het zogenaamde horrorgezinnetje met twee of drie kinderen, die de uitvoeringen zijn van hetzelfde model in drie verschillende maten. Zij zijn de Daltons uit Lucky Luke, en goudblond huppelend dissoneren ze met alles wat Italië ooit is geweest of zal worden. Ze roepen vertederingen op bij oude Italiaanse vrouwen. Ze zien hen als engeltjes, al zijn ze in hun ogen nogal slecht opgevoed.
En dat vindt pappa ook. Vanwege zijn belangrijke baan moet hij de opvoeding gedurende de rest van het jaar noodgedwongen overlaten aan zijn vrouw, maar nu heeft hij drie weken de tijd om de nodige feedback te geven en het opvoedingstraject van zijn kinderen op een paar essentiële punten bij te sturen. Fier en energiek loopt hij voorop in een hemelsblauw poloshirt met het logo van een van de toeleveringsbedrijven en zijn kaki kniebroek met praktische, ruime zakken. Hij zal weleens voordoen hoe dat moet, op vakantie zijn. De kinderen waren al bij voorbaat recalcitrant bij de gedachte dat ze drie weken hun PlayStation moeten missen, en tot nu toe overtreft het culturele strafkamp dat vakantie heet hun ergste angstdromen. ‘Laten we die computerspelletjes voor de kinderen maar gewoon meenemen, Jan-Jaap’, had mamma gezegd. ‘Dat maakt het makkelijker. Geloof me. Voor ons is het tenslotte ook vakantie.’ Maar daar had pappa Jan-Jaap niets van willen weten. ‘Deze vakantie doen we op mijn manier, Tineke. Maak je geen zorgen. Jij kunt uitrusten.’
Terwijl ze achter haar gezin aan loopt in haar opvallende, weinig aanstootgevende en op een bepaalde manier zelfs smaakvolle zomerjurk, probeert ze dapper te genieten. En als Jan-Jaap besluit om plaats te nemen op een terras om zijn kinderen bij te brengen dat Ice Tea net zo lekker is als Coca-Cola, lukt het haar voorwaar om een glimlach te veinzen. Ze zou wel een prosecco lusten. Of een wilde cocktail. Maar Jan-Jaap zou dat onverantwoord vinden. Ze bestelt nog een Ice Tea. Tot nu toe verloopt de vakantie rampzalig, maar niet slechter dan verwacht.
dissoneren: niet overeenstemmen
recalcitrant: koppig, ongehoorzaam
veinzen: doen alsof
3 Zo beschrijft Pfeij er nog enkele andere toeristentypes. Hij heeft het over de kookhomo’s, de hysterische italo elen, de blonde roofprinsesjes, de verbeterlanders, de camou agetoeristen, de bibberlanders en de e ciënte nerds.
a Wat valt er op aan zijn schrijfstijl?
b Beschrijf op een apart blad in een vijftiental zinnen een van die toeristentypes. Probeer daarbij zo veel mogelijk de schrijfstijl van Ilja Leonard Pfeijffer aan te houden. Let erop dat je een literaire beschrijving maakt. Markeer het toeristentype dat je zult beschrijven. Kies uit: kookhomo’s – hysterische italofielen – blonde roofprinsesjes – verbeterlanders –camouflagetoeristen – bibberlanders – efficiënte nerds
Je las net een fragment uit Grand Hotel Europa, maar je weet nog niet erg veel over dit boek.
4 Ga op zoek naar concrete informatie over dit werk. Je krijgt vijf minuten om informatie op te zoeken en aan te vullen. Wees dus e ciënt.
• objectieve boekinformatie
• inhoud
• recensies
5 Op de achter ap van het boek lees je volgende informatie. De schrijver neemt zijn intrek in het illustere, maar in verval geraakte Grand Hotel Europa om te overdenken waar het is misgegaan met Clio, op wie hij in Genua verliefd is geworden en met wie hij in Venetië is gaan wonen. Hij reconstrueert het meeslepende verhaal van liefde in tijden van massatoerisme, van hun reizen naar Malta, Palmaria, Portovenere en de Cinque Terre en hun spannende zoektocht naar het laatste schilderij van Caravaggio. Intussen vat hij een fascinatie op voor de mysteries van Grand Hotel Europa en raakt hij steeds meer betrokken bij het wedervaren van de memorabele personages die het bevolken en die uit een eleganter tijdperk lijken te stammen, terwijl de globalisering ook op die schijnbaar in de tijd gestolde plek om zich heen begint te grijpen.
a Wie wordt er bedoeld met ‘de schrijver’?
b Gaat het hier om een autobiografie volgens jou?
c Uit de flaptekst kun je afleiden dat het verhaal zich afspeelt in twee decors. Welke zijn dat? In welke tijd plaats je elk decor?
d In welk decor plaats je het fragment dat je in opdracht 3 las?
e Zou je dit boek graag lezen moest je het in de bibliotheek tegenkomen? Waarom wel/niet? Geef minstens twee argumenten.
Fragment 2 – Nieuwe gasten



Er zijn vandaag nieuwe gasten gearriveerd in Grand Hotel Europa. In weinig andere hotels ter wereld zou men de neiging hebben een hoofdstuk te openen met deze gebeurtenis, maar hier gaat het om de eerste nieuwkomers sinds ik zelf hier mijn intrek heb genomen.
Ooit, lang geleden, bezocht ik tijdens een vakantie het Griekse eiland Kythera. Dat was in de tijd dat ik nog godengrieks studeerde, elke zomer onder de meedogenloze zon door Griekenland reisde en alle andere toeristen, alsmede elk gebouw dat na Christus was neergezet, probeerde weg te denken in een poging een glimp op te vangen van het oude Hellas, waar de taal werd gesproken die ik de rest van het jaar onder lamplicht ontcijferde. Uiteraard had ik geen reisgids nodig om te weten dat Kythera het eiland was waar Aphrodite is geboren uit het schuim van de zee, maar de Lonely Planet, die ik uitsluitend vanwege de praktische informatie in mijn rugzak had gestopt, vermeldde iets anders, wat ik niet wist en waardoor ik zeer door het eiland werd aangetrokken.
Enkele jaren eerder was er op Kythera een referendum georganiseerd over de vraag of er op het eiland faciliteiten moesten worden aangelegd voor toerisme, en bij die gelegenheid hadden slechts twee inwoners vóór gestemd. Niet twee procent, maar twee. De rest was tegen. De Lonely Planet legde ook uit waarom dat was. Een groot deel van de eilandbevolking was naar Australië geëmigreerd. Bijna iedereen die nog op het eiland woonde, had wel familieleden in Australië die regelmatig geld stuurden. Ze hadden de inkomsten die toerisme eventueel zou kunnen genereren niet nodig en konden zich de luxe permitteren om te handelen naar de wijsheid dat toerisme hoe dan ook geweerd dient te worden als je wilt behouden wat je dierbaar is.
Omdat ik in die dagen een typische toerist was die vond dat hij geen toerist was, was Kythera een eiland voor mij. Het was lastig te bereiken. Zelfs in het hoogseizoen gingen er maar twee nachtboten per week vanuit het afgelegen havenstadje Gythion op de Peloponnesos, waarheen Paris Helena had ontvoerd voor zijn door Aphrodite bekokstoofde huwelijksnacht, alvorens vandaar, met haar als buit aan boord, uit te varen naar Troje. En toen ik eenmaal op Kythera was, was het niet gemakkelijk om accommodatie te vinden. Ik huurde een brommertje in Hagia Pelagia, het havenplaatsje waar de veerboot aanlegde en waar verder niets was, en reed naar de andere kant van het eiland, naar de stad Kapsali met de dubbele baai, waar ik uiteindelijk een spartaans kamertje wist te huren.
Er was verder niets te doen op het eiland en binnen een week kende ik iedereen van het handjevol buitenlanders dat net als ik aangetrokken was geweest door de afwezigheid van toeristen en dat net als ik niets te doen had. De grootste en eigenlijk enige attractie was om twee keer per week op onze brommertjes naar Hagia Pelagia te rijden en te gaan kijken naar de twee of drie toeristen die zo naïef waren om op Kythera van boord te gaan. Het was een soort metaramptoerisme. We verkneukelden ons als toeristen bij het zien van de problemen waar andere toeristen tegen aanliepen bij ontstentenis van een infrastructuur en faciliteiten.
Deze herinnering kwam in mij op bij aankomst van nieuwe gasten in Grand Hotel Europa. Hoewel hun komst niet samenviel met het tijdstip van enige maaltijd of tussenmaaltijd, waarop de vaste gasten in een van de zalen beneden werden verwacht, maakte zo goed als iedereen schijnbaar toevallig zijn opwachting in de centrale hal en de belendende vertrekken, en bibliotheekbezoek veinzend, dan wel bladerend in



meedogenloos: zonder medelijden alsmede: en ook het referendum: stemming, rechtstreeks door het volk weren: tegenhouden, verdedigen bekokstoven: stiekem voorbereiden
spartaans: van weinig of geen comfort voorzien (uitdrukking) de ontstentenis: afwezigheid, gebrek belendend: aangrenzend
een dagblad in een van de nieuwe chesterfields voor de schouw onder het portret van Paganini. Ook ik begaf mij naar de centrale hal, ogenschijnlijk met het plan om buiten een sigaretje te gaan roken met Abdul, waarbij het feit dat hij druk in de weer was met een imposante hoeveelheid verse bagage mij het ideale excuus verschafte om de uitvoering van mijn zogenaamde plan uit te stellen en nog even rond te hangen in de hal, waar de nieuwe gasten door Montebello met alle egards werden verwelkomd.
Het betrof een Amerikaans gezin, zo moesten wij allen tot onze teleurstelling vaststellen. Hun tongval verried hun herkomst, en hun herkomst stond in onze ogen garant voor oppervlakkigheid en alles wat wij als Europeanen niet wilden zijn. En een gezin, dat was vaker wel dan niet een in zichzelf gesloten horroreenheid, die al haar energie nodig had voor het verzieken van de onderlinge verhoudingen en geen oog had voor de mogelijkheden die het samenleven met wildvreemden op dit gebied te bieden had, daar hadden we niets aan. Misschien waren we gewoon jaloers. Ik had er niet eerder zo bij stilgestaan, maar Grand Hotel Europa werd bewoond door louter alleenstaanden. De komst van een gezin benadrukte onze celibataire toestand. Het besef dat ik geen enkel recht had om hierin een uitzonderingspositie voor mezelf op te eisen en dat ook ik beschouwd diende te worden als een desolate vrijgezel, stak mij en stemde mij een kort moment intens bitter.
Het enige wat de hoop op een interessante toevoeging aan ons gezelschap levend hield, was dat zij als gezin enigszins atypisch waren. De ouders leken te oud, of hun tienerdochter te jong, om te kunnen spreken van ouders en hun dochter. Dat het grootouders betrof die met hun kleindochter op stap waren, was op grond van hun uiterlijke verschijning een waarschijnlijker scenario. Hij zag eruit als een man die elk moment zou kunnen uitbarsten in een potje golf. Veel was geruit aan hem. Zijn gade had de leiding over de operatie van het inchecken. Haar routine verried dat ze wel meer bestierde. Ze droeg wijde Indiase gewaden, die waarschijnlijk bedoeld waren om haar een jeugdig en vrijgevochten voorkomen te verschaffen, maar die voornamelijk als effect sorteerden dat ze haar omvangrijkheid accentueerden. Onder al dat geflodder huisde een vrouw die goed was in het bakken van appeltaarten.
‘Zou je die arme magere jongen niet even helpen?’ zei ze tegen haar dochter dan wel kleindochter, waarbij ze op Abdul wees, die worstelde met de imposante hoeveelheid bagage die het drietal vergezelde. ‘Je kunt je eigen koffers zelf dragen, Memphis.’
‘Maakt u zich vooral geen zorgen, mejuffrouw’, zei Montebello tegen het meisje. ‘Onze piccolo is er trots op u van dienst te kunnen zijn. U zou hem beledigen als u zijn taak verlichtte.’
Het meisje, dat kennelijk Memphis heette, gaf er de voorkeur aan de majordomus op zijn woord te geloven. Anders dan haar meerderjarige begeleiders was zij het beschrijven waard. Ze was een energiek kauwgumkauwend vampje van de leeftijd waarop ze het huppelen nog niet was verleerd, maar al wel had begrepen dat vrouwen met hun oogopslag gevaar kunnen stichten. Hoewel het niet speciaal warm was, droeg ze hotpants en ze was misschien nog net jong genoeg om in geval van nood onder druk met succes te kunnen volhouden dat ze daar niets mee bedoelde. De potentieel pikante connotaties van dat broekje werden geïroniseerd door grote, lompe, zwarte gymschoenen, waar de veters gemakshalve uit waren gehaald en die niet zouden misstaan aan de zelfverzekerde voeten van een met Rolexen behangen gangster die baas is van de hood. Ze droeg een simpel wit T-shirt met kapmouwtjes, dat was voorzien van de tekst ‘YOLO’, en ik wist wat dat betekende, zo oud was ik nou ook weer niet. De wijze waarop de letters van dit vitale levensmotto werden vervormd door de prangende welving die ze bedekten, maakte een overtuigende en meerderjarige indruk. Haar outfit was gecompleteerd door een baseballpet met zilveren pailletten, die ze droeg met de klep naar voren. Haar blonde paardenstaart was door het gat aan de achterkant getrokken. Haar hele voorkomen had in de context van het oude, voorname Grand Hotel Europa iets paradoxaals, zoals de verschijning van een showballerina op een monumentale begraafplaats. De marmeren zuilen stonden haar stompzinnig aan te staren. De vergulde lambriseringen bladderden van verbazing. Het hoogpolige rode tapijt waarover zij energiek banjerde, bloosde van verlegenheid.

de egards: ontzag, beleefdheid, aanzien desolaat: verlaten
de gade: echtgenoot, echtgenote
de majordomus: hoofd van de huishouding de vamp: verleidelijke vrouw
prangend: klemmend, drukkend
woord



de welving: lichte boogvorm, ronding stompzinnig: dom, dwaas vergulden: met een laagje goud bedekken de lambrisering: houten wandbekleding banjeren: heen en weer lopen

6 Beantwoord de volgende vragen bij het fragment.
a In het eerste fragment beschreef Ilja Leonard Pfeijffer verschillende types toeristen. Welk type toerist zou de protagonist zijn? Bewijs dat aan de hand van concrete informatie.
b Welke paradox merk je op in de uiteenzetting van de protagonist over toerisme? Hoe linkt dat aan wat hij ‘metaramptoerisme’ noemt?
Een paradox is een schijnbare tegenstelling. Het is een stijlfiguur waarbij een schrijver twee elementen samen plaatst die elkaars tegengestelde lijken. Wanneer je echter goed nadenkt over de combinatie, merk je dat de twee elementen toch niet helemaal tegenover elkaar staan.
Schrijven is de kunst van het schrappen
Er is een constante in het leven: alles verandert voortdurend. Zelfs weinig alcohol kan al te veel zijn.
c Welk vertelperspectief herken je in het fragment? Wat impliceert dat voor het verhaal? Is de verteller eerder betrouwbaar of onbetrouwbaar?
d Je wist al dat het boek heen en weer gaat tussen Grand Hotel Europa en de gebeurtenissen in Italië die zich vroeger afspeelden. Ook in dit fragment kun je een flashback onderscheiden. Waar vind je die?
e In literaire werken wordt er regelmatig gebruikgemaakt van een mise en abyme. Daarbij wordt een literair werk afgebeeld binnen een ander literair werk, parallel aan het logo van de beroemde smeerkaasjes van La Vache qui Rit. In de oorbel van de koe wordt die opnieuw afgebeeld. Op welke manier wordt mise en abyme toegepast in Grand Hotel Europa?



f Grand Hotel Europa wordt gekenmerkt door een literaire en beeldende schrijfstijl. Pfeijffer gebruikt vaak beeldspraak om dat literaire karakter te benadrukken. Je leerde al wat een vergelijking, een metafoor, een synesthesie en een personificatie is. Ga op zoek naar een voorbeeld in het fragment.
• vergelijking
• metafoor
• synesthesie
• personificatie
In een interview over Grand Hotel Europa zei Pfeijffer het volgende. Kun je verklaren waarom het de lezers zo aanspreekt?
Lees in het Onthoudenkader op p. de uitleg over beeldspraak.
‘Om te beginnen heb ik er mijn best op gedaan en vind ik het gewoon een goed boek. In Brieven uit Genua nam ik de provocerende stelling in dat het succes van het boek volledig afhangt van het decor. Dát is namelijk wat je je herinnert van een boek: de setting. Ik denk dat dit ook voor Grand Hotel Europa geldt. Ook de maatschappelijke urgentie van het boek draagt bij aan het succes. De toekomst van Europa en het alsmaar groeiende toerisme zijn thema’s die veel mensen bezighouden en waar men zich in kan herkennen. Het hotel is een metafoor voor de richting die Europa inslaat. Als Europa zijn toeristische lotsbestemming blijft volgen, wordt het hele continent een hotel. In een boek dat gaat over oude Europese tradities, wilde ik ook op een literaire manier aanhaken. Het Grand Hotel is een voor de hand liggende echo van De Toverberg van Thomas Mann.’
Bron: magazine.paagman.nl
7 Bespreek klassikaal.
a Ben je het eens met Pfeijffer wanneer hij zegt dat het decor van het boek bepalend is voor het succes ervan? Zou Grand Hotel Europa minder succesvol zijn in een andere setting?
b Vind jij dat Europa tradities kwijtspeelt door toerisme?
Naar aanleiding van zijn boek Grand Hotel Europa is Ilja Leonard Pfeijffer te gast in het programma Van Gils & gasten Bekijk het fragment en beantwoord de volgende vragen.

1 Je ziet zo meteen Ilja Leonard Pfeij er in beeld. Hoe denk je dat de man eruitziet? Beschrijf jouw beeld van hem in vijf woorden.
2* Ken je Van Gils en gasten?
3 Bedenk drie vragen die jij als interviewer zou stellen aan Pfeij er.
4 Welke combinatie maakt van Grand Hotel Europa zo’n goed boek volgens Tom Lenaerts?
5 Lieven Van Gils omschrijft het boek als ‘een raamvertelling’.
a Wat zou hij daarmee bedoelen?
b Aan welke term die je eerder deze les leerde, kun je dit koppelen?
6 Welke persoonlijke vraag van Pfeij er lag aan de basis van de roman? Wat is zijn antwoord?
* Het antwoord op deze vraag hoef je niet te noteren

7 (Massa)toerisme is een belangrijk thema in Grand Hotel Europa. Het verhaal speelt zich niet toevallig af in Venetië. Waarom?
8 Pfeij er stelt dat de toerist altijd de andere is.
a Wat bedoelt hij daarmee?
b Waarom is dit een paradox?
Na het kijken
9* Zijn de vragen die je in opdracht 3 opstelde, beantwoord? Zo ja, zijn er antwoorden die je verrassend vond?

Taal: nieuwe woorden
1 Raad jij snel het gezochte woord? Of schud je nieuwe woorden zomaar uit je mouw? Bewijs jezelf in Begrippen wie beschrijven kan
Woordenschat: betekenisrelaties
2 Plaats de letter van de onderstaande de nities bij de juiste term.
a verschillende woorden met een tegengestelde betekenis
b verschillende woorden met dezelfde betekenis
c dezelfde woorden met een verschillende betekenis
synoniemen antoniemen homoniemen
3 Op de volgende pagina vind je een ingekort fragment uit een recensie. Vul de tabel aan met het antoniem van de gemarkeerde woorden uit het artikel.
scherpzinnig protagonist
liefde klassiek
complex achtergrond
stroef afnemen
traditioneel prequel
prima somber
intern zuur
voortdurend volgen

De Zweedse rechercheur Kurt Wallander, die bekendstaat om zijn scherpzinnige geest en liefde voor klassieke muziek, kennen we in vele gedaanten. Allereerst natuurlijk als de protagonist in de Wallander-boeken van de Zweedse veelschrijver Henning Mankell, waarin hij voortdurend werd betrokken in complexe moordzaken.
Tussen 2005 en 2013 maakte de Zweedse televisie 32 afleveringen van de serie Wallander, met de geweldige Krister Henriksson in de hoofdrol. Hoewel elke aflevering een nieuwe zaak behandelde, werden op de achtergrond de gebeurtenissen in het leven van Wallander doorgenomen: de stroeve verhouding met zijn dochter en het komen en gaan van de vrouwen aan zijn zijde. Per zaak nam zijn vertrouwen in de mensheid af. En in de laatste afleveringen zien we hoe hij afglijdt in dementie en de grip op de wereld verliest.
In 2020, vijf jaar na de dood van Mankell, begon op Netflix de serie Young Wallander. Dat is geen traditionele prequel die zich in de Zweedse jaren zeventig afspeelt. Hoewel de serie zich in het Zuid-Zweedse Malmö afspeelt, vonden de opnames plaats in de Litouwse hoofdstad Vilnius, in hetzelfde sombere winterlicht als aan de overkant van het water.

Neemt niet weg dat Young Wallander: Killer’s Shadow een prima misdaadserie is. De serie begint met een ongeluk dat al snel geen ongeluk, maar een aanslag blijkt. Ondertussen zijn er op het politiebureau intern ook de nodige strubbelingen. Onder meer met de nieuwe chef van Wallander, die hem het leven zuur maakt door hem voortdurend te herinneren aan protocollen – en er is echt geen enkele televisiespeurder die het protocol volgt
Naar: www.volkskrant.nl
In formele communicatie wordt nog geregeld moeilijke of plechtige taal gebruikt. Soms kan dat grappig zijn, maar vaak is het storend.
4 Lees nu de volgende zinnen.
a Welke onderstreepte woorden kun je gewoon weglaten?
b Welke zou je vervangen door een ander woord? Of anders formuleren? Noteer je antwoorden.
weglaten vervangen
a Ik wil langs deze weg iedereen een goede zomervakantie wensen.
b Met behulp van satellietbeelden brachten de onderzoekers in kaart welke leefgebieden van planten het meest worden bedreigd.

c We beantwoorden uw mail betreffende het ongeval zo spoedig mogelijk.
d Ik was niet in de gelegenheid uw mail te beantwoorden.



e Wij hebben tot op heden nog geen betaling ontvangen.
f De dame kon niet langskomen in verband met de regen.
5 Zoek de homoniemen die passen bij de woordverklaringen en vul ze in.
HHETRAPRVSOMM
QJVBLDUIKERKR
ANBOOGPLINCXO
SYHWOEISINUSO
VOEMDARPKLAWS
KWALSXIULEKBX
PKOPFAMNIHRAV
ELRFPLITNGDOL
ZOPPA IJ DEKEGHP
DEPLJSZSECOU IJ
GODHATKORVLNS
IKSALTMROKFUJ
MOLSPQGJANTER
1 het op- en neergaan van water; trilling van licht of geluid
2 sport waarbij je een balletje in een kuiltje moet slaan
1 rand van een schilderij
2 opsomming
3 groep kandidaten die samen aan een verkiezing deelnemen
1 iemand die onder water duikt
2 waterafvoer onder wegen, dijken
1 bloem
2 hoofdhuidontsteking
3 rond mikpunt in schietschijf
1 bevroren water
2 zoete, bevroren lekkernij
1 kledingstuk voor vrouwen
2 deftige, zwarte jas voor heren
1 schop
2 trede om naar boven of beneden te gaan
3 graad van moeilijkheid
1 schietwapen met pijlen
2 deel van een cirkelomtrek
3 ronde overdekking
1 persoon die schepen in en uit een haven brengt
2 berg- of werkplaats
1 gebruik je om uit te drinken
2 hoofd
3 titel boven een krantenartikel
1 neusholte
2 begrip uit de meetkunde
1 aarden versterking om iets heen
2 verdikking onder het oog
1 plek, plaats
2 leesteken
3 stuk taart
1 zeer harde baksteen
2 klank die door de stembanden
voortgebracht wordt, zonder dat de luchtstroom
belemmerd wordt
6 Vul onderstaand diagram aan met de informatie uit de volgende stellingen.
a Zoogdier is een hyperoniem van hondachtige en katachtige
b Panterkat is een hyponiem van katachtige
c Tijger en leeuw zijn op hun beurt dan weer hyponiemen zijn van panterkat
d Wolf is een hyponiem van hondachtige, maar een hyperoniem van poolwolf
e Hondachtige is een hyperoniem van vos
f Vos is een hyperoniem van woestijnvos en poolvos
7 Leg in je eigen woorden uit wat een hyponiem en wat een hyperoniem is. Volgende elementen kunnen helpen: overkoepelend – specifieker ↔ breder – betekenis– woord –begrip – deel uitmaken van
• hyponiem:
• hyperoniem:
1 Hieronder vind je vier stellingen. Welke zijn op jou van toepassing?
a Ik lees graag populaire boeken zoals thrillers, romans … ja nee
b Ik lees graag literaire fictie. ja nee
c Ik leef vaak mee met de personages waarover ik lees. ja nee
d Ik vind boeken lezen nuttig. ja nee
2 Beluister het begin van het audiofragment.
a Wat is het onderwerp?
b Welk type programma is dit? nieuwsuitzending
praatprogramma
fictiereeks
quiz
c Wat is het doel van dit fragment?
overtuigen
informeren
raken
amuseren
3 Beluister vervolgens het volledige fragment en beantwoord de vragen.
a Welke afbeelding past het best bij het luisterfragment? Leg uit waarom.
b Wat is de conclusie van het aangehaalde onderzoek?
Wie meer leest, kan beter met mensen omgaan.
Wie populaire literatuur leest, is vaak gemener.
Wie literaire klassiekers leest, begrijpt de gevoelens van andere mensen beter.
Wie amper leest, heeft geen inlevingsvermogen.
c Welke stelling(en) over het aangehaalde onderzoek is/zijn fout? Duid die stelling(en) aan.
Literaire fictie en populaire literatuur werden allebei onderzocht.


Auteurs als W.F. Hermans en Virginia Woolf kwamen in het onderzoek aan bod.
De onderzoekers denken dat er een oorzakelijk verband is tussen empathie en literatuur, maar ze zijn niet zeker.
Het onderzoek werd eerst uitgevoerd in Italië, maar is al in verschillende landen herhaald.

d Waarom is er een duidelijk verschil in effect tussen literaire fictie en populaire fictie?
De woordenschat in literaire fictie is uitdagender.
De gebeurtenissen in populaire fictie zijn vaak ongeloofwaardiger en roepen daarom minder emoties op.
De personages in populaire fictie maken minder mee.
Literaire fictie bevat meer ‘leegtes’ die de lezer zelf moet opvullen.
e Waarom wordt het onderzoek uit 2013 gezien als controversieel?
Veel mensen geloofden niet dat een stukje tekst op een korte tijd een groot effect kan hebben.
De empathietest was eerder beperkt en daarom niet representatief.
Het onderzoek spreekt andere onderzoeken volledig tegen.
De onderzochte groep van dit onderzoek was niet groot genoeg.
f Verbind het woord met de juiste definitie.
1 simuleren aeffect hebben in afgezwakte vorm
2 correlationeel b de geldende norm
3 maatstaf c nauwkeurig, juist
4 accuraat d nabootsen van bepaalde situaties
5 nazinderen everband tussen twee of meerdere variabelen
g Wat bedoelt de presentator met de uitdrukking ‘de kip of het ei’ in het licht van het aangehaalde onderzoek? Leg uit in je eigen woorden.
h Waarom is literatuur net als een krachtige ‘virtual reality machine’?
i Hoe zou je de onderzoeksvraag ‘Word je een beter mens van literatuur?’ beantwoorden na het beluisteren van dit fragment? Schrijf een genuanceerde visie van minstens vier zinnen.
4 Hieronder vind je vier stellingen. Zijn ze op jou van toepassing of niet? Duid aan.
a Ik heb al eens een schooltaak van een medeleerling overgeschreven. ja nee
b Ik heb al eens een schooltaak door iemand anders laten maken. ja nee
c Ik gebruik Google Translate voor schoolopdrachten. ja nee
d Ik heb al eens teksten van het internet gekopieerd voor een schooltaak. ja nee
5 Lees de tekst op p. 376-377 globaal. Beantwoord vervolgens onderstaande vragen.
a Wat is het onderwerp van de tekst? Vat samen in enkele woorden.
b Wat is de hoofdgedachte van de tekst? Duid die aan in de inleiding.
c Wat is het doel van de tekst? Duid er twee aan.
ontspannen raken overtuigen activeren
d Welk type tekst is dit?
een reclametekst een wetenschappelijke studie een informatiebrochure een opiniestuk
een recensie
e Wie is het doelpubliek van de tekst?
taalleerkrachten leerlingen in het middelbaar onderwijs schooldirecteurs ouders van tieners
6 Lees de tekst een tweede keer. Je leest de tekst nu grondig. Beantwoord vervolgens onderstaande vragen.
a Welke titel is het beste alternatief voor deze tekst?
Hoe ChatGPT jouw teksten kan verbeteren
Waarom leerkrachten ChatGPT moeten omarmen
Hoe werkt ChatGPT?
Waarom leerkrachten geen fan zijn van ChatGPT
b Duid in elke alinea de kernzin aan.
c Waarom zijn de auteurs van het artikel tegen het verbieden van ChatGPT?
De bronnen waarop ChatGPT zijn gebaseerd, zijn gecontroleerd op betrouwbaarheid.
De leerlingen zullen het ondanks het verbod blijven gebruiken.
Rekenmachines en spellingcorrectors zijn ook niet verboden.
Het scherpt het geheugen en de vertelkunst van de leerlingen aan.
d ‘Hoewel best verstaanbaar, bleek zijn bezorgdheid achteraf ongegrond.’ Wat betekent ‘ongegrond’? Leid af uit de context.
e Welke drie strategieën voor ChatGPT in het onderwijs worden aangehaald? Lijst ze op in je eigen woorden, zonder zinnen over te schrijven uit de tekst.
f Wat is de conclusie van het artikel?


Met de aangehaalde strategieën wordt het gebruik van ChatGPT in de klas een succes.
Er moet nog verder onderzocht worden of een totaalverbod van ChatGPT een goede oplossing kan zijn.
Of ChatGPT goed geïntegreerd wordt in de lessen hangt niet alleen af van de leerkracht, maar van meerdere factoren.
ChatGPT zal in de toekomst onvermijdelijk zijn, maar moet daarom niet openlijk goedgekeurd worden.
7 Beantwoord onderstaande vragen over speci eke woordenschat of verbanden in de tekst.
a Welke betekenis drukken de voegwoorden ‘zo (snel) als’ in alinea 1 uit?
oorzaak-gevolg een tegenstelling
een voorwaarde een vergelijking
b Waarvan is alinea 7 een voorbeeld?
een chronologisch verband een conclusie
een tegenstelling een vergelijking
c Hoe verhoudt de laatste alinea zich tot de voorlaatste?
een verklaring een opsomming
een reden een tegenstelling
d Welk van de onderstaande woorden is een synoniem voor ‘obscuur’ (alinea 8)?

ingewikkeld nieuw
onbekend uitgebreid
e Welk van de onderstaande woorden is een antoniem voor ‘gezwind’ (alinea 10)?
makkelijk
met tegenzin
enthousiast moeizaam

Het is alomtegenwoordig in de wereld van het onderwijs: ChatGPT, een onlinecomputerprogramma dat automatisch teksten genereert. Leerkrachten zitten met de handen in het haar want leerlingen dreigen de tool massaal te gebruiken om taken en teksten te maken. Pieter Duysburgh en Rob Heyman van het Kenniscentrum Data en Maatschappij leggen uit waarom en hoe ChatGPT ook een hulpmiddel kan zijn in het klaslokaal.
Pieter Duysburgh en Rob Heyman
Zo snel als ChatGPT de wereld verovert, zoeken onderwijzers en onderwijsinstellingen naar oplossingen om met deze nieuwe technologie om te gaan. Eén oplossing is de gemakkelijkste: een volledige ban van het gebruik van de technologie. Onder meer scholen in New York en Nederland denken hier al hardop over na. Het is een kwestie van tijd voor gelijkaardige stemmen in Vlaanderen opduiken.
ChatGPT is een gratis onlinecomputerprogramma dat alle vragen beantwoordt die je stelt. Het kan ook op commando teksten schrij ven en ingewikkelde rekensommen oplossen. Daarbij doet het aan ‘machine learning’ en traint het zichzelf om beter te worden. Op die manier kan het teksten produceren die amper te onderscheiden zijn van teksten die door mensen zijn geschreven.

Plagiaat




Het is een begrijpelijke reactie: ChatGPT laat immers op een nooit eerder geziene manier plagiaat toe. Het is ongezien, omdat zelfs de gebruiker niet weet uit welke bronnen ChatGPT de info haalt. De oneindige hoeveelheid teksten die de basis vormt van de tekst die ChatGPT creëert, zijn onmogelijk te traceren en dus ook niet op hun juistheid te evalueren. De meeste bestaande plagiaatdetectiesoftware kan nog geen automatisch gegenereerde teksten herkennen. De tool verbieden lijkt dan intuïtief de beste oplossing.
Eén probleem alleen hierbij: ChatGPT valt niet te verbieden zonder een al even onwenselijk niveau van toezicht. Of je de software nu verbiedt of niet, heel wat leerlingen zullen de kans grijpen om de tool in te zetten zodra ze daar de kans toe krijgen. De verleiding daartoe zal onweerstaanbaar sterk zijn, des te meer omdat een slippertje met ChatGPT zo moeilijk op te sporen valt.
Leerinstrument


Misschien zijn er slimmere manieren te bedenken waarop het onderwijs met ChatGPT kan omgaan. De Griekse filosoof Socrates maakte zich al zorgen over hoe het schrift het geheugen en vertelkunst van jongeren zou aantasten.
Hoewel best verstaanbaar, bleek zijn bezorgdheid achteraf ongegrond. Onderwijzers zijn er prima in geslaagd om niet alleen het schrift, maar ook zaken als rekenmachines, spellingcorrectors en Wikipedia een plaats te geven in het leertraject van jongeren. Hoe kan ook ChatGPT een leerinstrument worden dat het leren kan versterken? We geven drie strategieën voor onderwijzers.
Geef leerlingen expliciet de instructie om van ChatGPT gebruik te maken. Laat leerlingen een tekst genereren met ChatGPT en laat hen hierop verder werken. Laat hen toelichten welke ‘prompts’ ze hebben ingegeven. Vraag hen vervolgens te reflecteren op de gegenereerde tekst: waar kan het beter, wat moet anders? Laat hen uiteindelijk een verbeterde versie van de tekst maken op basis van hun eigen reflectie. Leerlingen kunnen zo inzien waarom ChatGPT een lagere beoordeling zou krijgen voor een taak dan wanneer zij zelf de pen zouden vasthouden.
Net als elke andere AI-oplossing, is het algoritme van ChatGPT getraind op informatie die online te vinden is. De meest recente informatie in de database waarop ChatGPT getraind werd, dateert van 2021. Laat leerlingen daarom werken op actuele onderwerpen en obscure thema’s of verplicht hen een minimum aantal recente bronnen in de tekst te verwerken. Moedig hen aan om de input die ze krijgen uit ChatGPT te controleren met andere bronnen.
ChatGPT kan in geen tijd veel tekst produceren, maar de inhoud van die tekst is even vaak wel als niet correct. Tegelijk kan dat ‘hallucineren’ van de technologie best inspirerend zijn. Het kan leerlingen aan ideeën helpen die ze zelf niet konden bedenken, maar vaak zullen ze zelf het best in staat zijn die ideeën te weerhouden die écht waardevol zijn. Of ze kunnen op deze ideeën verder bouwen. Laat een brainstorm starten met ChatGPT en push hen vervolgens om het algoritme te verslaan en écht creatief te zijn.
Deze strategieën lossen niet alle uitdagingen op. Niet elke leerkracht zal even gezwind de mogelijkheden die ChatGPT biedt in een educatieve richting kunnen sturen. Bijscholingen, afsprakenkaders en software die op een slimmere manier plagiaat kan detecteren, zullen nodig zijn.
Toch moeten we er nu al van uitgaan dat ChatGPT een onvermijdelijke blij ver is in de toekomst. Aan ons om die toekomst op de beste manier vorm te geven. Bron:
1* Denk na over je eigen toekomst. Wat zou jij willen bereiken voor de leeftijd van 18, 25 en 34 jaar? Som minstens twee dingen op per leeftijd.
2* Bespreek je antwoorden met die van een medeleerling en identi ceer de grootste gelijkenissen en verschillen.
3 Lees het artikel uit Ze willen allemaal hetzelfde op de volgende pagina.
a Rond welke leeftijd hopen tieners voor het eerst moeder of vader te worden?
b Welke andere droom hebben ze voor diezelfde leeftijd uit vraag a?
c Welke meningen hebben verschillende leeftijden over de ideale pensioenleeftijd?
4 Bestudeer de infographic bij het artikel. Beantwoord onderstaande vragen in sleutelwoorden.
a Wanneer denken jongeren het hoogtepunt van hun carrière te beleven?
b Welke plannen hebben veel jongeren tussen hun 23e en 25e levensjaar?
c Hoeveel jaren zitten er ongeveer tussen het eerste kind en het laatste kind?
5 Vergelijk het artikel Ze willen allemaal hetzelfde met de infographic. Benoem een sterkte en een zwakte voor ieder teksttype.
Of het nu om meisjes of jongens gaat, om hoog- of om laaggeschoolde jongeren: bijna allemaal willen ze dezelfde toekomst, waarin op relatief jonge leeftijd plaats wordt geruimd voor het samenwonen met een partner (24 jaar), de aankoop van een huis of appartement (25 jaar), het eerste kind (26 jaar) en een trouwpartij (ook 26 jaar). Dat blijkt uit een grootschalige enquête van het Jeugdonderzoeksplatform (JOP), een samenwerkingsverband tussen diverse disciplines van de Universiteit Gent, de Vrije Universiteit Brussel en de KU Leuven. (…)
Jongens zijn haantje-de-voorste wat betreft het eerste seksuele contact en het autorijbewijs halen. Maar het verschil is niet erg groot met meisjes: bijna iedereen ziet de ideale leeftijd voor de eerste seks rond 17,5 jaar en het rijbewijs behalen op 18 jaar of iets later. (…)
Opvallend is dan weer dat de jonge mannen en vrouwen in deze enquête de ideale pensioenleeftijd gelijktijdig situeren. Gemiddeld ziet men die rond de leeftijd van 60 jaar. Dat is twee jaar later dan de ideale pensioenleeftijd die jongeren in ander onderzoek, uit 2005, naar voren schoven. De aanhoudende berichten in de media dat we langer moeten werken, blijken dus impact te hebben.
Wie jonger is, denkt er wel anders over dan de wat oudere jongeren: op 14-jarige leeftijd wil men werken tot zijn 61e. Op 30-jarige leeftijd, als men al enkele jaren werkervaring heeft, oordeelt men dat het op 58- of 59-jarige leeftijd welletjes zal zijn geweest.
Jongere tieners denken ook dat ze het toppunt in hun carrière al heel vroeg zullen bereiken: al op de leeftijd van 33 jaar. Wie tegen de 30 aanloopt, schuift dat hoogtepunt op naar de leeftijd van 38 jaar. Maar dat is dan ook zowat het enige grote verschil in de ideale levensloop.
Bron: standaard.be - 25/03/2010

Jongens zijn haantje-devoorste wat betreft het eerste seksuele contact en het autorijbewijs halen.
6 Bestudeer de infographic Voorlezen aan de allerjongsten op p. 381 en beantwoord de bijhorende vragen.
a Combineer de stukken tekst uit de infographic met de juiste titels. Kies uit de volgende mogelijkheden:
a Slimme investering
b Welzijn van ouder en kind
c Gereedschap voor later
d Uniek taalaanbod
e Ieder kind gelijke kansen
f Het talige brein: volop in ontwikkeling
g Uitnodiging tot interactie
b Wie is het doelpubliek van de infographic? Waarom?
c Waar zou je deze infographic kunnen terugvinden?
a socialemedia-account van een moeder
b lokale bibliotheek
c artikel in De Standaard
d website van een boekenwinkel
d Leg de afbeelding bij punt 1 in je eigen woorden uit.
e Leg de afbeelding bij punt 7 in je eigen woorden uit.
f Hoe zou je deze infographic beter kunnen maken? Formuleer minstens twee suggesties.
7 Analyseer enkele voorbeelden van infographics hieronder.





a Vat in maximum twee zinnen samen waarover ze gaan.



b Zijn het goede of slechte voorbeelden? Geef minstens twee argumenten. Gebruik volledige zinnen.



8* Lees jij wel eens digitale boeken? Wat zijn mogelijke voor- en nadelen van digitale boeken?
9* Luister jij wel eens naar luisterboeken? Wat zijn hiervan mogelijke voor- en nadelen?
Lees de tekst Digitale boeken voelen anders dan fysieke boeken op deze en volgende pagina.



10 Markeer belangrijke informatie.
11 Bekijk je gemarkeerde informatie in de tekst. Bepaal welke informatie je onder dezelfde thema’s of categorieën kunt onderbrengen. Werk met sleutelwoorden in plaats van volledige zinnen.
12 Maak een eerste basisversie van je infographic op een apart blad. Denk eerst na over de juiste indeling. Vervolledig vervolgens de infographic met de informatie uit opdracht 11.
13 Bepaal voor elke categorie welke informatie je kunt vervangen door een pictogram of afbeelding.

14 Werk vervolgens een gedetailleerde infographic uit. Je kunt een infographic in posterformaat op papier maken. Nog handiger is om een digitale infographic op te stellen.
E-boeken ontberen de tastzin en het knispergenot van papier. Dit lijkt nadelen te hebben voor de verwerking van de tekst. Dit speelt minder bij de e-readers dan bij de tablet.
Papier bezit volgens Mangen (2008) fysieke eigenschappen die helpen bij het lezen en interpreteren van de tekst. De pagina’s van het gedrukte boek zijn tastbaar, ze knisperen tussen de vingers, de lezer slaat ze om en ruikt ze zelfs. Het gevoel dat papier geeft, helpt zodoende om een relatie met de tekst op te bouwen. Daarnaast maakt de fysieke vorm (lengte, breedte, dikte) van een boek, magazine of krant het eenvoudig om de resterende leestijd in te schatten. Tot slot is een tekst op papier stabiel ten opzichte van de pagina. Dit helpt om de informatie te onthouden aan de hand van het visuele tekstbeeld (Mangen, 2008).
E-readers, tablets, computers en smartphones bieden volgens Mangen (2008) een andere tactiliteit. In plaats van de wereld achter de tekst zichtbaar te maken, vestigen het scherm en de muis de aandacht op zichzelf. De handeling van het surfen en klikken treedt op de voorgrond, wat onze relatie met de inhoud van de tekst en de wereld van het verhaal verbreekt.
Lezers van e-boeken voelen en zien bovendien enkel de pagina die ze op dat moment aan het lezen zijn. Ze ontberen een indruk van de omvang en de lengte van de tekst, wat het inschatten van de leestijd en de oriëntatie in de tekst bemoeilijkt. Tot slot laten lettergrootte en -type in e-boeken zich eenvoudig aanpassen. Het gevolg is dat het tekstbeeld verschuift en de tekst instabiel wordt ten opzichte van de drager. Hierdoor is de informatie minder makkelijk te onthouden (Mangen, 2008).
Empirisch onderzoek levert voorzichtig bewijs voor deze ideeën. Lezers van een e-boek of kortverhaal op de tablet gaan minder diep op in de verhaalwereld (Van Gils, Bakker & Evers-Vermeul, 2020; Mangen & Kuiken, 2014). Hiernaast blijken ze het verhaal minder grondig te onthouden (Mangen & Kuiken, 2014). Vergelijkbare verschillen zijn gevonden bij jongeren: 15-jarigen die een kortverhaal lezen op papier, begrijpen het diepgaander dan op de personal computer (Mangen,

Walgermo & Brønnick, 2013). Bovendien boeken 15-jarigen die gedrukte boeken lezen sterkere leesprestaties dan leeftijdgenoten die digitale boeken lezen (OECD, 2021). Deze resultaten suggereren dat de eigenschappen van digitale tekstdragers inderdaad minder gunstig zijn voor de leeservaring en het tekstbegrip dan die van het papieren boek.


Tegelijkertijd wijst onderzoek onder basisscholieren uit dat zij de tekst even diepgaand begrijpen van papier en van het scherm (Nielen, 2016). Hiernaast zijn de verschillen bij de e-reader geringer dan bij de tablet en personal computer. Zowel de leeservaring als het tekstbegrip blijken nagenoeg gelijk tussen het gedrukte boek en de e-reader (Schwabe et al., 2019; Mangen, Olivier & Velay, 2019; Bakker, 2021). Lezers van de e-reader zijn wel minder sterk in staat om de gebeurtenissen in het verhaal in de volgorde te zetten waarin deze zich hebben voorgedaan. Dit duidt mogelijk op uitdagingen met het zich kunnen oriënteren (Mangen, Olivier & Velay, 2019).
Tekstlengte, zelfinschatting en ervaring Verschillen in begrip tussen papier en scherm treden in het bijzonder aan het licht bij teksten die langer zijn dan ongeveer een pagina in een tekstverwerkingsprogramma. Dit komt mogelijk doordat er in langere teksten meer scrollen plaatsvindt, met hogere cognitieve eisen tot gevolg (Singer & Alexander, 2017). Tevens zijn er


verschillen gevonden tussen papier en scherm in het inschatten van de prestatie op de taak. Digitale lezers denken sterker te presteren dan dat ze in werkelijkheid doen, investeren hierdoor waarschijnlijk minder energie in het lezen, en begrijpen de tekst als gevolg minder diepgaand (Singer, Alexander & Berkowitz, 2019).
Het zou kunnen dat de leeservaring en het tekstbegrip groeien naarmate de ervaring met lezen van het scherm groeit. Empirisch onderzoek laat voor deze voorspelling uiteenlopende resultaten zien. Aan de ene kant blijkt een sterke bedrevenheid in het lezen van e-boeken positief samen te hangen met een prettige en optimale leeservaring (Bakker, 2021). Aan de andere kant leidt bij brugklassers die ervaring hebben met lezen van de tablet, het lezen van een kort verhaal op de tablet tot minder onderdompeling dan het lezen van hetzelfde verhaal van papier (Van Gils, Bakker & Evers-Vermeul, 2020). Bovendien blijkt het verschil in tekstbegrip tussen de beide media, in het nadeel van het scherm, groter voor meer recente onderzoeken. Dit suggereert dat meer ervaren schermlezers de tekst minder diepgaand begrijpen (Delgado et al., 2018). Tot slot hangt het frequent lezen van korte teksten van het scherm negatief samen met de aandacht voor en onderdompeling in een literair verhaal (Hakemulder & Mangen, 2021).

Bron: Stichting Lezen - www.lezen.nl


Een klinker is kort in bot, man, pen, win en kus Een klinker is lang in boot, maan, geen, biet, kuur en boek
Een gesloten lettergreep eindigt op een medeklinker. De klinker in die lettergreep noemen we een gedekte klinker bot-ten, win-nen, kus-ten
Er zijn vijf gedekte klinkers of korte klinkers man, cel, wil, hol, kus
Korte klinkers komen alleen voor in gesloten lettergrepen. bot, bot-ten
Dit zijn de tweeklanken: ei/ij, au/ou, ui. ai, oi, aai, ooi, oei, eeuw en ieuw zijn in feite combinaties met de klanken j of w. reis, lijst, pauw, oud, trui

Een open lettergreep eindigt op een lange klinker of op een tweeklank. bo-ten, reu-zen, lei-den
Lange klinkers en tweeklanken komen voor in open en gesloten lettergrepen. boot – bo-ten, reus – reu-zen, kruin – krui-nen
• Zelfstandige naamwoorden benoemen personen, zaken, begrippen … Je kunt er altijd een lidwoord voor zetten.
de jongen, de stoel, de liefde
• Bijvoeglijke naamwoorden geven meer informatie over een zelfstandig naamwoord.
een lief meisje, de zachte stof, het mooie huis
• Lidwoorden staan altijd voor een zelfstandig naamwoord. bepaald lidwoord de, het onbepaald lidwoord een
• Bijwoorden geven meer informatie over een werkwoord, een bijvoeglijk naamwoord, een ander bijwoord of een hele zin.
Je beweegt houterig.
Het is een erg leuke les.
Je praat heel grappig
Ik kom zeker
• Telwoorden zijn woorden die een aantal of een volgorde weergeven. twee, zeven, honderd (aantal) tweede, tiende, laatste (volgorde)
– Hoofdtelwoorden geven een aantal of nummer aan.
Een atletiekbaan heeft een lengte van vierhonderd meter. In de tijd dat ik vijftien rondes loop, loopt mijn vriendin er achttien
– Rangtelwoorden geven de rangorde of plaats in een reeks aan. Hij eindigde op de vierde plaats, maar zijn vriendin op de eerste
• Voegwoorden verbinden zinnen en zinsdelen met elkaar en drukken een bepaald verband uit. en, maar, omdat, als, wanneer, hoewel, terwijl
• Voorzetsels drukken de relatie uit tussen de woordgroep waar het voorzetsel deel van uitmaakt en een ander element in de zin.
in, aan, van, door, tussen, uit, op, boven, onder, over, mee, voor
• Voornaamwoorden verwijzen naar iets of iemand. Het zijn korte woordjes; om te weten over wie of wat ze gaan, heb je andere delen uit de tekst nodig. Er zijn acht soorten:
persoonlijk voornaamwoord ik, jij, hij, wij, jullie, zij, mij, jou, hem, haar, ons bezittelijk voornaamwoord mijn, jouw, zijn, haar, onze, jullie, hun aanwijzend voornaamwoord die, dat, deze, dit, degene, hetzelfde vragend voornaamwoord wie, wat, welk(e)
wederkerend voornaamwoord hij wast zich, wij scheren ons wederkerig voornaamwoord wij zien elkaar, we houden van mekaar betrekkelijk voornaamwoord het meisje dat daar loopt, de jongen die zingt onbepaald voornaamwoord men, ieder, alles, iets, iemand, sommige
• Werkwoorden
Een werkwoord geeft een handeling of een toestand aan. Het drukt uit hoe het onderwerp van een zin eruitziet, wat het onderwerp doet, hoe het onderwerp zich voelt …
stralen, studeren, hopen
Persoonsvorm
In een goed gebouwde zin staat altijd een persoonsvorm (pv). De persoonsvorm geeft de tijd en het getal aan.
Ik voetbal graag in open lucht.
De persoonsvorm is voetbal, en staat in de tegenwoordige tijd (= tijd) en in het enkelvoud (= getal).
Zijn vrienden voetbalden vroeger enkel in de zaal.
De persoonsvorm is voetbalden, en staat in de verleden tijd (= tijd) en in het meervoud (= getal).
Tussen de persoonsvorm en het onderwerp van een zin is er congruentie. Dat wil zeggen dat het onderwerp en de persoonsvorm hetzelfde getal hebben.
Hij luistert met veel aandacht naar de leerkracht.
Het onderwerp en de persoonsvorm staan beide in het enkelvoud.
Wij luisteren met veel aandacht naar de leerkracht.
Het onderwerp en de persoonsvorm staan beide in het meervoud.
Infinitief
De onvervoegde vorm van het werkwoord is de infinitief. De infinitief vind je in het woordenboek en eindigt meestal op -en.
Stam
De stam van een werkwoord krijg je door de infinitief zonder -(e)n te nemen. werken (= infinitief) werk (= stam)
Voltooid deelwoord
Een andere vorm van het werkwoord is het voltooid deelwoord
Zij heeft in de tuin gewerkt
Hij heeft met de poppen gespeeld
Er zijn drie soorten werkwoorden: zelfstandige werkwoorden, hulpwerkwoorden en koppelwerkwoorden
Een zelfstandig werkwoord bevat op zichzelf de betekenis van het werkwoordelijk gezegde.
Mijn leerlingen lezen geregeld een boek.
Het zelfstandig werkwoord kun je niet weglaten in de zin. Soms zijn er extra werkwoorden in de zin.
Mijn leerlingen hebben dit jaar een boek gelezen
Het zelfstandig werkwoord is lezen
Hebben is in deze zin het hulpwerkwoord
Soms kunnen er verschillende hulpwerkwoorden in een zin staan. Mijn leerlingen willen soms blijven lezen
Willen en blijven zijn hulpwerkwoorden.
Lezen is het zelfstandig werkwoord.
Veelvoorkomende hulpwerkwoorden zijn onder andere hebben, worden, zijn, kunnen en willen.
In een zin met een naamwoordelijk gezegde hebben we een koppelwerkwoord
Hij is een voetballer.
Jan lijkt een lezer.
De werkwoorden hebben in de voorbeeldzinnen nog onvoldoende betekenis. Er is nog extra informatie nodig. In de eerste zin koppelt is de woorden hij en voetballer aan elkaar zodat de betekenis van de zin duidelijk wordt.
Veelvoorkomende koppelwerkwoorden zijn: zijn, worden, blijven, lijken en schijnen.
Sommige werkwoorden kunnen dus tot verschillende soorten behoren. Denk bij het analyseren dus steeds over de betekenis en kijk naar het verband tussen het werkwoord en de andere zinsdelen.
De zon schijnt (= zelfstandig werkwoord: de betekenis is duidelijk, er zijn geen andere zinsdelen nodig om de boodschap te begrijpen.)
Hij schijnt blij met zijn nieuwe fiets. (= koppelwerkwoord: schijnt betekent hier niet stralen, we hebben aanvullende informatie uit andere zinsdelen nodig om de boodschap te begrijpen.)
Ik heb drie zussen. (= zelfstandig werkwoord, hebben betekent bezitten.) Ik heb gisteren toets gehad. (= hulpwerkwoord, hebben geeft de tijd aan.)
Het Nederlands heeft acht werkwoordstijden. Je vindt ze in de onderstaande tabel. De eerste twee tijden zijn de belangrijkste. Voor de andere tijden combineer je eigenlijk verschillende werkwoorden met elkaar.

werkwoordstijd voorbeeld
1onvoltooid tegenwoordige tijd (ott) ik werk, ik studeer, ik lees
2onvoltooid verleden tijd (ovt) ik werkte, ik studeerde, ik las
3 voltooid tegenwoordige tijd (vtt) ik heb gewerkt, ik heb gestudeerd, ik heb gelezen
4voltooid verleden tijd (vvt) ik had gewerkt, ik had gestudeerd, ik had gelezen
5onvoltooid (tegenwoordige) toekomende tijd (otkt) ik zal werken, ik zal studeren, ik zal lezen
6voltooid (tegenwoordige) toekomende tijd (vtkt) ik zal gewerkt hebben, ik zal gestudeerd hebben, ik zal gelezen hebben
7onvoltooid verleden toekomende tijd (ovtkt) ik zou werken, ik zou studeren, ik zou lezen
8voltooid verleden toekomende tijd (vvtkt) ik zou gewerkt hebben, ik zou gestudeerd hebben, ik zou gelezen hebben
Bij zwakke werkwoorden hebben de verleden tijd en het voltooid deelwoord dezelfde klank als de infinitief en de tegenwoordige tijd. spelen: ik speel, ik speelde, gespeeld antwoorden: zij antwoordt, zij antwoordde, geantwoord hopen: wij hopen, wij hoopten, gehoopt
Bij sterke werkwoorden vinden we in de verleden tijd een andere klank terug dan in de infinitief en de tegenwoordige tijd. vergeten: ik vergeet, ik vergat, vergeten nemen: hij neemt, hij nam, genomen


Sommige werkwoorden hebben beide vormen. zegde/zei, klaagde/kloeg, wilde/wou
Soms bestaat zowel de sterke als de zwakke vorm, maar is er een betekenisverschil.
prijzen
• Ik prijsde de producten in de winkel. (= een prijs plakken op iets, zwakke vorm)
• Hij prees de prestatie van zijn tegenstander. (= vol lof spreken over iemand, sterke vorm)
scheppen
• Mijn broer heeft heel de middag op het strand geschept (= zand verplaatsen, zwakke vorm)
• Die kunstenaar heeft een prachtig beeld geschapen (= creëren, sterke vorm)
Op iDiddit vind je aanvullende oefeningen op het gebruik van de verschillende woordsoorten.
Een samenstelling is een woord dat gevormd is uit twee of meer woorden die op zichzelf bestaan. Met de woorden kook en boek kun je kookboek vormen.
In het Nederlands kun je veel samenstellingen vormen. fietshelm, fietshelmenhandel, fietshelmenverzameling
De delen van een samenstelling zijn woorden die ook zelfstandig voorkomen. fiets, helm, handel, verzameling
Samenstellingen kun je op verschillende manieren vormen:
• zelfstandig naamwoord + zelfstandig naamwoord
dorpsplein, boekenkast
• telwoord + zelfstandig naamwoord
drieluik, vierkant, eenrichtingsverkeer, tweedejaarsstudent
• bijvoeglijk naamwoord + zelfstandig naamwoord
hogeschool, sneltrein, zuurdeeg
• bijwoord + zelfstandig naamwoord achterneef, binnentuin
• werkwoordstam + zelfstandig naamwoord
kookboek, waakhond
In een afleiding kunnen niet alle delen zelfstandig voorkomen. Dat is een belangrijk verschil tussen een afleiding en een samenstelling.
treintje: tje is geen zelfstandig woord. schattig: ig is geen zelfstandig woord.
Een afleiding bestaat uit een grondwoord en voor- of achtervoegsels
Onschuldig is een afleiding:
on is het voorvoegsel, het komt voor het grondwoord, on kan niet zelfstandig voorkomen
schuld is het grondwoord ig is het achtervoegsel, het komt achter het grondwoord, ig kan niet zelfstandig voorkomen
Leestekens helpen de structuur van een tekst te verduidelijken. Zo wordt de tekst vlotter leesbaar. Je gebruikt ze:
• op het einde van de zin om een zin af te sluiten;
• binnen de zin als pauze of om de structuur van de zin te verduidelijken.
Deze leestekens komen op het einde van de zin
Punt
• na een mededelende zin
Onze kat vangt geregeld een muis.
• na een verzoek
Help onze kinderen en koop een boekje.
Vraagteken
• na een vraag
Hoe laat vertrek de volgende bus?
Uitroepteken
• na een bevel
Je houdt er nu mee op!
• na een (korte) zin waarin de spreker zijn emotie of wens uitdrukt
Help me!
• na een waarschuwing Pas op voor de hond!
De komma gebruik je binnen de zin
In deze tabel staan een aantal veelvoorkomende voorbeelden van het gebruik van de komma. De komma duidt een pauze aan en verduidelijkt de structuur van de zin.
Je gebruikt een komma:
• tussen twee persoonsvormen;
Toen ik honger had, kwam ik naar je toe.
• bij een opsomming (behalve voor en en of);
De vier minst getroffen landen zijn België, Frankrijk, Zweden en Spanje.
• bij een aanspreking; Joris, heb jij het vlees gekocht? Je kijkt zo triestig, Lies.
• bij samengestelde zinnen; Jan kan morgen niet voetballen, hij heeft een taak voor Nederlands.
• voor de voegwoorden maar, want; Je had dat niet moeten doen, maar nu is het te laat.
• tussen bijvoeglijke naamwoorden bij hetzelfde zelfstandig naamwoord; Onze hond heeft een zachte, bruine pels.
• voor of na een tussenwerpsel. Oeps, wat onhandig van mij. Dat is een verrassing, hé.
De puntkomma gebruik je binnen de zin. Het brengt tussen twee zinnen minder scheiding aan dan een punt, maar meer dan een komma.
Je gebruikt een puntkomma:
• tussen twee samenhangende nevengeschikte zinnen; Sommige chauffeurs houden zich altijd aan de snelheidsbeperkingen; anderen rijden dan weer voortdurend te snel.
• tussen de delen van een opsomming als die uit meer dan één woord bestaan; We hebben drie keuzes: hier blijven; onmiddellijk vertrekken; afwachten en dan gaan.
De dubbele punt gebruik je binnen de zin. Het is een rustteken dat aantoont dat er nog iets volgt.
Je gebruikt een dubbele punt:
• voor het letterlijk weergeven van iemands woorden of gedachten;
Zij antwoordt: ‘Ik weet het echt niet.’
• voor een citaat;
Er hing een poster in de klas met het oude spreekwoord: ‘Rust roest’.
• voor een opsomming;
Hij doorkruiste vier landen: Duitsland, Oostenrijk, Italië en Slovenië.
• voor een verklaring.
We mogen niet meer schaatsen op de vijver: het dooit.
Je gebruikt aanhalingstekens:
• voor het letterlijk weergeven van iemands woorden of gedachten; Andere leestekens bij aanhalingen: een punt op het einde van een beginaanhaling wordt vervangen door een komma buiten de aanhalingstekens.
Jan vroeg: ‘Wanneer ben je dan thuis?’
‘Ik heb er geen idee van’, antwoordde ze.
Andere leestekens staan slechts binnen de aanhalingstekens als ze bij de aanhaling horen.
‘Als het regent,’ zei ze, ‘wachten we een tijdje.’
‘Pas op!’ schreeuwde Bert.
• bij een speciale gevoelswaarde, als iets:
ironisch bedoeld is;
Dit is een echt ‘meesterwerk’.
een opvallend woord is; Ze leeft in de ‘cocon’ van het gezin.
een volkse uitdrukking is; Op kamp maakten ze ‘leute en plezier’.
een voorbeeld van taalcreativiteit is. Vanavond gaan we lekker ‘terrassen’.
• bij titels en namen.
Las jij ook al ‘Eeuwig Zwijgen’ van Guy Didelez? We logeerden in hotel ‘Zeebries’.
Je gebruikt een beletselteken:
• na een onvolledige opsomming; De jongen heeft een hond, twee schildpadden, twee konijnen ...
• om de spanning op te drijven; De deur draaide kreunend open ...
• om de lezer te laten nadenken; Hij viel en ...
• om een verrassingseffect te bekomen; Mijn zus kreeg een naaimachine, nu kan ze ... stikken!
• om taboewoorden of scheldwoorden af te breken.
Godv... !
3.2
Je gebruikt gedachtestreepjes:
• bij een onderbreking in de gedachtegang (door toevoeging van een tussenzin), vaak om een onverwachte wending duidelijk te maken;
Het resultaat is – niemand verwachtte dat – verbluffend.
• om een gedachte te beklemtonen.
Ze reed – heel langzaam – naar huis.
Je gebruikt haakjes:
• om extra uitleg te geven (die je weglaat bij het hardop lezen);
De EGKS (Europese Gemeenschap voor Kolen en Staal) werd op 23 juli 2002 geschiedenis.
• om een gevoelswaarde te geven: twijfel (?) of nadruk (!).
Ze vertelt dat ze nog een uur (?) zal studeren.
Ze zal nog een uur geschiedenis (!) studeren.
Je gebruikt een schuine streep:
• om een keuze aan te duiden;
Gevraagd: meisje/jongen voor een vakantiejob
• in enkele afkortingen.
t/m (tot en met), p/a (per adres)
Op iDiddit vind je aanvullende oefeningen op het gebruik van leestekens.
SOORTEN ZINNEN
Een zin heeft een bedoeling: iets meedelen, iets vragen, iets bevelen of uitroepen. We spreken van een mededelende zin, een vragende zin (of vraagzin), een uitroepende zin (of uitroep) en een bevelende zin (of bevel).
Elke zin eindigt met een leesteken. Meestal begint een zin met een hoofdletter.
De mededelende zin komt het meeste voor in onze taal. Die zin bevat altijd een onderwerp en een persoonsvorm. In dit zinstype is de persoonsvorm altijd het tweede zinsdeel.
Hij heeft de wedstrijd gewonnen. Dat meisje speelt voetbal.
3.2.2 Vragende zin
Een vragende zin die je met ja of nee kunt beantwoorden, begint altijd met de persoonsvorm. We noemen die omkering van onderwerp en persoonsvorm inversie. Andere vraagzinnen beginnen met een vraagwoord.
Heeft hij de wedstrijd gewonnen?
Wie heeft de wedstrijd gewonnen?
Speelt zij voetbal?
Welke sport beoefent zij?
Na een vraag komt een vraagteken
3.2.3 Bevelende zin of imperatief
Met een bevelende zin geef je iemand een bevel, een opdracht, een instructie … Ruim je bureau op!
Geef hem een pass!
Na een bevelende zin komt een uitroepteken
3.2.4 Uitroepende zin
Een uitroepende zin drukt een gevoel uit.
Kon ik maar beter voetballen! (= wens)
Jij moet toch altijd rommel maken! (= boosheid)
Na een uitroepende zin komt een uitroepteken.
Zinnen kunnen bevestigend of ontkennend zijn. Dit is lekkere spaghetti. (= bevestigend)
Ik ontmoet iemand tijdens mijn ziekteverlof. (= bevestigend)
Dit is geen lekkere spaghetti. (= ontkennend)
Ik ontmoet niemand tijdens mijn ziekteverlof. (= ontkennend)
Er zijn enkelvoudige en samengestelde zinnen. Een enkelvoudige zin bestaat uit éénhoofdzin en heeft slechts éénpersoonsvorm
Ik zal vanavond zeker naar de training gaan. Zaterdag is er een wedstrijd. (= twee enkelvoudige zinnen)
Gebruik geen bestaand woord of een naam. Dat is gemakkelijk te raden. (= twee enkelvoudige zinnen)
Wanneer je enkelvoudige zinnen samenvoegt, dan krijg je een samengestelde zin. Je vindt in die zinnen meestal verschillendepersoonsvormen
Ik zal vanavond zeker naar de training gaan, want zaterdag is er een wedstijd. (= één samengestelde zin)
Gebruik geen bestaand woord of een naam omdat dat gemakkelijk te raden is. (= één samengestelde zin)
Een samengestelde zin kan een zin met nevenschikking of met onderschikking zijn.
Van een samengestelde zin met nevenschikking kun je twee gelijkwaardige zinnen maken zonder dat de woordvolgorde verandert.
nevenschikking
zin 1 voegwoord of leesteken zin 2
Ik had honger en ik kwam naar je toe.
Bij een samengestelde zin met onderschikking kun je dat niet.
onderschikking
voegwoord bijzin hoofdzin
Toen ik honger had, kwam ik naar je toe.
Om samengestelde zinnen te maken heb je vaak een voegwoord nodig. Met een nevenschikkend voegwoord maak je een zin met nevenschikking. Nevenschikkende voegwoorden zijn bijvoorbeeld en, of, maar en want
Met een onderschikkend voegwoord vorm je een zin met onderschikking. Onderschikkende voegwoorden zijn bijvoorbeeld terwijl, omdat, toen en zodra
Op iDiddit vind je aanvullende oefeningen op enkelvoudige en samengestelde zinnen.
In een goed gebouwde zin staat altijd een persoonsvorm (pv). De persoonsvorm is het werkwoord dat hoort bij het onderwerp
In de zin Mijn broer gaat straks liever voetballen is gaat de persoonsvorm. Gaat staat in het enkelvoud, net zoals het onderwerp. Als het onderwerp enkelvoud is, dan staat de pv in het enkelvoud; als het onderwerp meervoud is, dan staat de pv in het meervoud.
Het deel waarin je verneemt wat het onderwerp doet of wat ermee gebeurt, noem je het werkwoordelijk gezegde (wwg). Het deel waarin verteld wordt hoe, wie of wat het onderwerp is of wordt, noem je het naamwoordelijk gezegde (nwg).
werkwoordelijk gezegde doen
Mama voetbalt in de tuin met mijn zusje. Columbus ontdekt Amerika.
Mama doet iets. Columbus doet iets. naamwoordelijk gezegde zijn / worden
Dries Mertens is een voetballer. Columbus werd beroemd.
Dries is iets. Columbus wordt iets.
Het meisje helpt haar vader. (= lijdend voorwerp, iemand helpen)
Hij maakt het eten klaar. (= lijdend voorwerp, iets klaarmaken)
Ik geef een cadeau aan Anna. (= lijdend voorwerp, iets geven)
Hoe herken je een lijdend voorwerp?
1 Het komt alleen voor bij een werkwoordelijk gezegde.
2 Het kan vervangen worden door iets/iemand.
3 Het begint nooit met een voorzetsel (in, met, op, uit …).
Sommige werkwoorden hebben naast bijvoorbeeld het lijdend voorwerp nog een aanvulling nodig, dan kun je aan of voor iets/ iemand aanvullen. Dat zinsdeel is het meewerkend voorwerp
Hij gaf aan zijn vriendin een verlovingsring. (= meewerkend voorwerp, iets aan iemand geven)
Ze koopt hem een nieuwe blu-ray van The Mandalorian. (= meewerkend voorwerp, iets voor iemand kopen)
Hoe herken je het meewerkend voorwerp?
1 Het komt alleen voor bij een werkwoordelijk gezegde.
2 Het meewerkend voorwerp kan vervangen worden door aan of voor iets/iemand
Bepalingen zijn zinsdelen die extra informatie geven aan de ontvanger over wanneer, hoe, waarom, waar … iemand iets doet.
De bepaling is een zinsdeel dat minder nauw met het werkwoord verbonden is dan zinsdelen zoals het onderwerp en voorwerpen (bv. lijdend en meewerkend voorwerp). Het kan gemakkelijker wegvallen dan die andere zinsdelen.
Een zin kan meer dan één bepaling bevatten.
Zij gaat morgen voetballen in Lokeren


Morgen match!

Zij voetbalt morgen
Zij voetbalt op het veld
Zij voetbalt graag








We noemen teksten fictie wanneer ze gaan over een verzonnen werkelijkheid. Die verhalen spelen zich vooral af in de fantasie van de auteur en zijn publiek, bijvoorbeeld: videogames, fantasy en sprookjes. Ook creatieve teksten waarin emoties centraal staan, bijvoorbeeld gedichten, kortfilms en liedteksten, zijn fictie.
Non-fictie is de verzameling van zakelijke teksten die over feiten gaan. Voorbeelden zijn kranten, woordenboeken en reisgidsen
Een vrouw sterft in een verkeersongeval. Er verschijnt een artikel in de krant waarin het ongeval besproken wordt. Het artikel vermeldt de datum, de naam van de vrouw, de plaats … Dat artikel noemen we non-fictie
De man van de vrouw schrijft een gedicht voor zijn overleden vrouw. Dat gedicht noemen we fictie

De grens tussen fictie en non-fictie is niet altijd duidelijk. Heel vaak baseren auteurs zich op de werkelijkheid om overdreven of uitgevonden verhalen te vertellen. Soaps zijn hier een duidelijk voorbeeld van.
Sommige non-fictie kan de werkelijkheid ook fout weergeven, terwijl sommige fictie een heel getrouw beeld van de werkelijkheid geven. Het is vooral belangrijk dat je nadenkt over de bedoeling van de auteur. Had hij de bedoeling om fictie of non-fictie te schrijven?
Boekhandels en bibliotheken gebruiken de termen fictie en non-fictie ook om bijvoorbeeld boeken in te delen.


Op zoek naar dé boeken van deze week? Laat je inspireren door onze top 5 fictieboeken!

ouderlijk huis en de voorspelbaarheid van zijn saaie provinciestadje achter zich en gaat de anonimiteit van de grootstad bloeit de teruggetrokken jongeman langzaam open: hij staat op eigen benen, maakt enkele intrigerende nieuwe vrienden en komt in de ban van zijn bloedmooie studiegenote Rachella. Verlegen als hij is, durft Tom haar niet aan te spreken en hij verliest zich in dagdromen. Hij krijgt ook woedeaanvallen, waarbij hij het contact met de werkelijkheid compleet verliest. Wanneer Rachella een donkere periode doormaakt, blijkt hij toevallig de juiste man op de juiste plaats. Ze groeien gaandeweg naar elkaar toe. Wordt de liefde voor Rachella Toms redding
Het bijvoeglijk naamwoord van fictie is fictioneel. We spreken dus van fictionele en non-fictionele teksten.
Op iDiddit vind je aanvullende oefeningen op fictie en non-fictie.

Objectief betekent zakelijk, letterlijk, neutraal. Een objectieve foto geeft de werkelijkheid weer zoals die echt is. In objectieve teksten wordt de werkelijkheid neutraal beschreven, zonder een eigen mening.
Het tegenovergestelde is subjectief. Een schrijver of kunstenaar zal een persoonlijk standpunt innemen en dat verwerken in de boodschap. Zo komt de eigen mening naar voren en worden gegevens vanuit een bepaalde overtuiging weergegeven.
Een schrijver of spreker wil met zijn tekst iets bereiken. Hij heeft een bepaald doel. Afhankelijk van het doel kiest de schrijver of spreker voor een tekstsoort. Er zijn verschillende tekstsoorten en tekstdoelen en veel teksttypes
tekstsoort tekstdoel teksttype informatieve tekst informeren krantenartikel, bijsluiter, nieuwsbericht, rapport, verslag persuasieve tekst of beïnvloedende tekst beïnvloeden, aanzetten om iets te doen reclameboodschap, betoog, klachtenbrief opiniërende tekst of overtuigende tekst opiniëren, overtuigen opiniestuk, recensie
prescriptieve tekst voorschrijven recept, gebruiksaanwijzing narratieve tekst of verhalende tekst vertellen, ontspannen, amuseren, ontroeren reisverhaal, stripverhaal, roman
1 Het verschil tussen persuasieve en opiniërende teksten is vaak klein. Persuasieveteksten willen beïnvloeden en aanzetten om iets te doen. Opiniërendeteksten willen een opinie geven of overtuigen.
2 Elke tekst heeft een van die doelen als hoofddoel. Soms heeft een tekst nog andere doelen; er zijn dus veel mengvormen
Iemand die een lezersbrief schrijft, wil de lezer overtuigen, maar ook informeren over een bepaald probleem.
3 Hetzelfde teksttype kan gebruikt worden voor verschillende tekstdoelen. Zo kun je een grafiek gebruiken om je publiek objectief te informeren. Je kunt diezelfde grafiek echter ook gebruiken om je publiek te overtuigen, zeker wanneer je de lay-out en woordkeuze aanpast om je boodschap kracht bij te zetten.
Artikels zijn meestal informatieve teksten. Ze bestaan uit volgende elementen.

In de kop of titel vind je vaak de hoofdgedachte. Dikwijls bevat de kop geen lidwoorden. Soms is een kop gewoon bedoeld om de aandacht van de lezer te trekken.

De lead is de samenvattende inleiding. Die is vaak schuin- of vetgedrukt. In dit deel van de tekst beantwoordt de journalist enkele belangrijke topische vragen en geeft hij de hoofdgedachte van zijn tekst kernachtig weer.

Een krantenartikel begint vaak met een plaatsaanduiding. Op die manier weet de lezer waar de gebeurtenissen zich afspelen.
De eigenlijke tekst van het artikel noemen we de broodtekst. Die kan onderverdeeld zijn in alinea’s en er kunnen ook nog tussentitels of tussenkoppen zijn.
Wanneer een citaat in grote letters geplaatst wordt bij een artikel om de lezer aan te trekken en de bladspiegel aantrekkelijker te maken, spreken we van een streamer
In kranten vind je vaak inzetteksten. Dit zijn kleine stukjes tekst die achtergrondinformatie geven. Vaak worden ze in een kadertje geplaatst.
De illustraties verduidelijken wat in het artikel staat. Soms dienen ze om de aandacht te trekken. De naamsvermelding van de maker van die illustraties noemen we de credits
Vaak wordt de auteur van het artikel vermeld; soms vermeldt de krant enkel de initialen van de journalist.
Een column is een korte tekst waarin een auteur op een persoonlijke manier zijn visie geeft op de maatschappij of een onderwerp uit de actualiteit. Meestal maakt de schrijver gebruik van literaire technieken om zijn emoties over te brengen. Vaak zal een column ook humor bevatten.
Vaak is het de bedoeling om de lezer te raken met een mening, anekdote of speciale kijk op het onderwerp.
COLUMN
AYA SABI
columnist en auteur van Verkruimeld land
De tekst verscheen bij het begin van een nieuw schooljaar.
Ik denk in het Nederlands. Wanneer ik tegen mezelf praat of grapjes in mijn hoofd herhaal en hardop giechel, doe ik dit in het Nederlands. Ik spreek het vlotst in het Nederlands. Ik schrijf in het Nederlands. Ik heb een hele carrière gebouwd met deze taal alleen.
Ik heb me er ondertussen bij neergelegd dat het Nederlands toch nooit helemaal van mij zal zijn. Ik vergeleek dit eerder al met een bord waarin de buurvrouw je iets lekkers heeft gebracht en waar je dus extra voorzichtig mee bent. Wanneer je het lekkers opeet, wanneer je het bord wast en afdroogt. Het is niet van jou, dus het mag zeker niet breken. Het Nederlands is andermans bezit. Ik heb de taal in bruikleen.
De opmerkingen die ik krijg over mijn taal zijn niet op één hand te tellen. Mijn uitspraak is inderdaad gekleurd, dus zo gek is dat niet. Ik moet niet lang praten voor de meeste mensen horen dat ik van Limburg ben. Voor anderen is mijn tongval vreemd, omdat mijn uiterlijk hen verwart. Ik ben een vreemde, dus dan moet mijn taal ook even exotisch zijn als mijn huidskleur en mijn afkomst. Wat zegt dit over mijn taal of over mijn capaciteiten om deze te spreken, te gebruiken, er literatuur van te maken: helemaal niets. Wat zegt dat over deze mensen? Alles.
(...)
Bron: www.demorgen.be






Een opiniestuk is een overtuigende tekst bij een gebeurtenis uit de actualiteit. De schrijver reageert op een voorstel of gebeurtenis in de maatschappij en geeft daarover zijn mening. De auteur schrijft een zakelijk stuk waarin hij voor- en tegenargumenten afweegt en zelf een conclusie over het onderwerp formuleert.
In kranten en tijdschriften staat er meestal een opiniestuk van de hoofdredacteur op de tweede pagina.

RUUD HENDRICKX & DOMINIEK SANDRA
Ruud Hendrickx is taaladviseur voor VRT en Dominiek Sandra is professor Taalkunde aan Universiteit Antwerpen. Wil je half Vlaanderen in opstand laten komen, durf dan te opperen dat we misschien beter de dt-regels kunnen afschaffen. Dat is de afgelopen week weer eens gebleken. In de Facebookgroep van VRT Taal kwamen honderden, vaak emotionele reacties op die stelling. Heel wat mensen stelden dat die regels eenvoudig en logisch zijn. Gek genoeg voegden ze er geregeld aan toe: je moet alleen veel oefenen. Als de regels logisch en eenvoudig zijn, dan zou je toch juist niet veel hoeven te oefenen?
(...)
Bron: www.vrt.be/vrtnws





Een recensie bespreekt een nieuw uitgekomen cd, boek, film of tv-reeks. Ook events zoals een tentoonstelling of festival kunnen het onderwerp zijn.
De recensent geeft aan dat het onderwerp er is, geeft er achtergrondinformatie bij (over de maker, het onderwerp, de reeks …) en geeft ten slotte een eigen mening.
Schrijfster Lize Spit legt de lat hoog in haar ‘moeilijke tweede’ over een harmonieuze liefdesrelatie die omkantelt in manie. Ze raakt er met veel souplesse over.

Vier jaar geleden rolde het debuut Het smelt als een sneeuwbal de Vlaamse en Nederlandse letteren binnen. Bij het uitkomen werd het boek van Lize Spit, over een jonge vrouw die met een ijsblok in de koffer van haar wagen naar haar geboortedorp terugkeert om af te rekenen met een problematisch verleden, bedolven onder de lovende recensies. Ook aan de kassa ging het hard. Van de roman werden 210 000 exemplaren verkocht; van de Franse en Duitse vertaling – twee van de vijftien vertalingen – nog eens 20 000 en 30 000 stuks. De Engelse vertaling is onderweg, horen we bij haar uitgeverij.
‘Succes is een zegen, maar het is niet de eenvoudigste zegen die de goden in huis hebben’, zei haar Nederlandse vriend Rob van Essen, zelf een voortreffelijk schrijver, over de ‘moeilijke tweede’ die aan hun keukentafel geschreven werd. De schrijfster zelf verkondigde ook vaak in interviews hoe Het smelt haar opzadelde met een knoert van een writer’s block en hoe het succes haar onzekerheid en slaapproblemen versterkte.
Haar aanhoudende stress over de onverwachte bijval voor haar debuut is de belangrijkste reden waarom Ik ben er niet nu pas af is. Behalve het hoge verwachtingspatroon speelden Spits perfectionisme en teugelloze ambitie als schrijfster op. Dat eerste lees je af uit elke paragraaf die langskomt. Je ziet haar aan haar laptop schaven en schrappen tot elk woord en leesteken op de juiste plaats staan. Haar ongebreidelde aspiraties zijn te merken aan het volume: met 570 bladzijden is dit boek er zowat 100 dikker dan haar eerste roman. Maar je glijdt er doorheen als een warm mes door boter.
(...)
Bron: www.tijd.be - 12/12/2020
Een infographic is een illustratie die informatie weergeeft in de vorm van grafieken, diagrammen en afbeeldingen in combinatie met beperkte tekst. Vaak wordt er in een infographic gebruikgemaakt van kleurcoderingen, afbeeldingen, lijntekeningen en cijfers.
Infographics worden vooral gebruikt om resultaten van onderzoeken overzichtelijk weer te geven.


Diabetes is een ziekte waarbij het lichaam de bloedsuikerwaarden niet meer in evenwicht kan houden. Het hormoon insuline regelt dit evenwicht. Als het lichaam niet meer goed op insuline reageert of helemaal geen insuline meer maakt, dan heb je
Een tekst gaat altijd ergens over. Dat is het onderwerp van de tekst. Dikwijls kun je dat onderwerp in één woord benoemen. Het onderwerp van de tekst is een woord (of een woordgroep) dat aangeeft waarover de tekst gaat. taalfouten of taalfouten van leerlingen
De hoofdgedachte is het belangrijkste wat over het onderwerp wordt gezegd. Die zin geeft de centrale boodschap van de tekst. Leerlingen maken veel taalfouten.
De hoofdpunten zijn de inhoudelijke elementen die de auteur gebruikt om de hoofdgedachte uit te werken. Leerlingen maken veel taalfouten wanneer ze met elkaar communiceren. Leerlingen maken minder taalfouten wanneer ze met de leerkracht communiceren.
Elke tekst begint met een titel (of kop). Een goede titel is kort, zegt iets over de inhoud en bevat geen leestekens.
Soms zijn er tussentitels (of tussenkopjes). Die staan boven een deel van de tekst en geven aan waarover dat deel gaat.
Een alinea is een tekstblok van bij elkaar horende zinnen. Soms wordt het begin van een nieuwe alinea duidelijk gemaakt in de vorm: door witregels of een insprong.
De kernzin van een alinea is meestal de eerste zin. In de kernzin zit de belangrijkste informatie uit de alinea.
IMS-structuur : een goede tekst is opgebouwd uit een inleiding (I), een midden (M) en een slot (S).
De inleiding (of lead) leidt kort de tekst in. Hier vind je meestal het belangrijkste onderwerp van de tekst en wat de auteur daarover wil zeggen. Vaak staat dit tekstdeel ook in een ander lettertype. Een goede inleiding probeert de lezer ook altijd te verleiden om verder te lezen door een citaat, een voorbeeld of een vraag.
Na de inleiding volgt een midden waarin de auteur meer informatie geeft over het onderwerp. Dat stuk tekst is meestal opgedeeld in alinea’s. In elke alinea wordt telkens een aspect of een deelonderwerp van het hoofdonderwerp besproken.
De laatste alinea vormt vaak het slot van de tekst. Hierin wordt nog eens samengevat wat er over het onderwerp wordt gezegd of wat de auteur van het onderwerp vindt (= de hoofdgedachte van de tekst). Niet elke tekst heeft een slot.
Sommige inhoudelijke elementen horen bij een bepaalde structuur. Woorden als ‘probleem’ en ‘oplossing’ zullen vaak voorkomen in teksten met een probleemstructuur. Teksten met een chronologisch verband zullen jaartallen of tijdsaanduidingen bevatten.
Signaalwoorden geven een teken dat er een bepaald verband bestaat tussen zinnen of alinea’s. Het publiek begrijpt de tekst beter wanneer de verbanden tussen de zinnen worden aangegeven. In de tabel vind je de belangrijkste tekstverbanden en de bijhorende signaalwoorden.
verband signaalwoorden chronologie eerst, daarna, vervolgens, dan, nu, later, nadien, toen, eerst, ten slotte, terwijl, vroeger middel-doel met de bedoeling …, zodat, door … te, om te …, daarvoor, waarvoor reden daarom, om die reden, dus, want, immers, namelijk, aangezien, gezien, de reden is tegenstelling maar, toch, hoewel, ondanks, echter, niet, in tegenstelling tot, het tegenovergestelde voorwaarde als, indien, in het geval dat, mits, wanneer opsomming ten eerste, ten tweede, ten derde, verder, vervolgens, daarnaast, ook, tevens, bovendien vergelijking zoals, alsof, of, gelijk (schrijftaal), in vergelijking met, aan de ene kant, aan de andere kant, tegenover conclusie dus, daarom, besluitend, ik besluit
Om communicatie eenvoudiger te maken gebruiken heel wat zenders vaste structuren. Ze bouwen hun teksten op volgens een vaste structuur die een aantal vragen en een bepaalde volgorde bevat.
Afhankelijk van het tekstdoel kiest de zender een andere tekststructuur. Je vindt hieronder de meest gebruikte tekststructuren. We noteren de vaste structuren aan de hand van een aantal vragen waarop in de tekst een antwoord wordt gegeven.

4.6.1 Probleemstructuur
• Wat is het probleem?
• Wat zijn de deelproblemen?
• Waarom is het een probleem?
• Wat zijn de oorzaken van het probleem?
• Welke oplossingen zijn er?
4.6.2 Maatregelstructuur
• Wat is de maatregel?
• Waarom is de maatregel nodig/ingevoerd?
• Hoe wordt de maatregel uitgevoerd?
• Wat zijn de (verwachte) effecten van de maatregel?
4.6.3 Evaluatiestructuur
• Wat wordt er geëvalueerd?
• Wat zijn de voor- en nadelen?
• Welke gelijkenissen en verschillen zijn er met andere(n)?
• Wat pleit voor en wat pleit tegen?
• Wat is de conclusie?

4.6.4 Handelingsstructuur
• Wat is het doel van de handeling?
• Wat heb je nodig (voorwaarden, ingrediënten)?
• Wat doe je eerst?
• Wat volgt er dan?
• Waar moet je tijdens het uitvoeren rekening mee houden?
• Wat is de uitkomst?
4.6.5 Onderzoeksstructuur
• Wat wordt er onderzocht?
• Hoe verloopt het onderzoek?
• Welke methode wordt er gebruikt?
• Door wie gebeurt het onderzoek?
• Wat zijn de resultaten van het onderzoek?
• Wat zijn de conclusies van het onderzoek?
4.6.6 Chronologische structuur

• Wat is het onderwerp?
• Welke stap komt eerst?
• Welke stappen volgen dan?
Ook bij spelling is het belangrijk om de juiste strategie te gebruiken. Je vindt hier drie belangrijke strategieën:
1 Je schrijft zoals je het in de standaarduitspraak hoort.
Je hoort muis, vis, aap Je schrijft muis, vis, aap
2 Je herkent soortgelijke of analoge gevallen omdat we woorden en woorddelen zoveel mogelijk op dezelfde manier spellen.
Je schrijft breedte (breed +te) omdat je ook hoogte (hoog +te) schrijft.
Je schrijft hij wordt (word +t) omdat je ook hij loopt (loop +t) schrijft.
Je schrijft hond omdat het meervoud honden is.
3 Je weet dat spelling soms ook te maken heeft met de oorsprong (= etymologie) van woorden. Die woorden moet je correct leren gebruiken en onthouden
pijl – peil, lijden – leiden computer, jazz, thuis

HOE VERVOEG JE EEN WERKWOORD?
tegenwoordige tijd (nu) verleden tijd (vroeger)
PV?
NEE
Hoor je een -t achteraan?
stam + t hij werkt, hij vindt Schrijf wat je hoort. Ik lach uitbundig.
imperatief stam Zwijg! Word volwassen!
infinitief op -en of -n


















Ik ben aan het praten
Mijn vrienden zijn aan het praten Ik moet verder gaan
Zij moeten verder gaan
Is er klankverandering?
voltooid deelwoord (vd) op -en of -n
Zij hebben geslapen Het is gedaan op -d of -t (verlengen) Ik heb beloofd. Er wordt gekookt vd bijvoeglijk gebruikt de omgewaaide boom de vergrote foto een gekocht boek
NEE
Schrijf wat je hoort. De baby sliep
Hoor je een -de(n)? stam + de(n) Het vliegtuig landde
Hoor je een -te(n)? stam + te(n) De tuinman plantte een struik.
Gebruik je liever de analogieregel?
Je twijfelt aan de spelling van de werkwoordvorm? Vervang die door het werkwoord werken
Vind je werkwoorden moeilijk? Werk je …?
Vindt u geweldfilms ook zo leuk? Werkt u …?
je werk+t je werk+te je hebt ge+werk+t
vd verlengen!
je wacht+t wacht je wacht+te je hebt ge+wacht
je open+t je open+de je hebt ge+open+d
je antwoord+t je antwoord+de je hebt ge+antwoord
je download+t je download+de je hebt ge+download letter uit ’t kofschip +te letter uit ’t kofschip +t
Bij klankverandering: geen uitgang toevoegen!
hij kwam, hij vond
’t Kofschip is een ezelsbruggetje om te bepalen of er een -d of een -t achter een werkwoord komt in de verleden tijd.
Hoe doe je dat?
1 Neem de infinitief. werken
zeuren
2 Laat -en weg. werk
zeur
3 Zit de laatste klank in ’t kofschip?
k is een medeklinker van ’t kofschip (t, k, f, s, ch of p) t werk te r is geen medeklinker van ’t kofschip d zeurde
Opmerkingen
1 Dat is ook zo voor het voltooid deelwoord. Zij heeft de hele dag gewerkt. Hij heeft de hele dag gezeurd.
2 Het gaat om de klank. faxen
x klinkt als /s/ s is een medeklinker van ’t kofschip t fax te; hij heeft gefaxt
3 Luister naar de laatste klank voor de -en van de infinitief (kijkletter).
verhuizen verhuiz z is geen medeklinker van ’t kofschip d verhuisde; hij is verhuisd
BIJZONDERE MOEILIJKHEDEN
Persoonsvorm en onderwerp
Persoonsvorm (pv) en onderwerp horen samen. Dat merk je bij een ja-neevraag. De pv komt eerst, het onderwerp volgt op de tweede plaats.
Herhaalt hij die zin? Beantwoord jij die brief?
Herhaalt en beantwoord zijn beide pv.
Heeft hij die zin herhaald? Heb je die vraag beantwoord?
Hier zijn heeft en heb pv, en zijn herhaald en beantwoord niet pv.
De pv verandert mee van getal met het onderwerp. De andere werkwoorden in de zin doen dat niet. Dat is congruentie
Heb (= pv) jij die brief beantwoord?
Hebben (= pv) wij die brief beantwoord?
Verander je de zin van tijd, dan verandert de pv.
Beantwoordde (= pv) jij die brief?
Had (= pv) je die brief beantwoord?
Inversie
Bij omkering of inversie van de jij-vorm valt de -t weg. Werk je? Antwoord je?
Let op:
Antwoordt je broer?
Je broer is onderwerp. Je is hier geen persoonlijk, maar een bezittelijk voornaamwoord en een synoniem van jouw (Antwoordt jouw broer?). Ook hier kun je weer met werken vergelijken: Werkt je broer?
Imperatief
Bij de bevelvorm of imperatief gebruik je de stam.
Red het milieu! Word wakker! Ga naar huis! Antwoord meteen! Wacht hier!
Soms moet je toch de uitgang -t schrijven:
• in vaste formuleringen of oude zegswijzen; Bezint eer ge begint!
• in de imperatief met u, maar alleen als u onderwerp is.
Doet u maar verder! Draait u zich even om! Wendt u zich tot de huismeester! Kleedt u zich maar weer aan!
Geen -t, want u is geen onderwerp.
Wind u niet op! Wend u tot de directeur!
(Controle: u windt op / u wendt tot de directeur zijn geen correcte Nederlandse zinnen.)
Uitzonderingen
Zijn, hebben, willen, zullen, kunnen en mogen hebben een aparte vervoeging in de tegenwoordige tijd en verleden tijd. Vooral de eerste, tweede en derde persoon enkelvoud volgen niet het gewone schema.
ik ben, was, geweest – heb, had, gehad – wil, wilde of wou, gewild – zal, zou – kan, kon, gekund – mag, mocht, gemogen
jij bent, was – hebt, had – wilt, wilde of wou – zult, zou – kunt, kon – mag, mocht
u bent, was – hebt of heeft, had – wilt, wilde of wou – zult, zou – kunt, kon – mag, mocht

hij is, was – heeft, had – wil, wilde of wou – zal, zou – kan, kon – mag, mocht
U heeft, jij wilt, jij zult, jij kunt is schrijftaal, in spreektaal gebruik je: u hebt, jij wil, jij zal, jij kan.
De werkwoorden van Engelseherkomst volgen de regel van de regelmatige werkwoorden, bijvoorbeeld werken en openen
infinitief stam ott ovt vd
werken werk hij werkt hij werkte gewerkt
coachen coach hij coacht hij coachte gecoacht
finishen finish hij finisht hij finishte gefinisht
promoten promoot hij promoothij promootte gepromoot
openen open hij opent hij opendegeopend
skateboardenskateboard hij skateboardthij skateboardde geskateboard
joggen jog hij jogt hij jogde gejogd
bingoën bingo hij bingoothij bingode gebingood
scoren scoor hij scoort hij scoordegescoord
Je moet heel goed op de uitspraak letten, want de klanken zijn belangrijk voor de schrijfwijze.
• Wanneer een dubbele medeklinker nodig is voor de uitspraak, blijft die behouden.
• Soms blijft de -e in de stam behouden vanwege de uitspraak. (Vergelijk de uitspraak van hat(hoed) en to hate (haten).)
• Sommige Engelse werkwoorden kun je op twee manieren uitspreken. Je kunt ze dus ook op twee manieren vervoegen.
infinitief stam ott ovt vd
baseballenbaseball hij baseballthij baseballde gebaseballd
volleyballenvolleybal hij volleybalthij volleybaldegevolleybald
racen race hij racet hij racete geracet
saven save hij savet hij savede gesaved
timen time hij timet hij timede getimed
barbecueënbarbecue hij barbecuet hij barbecuede gebarbecued
surfen surf hij surft hij surfde/surfte gesurfd/gesurft
Je schrijft een hoofdletter :
• aan het begin van een zin; Aan het begin van een zin, schrijf je een hoofdletter.
• bij namen van: – personen; Koen Wauters, Angèle

– gebouwen, bedrijven, merken; Atomium, Aldi, Mars
– kranten, tijdschriften, hemellichamen. De Standaard, Humo, Mars



• bij aardrijkskundige namen en hun afleidingen; Houthalen, België, Belgisch(e), Belg

• bij talen en dialecten; West-Vlaams, het Grieks
• bij feestdagen; Kerstmis, Moederdag, Pasen
• bij historische gebeurtenissen. De Franse Revolutie, de Eerste Wereldoorlog

tip
Je schrijft geen hoofdletter bij:
• seizoenen; de lente
• dagen, maanden; maandag, augustus
• windstreken; oost, zuidwest
• periode of kunststroming; de middeleeuwen, de romantiek
• samenstellingen met een feestdag; kerstgeschenk, paasvakantie

• eigennamen die een soortnaam werden. een cognac, een fles champagne (maar: Reims is een stad in de Champagnestreek)
Op iDiddit vind je aanvullende oefeningen op het gebruik van hoofdletters.
Als we samenstellingen vormen door een of meer zelfstandige naamwoorden met elkaar te verbinden, komt het vaak voor dat we een tussenklank gebruiken om die samenstelling beter te kunnen uitspreken. Er zijn geen vaste regels, maar we doen dat eigenlijk op basis van ons taalgevoel.
kip + filet = kipfilet
kip + vlees = kipvlees kippenvlees
Naast de doffe -e gebruiken we ook een -s als tussenklank.
hout + kool = houtkool houtskool
Wanneer we die samenstellingen spellen, moeten we er rekening mee houden dat die klanken correct in ons woord terechtkomen. Daarvoor bestaan concrete regels.
TUSSEN-N
Je schrijft een tussen-n als het eerste deel van de samenstelling een zelfstandig naamwoord is dat uitsluitend een meervoud op - (e)n heeft.
eikenboom, krantenbericht, ziekenhuis, zakenreis, paardenbloem
Er zijn enkele uitzonderingen die je kunt onthouden als de zonneschijnregel, de beresterkregel en de flierefluiterregel:

• Het eerste deel is enig in zijn soort. Er is maar één zon (= zonneschijnregel). zonneschijn, Onze-Lieve-Vrouwekerk, maneschijn
• Het eerste deel heeft een emotioneel versterkende betekenis (heel) en de samenstelling is een bijvoeglijk naamwoord (= beresterkregel). beresterk, reuzeleuk, apetrots
• Het geheel is een versteende uitdrukking die niet meer als een echte samenstelling wordt gezien (= flierefluiterregel). flierefluiter, elleboog, papegaai
Je schrijft toch een tussen-n bij bijvoorbeeld lerarentekort (ondanks twee meervouden: leraars en leraren) en artikelenreeks (ondanks twee meervouden: artikels en artikelen) omdat je daar de -n hoort bij het uitspreken.
TUSSEN-E
Je schrijft een tussen-e bij volgende samenstellingen:
• Het eerste deel van de samenstelling eindigt in het enkelvoud op -e en in het meervoud op -s of op -n. horlogewinkel, machinekamer, aspergesoep
• Het eerste deel heeft geen meervoud. rijstebrij, snottebel
• Het eerste deel is een bijvoeglijk naamwoord. rodekool, platteland
• Het eerste deel is afkomstig van een werkwoord. spinnewiel, wiegelied





Je schrijft een tussen-s bij volgende samenstellingen:
• Als je ze hoort. eendagsvlieg, meisjesgek
• Als het tweede deel met een sisklank begint, pas je de analogieregel toe.
Dorpsstraat dorpsplein spijsverteringsstelsel spijsverteringskanaal
• Soms heb je de keuze. Raadpleeg www.woordenlijst.org als je twijfelt.


tijdverschil, tijdsverschil
• Onthoudwoorden: alleszins, geenszins, anderszins, buitenshuis
Op iDiddit vind je aanvullende oefeningen op tussenklanken.

MEERVOUD VAN ZELFSTANDIGE NAAMWOORDEN
De meeste zelfstandige naamwoorden hebben een meervoud.
• De meeste daarvan krijgen in het meervoud -en als uitgang. boeken, kasten, woorden

• Een meervoud op -s komt ook vaak voor. tips, letters, bijtjes
• Soms zijn er ook dubbelvormen. leraren – leraars, appelen – appels




• Er zijn ook speciale meervoudsuitgangen. mogelijkheid – mogelijkheden, stad – steden, ei – eieren
• Een korte klinker wordt soms lang in het meervoud. vat – vaten, voetpad – voetpaden
Bijzondere meervouden
• Bij samenstellingen met twee gelijkwaardige delen krijgen beide de meervoudsvorm. studiemeesters-opvoeders
• Bepaalt het eerste deel het tweede, dan staat alleen het tweede deel in het meervoud. kandidaat-notarissen (Welke notarissen?)
• Bepaalt het tweede deel het eerste, dan staat alleen het eerste deel in het meervoud. processen-verbaal (Welke processen?)
MEERVOUD VAN WOORDEN UIT HET LATIJN OF GRIEKS
Het meervoud van sommige woorden wordt soms mee ontleend. Het krijgt dan de vorm die het oorspronkelijk in de andere taal had. politici, critici, classici
In veel gevallen kun je ook een -s of -en als meervoud gebruiken. data – datums, musea – museums, bases – basissen, crises – crisissen
©VANIN
tip
Beide of beiden?
Allen keken verbaasd naar het optreden. Kat en hond zijn beide toffe huisdieren.
• Je voegt een -n toe als het woord verwijst naar personen beiden, allen, velen
• Het woord blijft onveranderd als het naar dieren of zaken verwijst. beide, alle, vele
Woorden zonder meervoud Niet-telbare zelfstandige naamwoorden hebben geenmeervoud
• abstracte begrippen zoals gehoorzaamheid
• stofnamen zoals rubber
• verzamelnamen zoals vee
Op iDiddit vind je aanvullende oefeningen op de meervoudsvormen.
Woordtekens helpen je om woorden correct uit te spreken en/of om de woorden beter te begrijpen.
• Trema België, patiënt, industriële, financiën
• Koppelteken Vlaams-Brabant
• Apostrof auto’s, ’s nachts
• Accenttekens café (= accent aigu) carrière (= accent grave) enquête (= accent circonflexe)
Je gebruikt een trema om leesverwarring te voorkomen. Bijvoorbeeld bij poezie zonder trema zou je oe kunnen lezen zoals in poes. Met het trema zie je hoe je de e moet uitspreken.
naïviteit, ruïne, reële, financiële, geïnteresseerd, poëzie, reünie, vacuüm, continuüm

Je schrijft geen trema:
• bij woorden met Latijnse of Franse uitgangen (= leenwoorden); museum, elekricien, Parisienne
• wanneer er geen leesverwarring is; chaos, neon, koala
• bij dubbele-i; glooiing, verfraaiing

• bij het splitsen in lettergrepen. knie-en, ru-ine, fi-nan-ci-ele
Het trema geeft aan wanneer een nieuwe lettergreep begint en daarom wordt het ook wel eens ‘deelteken’ genoemd.
Meervouden van woorden die eindigen op -ie
Als -ie de klemtoon heeft, schrijf je -ieën. genieën, melodieën, knieën
Als -ie geen klemtoon heeft, schrijf je -iën. poriën, provinciën, ceremoniën
De woorden die eindigen met de onbeklemtoonde -ie hebben vaak ook een meervoud op -s. provincies, ceremonies
Je gebruikt een koppelteken om leesverwarring te voorkomen. Je gebruikt het bij andere woorden dan het trema.
Je schrijft een koppelteken:
• bij samenstellingen met evenwaardige delen; leerling-kok, studiemeester-opvoeder, paarse-groene regering, politiekeconomische problemen
• bij samengestelde aardrijkskundige namen en hun afleidingen; West-Vlaanderen, Oost-Vlaams
• bij uitgebreide samenstellingen met gelijkwaardige delen of combinaties; nek-aan-nekrace, doe-het-zelfzaak, zwart-witfoto

• bij weggelaten woorddelen; in- en uitvoer, op- en afrit

• bij woordcombinaties met als eerste lid niet, non, bijna, oud, sint, ex; niet-roker, non-verbaal, bijna-doodervaring, oud-leerlingen, Sint-Niklaas, sintbernardshond, ex-vriendin
• bij samenstellingen met cijfers, letters, tekens en afkortingen; 3-daagse, B-elftal, @-teken, sms-bericht

• bij Engelse woorden waarvan het tweede deel een voorzetsel is dat met een klinker begint; black-out, lay-out, hold-up, drive-in
• bij samenstellingen met klinkerbotsing.
astma-aanval, media-evenement, diploma-uitreiking, live-uitzending, ski-instructeur, auto-export, bureau-uren


Klinkerbotsing
Klinkerbotsing betekent dat er twee klinkers naast elkaar staan die als één klank gelezen kunnen worden terwijl dat niet de bedoeling is.
wel klinkerbotsing geen klinkerbotsing
Gebruik een koppelteken bij samenstellingen en een trema bij afleidingen bij klinkerbotsing.
• samenstellingen
camouflage-uitrusting, functie-inhoud
• afleidingen
geüniformeerd (= afleiding van uniform) beïnvloeden (= afleiding van invloed)
Leesbaarheid verhogen
Soms kun je als taalgebruiker toch een koppelteken gebruiken wanneer er geen klinkerbotsing is. Je doet dat dan om de leesbaarheid te verhogen.
rijangst – rij-angst, batterijoplader – batterij-oplader, babyyoghurt – baby-yoghurt, skiuitrusting – ski-uitrusting

Je gebruikt een apostrof :
• als het woord eindigt op een enkele klinker die lang wordt uitgesproken, of op een medeklinker +y, en gevolgd door: – de meervoudsuitgang -s; agenda’s, accu’s, taxi’s, whisky’s Maar je gebruikt geen apostrof als er geen fout in de uitspraak mogelijk is. lentes, bureaus, milieus, etuis, shampoos, cafés, cowboys


– de -s die de bezitsvorm aanduidt.
Andrea’s vriendje, Betty’s broer
Maar je gebruikt geen apostrof als er geen fout in de uitspraak mogelijk is;
Belgiës ontstaan, tantes auto, Renés job, Britneys hits of om de merknaam te accentueren.

Van Dale’s woordenboek
• bij een naam waarbij je als laatste letter een sisklank hoort; Andreas’ vriendin, Janice’ kleedje, Mulisch’ boeken, Brusselmans’ idee
• voor -tje van het verkleinwoord maar dit alleen na een medeklinker +y;
baby’tje, pony’tje

Maar je gebruikt geen apostrof:
– na een klinker +y; playboytje, essaytje

– bij verkleinwoorden van woorden die eindigen op een lang uitgesproken enkele klinker.
autootje, cafeetje, skietje, parapluutje, cappuccinootje, slaatje
• in afleidingen van cijfer- of letterwoorden;
een 40+’er, een tv’tje, een A4’tje, gsm’s, sms’en (je sms’t)
• om aan te duiden dat er letters of cijfers uit een woord of een getal zijn weggelaten.
’s morgens, ’t sneeuwt, z’n, ’n

Je gebruikt het accentteken:
• niet op a, o, u in gangbare Franse woorden; debacle, depot, ragout

• op de e (é, è en ê) als dat nodig is voor de correcte uitspraak, meestal in de laatste lettergreep; comité, paté, clientèle, crèche, première, gênant, enquête, crêpe, resumé, etage, decolleté, frequent, procedé, bohemien, protegé
• in sommige Franse leenwoorden; tête-à-tête, crème fraîche, maîtresse, déjà vu, comédienne
• niet bij vrouwelijke vormen van gangbare Franse woorden op -é. attachee, prostituee, logee, employee
Op iDiddit vind je aanvullende oefeningen op woordtekens.
Hieronder en op de volgende pagina’s vind je een zootje ongeregeld. Het zijn woorden die je juist moet spellen en waar de spellingsregels weinig houvast bieden. We noemen ze onthoudwoorden omdat je de spelling van de woorden moet onthouden.
A à volonté abonnee
abrupt
accent
accepteren
accessoire
accommodatie

accu
achttien
acrobatisch
acuut
acute adresseren
advocaat
affiche
agressief
akkoord
akoestiek
alleszins
allochtoon
althans
analyseren
anekdote
annuleren
antiek
antiquair
apart apotheek apparaat appartement
applaudisseren
appreciëren
aquarium
arrestatie
arrondissement
astma
atleet
attentie
attitude
attractie
B
back-up
barbecue
barbecueën
barricade
beautycase
begroeiing
bibliothecaresse
bijvoorbeeld
bleachen
blessure
bodypainting
boeddhistisch
bouillabaisse
bouillon
boulevard
brancard
breedte
broccoli
budgettair
business
C
cabine
cactussen
caissière
camoufleren
campagne
canapé
cappuccino
carnaval
carpoolen
carrière
carrosserie
carrousel
certificaat
champignon
chantage
chauffeur
chassis
checken
chic chique
chiquer
chicst
chipolata
chronologisch
cilinder circa cirkel cliché
climax
close-up
coalitie
cocaïne
cocktail
coëfficiënt
cognac
collectie
comfortabel
comité commentaar
commissaris
competentie complot
compromis
concentratie conciërge conclusie concurrentie confetti conflict connectie consensus consequent consumptie contact context
contradictie controle coördinatie copiloot
coulissen countdown
elektrocutie elektronisch elite emigrant emotie emotioneel enigszins enquête enthousiasme enthousiast entrecote envelop(pe) espresso etablissement ethiek etiket etnisch
coupé
crèche criticaster criticus
croissant
croque-monsieur cursus
cyclus
D dankzij debatteren decolleté defilé déjà vu democratie
depot
derdewereldland
desillusie diarree
dichtstbijzijnde dieet
diëtist diner discipline
discriminatie
discussiëren
diskwalificeren
douane
douche
driekwart dynastie
efficiënt
egoïst
elektricien elektriciteit
euthanasie evacuatie exact examen excentriek
excuseren executie exotisch
H halfacht hectisch helikopter herinneren hygiëne hypotheek I illegaal illusie imitatie immens immigratie immoreel immuun incognito insect installatie intact intelligent interessant interview introductie irritant
lokaal locatie
lucratief
luxueus
M maîtresse
make-up
management
manege
manoeuvre
manoeuvreren
maquette mayonaise
mecanicien
mechanisch
medaille
medicijnen meineed
middeleeuws
miljonair
millennium
misschien
mountainbike
mozaïek
mysterieus
F failliet faillissement faliekant fascineren
februari feuilleton financieel financiële flexibel fotokopie fulltime functioneren
G geachte gechoqueerd geïnteresseerd
gênant
gequoteerd
gewelddadig
gewricht gezamenlijk goeiemorgen graffiti grenzeloos
grootte guerrilla gynaecoloog
J jaloezie jenever journalist juffrouw
K karamel
karikatuur
kathedraal kolossaal komediant
kompres
kopieën kosmos
kosteloos kostuum
kotelet
kritiek
kroket kwaliteit
L laag-bij-de-gronds
labyrint
laconiek
lay-out
leidraad
lesbienne
litteken
N naïef
naïviteit neiging
niveau nochtans nonchalant
nuance
O omelet
onmiddellijk
P
panikeren parachute parallel
parallellogram
parcours
parttime
paté
patiënt
patrouille per se
personage pinguïn
piramide
pittoresk
pleister
portefeuille portemonnee
pousse-café precies
première principe
respect reünie
revolutionair
ritme
royaal ruïne
stiekem
stijl (manier)
succes
suggereren supplement
supporteren
tweetaktmotor
tweetjes
twijfelen
U
uittreksel
pro Deo productie professioneel professor profiteren
prostitué
prostituee
psychiater
pyjama
Q
quiz R
racisme
racistisch
racket
radicaal
rancuneus
rapporteren
razzia
reactie
recensie
recensent
reglement
rekwisiet
S sabotage
satelliet
‘s avonds
scenario
scène
sciencefiction
scoren
scrupules seks
selfservice
sexappeal
sexy
shampoo showbizz
signaal
solliciteren
spaghetti
spectaculair
spektakel
spionage
sponsor
sponsoren
stagiair / stagiaire
steil (sterk hellend)
sushi
sympathiek
symptoom
synoniem
synthese
T
tactiek
tête-à-tête
textiel
tezelfdertijd
thermometer
thriller
tiramisu
tornooi
tournee
trakteren
treiteren
trofee
truc (goocheltruc)
truck (vrachtwagen)
trukendoos
tsunami
tweederdemeerderheid
tweemaal
uitweiden
up-to-date
V
vaccin
vanmorgen
variëren
verrukkelijk
viaduct
vleien (de ijdelheid strelen)
volleybal
W
wraak
wrijven
Y
yoghurt
Z
zo-even